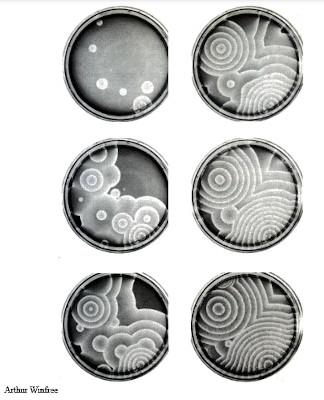

Caos
James Gleick
A Cynthia
humana era la música,
natural era el ruido parásito…
JOHN UPDIKE
En los tres decenios transcurridos desde que J. Robert Oppenheimer había elegido aquel peregrino paraje como solar del proyecto de la bomba atómica, el Los Alamos National Laboratory (Laboratorio Nacional de Los Álamos) se había extendido por la desolada altiplanicie y dado cabida a aceleradores de partículas, láseres de gas e instalaciones químicas; a millares de científicos, administradores y técnicos, y, en fin, a una de las mayores concentraciones de superordenadores del mundo. Varios especialistas, ya veteranos, recordaban los edificios de madera erigidos con premura en el borde rocoso en la década de 1940; mas para la mayor parte del personal, hombres y mujeres jóvenes, vestidos como estudiantes universitarios, con pantalón de pana y camisa de obrero, los primeros hacedores del artefacto eran poco más que fantasmas. El centro del pensamiento más puro se hallaba en la Sección Teórica, denominada Departamento T, de la misma manera que la de ordenadores era el C, y la de armas, el X. En el T trabajaban más de un centenar de físicos y matemáticos, bien pagados y libres de la presión académica de enseñar y publicar. Era gente acostumbrada a los talentos brillantes y excéntricos, y, por lo mismo, nada proclive a asombrarse.
No obstante, Mitchell Feigenbaum se salía de lo usual. Había firmado, exactamente, un solo artículo y, a todas luces, no se dedicaba a algo prometedor. Llevaba la desordenada melena peinada hacia atrás, al estilo de los hermas de los compositores alemanes. Tenía los ojos vivos, apasionados. Al hablar, lo que siempre hacía con precipitación, tendía a prescindir de los artículos y pronombres de modo vagamente centroeuropeo, aunque había nacido en Brooklyn. Cuando trabajaba, lo hacía casi con obsesión. Cuando no trabajaba, caminaba y pensaba, fuese de día o de noche, y de preferencia en ésta. Veinticuatro horas, las diarias normales, se le antojaban demasiado angostas. Sin embargo, su experimento sobre la cuasi periodicidad personal llegó al cabo cuando decidió que no podía soportar durante más tiempo saltar de la cama en el momento de la puesta de sol, lo que le acontecía cada pocos días.
A los veintinueve años de edad ya se había convertido en sabio entre los sabios, en consultante ad hoc, al que los científicos recurrían en los casos en que se enfrentaban con un problema especialmente irreductible, siempre y cuando consiguieran encontrarle. Una tarde llegó al trabajo en el preciso segundo en que se iba el director del laboratorio, Harold Agnew. Agnew era poderoso, uno de los antiguos aprendices de Oppenheimer. Había volado sobre Hiroshima en un avión cargado de instrumentos, el que acompañó al Enola Gay, encargado de fotografiar la entrega del primer producto del laboratorio.
—Sé que es usted muy inteligente —espetó Agnew a Feigenbaum—. Si lo es tanto, ¿por qué no resuelve la fusión de láser?
Incluso los amigos del joven se preguntaban si llegaría a producir obra propia. Estaba dispuesto a realizar súbitos milagros en beneficio de lo que los preocupaba; en cambio, no le interesaba, en apariencia, consagrar sus facultades a una investigación que rindiera frutos. Meditaba sobre la turbulencia en los líquidos y gases. Meditaba sobre el tiempo: ¿Se deslizaba con suavidad o a saltos discretos, como una secuencia de fotogramas en una película cósmica? Reflexionaba sobre la capacidad del ojo para ver formas y colores consistentes en un universo que, en opinión de los físicos, era un mutable caleidoscopio cuántico. Reflexionaba sobre las nubes, contemplándolas desde las ventanillas de aviones (hasta que, en 1975, sus privilegios de viajero científico fueron anulados oficialmente por exceso de utilización), o desde los senderos que dominaban el laboratorio.
En las poblaciones montañesas del Oeste, las nubes apenas se asemejan a las calinas bajas, fuliginosas e indeterminadas, que llenan el aire del Este. En Los Álamos, al socaire de una gran caldera volcánica, se esparcen por el firmamento en formación casual, sí, pero también no casual, y se muestran en puntas uniformes u ondean en diseños, con surcos regulares como los del cerebro. En las tardes tormentosas, en que el cielo brilla con resplandor trémulo y vibra con la electricidad inminente, las nubes se destacan a cuarenta y cinco kilómetros de distancia, filtrando la luz y reflejándola, hasta que toda la bóveda celeste adquiere el aspecto de espectáculo representado como reproche sutil a los físicos. Las nubes significaban una parte de la naturaleza que la corriente principal de la física había omitido, parte a la vez borrosa y detallada, estructurada e impredecible. Feigenbaum rumiaba tales cosas, callada e improductivamente.
Para un físico, crear la fusión de láser era cuestión conforme con los principios establecidos; resolver el enigma del espín, la fuente de atracción y las cualidades distintivas de las partículas subatómicas, era conforme con los principios establecidos; fechar el origen del cosmos era conforme con los principios establecidos. La comprensión de las nubes atañía a los meteorologistas. Como otros de sus colegas, Feigenbaum se servía de un vocabulario depreciador, de hombre hecho a todas, para denotar tales asuntos. Es algo evidente podía decir, como señal de que un resultado sería entendido por cualquier físico experto, tras la reflexión y el cálculo adecuados. La expresión no evidente describía un trabajo merecedor de respeto y del Premio Nobel. Para los problemas más abstrusos, aquellos que no se solventaban sin largo escrutinio de las entrañas universales, los físicos reservaban epítetos por el estilo de profundo. En 1974, pocos compañeros sabían que Feigenbaum luchaba a brazo partido con uno en verdad profundo: el caos.
* * * *
La ciencia clásica acaba donde el caos empieza. Mientras los físicos indagaron las leyes naturales, el mundo adoleció de una ignorancia especial en lo que concierne a los desórdenes de la atmósfera y del mar alborotado; a las fluctuaciones de las poblaciones silvestres de animales y vegetales; y, para abreviar, a las oscilaciones del corazón y el cerebro. La porción irregular de la naturaleza, su parte discontinua y variable, ha sido un rompecabezas a ojos de la ciencia o, peor aún, una monstruosidad.No obstante, en la década de 1970, un puñado de científicos estadounidenses y europeos comenzó a fraguarse camino en el desorden. Eran matemáticos, físicos y biólogos, y todos buscaban nexos entre las diferentes clases de irregularidades. Los fisiólogos hallaron pasmoso orden en el caos que sobreviene en el corazón humano, causa primera de inexplicables muertes repentinas. Los ecologistas exploraron el aumento y el decrecimiento de las poblaciones de mariposas lagartas. Los economistas exhumaron datos pretéritos sobre el precio de valores cotizados en la bolsa, y emprendieron un género nuevo de análisis. Las percepciones así reunidas condujeron en derechura del mundo natural: a las formas de las nubes, al recorrido de las exhalaciones eléctricas, al microscópico entretejido de los vasos sanguíneos y a la acumulación galáctica de las estrellas.
Cuando se puso a cavilar en Los Álamos sobre el caos, Mitchell Feigenbaum pertenecía a la minoría de aquellos científicos desperdigados, los más de los cuales no se conocían. Un matemático de Berkeley (California) había congregado un grupito entregado a un estudio peculiar de los «sistemas dinámicos». Un biólogo de la población estaba, en la Universidad de Princeton, a punto de publicar una súplica apasionada para que todos los hombres de ciencia contemplasen el comportamiento, asombrosamente complejo, que se disimulaba en modelos sencillos. Un geómetra, empleado de la IBM, buscaba un vocablo para describir una familia de formas —dentadas, enmarañadas, astilladas, retorcidas y fracturadas—, que consideraba norma organizadora en la naturaleza. Un físico matemático francés acababa de manifestar la controvertible proposición de que la turbulencia en los fluidos tal vez se relacionara con una abstracción, extravagante e infinitamente complicada, a la que denominaba «atractor extraño».
Diez años más tarde de lo anterior, el caos se ha convertido en el nombre conciso de un movimiento, de crecimiento acelerado, que reforma la trama del establishment científico. Menudean las conferencias y publicaciones sobre él. En los Estados Unidos, los directores de programas gubernamentales, encargados de administrar los fondos de investigación para los militares, la CIA y el Ministerio de Energía, invierten sumas cada vez más cuantiosas en el estudio del caos; y se han organizado burocracias especiales para pilotar su financiamiento. En todos los centros de investigación y universidades más importantes, algunos teóricos se sienten más atraídos por el caos que por las especialidades que motivaron su contrato. En Los Álamos se fundó un Centro de Estudios No Lineales, cuya misión consiste en coordinar los esfuerzos sobre él y los problemas anexos. Instituciones similares han brotado en el ámbito universitario de todo el país.
El caos ha forjado técnicas privativas en la utilización de los ordenadores y géneros peculiares de representaciones gráficas, imágenes que captan estructuras fantásticas y delicadas, de complejidad subyacente. La nueva ciencia ha inventado un léxico característico, una jerga distinguida de fractales y bifurcaciones, intermitencias y periodicidades, difeomorfismos de toalla doblada y diagramas de fideos blandos. Se trata de los nuevos elementos del movimiento, de la misma manera que, en la física tradicional, los quarks y gluones son los nuevos elementos de la materia. Algunos físicos interpretan el caos como ciencia del proceso antes que del estado, del devenir antes que del ser.
Dada la voz de aviso, parece ahora que el caos se halla por doquier. Una columna ascendente de humo de cigarrillo se deshace en disparatadas volutas. Una bandera flamea al viento. Un grifo goteante va de un chorrito uniforme a uno sin orden ni concierto. El caos asoma en el comportamiento del tiempo atmosférico, en el de un aeroplano durante el vuelo, en el de los automóviles que se arraciman en una autopista, en el del petróleo que se desliza por los oleoductos subterráneos. Sea cual fuere el medio, el comportamiento obedece a las mismas leyes, recién descubiertas. El hecho de haberse dado cuenta de ello, comienza a modificar el modo como los ejecutivos toman decisiones sobre los seguros, la forma como los astrónomos consideran el sistema solar y la manera como los teóricos de la política hablan de las tensiones que concluyen en choques armados.
El caos salva las fronteras de las disciplinas científicas. Por ser la ciencia de la naturaleza global de los sistemas, ha reunido a pensadores de campos muy separados.
—Hace quince años, el saber se abocaba a una crisis de especialización creciente —comentó un oficial de la marina, encargado de la financiación científica, ante un auditorio de matemáticos, biólogos, físicos y médicos—. La superespecialización inminente se ha trastocado de modo espectacular gracias al caos.
Éste plantea cuestiones que desafían los usuales métodos científicos de trabajo. Defiende con vigor el comportamiento universal de lo complicado. Sus primeros teóricos, aquellos que le imprimieron impulso, compartían ciertas sensibilidades y aficiones. Poseían vista aguda para reconocer unos modelos dados, sobre todo los que aparecen simultáneamente en escalas distintas. Les agradaba el azar y la complejidad, los bordes quebrados y los saltos repentinos. Los creyentes en el caos —en ocasiones se denominan así, y también conversos y evangelistas— especulan acerca del determinismo y el libre albedrío, la evolución y la índole de la inteligencia consciente. Sienten que interrumpen cierta tendencia de lo científico al reduccionismo, al análisis de los sistemas en términos de sus partes constitutivas: quarks, cromosomas o neuronas. Creen buscar la totalidad.
Los defensores más encendidos de la nueva ciencia llegan al extremo de declarar que el saber del siglo XX se recordará sólo por tres cosas: la relatividad, la mecánica cuántica y el caos. El último, sostienen, se ha transformado en la tercera gran revolución de la ciencia física en esta centuria. Como las dos anteriores, el caos propina un buen tajo a los dogmas newtonianos.
—La relatividad eliminó la ilusión del espacio y el tiempo absolutos de Newton —ha manifestado un físico—; la teoría cuántica arruinó el sueño del mismo sabio de un proceso de medición controlable; y el caos barre la fantasía de Laplace de la predectibilidad determinista.
De las tres revoluciones, la del caos importa al mundo que vemos y tocamos, a los objetos de proporción humana. La experiencia cotidiana y las imágenes reales de cuanto nos rodea se han convertido en fin legítimo de la investigación. Hacía bastantes años que se alimentaba la creencia, no siempre expresada a las claras, de que la física teórica se había apartado mucho de la intuición que el hombre tiene del mundo. Nadie sabe si esta orientación terminará en herejía fructífera o en herejía monda y lironda. Pero algunos que estaban persuadidos de que la física parecía meterse en un callejón ciego, ahora ven el caos como una posible salida.
El estudio del caos surgió, en el seno de la física, de un remanso. La corriente principal, durante la mayor parte de este siglo, ha estado representada por la de las partículas, que explora los bloques constructivos de la materia, según energías cada vez más altas, escalas cada vez más pequeñas y tiempos cada vez más fugaces. De ella han nacido teorías sobre las fuerzas básicas de la naturaleza y sobre el origen del universo. No obstante, hubo jóvenes especialistas que sintieron descontento creciente ante la orientación de la más prestigiosa de las ciencias. Empezaron a creer que los progresos eran lentos, fútil la especificación de nuevas partículas y confusa la masa teórica. Al presentarse el caos, vieron en él un cambio de dirección de toda la física. Las rutilantes abstracciones de las partículas de alta energía y la mecánica cuántica habíanse impuesto más de lo conveniente, en su opinión.
El cosmólogo Stephen Hawking, que ocupa la cátedra Newton en la Universidad de Cambridge, habló en nombre de la generalidad de los físicos cuando hizo el inventario de su disciplina en una conferencia de 1980, titulada «¿Está a la vista el final de la física teórica?».
—Sabemos ya las leyes que gobiernan todo lo que experimentamos en la vida diaria… Se presenta como un tributo a lo lejos que hemos ido la circunstancia de que se requieran ahora máquinas enormes y muchísimo dinero para efectuar un experimento de resultado incierto.
Hawking admitió, sin embargo, que la comprensión de las leyes naturales, de acuerdo con la física subatómica, no satisfacía la cuestión de cómo aplicarlas al sistema más simple. Una cosa es la predectibilidad en una cámara de niebla, en la que dos partículas se embisten al término de su carrera por el acelerador, y otra, muy diferente, en el más sencillo tubo de fluido enturbiado, o en el tiempo atmosférico de la Tierra, o en el cerebro del hombre.
La física de Hawking, que cosecha con gran eficacia Premios Nobel y dinerales para los experimentos, se ha descrito a menudo como una revolución. Ha parecido en ocasiones tener a su alcance el grial de la ciencia, la «gran teoría unificada» o «teoría total». Los especialistas habían rastreado por completo el desarrollo de la energía y de la materia, con excepción del primer atisbo de la historia cósmica. Pero ¿era una revolución auténtica la física de las partículas posterior a la segunda guerra mundial? ¿O sólo la raedura de los restos de carne que persistían en el esqueleto ensamblado por Einstein, Bohr y demás progenitores de la relatividad y la mecánica cuántica? Ciertamente, los logros de la física, desde la bomba atómica hasta el transistor, habían alterado el paisaje del siglo XX. Pese a ello, la esfera de la consagrada a las partículas parecía haberse reducido. Dos generaciones habían visto la luz desde que se produjo otra idea teórica apta para modificar la concepción del mundo de los profanos.
La física descrita por Hawking podía rematar su misión sin contestar alguna de las preguntas más fundamentales sobre la naturaleza. ¿Cómo se inicia la vida? ¿Qué es una turbulencia? Y, por encima de todo, en un universo en que señorea la entropía, o sea, inexorablemente condenado a un desorden cada vez mayor, ¿cómo se suscita el orden? Al propio tiempo, los objetos de la experiencia cotidiana, tales como los fluidos y los sistemas mecánicos, habían llegado a hacerse tan primarios, básicos y comunes, que los físicos tendían de forma casi indeliberada a creer que se los entendía a la perfección. Y no era así.
Mientras la revolución del caos sigue su curso, los mejores especialistas advierten que vuelven, sin empacho alguno, al examen de fenómenos de dimensiones humanas. Estudian, no las galaxias, sino las nubes. Efectúan investigaciones fecundas tanto con los ordenadores Cray como los Macintosh. Las revistas de categoría publican artículos sobre la rara dinámica de una pelota al botar en una mesa, y se leen junto a otros que tratan de materia cuántica. Los sistemas más sencillos se conciben ahora como capaces de suscitar muy arduos problemas de predectibilidad. Sin embargo, el orden se presenta de modo espontáneo en tales sistemas: caos y orden simultáneos. Únicamente una ciencia nueva podía emprender el cruce de la amplia sima que separaba el conocimiento de lo que una cosa hace —una molécula de agua, una célula de tejido cardíaco, una neurona— de lo que hacen millones de ellas.
Dos pizcas de espuma flotan contiguas en el fondo de una cascada. ¿Qué se colegirá de su proximidad anterior en lo alto? Nada. En lo que afecta a los físicos clásicos, bien pudo Dios haber barajado aquellas moléculas de agua debajo de su tapete verde. Por tradición, cuando observan efectos complejos, buscan causas complejas. Si perciben una relación fortuita, impensada, entre lo que penetra en un sistema y lo que sale de él, suponen que han de convertir lo casual en teoría realista, y para ello agregan ruido o error artificial. El moderno estudio del caos comenzó en el decenio de 1960, con el desagradable hallazgo de que ecuaciones matemáticas muy simples podían modelar sistemas tan violentos como una cascada. Nimias diferencias de entrada o input llegaban a transformarse rápidamente en enormes diferencias de salida u output, fenómeno que se denominó «dependencia sensitiva de las condiciones iniciales». En el tiempo atmosférico, por ejemplo, ello se traduce en lo que se conoce, sólo medio en broma, por efecto de la mariposa, a saber, la noción de que, si agita hoy, con su aleteo, el aire de Pekín, una mariposa puede modificar los sistemas climáticos de Nueva York el mes que viene.
Cuando repasaron la genealogía de su ciencia, los exploradores del caos descubrieron muchos rastros intelectuales en el pasado. Uno se destacaba con claridad. Para los jóvenes físicos y matemáticos que encabezaban la revolución, un punto de partida fue el «efecto de la mariposa».Ni siquiera en nuestros días ha dejado de sonar un tanto a oxímoron la expresión teoría del caos. En la década de 1980, caos y teoría eran palabras que difícilmente habrían podido encontrarse en la misma sala, por no decir ya en la misma frase. Cuando mis amigos supieron que estaba trabajando en un libro sobre el caos —y que tenía que ver con la ciencia—, me miraron inquisitivos y recelosos. Una de ellos me confesó, más tarde, que estaba convencida de que debía de estar escribiendo sobre «gas». Tal como se afirma en el subtítulo, la del caos era una ciencia nueva, extraña y de nombre extravagante, emocionante y difícil de aceptar.
¡Lo que cambian las cosas en un cuarto de siglo! Las ideas vinculadas a esta teoría se han visto adoptadas y asumidas no sólo por la ciencia convencional, sino también por la cultura en general. Aun hoy, sin embargo, sigue habiendo muchos investigadores a los que les parece extraña y de nombre extravagante, emocionante y difícil de aceptar.
En nuestros días, todos hemos oído hablar del caos, aunque sea sólo de pasada.
—No entiendo eso del caos —dice el personaje que interpreta Laura Dern en la película de 1993 Parque Jurásico, basada en la novela de Michael Crichton, y el de Jeff Goldblum, que se presenta como adepto de dicha teoría, puede permitirse así explicarle en tono cautivador:
—Se trata de la imprevisibilidad en sistemas complejos. Se resume en el efecto mariposa. Una mariposa bate las alas en Pekín, y en Nueva York llueve en lugar de hacer sol.
A esas alturas, el efecto mariposa se hallaba a un paso de erigirse en lugar común de la cultura popular. En él, de hecho, se han inspirado al menos dos obras cinematográficas, una entrada del Bartlett’s familiar quotations, un vídeo musical y un millar de páginas y cuadernos de bitácora en Internet (eso sí: los topónimos no han dejado de cambiar, y así, la mariposa aletea en Brasil, el Perú, la China, California, Tahití y Suramérica, y provoca lluvia, un huracán, un tornado o una tormenta en Texas, Florida, Nueva York, Nebraska, Kansas o Central Park). Tras los huracanes sufridos en 2006, la revista Physics Today publicó un artículo, titulado «Battling the butterfly effect» («La lucha contra el efecto mariposa»), que deja volar la fantasía para culpar del desastre a una formación de tales insectos: «De pronto acuden a la mente visiones de campos de entrenamiento para lepidópteros terroristas».
Tanto los expertos modernos en administración empresarial como los autores posmodernos de teoría literaria han recurrido a un aspecto u otro del caos. En los dos ámbitos han resultado de gran utilidad expresiones como la del «desorden ordenado», popular sobre todo en títulos de tesis. A los personajes apasionantes de la literatura, como la Cleopatra de Shakespeare, se les considera «atractores extraños», y a las tendencias de los diagramas de los mercados financieros, también. Por su parte, los pintores y los escultores han hallado inspiración tanto en las imágenes como en los contenidos de la geometría fractal. Yo diría que la encarnación artística más poderosa de estas ideas se da en Arcadia, obra teatral de Tom Stoppard, estrenada en Londres unos meses antes que Parque Jurásico. También en ella aparece un matemático que se deleita en el caos: «Lo estrafalario —asegura— está resultando ser la matemática del mundo natural». El dramaturgo va más allá del desorden ordenado para abordar la tensión que se da entre el jardín inglés formal y una selva; entre lo clásico y lo romántico. Stoppard encauza las voces que pueden escucharse en este libro, y sé que citarlo aquí equivale a enzarzarse en un diálogo de besugos; pero lo cierto es que no puedo evitarlo. El autor capta a la perfección la euforia que provoca a muchos jóvenes el descubrimiento del caos. No ve sólo la puerta abierta, sino también el paisaje que se extiende tras ella.
Esa realidad ordinaria que es nuestra vida, las cosas sobre las que escribe la gente poesía: las nubes, los narcisos, las cascadas o lo que ocurre en una taza de café cuando le echamos crema…; todas estas cosas están cargadas de misterio. Son tan enigmáticas para nosotros como lo era el firmamento para los griegos. El futuro es desorden. Una puerta así sólo se ha entreabierto cinco o seis veces desde que echamos a caminar sobre las patas traseras. ¿Qué mejor momento para estar vivo que éste, en el que casi todo lo que creíamos saber ha resultado estar equivocado?En realidad, la puerta está más que entreabierta ahora, que contamos con una nueva generación de científicos armada con un conjunto de convicciones más robusto acerca del funcionamiento de la naturaleza. Saben que un sistema dinámico de cierta complejidad puede adoptar formas insólitas, y también que, cuando tal cosa ocurre, no deja de ser posible mirarlo a los ojos y conocer de qué pie cojea. Los encuentros interdisciplinares destinados a compartir metodologías relativas a configuraciones de escala o pautas de redes, si bien siguen sin ser la norma, ya no son, cuando menos, ninguna excepción.
En general, los precursores del caos llegaron salidos de un terreno agreste para hacerse un hueco entre lo más granado de la investigación científica. Después de que lo nombraran profesor emérito del MIT y lo colmaran de honores, Edward Lorenz aún acudía a trabajar a los noventa años a su despacho, situado en las alturas del Edificio 54, desde donde no era difícil verlo observar las condiciones del tiempo. Mitchell Feigenbaum entró a formar parte del claustro de la Universidad Rockefeller y creó allí un laboratorio de física matemática. A Robert May, que presidió la Royal Society y fue asesor jefe científico del Gobierno del Reino Unido, le otorgaron en 2001 el título de barón May de Oxford. Por su parte, Benoît Mandelbrot publicó, en 2006, un «currículo» en su página web de la Universidad de Yale en el que se relacionan 24 premios, menciones y medallas; dos condecoraciones; 19 «diplomas, títulos honoris causa y similares»; su afiliación a 12 sociedades científicas; su pertenencia a 15 consejos y comités editoriales, y toda una variedad de objetos y entidades que llevan su nombre y entre los que se incluyen «un árbol del paseo Nobel» de la ciudad húngara de Balatonfüred, un laboratorio en la China y un asteroide.
Los principios que descubrieron y los conceptos que inventaron todos ellos han seguido evolucionando, y el primer ejemplo de ello lo constituye la propia palabra caos. Ya a mediados de la década de 1980 recibía una definición bastante estricta por parte de los numerosos científicos consagrados a este particular, que la aplicaban a un subconjunto particular de los fenómenos abarcados por expresiones más generales como sistemas complejos. El lector sagaz, sin embargo, habrá podido advertir que un servidor prefería una definición más libre y abarcadora, al estilo de la de Joe Ford: «La dinámica que ha sacudido, al fin, el yugo del orden y lo predecible»; y aunque sigo adherido a ella, lo cierto es que todo evoluciona hacia la especialización, y en un sentido estricto, el caos es, en nuestro tiempo, algo muy preciso. Cuando Yaneer Bar-Yam escribió, en 2003, el manual de casi mil páginas que tituló Dynamics of Complex Systems, abordó el caos propiamente dicho en la primera sección del capítulo inicial («Vale: tengo que reconocer que el capítulo primero tiene trescientas páginas», asevera). A continuación llegaron el proceso estocástico, la simulación de modelos matemáticos, los autómatas celulares, las teorías de computación e información, las escalas, la re normalización y los fractales, las redes neuronales y de atractores, los sistemas homogéneos y los heterogéneos, etc.
Bar-Yam, hijo de un experto en física de partículas, había estudiado física de la materia condensada y, en 1997, tras abandonar la docencia en la Universidad de Boston, fundó el Instituto de Sistemas Complejos de Nueva Inglaterra. Había conocido la obra de Stephen Wolfram sobre autómatas celulares y la de Robert Devaney sobre el caos, y descubrió que los polímeros y superconductores le interesaban menos que las redes neuronales y —según afirma sin ánimo de ostentación— la naturaleza de la civilización humana. «Reflexionar sobre la civilización —asevera— me llevó a pensar en la complejidad en cuanto entidad. ¿Con qué es comparable la civilización? ¿Con el latón?; ¿con una rana? ¿Cómo contestar a esa pregunta? Eso es lo que origina los sistemas complejos».
La respuesta, por si el lector no ha dado con ella, es que se asemeja más a una rana que al latón, por el simple hecho de que evoluciona, y los procesos de adaptación que comporta este hecho son esenciales para el diseño y la creación de algo tan complejo que no puede descomponerse de forma eficaz en piezas independientes. Los sistemas socioeconómicos son como ecosistemas; de hecho, son ecosistemas. Mediante simulación por ordenador, Bar-Yam ha estado estudiando, entre otras cosas, patrones mundiales de violencia étnica, para lo cual ha tratado de aislar los de mezclas de población y de fronteras que suscitan conflictos. Se trata, en lo fundamental, de una investigación de formación de pautas, y la simple circunstancia de que pueda trabajar en este campo ilustra el cambio profundo que se ha producido en las dos últimas décadas en lo tocante a comprensión, por parte del público, de lo que constituye un problema científico legítimo. «Voy, con su permiso, a compendiar el proceso», propone a sus lectores antes de referir la siguiente parábola:
Tenemos un huerto, y gente que trabaja en él para recoger los frutos que ofrecen sus árboles. ¿Vale? Cosechan lo que les dan y lo llevan al mercado, y a continuación toca hacerse con la fruta que se encuentra en las ramas más altas. Resulta más difícil de alcanzar, y tal vez tiene un tamaño menor y un aspecto no tan bueno. Fabricamos escaleras y subimos a lo alto para cogerla, y a continuación recompensamos a quienes han hecho las escaleras.A su entender, en nuestros días ha mejorado mucho la comunicación: las disciplinas de todo el abanico que ofrece la ciencia han aprendido a centrarse en comprender la complejidad, las escalas, los patrones y la conducta colectiva ligada a estas últimas. Todo eso es fruta.
Yo tengo la sensación de haber hecho lo siguiente: Miro a mi alrededor y veo que hay un seto, y detrás, otro huerto con un montón de árboles cargados de frutas hermosísimas. Y allá que voy: doy con una de ellas y vuelvo al seto para enseñársela a todos, y todos me dicen:
— ¡Eso no es fruta!
Ya no la reconocen.
En lo más embriagador de los primeros días, los investigadores describieron el caos como la tercera revolución del siglo en el ámbito de las ciencias físicas, pues llegó detrás de la relatividad y la mecánica cuántica. Lo que no puede negarse hoy es que resulta inseparable de estas dos: física sólo hay una.
Las ecuaciones fundamentales de la relatividad general son de carácter no lineal, y eso, por lo que sabemos, es una señal de que el caos acecha oculto. «No siempre se está bien versado en sus métodos —advierte Janna Levin, astrofísica y cosmóloga de la Universidad de Columbia—. La física teórica en particular está cimentada en la idea de simetrías fundamentales —señala—, y creo que ése es el motivo por el que ha sido tan difícil a los físicos teóricos aceptar semejante cambio de paradigma». Las simetrías y los grupos de simetría tienden a producir ecuaciones solubles, y por eso funcionan tan bien… cuando funcionan.
En cuanto experta en relatividad, Levin aborda las preguntas más abarcadoras que puedan imaginarse, como la de: ¿Es infinito el universo, o sólo inmenso? Sus investigaciones parecen apuntar a que hay que considerarlo inmenso o —si nos ponemos técnicos— compacto desde el punto de vista topológico y multi conectado. Al estudiar su origen, Levin no tuvo más remedio que enfrentarse al caos y topó con no poca resistencia. «Mis investigaciones provocaron reacciones violentísimas la primera vez que las hice públicas», recuerda. En general, se consideraba que la teoría del caos estaba bien para analizar «sistemas complicados y mugrosos, pero no el terreno virtual, puro y sencillo de la física fundamental».
En realidad, estábamos trabajando sobre el caos en la purísima relatividad general, exenta por completo de mugre. Se trataba de una empresa diminuta, muy diminuta. Intentábamos entender el caos en un big banggenérico, en la caída en un agujero negro o en las órbitas que se producen a su alrededor. La gente no piensa que se trate de un mundo fantasmagórico, pero se sorprende de ver que tiene su función en algo tan poco mugroso (sin átomos ni trastos de ningún tipo) como un sistema puramente relativista.Los astrónomos habían dado ya con la huella del caos en la violencia que se genera en la superficie solar, en los vacíos que se dan en el cinturón de asteroides y en la distribución de las galaxias, y Levin y sus colegas la han hallado también en lo que ocurrió tras el Big Bang y en los agujeros negros. Al decir de sus predicciones, la luz que atrapan éstos puede entrar en órbitas caóticas inestables y verse re emitida, con lo que sería posible contemplar el agujero negro, siquiera un instante. Sí: el caos puede iluminarlo. «Aún quedan por explotar números racionales, conjuntos fractales y toda clase de consecuencias hermosas —asegura—. De modo que todos están aterrados y fascinados a partes iguales». Ella ha introducido el caos en el espacio-tiempo curvado. Einstein estaría orgulloso.
* * * *
Por lo que a mí respecta, lo cierto es que jamás he vuelto al ámbito del caos, aunque es posible que el lector encuentre en el presente libro las semillas de todos cuantos he escrito tras él. Apenas sabía nada de Richard Feynman, y sin embargo, aparece aquí como invitado (véase el capítulo 5). Isaac Newton tiene un protagonismo mucho mayor: da la impresión de ser el antihéroe del caos, o el dios que debe ser destronado. Con el tiempo, leyendo sus cuadernos y su correspondencia, reparé, sin embargo, en lo equivocado que estaba sobre él. También mi último libro tuvo su origen en éste, y de un modo más concreto, en lo que me reveló Rob Shaw acerca del caos y la teoría de la información. Otra paradoja: el caos es creador de información.Capítulo 1
El efecto de la mariposa
Los físicos se complacen en pensar que basta decir:
Éstas son las condiciones. Pero ¿qué sucede a continuación?
RICHARD P. FEYNMAN
§. Edward Lorenz y el juguete del tiempo atmosférico§. Edward Lorenz y el juguete del tiempo atmosférico
§. El ordenador se porta mal
§. Los pronósticos muy amplios del tiempo están condenados a desaparecer
§. Orden disfrazado de azar
§. Un mundo no lineal
§. «No nos dimos cuenta de la verdad»
El sol batía desde un cielo que las nubes jamás habían encapotado. Los vientos recorrían una tierra lisa como el cristal. Nunca llegaba la noche, y nunca el invierno sucedía al otoño. Jamás llovía. El tiempo atmosférico simulado en el nuevo ordenador de Edward Lorenz cambiaba lenta, pero seguramente, a lo largo de un mediodía constante y seco, como si el mundo se hubiera convertido en Camelot o en una versión sobremanera benigna del sur de California.
El tiempo real se ofrecía a Lorenz por la ventana: la bruma matinal envolvía el solar del Massachusetts Institute of Technology (Instituto de Tecnología de Massachusetts), y las nubes bajas, procedentes del Atlántico, rozaban los tejados. Bruma y nubes que nunca se mostraban en el modelo de su ordenador. El aparato, un Royal McBee, espesura de cables y tubos de vacío, ocupaba un desmesurado espacio en la oficina de Lorenz; emitía un ruido singular e irritante, y se estropeaba, más o menos, cada semana. No poseía ni la velocidad ni la memoria precisas para rendir una simulación realista de la atmósfera y los océanos terrestres. Y, a pesar de ello, Lorenz creó, en 1960, un tiempo de juguete que fascinó a sus colegas. La máquina señalaba cada minuto el paso de un día, imprimiendo una hilera de números en un papel. Quien sabía leer las cifras notaba que un viento occidental predominante fluctuaba del norte al sur, y de nuevo al norte. Ciclones digitalizados rotaban despacio en torno de un globo terráqueo idealizado. Corrió la voz de ello por el departamento. Los demás meteorologistas, en compañía de los estudiantes graduados, apostaban sobre lo que haría el tiempo de Lorenz. Como por arte de ensalmo, jamás acontecía una cosa dos veces del mismo modo.
Lorenz se divertía con el tiempo, lo cual no es requisito previo en la investigación meteorológica. Paladeaba su mutabilidad. Apreciaba las pautas que apuntaban y desaparecían en la atmósfera: familias de mareas y ciclones, que obedecían siempre a reglas matemáticas, aunque nunca se repitiesen. Mientras las contemplaba, creía ver algo semejante a una estructura en las nubes. Había temido que estudiar la ciencia del tiempo fuese como fisgar en un muñeco de resorte con la ayuda de un destornillador. Y entonces se preguntaba si la ciencia lograría introducirse en su magia. El tiempo atmosférico contenía algo inexpresable con promedios. La temperatura máxima diaria en Cambridge (Massachusetts) promedia en junio los 24 °C. El número de días lluviosos en Riad (Arabia Saudí) es de diez anuales por término medio. Se trataba de estadísticas, y nada más. Lo esencial estribaba en cómo cambiaban las pautas atmosféricas en el transcurso de las horas, es decir, precisamente lo que Lorenz había capturado en su Royal McBee.
Era el dios de aquel universo maquinal, libre de elegir a su capricho las leyes de la naturaleza. Luego de cierta cantidad de tanteos y equivocaciones, nada divinos, escogió doce. Fueron reglas numéricas: ecuaciones que expresaban los nexos entre la temperatura y la presión, y entre la presión y la velocidad del viento. Comprendió que ponía en práctica las normas de Newton, instrumentos apropiados para una deidad relojera, capaz de crear un mundo y de mantenerlo en marcha durante la eternidad. No sería menester otra intervención, gracias al determinismo de los principios físicos. Los autores de tales modelos daban por supuesto que, desde el presente al futuro, las reglas del movimiento tendían un puente de certeza matemática. Entiende las leyes y entenderás el cosmos. Aquélla era la filosofía que se escondía detrás de un modelo del tiempo atmosférico en un ordenador.
Si imaginaron a su Creador como un benévolo no intervencionista, contento de permanecer entre bastidores, los filósofos del siglo XVIII tal vez concibieron a alguien como Lorenz. Era un meteorólogo de especie singular. De faz cansada como la de un agricultor yanqui, el notable brillo de sus pupilas le daba el aire de estar riendo aun cuando no lo hiciera. En contadas ocasiones hablaba de sí y de su trabajo, pues prefería escuchar. A menudo se perdía en un reino de cálculos o de ensoñación, en que sus colegas no lograban penetrar. Sus amigos más íntimos pensaban que la mayor parte de sus horas discurrían en un espacio exterior remoto. De muchacho había sido entusiasta del tiempo, hasta el extremo de que no perdía de vista el termómetro de máxima y mínima, con el fin de registrar los altibajos de la temperatura exterior a la casa paterna, en West Hartford (Connecticut). Pero, en el interior de ella, dedicaba aún más horas a la solución de problemas y pasatiempos matemáticos, a veces con la colaboración de su padre. En cierta ocasión, toparon con uno muy complicado, que, como comprobaron, no tenía solución. Aquello era admisible, le explicó el autor de sus días: uno puede siempre resolver un problema demostrando que no puede solventarse. El juicio agradó a Lorenz, como le agradaba la pureza de las matemáticas, y cuando se graduó en el Dartmouth College, en 1938, pensó que su porvenir estaba en ellas. No obstante, mediaron las circunstancias en forma de la segunda guerra mundial, y le llevaron a trabajar como diagnosticador del tiempo para el cuerpo aéreo del ejército. Finalizada la contienda, decidió atenerse a la meteorología, investigar su teoría y abrirse camino en sus matemáticas. Cobró renombre con la publicación de una obra sobre cuestiones ortodoxas, tales como la de la circulación general de la atmósfera. Y, en el ínterin, siguió meditando sobre el pronóstico del tiempo.
Tales previsiones eran menos que una ciencia para los meteorologistas sesudos. Las enjuiciaban como una actividad adocenada desempeñada por técnicos, quienes requerían alguna intuición para prever el tiempo del día siguiente con la observación de los instrumentos y las nubes. Pura conjetura. En centros como el MIT (Massachusetts Institute of Technology), la meteorología miraba con buenos ojos los problemas que tenían solución. Lorenz comprendía lo criticable de la predicción del tiempo tan bien como cualquier prójimo, no en balde la había ejercido en pro de los pilotos militares, pero abrigaba por ella mucho interés: un interés matemático.
De la misma suerte que los meteorologistas desdeñaban los pronósticos, casi todos los científicos serios desconfiaban, por aquellas calendas, de los ordenadores. Aparatos semejantes no se concebían como auxiliares de la ciencia teórica. Por ello, la simulación numérica del tiempo era materia espuria. Pero la ocasión no podía ser más propicia para ello. La previsión meteorológica había esperado dos siglos una máquina que repitiera millares de cálculos, una y otra vez, por fuerza bruta. Sólo un ordenador podía hacer efectiva la promesa newtoniana de que el mundo se desplegaba con orientación determinista, sujeto a leyes como los planetas y predecible como los eclipses y mareas. En hipótesis, un ordenador permitiría que los meteorologistas llevaran a cabo lo que los astrónomos habían efectuado con lápiz y regla de cálculo: averiguar con procedimientos matemáticos el futuro de su universo desde sus condiciones iniciales y las leyes físicas que guían su evolución. Las ecuaciones que escribían el movimiento del aire y del agua eran tan bien conocidas como las referentes a los planetas. Los astrónomos no habían conquistado la perfección y jamás la conseguirían, no en un sistema solar trabajado por la gravedad de nueve planetas, decenas de lunas y miles de asteroides; pero los cálculos de la moción planetaria eran tan precisos, que la gente se olvidaba de que se trataba de pronósticos. Bastaba que un astrónomo dijese: «El cometa Halley reaparecerá por aquí dentro de setenta y seis años», para que pareciese un hecho, no una profecía. Previsiones numéricas deterministas trazaban cursos exactos para naves espaciales y misiles. Entonces, ¿por qué no para los vientos y nubes?
El tiempo atmosférico, aunque colosalmente más complicado, se atenía a las mismas leyes. Tal vez un ordenador, de potencia suficiente, fuese la inteligencia suprema que había imaginado Laplace, filósofo, matemático y astrónomo del siglo XVIII, en quien prendió la fiebre newtoniana de manera paradigmática. «Tal inteligencia —escribió— abarcaría en la misma fórmula los movimientos de los cuerpos más gigantescos del cosmos y los del átomo más imperceptible; para ella no habría nada incierto, y así el futuro como el pasado estarían ante sus ojos». En estos días de la relatividad de Einstein y de la incertidumbre de Heisenberg, el optimismo de Laplace resulta casi grotesco; mas buena parte de la ciencia moderna persigue el mismo sueño. Implícitamente, la misión de muchos científicos del siglo XX —biólogos, neurólogos, economistas— ha sido desmontar sus universos en los átomos más escuetos para que se sometan a sus reglas. Se ha aplicado en todas esas ciencias una especie de determinismo newtoniano. Los padres de la actual informática pensaron siempre en Laplace, y la historia de ésta y la historia del pronóstico han andado entremezcladas desde que John von Neumann diseñó sus primeras máquinas en el Institute for Advanced Study (Instituto de Estudios Avanzados), en Princeton (Nueva Jersey), en la década de 1950. Von Neumann reconoció que los modelos del tiempo serían tarea ideal para un ordenador.
Hubo siempre algo muy pequeño, tan pequeño, que los científicos se olvidaron por lo común de su existencia, algo latente en un rincón de sus filosofías como una cuenta impagada. Las medidas jamás serían perfectas. Los que marchaban bajo la bandera de Newton agitaban otra cuyo lema venía a ser más o menos: Dados un conocimiento aproximado de sus condiciones iniciales y la comprensión de la ley natural, puede calcularse el comportamiento aproximado de un sistema. Esta presunción ocupa el corazón filosófico de la ciencia. Como un teórico tenía la afición de decir a sus alumnos:
—La idea básica de la ciencia occidental es que no debemos considerar la caída de una hoja de un planeta de otra galaxia, cuando queremos explicar el movimiento de una bola en una mesa de billar de la Tierra. Puede prescindirse de las influencias mínimas. Hay una convergencia en el modo como ocurren las cosas, y pequeñas influencias arbitrarias no se hinchan hasta tener grandes efectos arbitrarios.
Desde el punto de vista clásico, estaba bien justificada la creencia en la aproximación y la convergencia. Era eficaz. Un error nimio en fijar la posición del cometa Halley en 1910 causaría sólo un minúsculo error al predecir su llegada en 1986, error que continuaría siendo insignificante en el futuro durante millones de años. Los ordenadores recurren a la misma creencia al guiar a las naves espaciales: un input aproximadamente exacto rinde un output aproximadamente exacto. Los pronosticadores económicos recurren al mismo proceder, bien que su éxito sea menos aparente. También lo hicieron los precursores en la previsión global del tiempo atmosférico.
Lorenz lo había reducido a los términos más elementales con su primitivo ordenador. Pero, línea tras línea, los vientos y las temperaturas que surgían en el papel parecían portarse de forma muy terrestre. Respondían a su intuición bien amada sobre el tiempo, su presentimiento de que se repetía, mostrando pautas familiares en las que la presión subía y bajaba, y la corriente aérea se alteraba hacia el norte y hacia el sur. Descubrió que cuando una línea iba de arriba abajo sin un salto, habría después un salto doble, y se dijo: «Es la clase de regla que resultaría útil a un pronosticador». Sin embargo, las repeticiones jamás eran idénticas. Había una pauta, con perturbaciones. Un desorden ordenado.
Lorenz inventó un rudimentario género de gráficas con el fin de que las pautas se apreciasen sin dificultad. Hizo que la máquina, en lugar de las habituales líneas de dígitos, señalara cierto número de espacios en blanco seguidos de la letra a. Seleccionaba una variable, quizá la dirección de la corriente aérea. Paulatinamente las aes recorrían el papel, moviéndose adelante y atrás en una trayectoria sinuosa, que marcaba una larga serie de colinas y valles, representativos de cómo el viento occidental oscilaba al norte y al sur a través del continente. Su regularidad, los ciclos reconocibles que aparecían y reaparecían, aunque nunca de la misma manera, estaban dotados de un poder fascinante, hipnótico. El sistema se portaba como si revelase despacio sus secretos al pronosticador.
En un día invernal de 1961, Lorenz tomó un atajo con el deseo de examinar una sucesión de modo más prolijo. Para no comenzar desde el principio, empezó a medio camino de ella. Copió los números directamente de la impresión anterior, pensando conseguir que la máquina funcionase según las condiciones iniciales, y se dirigió al vestíbulo para librarse del ruido y tomar una taza de café. Regresó una hora después y se encontró algo inesperado, algo que plantó la simiente de una ciencia desconocida.
§. El ordenador se porta mal
La nueva pasada tenía que haber sido la réplica exacta de la original. Él mismo había copiado los números. El programa no se había modificado. Pero Lorenz vio, en la nueva impresión, que su tiempo divergía tan prontamente de la pauta de la antigua pasada, que, al cabo de unos pocos meses —teóricos—, cualquier similitud se había borrado. Examinó uno de los conjuntos de números y luego el otro. El resultado era como si hubiese sacado al azar de un sombrero dos tiempos atmosféricos. Se le ocurrió al pronto que se había estropeado otro tubo de vacío.
De repente comprendió la verdad. No había desperfecto. El quid estaba en los números que había pulsado. La memoria de ordenador almacenaba seis decimales: 0,506127. En la impresión, para ahorrar espacio, aparecían únicamente tres: 0,506. Lorenz había entrado la expresión más corta, redondeada, convencido de que la diferencia —una milésima parte— era de poca importancia.
Se trataba de una suposición razonable. Si un satélite meteorológico registra la temperatura superficial del océano hasta una milésima parte, quienes lo operan se consideran afortunados. El Royal McBee de Lorenz ejecutaba el programa clásico. Utilizaba un sistema de ecuaciones estrictamente determinista. Dado un especial punto de partida, el tiempo se desarrollaría siempre del mismo modo. Dado un punto de partida levemente distinto, el tiempo se desarrollaría de modo ligeramente diferente. Un pequeño error numérico era como un imperceptible soplo de aire, pues soplos como aquéllos se extinguían o se anulaban unos a otros antes de que alteraran las condiciones importantes, a gran escala, del tiempo. Pero, en el sistema de ecuaciones de Lorenz, los errores ínfimos fueron catastróficos.
Decidió comprobar con más atención cómo dos pasadas del tiempo, casi idénticas, se manifestaban al ser parangonadas simultáneamente. Copió en una hoja transparente una de las onduladas líneas de output y la colocó sobre la otra, para cerciorarse de qué manera divergían. Al principio, dos prominencias casaron detalle por detalle. Luego, una línea empezó a alejarse un pelo. Cuando llegaron al montículo siguiente, las dos pasadas se habían desfasado de forma evidente. Al tercer o cuarto abultamiento, se había desvanecido toda semejanza.

Cómo divergen dos pautas del tiempo atmosférico.
Edward Lorenz vio que su tiempo de ordenador, a escasa distancia del punto de partida, producía pautas que se alejaban cada vez más una de otra, hasta que desaparecía cualquier semejanza. (de las separatas de Lorenz del año 1961).
—No habíamos tenido éxito en aquello y ahora se nos ofrecía una excusa —dijo—. Creo que una de las razones de la gente para pensar que serían posibles previsiones tan anticipadas era que hay fenómenos físicos que uno logra pronosticar con anticipación, como los eclipses, en los cuales la dinámica del Sol, la Luna y la Tierra es bastante complicada, o como las mareas oceánicas. Jamás concebí el pronóstico de las mareas como predicción, sino como expresión de un hecho real; pero, desde luego, se hace un vaticinio en su caso. Las mareas son tan complicadas como la atmósfera. Unas y otra tienen componentes periódicos: cualquiera predice que el próximo verano será más cálido que este invierno. Mas, en cuanto al tiempo, adoptamos la actitud de que ya sabíamos eso. En cambio, en las mareas, nos interesa la parte predecible, y la impredecible tiene poca monta, a menos que haya una tempestad.
»La persona corriente, al ver que predecimos las mareas muy bien con unos meses de antelación, se pregunta por qué no logramos hacer lo mismo con la atmósfera, que sólo es un diferente sistema de fluido, con leyes de complicación semejante. Pero he comprendido que cualquier sistema físico de comportamiento no periódico será impredecible.
§. Los pronósticos muy amplios del tiempo están condenados a desaparecer
Los años de 1950 y 1960 se caracterizaron por su optimismo irreal en lo que se refería al pronóstico del tiempo atmosférico. Los periódicos y revistas rezumaban esperanza sobre la meteorología, no sólo en lo concerniente a la predicción, sino también en lo que atañía a la modificación y el dominio. Dos técnicas maduraban codo a codo: el ordenador digital y el satélite artificial. Se preparaba un proyecto entre naciones para explotarlos, el Global Atmosphere Research Program (Programa Global de Investigación Atmosférica). Había la idea de que la sociedad humana se libraría de la agitación del tiempo y llegaría a ser su señora en lugar de su víctima. Cubrirían los campos cúpulas geodésicas. Los aeroplanos sembrarían las nubes. Los científicos aprenderían a hacer lluvia y a detenerla.
El motor intelectual de esta concepción popular fue Von Neumann, que construyó su primer ordenador con la intención, entre otras, de dominar el tiempo. Se rodeó de meteorologistas y dio charlas asombrosas sobre sus proyectos a la comunidad de los físicos. Una razón matemática específica sostenía su optimismo. Reconoció que un complicado sistema dinámico podía albergar puntos de inestabilidad, puntos críticos, en que un débil empujón llegaría a tener amplias consecuencias, como, por ejemplo, el propinado a una pelota balanceada en la cima de un monte. Von Neumann imaginó que, con el ordenador en marcha, los científicos calcularían las actuaciones del movimiento fluido en unos pocos días. Luego, un comité central de meteorologistas despacharía aviones para esparcir capas de humo o sembrar nubes, con lo que se trastocaría adecuadamente el talante del tiempo. Pero Von Neumann no había tenido en cuenta la posibilidad del caos, la inestabilidad en todos los puntos.
Hacia la década de 1980, una vasta y costosa burocracia se aplicó a ejecutar la misión de Von Neumann o, al menos, parte de ella. Los primeros pronosticadores de los Estados Unidos operaron en un ascético edificio cúbico, situado en el Maryland suburbano, cerca del cinturón de ronda de Washington, la techumbre del cual poseía un nido de observación, con radar y antenas de radio. Su superordenador se atenía a un modelo, parecido al de Lorenz sólo en el espíritu esencial. Si el Royal McBee efectuaba sesenta multiplicaciones por segundo, la velocidad de un Control Data Cyber 205 se medía en megatlops, millones de instrucciones en coma flotante en idéntica fracción temporal. Si Lorenz se había dado por satisfecho con doce ecuaciones, el moderno modelo global calculaba sistemas de quinientos mil. Además, comprendía la manera en que la humedad atraía y despedía el calor del aire al condensarse y evaporarse. Los vientos digitales adquirían forma de serranías digitales. Se recibían chorros de datos cada hora de todas las naciones de la Tierra, desde aviones, satélites artificiales y barcos. El National Meteorological Center (Centro Meteorológico Nacional) servía previsiones que ocupaban el segundo lugar entre las mejores del mundo.
Las más excelentes procedían de Reading (Inglaterra), pequeña ciudad docente, que dista de Londres una hora en coche. El European Center for Medium Range Weather Forecasts (Centro Europeo de Previsión del Tiempo de Alcance Medio) se albergaba en una modesta construcción, rodeada de árboles, del estilo genérico de las Naciones Unidas —ladrillo y vidrio—, decorada con regalos de muchos países. Se había alzado durante el apogeo del entusiasmo por el Mercado Común, cuando la mayor parte de las naciones del occidente europeo decidieron aunar su talento y sus recursos en pro de la predicción meteorológica. Los europeos atribuían su éxito a su personal joven y rotante —no pertenecía al cuerpo de funcionarios—, y a su superordenador Cray, que siempre estaba, por lo visto, un modelo por delante de su pariente americano.
El pronóstico del tiempo fue el principio, pero no, ni en sueños, el final de la actividad de emplear ordenadores en la programación de sistemas complejos. Las mismas técnicas servían a muchas clases de físicos y estudiosos de la sociedad para formular previsiones sobre cualquier cosa, desde corrientes en pequeña escala de fluidos, que interesaba a los diseñadores de hélices, hasta amplios movimientos financieros, que importaban a los economistas. De esta suerte, entre 1970 y bien entrado el decenio de 1980, el diagnóstico económico con ordenador tuvo estrecha semejanza con la predicción global del tiempo. Las simulaciones se agitaban en medio de redes de ecuaciones, en muchas ocasiones arbitrarias, destinadas a ofrecer la medida de las condiciones iniciales —presión atmosférica o afluencia de dinero— en un modelo de las tendencias futuras.
Los programadores acariciaban la ilusión de que los resultados no se distorsionaran mucho a consecuencia de los inevitables supuestos simplificadores. Cuando un modelo hacía algo verdaderamente extravagante —inundaba el Sahara o triplicaba el valor de los intereses—, los programadores revisaban las ecuaciones para que el output, la salida, estuviese de acuerdo con lo esperado. En la práctica, los modelos econométricos pecaban de lamentable ceguera sobre lo que reservaba el porvenir; pero mucha gente, de la que podía exigirse otra conducta, obraba como si prestase fe a los resultados. Se presentaban las previsiones sobre el crecimiento económico o el desempleo con una precisión de dos o tres decimales. Los gobiernos e instituciones financieras pagaban por ellas y actuaban a su tenor, bien por necesidad, bien por falta de algo mejor.
Probablemente sabían que aquellas variables, de «optimismo de consumidor», no eran tan fáciles de ponderar como la «humedad», y que aún no se habían ideado las ecuaciones diferenciales perfectas sobre los movimientos políticos y la moda. Pocos comprendieron cuán frágil era el procedimiento de simular corrientes en los ordenadores, incluso cuando los datos eran razonablemente fidedignos y las leyes físicas, como en el pronóstico del tiempo.
El modelo de ordenador había, ciertamente, logrado cambiar la cuestión meteorológica de arte en ciencia. Las evaluaciones del European Center insinuaban que el mundo ahorraba miles de millones de dólares al año gracias a predicciones que eran, estadísticamente, mejor que nada. Pero, transcurridos dos o tres días, los más notables pronósticos mundiales se convertían en especulativos, y, pasados seis o siete, en despreciables.
La razón de ello era el efecto de la mariposa. Por culpa de meteoros insignificantes —y para un pronosticador global lo son las tormentas y ventiscas—, cualquier predicción se deteriora en seguida. Los errores e imprecisiones se multiplican, abultándose como un alud, a causa de una cadena de manifestaciones turbulentas, desde tempestades de polvo y chubascos a mareas del tamaño de continentes, que sólo ven los satélites artificiales.
Los modelos actuales del tiempo trabajan con una rejilla de puntos separados unos noventa y seis kilómetros. A pesar de ello, hay que imaginar algunos datos iniciales, porque las estaciones meteorológicas y los satélites no abarcan todo. No obstante, supóngase que la Tierra se cubriese de sensores distanciados treinta centímetros, y que se alzaran con intervalos de treinta centímetros hasta lo más alto de la atmósfera. Supóngase que cada sensor proporciona informes perfectos sobre la temperatura, presión, humedad y restantes pormenores que reclama un meteorologista. Exactamente al mediodía, un ordenador infinitamente poderoso absorbe todos los datos y calcula lo que sucederá en cada punto a las 12:01, a las 12:02, a las 12:03, etc.
Con todo, el ordenador será aún incapaz de predecir si en Princeton (Nueva Jersey) reinará el sol o lloverá en el día tal del mes siguiente. Al mediodía, los espacios entre los sensores ocultarán fluctuaciones que la máquina no conocerá, mínimas desviaciones del promedio. A las 12:01 tales fluctuaciones ya habrán creado pequeños errores treinta centímetros más allá, errores que se habrán multiplicado a la escala de trescientos centímetros, y así sucesivamente, hasta adquirir la dimensión entera del globo terráqueo.
Todo ello va en contra de la intuición, aun en el caso de los meteorólogos expertos. Uno de los más viejos amigos de Lorenz era Robert White, colega suyo en meteorología en el MIT, el cual, más tarde, fue nombrado jefe de la National Oceanic and Atmospheric Administration (Administración Atmosférica y Oceánica Nacional). Lorenz le habló del efecto de la mariposa y lo que opinaba de él por su influencia en el pronóstico a largo plazo. White le dio la respuesta de Von Neumann.
—Nada de predicción —dijo—. Esto es control del tiempo.
Pensaba que las pequeñas modificaciones, que consideraba dentro de la capacidad humana, causarían los cambios deseados a gran escala.
Lorenz lo concebía de otra manera. Sí, podía modificarse el tiempo. Podía lograrse que se portara de forma distinta de lo que habría hecho de no mediar la intervención. Pero, si se hacía tal cosa, se ignoraría siempre cuál hubiese sido su comportamiento. Sería como barajar sin necesidad un mazo de naipes ya bien mezclado. Aquello cambiaría la suerte del jugador, pero jamás se sabría si para bien o para mal.
§. Orden disfrazado de azar
El descubrimiento de Lorenz fue un accidente, uno más en la hilera que se remontaba a Arquímedes y su baño. Lorenz no era de los que chillaban eureka. La casualidad no le llevó sino al lugar en que siempre había estado. Se dispuso a explorar las consecuencias de su hallazgo, y a averiguar qué significaba para el modo como la ciencia entendía los flujos o corrientes en todo género de fluidos.
Si se hubiera contentado con el efecto de la mariposa, imagen de lo predecible cediendo al puro azar, no hubiera hecho sino dar pésimas noticias. Pero vio más que azar en su modelo del tiempo: una fina estructura geométrica, orden disfrazado de casualidad. Como era en el fondo matemático con el pergeño de meteorologista, comenzó a llevar una vida doble. Escribió artículos de meteorología estricta. También escribió artículos estrictamente matemáticos, con una pequeña dosis, apenas engañadora, de tiempo como prefacio. Por último, los prefacios desaparecieron del todo.
Se dedicó cada vez más al aspecto matemático de los sistemas que jamás alcanzaban estabilidad, sistemas que casi se repetían, pero que nunca lo hacían. El mundo entero sabía que el tiempo era uno de ellos: aperiódico. Abundan en la naturaleza: poblaciones animales que se multiplican y reducen casi con regularidad, o epidemias que vienen y se van con puntualidad fascinante. Si el tiempo llegase en una ocasión a un estado idéntico a otro anterior, en que cada racha y cada nube fuesen exactas a las precedentes, podría presumirse que se repetiría en adelante sempiternamente y el problema de los pronósticos sería trivial.
Lorenz comprendió que debía de haber un eslabón entre la resistencia del tiempo a ser como antes y la incapacidad de los meteorólogos para predecirlo: un vínculo entre la aperiodicidad y la impredecibilidad. No era fácil acertar con ecuaciones sencillas que produjeran la aperiodicidad que buscaba. Al pronto, su ordenador propendió a encastillarse en ciclos repetitivos. Mas, probando diferentes clases de complicaciones menores, Lorenz tuvo al fin éxito cuando introdujo una ecuación, que varió la cantidad de calentamiento de este a oeste, correspondiente a la variación real entre la manera como el sol calienta la costa oriental de Norteamérica, por ejemplo, y el modo como caldea el océano Atlántico. La repetición se esfumó.
El efecto de la mariposa no era accidental, sino necesario. Razonó que, supuesto que las perturbaciones leves continuaran siéndolo, en lugar de crecer como una cascada progresiva a través del sistema, cuando el tiempo se aproximara arbitrariamente a un estado por el que ya hubiese pasado, seguiría estando arbitrariamente próximo a las pautas que obedecía. Desde el punto de vista práctico, los ciclos serían predecibles y acabarían por no interesar. Para producir el rico repertorio del verdadero tiempo terrestre, su bella multiplicidad, ¿se podía ansiar algo mejor que el efecto de la mariposa?
Éste adquirió nombre técnico: dependencia sensitiva de las condiciones iniciales. Esta clase de dependencia no era una noción desconocida. Existía en el folklore anglosajón:
Por un clavo, se perdió la herradura;Tanto en la ciencia como en la vida, es harto conocido que una cadena de sucesos puede encaramarse a un punto crítico que abultará los cambios insignificantes. Pero el caos denotaba que tales puntos se hallaban por doquier. Se difundían. En sistemas como el tiempo atmosférico, la dependencia sensitiva de las condiciones iniciales era consecuencia inevitable de cómo las escalas pequeñas se entrelazaban con la grande.
Por una herradura, se perdió el caballo;
Por un caballo, se perdió el jinete;
Por un jinete, se perdió la batalla;
Por una batalla, se perdió el reino.
Los colegas de Lorenz estaban atónitos de que hubiese remedado tanto la aperiodicidad, como la dependencia sensitiva de las condiciones iniciales, en su versión de juguete del tiempo: doce ecuaciones, calculadas reiteradamente, con despiadada eficiencia mecánica. ¿Cómo surgía tal plétora, tal impredecibilidad —tal caos—, de un simple sistema determinista?
§. Un mundo no lineal
Lorenz abandonó el tiempo y buscó formas incluso más sencillas de producir aquel comportamiento complejo. Encontró una en un sistema de tres ecuaciones únicas. Eran no lineales, o sea, expresaban relaciones no rigurosamente proporcionales. Las lineales pueden indicarse con una línea recta en un gráfico, y no cuesta imaginar sus relaciones: cuantas más, mejor. Son resolubles, lo cual las hace idóneas para los libros de texto. Los sistemas lineales poseen una importante virtud modular: se pueden desmontar y montar de nuevo. Las piezas siempre casan.
Los no lineales generalmente son insolubles e indesmontables. En los sistemas mecánicos y de fluidos, los términos no lineales se exponen a ser pasados por alto, cuando la gente se interesa por una interpretación sencilla y aceptable. La fricción, por ejemplo. Sin ella, una simple ecuación lineal expresa la cantidad de energía que uno requiere para acelerar el puck en un partido de hockey sobre hielo. Con la fricción, la relación se complica, porque la cantidad de cambios de energía depende de la velocidad a que el puck se mueva ya. La no linealidad implica que el acto de jugar a dicho deporte cambia las reglas de algún modo. No se puede asignar importancia constante a la fricción, pues depende de la velocidad. Y ésta, a su vez, de la fricción. Por lo tanto, la mutabilidad intrínseca hace que la no linealidad sea difícil de calcular; pero crea, asimismo, abundantes clases de comportamiento que jamás ocurren en los sistemas lineales. En la dinámica de fluidos, todo estriba en una ecuación canónica, la de Navier-Stokes, de milagrosa brevedad, referente a la velocidad, presión, densidad y viscosidad; pero es no lineal. Por ello, resulta a menudo imposible precisar la índole de esas relaciones. El análisis del comportamiento de una ecuación no lineal como la de Navier-Stokes es como recorrer un laberinto cuyas paredes cambien de posición a medida que se avanza. El propio Von Neumann dijo:
—El carácter de la ecuación… se altera simultáneamente en todos los aspectos importantes: se modifican tanto el orden como el grado. De aquí que haya que esperar graves dificultades matemáticas.
El mundo sería distinto —y la ciencia no necesitaría el caos— si la ecuación de Navier-Stokes no albergase el demonio de la no linealidad.
Una especie de movimiento de fluido inspiró las tres ecuaciones de Lorenz: el de un gas o líquido caliente, lo que se llama convección. Agota en la atmósfera el aire calentado por la tierra caldeada por el sol; y temblorosas ondas conectivas aparecen como fantasmas sobre el alquitrán y los radiadores calientes. Lorenz charló placenteramente de la que existe en una taza de café recién hecho. La describió como uno de los innumerables procesos hidrodinámicos de nuestro universo, cuya conducta futura desearíamos predecir. ¿Cómo calcularemos la velocidad a que se enfriará el café? Si está tibio, su calor se disipará sin movimiento hidrodinámico. Permanece en estado estable. Pero, si tiene elevada temperatura, el trastorno conectivo llevará el café caliente del fondo de la taza a la superficie más fría. Ello se comprueba cuando se vierten en él unas gotitas de leche. Los remolinos llegan a ser complicados. Pero es evidente el fin del sistema a largo plazo. El movimiento se detiene inevitablemente, porque el calor se disipa y porque la fricción retiene al fluido en movimiento. Lorenz aseguró con sequedad en una reunión de científicos: —Quizá nos cueste pronosticar la temperatura del café con un minuto de anticipación; en cambio, no acontecerá lo mismo si lo hacemos una hora antes.
Las ecuaciones del movimiento de una taza de café que se enfría deben reflejar el destino del sistema. Han de ser disipativas. La temperatura tiene que orientarse hacia la de la habitación, y la velocidad hacia cero.
Lorenz despojó hasta los huesos una serie de ecuaciones sobre la convección, prescindiendo de todo lo que pudiera ser ajeno a ellas y dándoles una simplicidad irreal. No quedó casi nada del modelo original, pero respetó la no linealidad. A ojos de un físico, las ecuaciones parecían fáciles. Bastaba una mirada —muchos científicos lo hicieron en años posteriores— para atreverse a afirmar: Yo puedo resolver eso.
—Sí, hay la tendencia a pensar de ese modo al verlas —dijo Lorenz tranquilamente—. Contienen algunos términos no lineales, pero uno cree que se dará con la forma de salvarlos. Sin embargo, no se puede.

Un fluido giratorio.
Si se calienta por debajo, el líquido o gas tiende a organizarse en giros cilíndricos (izquierda). El fluido caliente se eleva por un lado, pierde temperatura y desciende por el lado opuesto. Es el proceso de la convección. Si se intensifica el calor (derecha), aparece la inestabilidad, y los giros exhiben un temblor que recorre adelante y atrás la longitud de los cilindros. A temperaturas aún más elevadas, la corriente se desordena y se hace turbulenta.
Sobreviene otro comportamiento en cuanto se calienta. El fluido, caldeado en la parte inferior, se expande y, por ello, se vuelve menos denso. La pérdida de densidad lo hace más ligero, lo bastante para vencer la fricción, y sube hacia la superficie. En una caja bien diseñada, se desarrolla un cilindro, un rollo, en el que el fluido caliente asciende por un lado, y el frío desciende por el otro. Visto lateralmente, el movimiento traza un círculo continuo. La naturaleza, lejos de los laboratorios, crea a menudo sus propias celdillas de convección. Por ejemplo, cuando el sol caldea la superficie de un desierto, el aire rodante llega a formar espectrales pautas en las nubes o en la arena.
Al avivar el calor, el comportamiento se complica. Los rollos empiezan a temblar. Las esquilmadas ecuaciones de Lorenz fueron demasiado simples para modelar aquel género de complejidad. Abstraían sólo un rasgo de la convección tal como se produce en el mundo: el movimiento circular del fluido caliente, que ascendía y volteaba como una noria en un parque de atracciones. Las ecuaciones tuvieron en cuenta la velocidad de aquel movimiento y la transferencia del calor, procesos físicos que se influían recíprocamente. Cualquier pizca cálida que se remontaba por el círculo encontraba fluido más frío y, por consiguiente, comenzaba a perder calor. Si el círculo se movía con suficiente rapidez, la pizca no perdía todo el exceso de calor cuando llegaba a lo alto, y principiaba a deslizarse por el otro lado del rollo, de manera que empezaba a resistir el impulso del resto del fluido cálido que ascendía detrás de ella.
Aunque no cumpliese punto por punto el modelo de la convección, el sistema de Lorenz tuvo analogías precisas con los reales. Por ejemplo, sus ecuaciones describen con exactitud una antigua dínamo eléctrica, antepasada de los actuales generadores, en los que la corriente circula a través de un disco, el cual gira en un campo magnético. Cumpliéndose determinadas condiciones, la dínamo puede invertir su movimiento. Y algunos científicos, así que las ecuaciones de Lorenz se conocieron mejor, insinuaron que el comportamiento de la dínamo quizá proporcionase una explicación de otros fenómenos peculiares de inversión, como el del campo magnético terrestre. Se sabe que la «geodínamo» ha dado muchos saltos mortales durante la historia de la Tierra, a intervalos que se antojan excéntricos e inexplicables. Los teorizadores, ante tal irregularidad, buscan típicamente justificaciones fuera del sistema y proponen causas tales como el impacto de los meteoritos. Pero tal vez la geodínamo posea caos propio.
Otro sistema descrito con precisión por las ecuaciones de Lorenz es la rueda de agua o noria, analogía mecánica del círculo rotante de la convección. El agua cae, en la porción superior, continuamente en cangilones situados en el borde de la rueda. Cada uno se vacía por un agujerito. Si la corriente de agua es lenta, los más elevados nunca se llenan con la prontitud necesaria para vencer la fricción; cuando es rápida, el peso empieza a voltear la rueda. La rotación tiene la posibilidad de hacerse continua. O, si el caudal es tan veloz que los pesados cangilones dan la vuelta hasta el fondo y se remontan por el lado contrario, la rueda llega a menearse despacio, hasta detenerse e invertir su rotación, yendo primero en un sentido y después en otro.

La rueda de agua o noria de Lorenz.
El primero y célebre sistema caótico que descubrió Lorenz corresponde a un ingenio mecánico: la rueda de agua. Un aparato tan sencillo es capaz de un comportamiento sorprendentemente complicado. La rotación de la noria comparte propiedades de los cilindros giratorios de un fluido en el proceso de la convección. Equivale a una sección vertical de ellos. Los dos sistemas reciben impulso continuo —el del agua o el calor—, y ambos disipan energía. El fluido pierde calor; la rueda, agua de los cangilones. Y en uno y otro el comportamiento a largo plazo depende de la intensidad de la energía. El agua cae a velocidad uniforme. Si su afluencia es lenta, el cangilón superior nunca se llena lo suficiente para vencer la fricción, y la noria no gira. (De la misma manera, en el fluido, si el calor es tan débil que no vence la viscosidad, no lo pondrá en movimiento). Si la corriente es rápida, el peso del cangilón hace que la rueda se mueva (izquierda). El aparato puede adquirir una rotación que persiste a velocidad uniforme (centro). Si la corriente es más rápida todavía (derecha), la rotación puede convertirse en caótica a causa de los elementos no lineales introducidos en el sistema. A medida que pasan por debajo del agua en movimiento, los cangilones se llenan más o menos según sea la velocidad de los giros. Si la rueda los describe de prisa, los cangilones disponen de poco tiempo para llenarse. (Igualmente, el fluido que se halla en un cilindro de convección, que voltee con gran rapidez, tiene escaso tiempo para absorber calor). Asimismo, si la noria gira con velocidad, los cangilones quizá emprendan la ascensión por el lado opuesto antes de haberse vaciado. De ello resultará que los cangilones pesados del lado que sube tal vez frenen el giro y lo inviertan. Lorenz descubrió que, de hecho, durante períodos largos, el giro puede invertirse en muchas ocasiones, sin jamás adoptar velocidad estable y sin jamás repetirse conforme a una pauta predecible.
Tres ecuaciones, con otras tantas variables, describían todo el movimiento de este sistema. El ordenador de Lorenz imprimió los valores cambiantes de las tres variables: 0-10-0; 4-12-0; 9-20-0; 16-36-2; 30-66-7; 54-115-24; 93-192-74. Los tres números ascendían y descendían como intervalos marcados por un reloj imaginario, cinco, cien, mil espacios temporales.
Con el objeto de obtener una imagen con aquellos datos, Lorenz empleó cada serie de tres números como coordenadas que especificasen la situación de un punto en un espacio tridimensional. Así, la secuencia numérica produjo una de puntos que trazaba una trayectoria continua, registro del comportamiento del sistema. La trayectoria avanzaría hasta un lugar en el que se detendría, indicando que el sistema había llegado al estado estable, en el que ya no se mudarían las variables de velocidad y temperatura; o formaría una curva que giraría a la redonda demostrando que el sistema había adoptado una pauta de conducta que se repetiría de manera periódica.
Pero en el caso de Lorenz no sucedió de tal suerte. En vez de ello, el diagrama manifestó una complejidad infinita. Permanecía siempre dentro de ciertos límites, sin jamás salir del papel, pero sin nunca repetirse. Reveló una configuración extraña, característica, algo por el estilo de una espiral doble en tres dimensiones, como una mariposa con su par de alas. La figura denotó desorden puro, puesto que ningún punto, o pauta de ellos, se repetía jamás. A pesar de todo, señaló una nueva clase de orden.

Los atractores de Lorenz.
Esta imagen mágica, similar a la cara de una lechuza o a las alas de una mariposa, se convirtió en emblema de los primeros exploradores del caos. Reveló la sutil estructura que escondía una serie desordenada de datos. Según la tradición, los valores cambiantes de cualquier variable podían mostrarse en la serie temporal (arriba). Para evidenciar las relaciones mutables entre tres variables se requiere una técnica diferente. En un instante dado, las tres señalan la situación de un punto en un espacio tridimensional; así que el sistema cambia, el movimiento del punto representa las variables que se modifican continuamente. Como el sistema nunca se repite de modo exacto, la trayectoria jamás se corta a sí misma. En lugar de ello, describe curvas una y otra vez, para siempre. El movimiento del atractor es abstracto, pero comunica la esencia del movimiento del sistema real. Por ejemplo, el traslado de un ala del atractor a otra corresponde a una inversión de la dirección del giro en la noria o en el fluido que experimenta convección
Los físicos adoptaban, años más tarde, expresión pensativa cuando se referían al artículo de Lorenz sobre aquellas ecuaciones —«esa espléndida maravilla»—. Entonces se hablaba de él como si fuese un escrito antiguo que conservara secretos de la eternidad. En los miles de publicaciones que constituyeron la bibliografía técnica del caos, pocas se citaron más a menudo que «Deterministic Nonperiodic Flow» (Flujo determinista no periódico). Durante mucho tiempo, nada inspiró más ilustraciones, hasta películas, que la curva misteriosa representada al final, la espiral doble que se conoció con el nombre de atractor de Lorenz. Por vez primera, las imágenes de éste habían probado lo que significaba decir «Es complicado». La riqueza entera del caos se hallaba en ellas.
En aquella época, sin embargo, contados lo comprendieron. Lorenz lo describió a Willem Malkus, profesor de matemáticas aplicadas en el MIT, científico caballeresco, dotado de gran capacidad para apreciar como merecían las obras de sus colegas.
—Ed, sabemos, y los sabemos muy bien, que la convección de fluidos no hace eso —dijo Malkus, riéndose.
La complicación seguramente se amortiguaría, opinó, y el sistema se trocaría en movimiento uniforme, regular.
—Como es evidente, no nos dimos cuenta de la verdad —dijo Malkus una generación más tarde, años después de que hubiese construido una rueda de agua de Lorenz en su laboratorio del sótano para mostrarla a los incrédulos—. Ed no pensaba en absoluto según nuestros términos físicos. Lo hacía conforme a un modelo generalizado, o resumido, cuyo comportamiento sentía intuitivamente que era peculiar de aspectos del mundo externo. Pero no podía decírnoslo. Sólo el tiempo hizo que sospecháramos que debió de tener tal opinión.
Escasos legos comprendieron con cuánta rigidez se ha encasillado la comunidad científica en especialidades, trocándose en un acorazado con tabiques herméticos contra las filtraciones. Los biólogos tenían sobradas cosas que leer para mantenerse al corriente de la bibliografía matemática; o, más aún, los biólogos moleculares disponían de demasiada literatura para estar al corriente de lo que escribían los biólogos de la población. Los físicos poseían mejores modos de invertir su tiempo que el de hojear las revistas meteorológicas. Algunos matemáticos se habrían entusiasmado, si se hubieran enterado del descubrimiento de Lorenz; un decenio después, físicos, astrónomos y biólogos buscaban algo como aquello y en ocasiones lo descubrían de nuevo por sí mismos. Pero Lorenz era meteorologista, y a nadie se le ocurrió enterarse del caos en la página 130 del volumen 20 de Journal of the Atmospheric Sciences.

Por descontado, el esfuerzo cabal es
ponerse fuera del alcance
ordinario de lo que se llama estadística.
STEPHEN SPENDER
§. Una revolución en el modo de ver§. Una revolución en el modo de ver
§. Relojes de péndulo, «bolas espaciales» y columpios
§. El invento de la herradura
§. Un misterio resuelto: La gran Mancha Roja de Júpiter
El historiador de la ciencia Thomas S. Kuhn describe el experimento perturbador que un par de psicólogos efectuó en el decenio de 1940. Dejaban que los sujetos echaran una fugaz ojeada a naipes de la baraja francesa, uno cada vez, y se les pedía que lo nombrasen. Había trampa, como se supondrá. Algunas cartas eran erróneas. Por ejemplo, un seis de picas rojas o una reina de diamantes negros.
A ritmo veloz, los sujetos salían bien de la prueba. Nada había más sencillo. No parecían advertir la existencia de anomalías. Cuando se les mostraba un seis de picas rojas, anunciaban, ora «seis de corazones», ora «seis de picas». Comenzaron a vacilar cuando se les enseñaron a intervalos más espaciados. Notaron que había algo raro, pero no estaban seguros de qué era. Alguno decía que había notado algo anómalo, como, verbigracia, un corazón negro ribeteado de encarnado.
Por fin, al hacerse más lenta la exhibición, la mayor parte de los sujetos alcanzó a distinguir la realidad. Vio los naipes falsos y efectuó la enmienda mental para no incurrir en equivocaciones. Pero no todos. Algunos experimentaron una sensación de desconcierto que les acarreó auténtico dolor.
—No conseguí entender ese palo, sea cual fuere —dijo uno—. Ni siquiera me pareció un naipe. Ignoro ahora de qué color es, y si se trata de una pica o un corazón. Incluso no estoy seguro de cómo es una pica. ¡Cielo santo!
Los científicos profesionales, a los que se presentan vistazos breves e inciertos de las actividades de la naturaleza, están asimismo indefensos y expuestos a la angustia y la confusión cuando se enfrentan con algo incongruente. Y la incongruencia, si cambian su manera de ver, posibilita los progresos más trascendentales. Tal es el argumento de Kuhn, y la historia del caos sugiere lo mismo.
Las ideas de Kuhn sobre cómo trabajan los científicos y cómo sobrevienen las revoluciones despertaron tanta hostilidad como admiración cuando las publicó por primera vez, en 1962. Desde entonces no se ha apagado la controversia. Clavó una aguja aguda en la opinión tradicional de que la ciencia progresa por acumulación de conocimientos, de que cada hallazgo se suma al precedente, y de que nuevas teorías emergen cuando lo requieren nuevos hechos experimentales. Deshinchó el parecer de que la ciencia es el proceso ordenado de formular preguntas y acertar con respuestas. Hizo resaltar el contraste entre el volumen de lo que hacen los científicos, esforzándose en los problemas, legítimos y bien entendidos, de sus disciplinas, y el trabajo excepcional, heterodoxo, que provoca las revoluciones. Logró, de manera nada casual, que los científicos dejaran de parecer racionalistas perfectos.
De acuerdo con la tesis de Kuhn, la ciencia corriente consiste sobre todo en operaciones de limpieza. Los experimentalistas ejecutan versiones modificadas de experimentos efectuados muchas veces anteriormente. Los teóricos añaden un ladrillo aquí, retocan una cornisa allí, en una pared de teoría. Apenas podría ser de otra forma. Si todos hubieran de comenzar desde el principio, poniendo en tela de juicio los supuestos fundamentales, se verían en un apuro para llegar al nivel de refinamiento técnico imprescindible que lleva a las obras útiles. En la época de Benjamin Franklin, el puñado de sabios que intentaba comprender la electricidad podía seleccionar sus principios básicos. Más aún, tenía que hacerlo. Un investigador quizá pensara que la atracción era lo principal del efecto eléctrico, y que la electricidad era algo así como un «efluvio» que brotaba de la materia. Otro tal vez la concibiera como un fluido, transportado por material conductor. Aquellos científicos hablaban casi con igual facilidad tanto al lego como entre ellos mismos, porque no habían llegado a la situación en que se aceptara un léxico especializado, compartido por ellos, para referirse a los fenómenos que estudiaban. En contraste, un estudioso de la dinámica de los fluidos, en el siglo XX, no avanza en el conocimiento de su disciplina si no adopta un cuerpo de terminología y técnica matemática. A cambio de ello, renuncia, inconscientemente, a casi toda la libertad necesaria para cuestionar los fundamentos de su saber.
Ocupa el centro de la concepción de Kuhn la visión de la ciencia normal como la tarea de resolver problemas, la clase de problemas que el estudiante conoce desde el instante en que abre los libros de texto. Son los que definen un estilo aceptado de consecuciones que guía a la generalidad de los científicos durante los estudios universitarios, la tesis doctoral y la redacción de artículos para las revistas adecuadas; el estilo que forja las carreras académicas. «En condiciones normales, el investigador científico es no un innovador, sino un desentrañador de rompecabezas, y los rompecabezas en que se concentra son precisamente aquellos que cree definibles y resolubles dentro del ámbito de la tradición científica existente», escribió Kuhn.
Hay, después, revoluciones. Una ciencia nace de otra que ha llegado a un callejón sin salida. Con frecuencia la revolución tiene carácter interdisciplinario: sus descubrimientos centrales se deben a menudo a personas que salvan las fronteras establecidas de sus especialidades. Los problemas que obsesionan a esos teóricos no se reconocen como líneas legítimas de investigación. Se rechazan sus propuestas de tesis doctorales o se niega la publicación de sus artículos. Los propios teóricos no están seguros de reconocer una respuesta si la encontraran. Aceptan riesgos en sus carreras. Unos pocos librepensadores, que trabajan a solas, incapaces de explicar cuál es su meta, temerosos de revelar a sus colegas lo que hacen… Es la imagen romántica que anida en el meollo del esquema de Kuhn, y eso ha acontecido en la realidad, en repetidas ocasiones, durante la exploración del caos.
Cuantos científicos se volvieron a él en fecha temprana pueden hablar de desaprobación o de hostilidad declarada. Los estudiantes graduados fueron apercibidos de que pondrían sus carreras en un aprieto, si componían tesis emparentadas con una disciplina no sancionada, en la que sus mentores no eran expertos. Un físico atómico, al enterarse de la nueva matemática, podía entretenerse con ella motu proprio, atraído por su belleza, por su belleza y dificultad, pero jamás sería lo suficientemente osado para hablar de ello a sus compañeros. Los profesores más entrados en años creían que sufrían algo semejante a una crisis propia de la edad madura, cuando se aventuraban en un linaje de investigación que muchos de sus colegas interpretarían mal o que les agraviaría. Pero, al propio tiempo, experimentaban la excitación intelectual que se deriva de lo verdaderamente nuevo. Incluso la sentían los profanos, los que armonizaban con la tendencia. Para Freeman Dyson, del Institute for Advanced Study, las noticias del caos fueron «como una descarga eléctrica» en el decenio de 1970. Otros imaginaron que, por primera vez en su vida profesional, presenciaban un cambio paradigmático, una transformación en el modo de pensar.
Quienes reconocieron el caos desde el principio se debatieron en la agonía de cómo dar forma publicable a sus pensamientos y hallazgos. La tarea era ambigua: demasiado abstracta para los físicos y demasiado experimental para los matemáticos, por ejemplo. Algunos abarcaron lo revolucionario de la naciente ciencia gracias a la dificultad de comunicar las nuevas ideas y a la feroz resistencia que oponían las huestes tradicionalistas. Las nociones someras se asimilan; las que obligan a la gente a reorganizar su imagen del mundo provocan hostilidad. Joseph Ford, del Georgia Institute of Technology (Instituto Tecnológico de Georgia), citó a Tolstoi: «Sé que la mayor parte de los hombres, incluidos los que se encuentran a sus anchas ante problemas enrevesadísimos, en raras ocasiones aceptan la verdad más sencilla y evidente, si les obliga a confesar la falsedad de las conclusiones que se han deleitado en exponer a sus colegas, que han enseñado a otros y que han urdido, hilo tras hilo, en la textura de sus vidas».
Muchos científicos tradicionales se enteraron sólo de modo vago de la ciencia que despuntaba. Varios, que cultivaban la dinámica de los fluidos, se resintieron activamente. De momento, las pretensiones de quienes defendían el caos tuvieron un timbre disparatado y acientífico. Y se apoyaba en matemáticas que parecían inconvencionales y arduas.
A medida que los especialistas del caos proliferaron, algunos departamentos pusieron mala cara a aquellos eruditos descarriados; otros pidieron más. Ciertas revistas establecieron reglas no escritas contra el sometimiento al caos; otras, en cambio, vieron el día exclusivamente para tratar de él. Los caoticistas o caólogos (palabras como éstas sonaron) comparecieron con frecuencia desproporcionada en las listas anuales de plazas pensionadas y premios importantes. Un proceso de difusión académica había situado, mediados los años de 1980, a especialistas del caos en cargos influyentes dentro de las administraciones universitarias. Se fundaron centros e institutos para especializarse en «dinámicas no lineales» y «sistemas complejos».
El caos se ha transformado no sólo en teoría, sino en método; no sólo en un canon de creencias, sino en una forma de hacer ciencia. Ha creado una técnica privativa en el empleo de ordenadores, la cual no exige la enorme velocidad de los Crays y Cybers: prefiere terminales modestos, que permiten la interacción flexible. Se ha convertido en una ciencia experimental para investigadores y matemáticos, en la que el ordenador sustituye los laboratorios repletos de tubos de ensayo y microscopios.
—Para el matemático es un masoquismo trabajar sin imágenes —dijo un perito en el caos—. ¿Cómo verá la relación entre el movimiento y esto? ¿Cómo desarrollará la intuición?
Algunos llevan a cabo su trabajo negando explícitamente que se trata de una revolución; otros aprovechan el vocabulario de Kuhn de mudanzas paradigmáticas, con el fin de describir las alteraciones que presencian.
Los primeros artículos sobre el caos recordaron, en cuanto al estilo, la época de Benjamin Franklin, puesto que regresaron a los principios originales. Kuhn comenta que las ciencias establecidas dan por supuesto una masa de conocimientos, la cual sirve en la investigación como punto de partida para todos. Para no aburrir a sus colegas, los científicos comienzan y terminan rutinariamente sus publicaciones con cosas esotéricas. Contrastaron con ello los artículos sobre el caos, aparecidos en los últimos años de la década de 1970, por su tono evangélico, desde los preámbulos a las peroraciones. Proclamaban credos desconocidos y solían concluir con frases estimulantes. Estos resultados se manifiestan como algo emocionante y sumamente provocativo. Principia a dibujarse una imagen teórica de la transición a la turbulencia. El corazón del caos es accesible para las matemáticas. El caos presagia el porvenir de modo indiscutible. Más, para aceptar el futuro, hay que renunciar a buena parte del pasado.
Nuevas esperanzas, estilos nuevos y, más importante aún, nueva forma de ver. Las revoluciones no se declaran paulatinamente. Una interpretación de la naturaleza reemplaza a otra. Se entienden los antiguos problemas bajo una luz hasta entonces ignorada y otros se reconocen por primera vez. Sucede algo que es como si toda una industria cambiase todos sus útiles para fabricar productos novedosos. Como lo describe Kuhn: «Es algo así como si la comunidad profesional hubiese sido transportada de repente a otro planeta, en el que los objetos familiares se contemplasen de forma diferente y a ellos se sumasen, al propio tiempo, otros desconocidos»
§. Relojes de péndulo, «bolas espaciales» y columpios
La rata de laboratorio de la nueva ciencia fue el péndulo: emblema de la mecánica clásica, ejemplo de actividad contenida y epítome de regularidad cronométrica. Una pesa en forma de lenteja se halla al cabo de una péndola. ¿Hay algo más distante de la extravagancia de la turbulencia?
Como Arquímedes su baño y Newton su manzana, Galileo tuvo, según la leyenda tan decantada como sospechosa, una lámpara de iglesia, que oscilaba de acá para allá, una y otra vez, sin tregua, enviando un monótono mensaje a su consciencia. Christian Huygens hizo de la predectibilidad del péndulo el medio de marcar el tiempo y puso a la civilización occidental en un camino sin retorno.
Foucault, en el Panthéon de París, utilizó uno de veinte pisos de alto para demostrar la rotación terrestre. Todos los relojes de pared y de muñeca (hasta la era del cuarzo vibrador) se fiaron de péndulos de tamaño y configuración variables. En el espacio, exento de fricción, el movimiento periódico se tiene en las órbitas de los cuerpos celestes; pero en la Tierra cualquier oscilación regular se debe a algún pariente del péndulo. Los circuitos electrónicos básicos se describen con ecuaciones que son, puntualmente, las mismas que importan a la lenteja pendular. Las oscilaciones electrónicas son millones de veces más raudas, pero idénticas a él desde el punto de vista físico. No obstante, hacia el siglo XX, la mecánica clásica se reservaba para las aulas y los proyectos rutinarios de ingeniería.
Los péndulos decoraron los museos de ciencia y animaron las tiendas de regalos de los aeropuertos en forma de «bolas espaciales» rotantes de plástico. Ningún físico se molestaba en investigarlos.
Sin embargo, ocultaban sorpresas. Se transformaron en piedra de toque, como lo habían sido para la revolución de Galileo. Aristóteles, al observar el péndulo, veía un peso que intentaba dirigirse a la tierra y que se balanceaba por ello con violencia de un lado a otro, porque lo impedía su cuerda. A oídos actuales eso suena a tontería. Para quien ha sido educado en los conceptos clásicos de movimiento, inercia y gravedad, resulta difícil apreciar la consecuente visión del mundo que acompañaba al modo aristotélico de entender el péndulo. El movimiento físico, según Aristóteles, no era ni una cantidad ni una fuerza, sino un cambio, como lo es el crecimiento de un individuo. Un peso que cae busca nada más que su estado más natural, el estado que alcanzará si se le abandona a sí mismo. Dentro de su contexto, la opinión de Aristóteles no era disparatada. En cambio, Galileo, al contemplar un péndulo, percibía una regularidad que podía medirse. Explicarla requería una manera revolucionaria de entender los objetos en movimiento. Galileo aventajaba a los antiguos griegos, pero no en la posesión de datos mejores. Antes bien, su idea de medir con precisión la continuidad de los desplazamientos del péndulo fue la de reunir a algunos amigos que contaran las oscilaciones durante un período de veinticuatro horas: un experimento de trabajo intensivo. Galileo percibió la regularidad porque había formulado ya una teoría que la predecía. Entendió lo que Aristóteles no consiguió comprender: que un objeto móvil tiende a mantenerse en movimiento, que un cambio de velocidad o dirección sólo resulta explicable por una fuerza externa, como la fricción.
Y, tan poderosa era su teoría, que vio regularidad donde no la había. Aseveró que un péndulo de longitud dada no sólo mantiene con precisión el tiempo, sino que lo conserva invariable sin importar cuán amplio o estrecho sea el ángulo de su oscilación. Uno que se balancee con gran amplitud debe recorrer más espacio, pero lo salva con velocidad mayor. O sea, su período es independiente de su amplitud. «Si dos amigos se ponen a contar las oscilaciones, uno las amplias y otro las estrechas, comprobarán que contarán no sólo decenas, sino centenares, sin discordar en una o en una porción de una». Galileo expresó su afirmación en términos experimentales, mas la teoría la hizo convincente, tanto, que se enseña todavía como el evangelio en los cursos de física de las escuelas superiores. Pero es errónea. La regularidad que Galileo observó no pasa de ser una aproximación. El cambio de ángulo del movimiento del peso crea en las ecuaciones una leve no linealidad. Cuando la amplitud es baja, apenas existe error. Pero lo hay, y puede medirse hasta en un experimento tan rudimentario como el que Galileo describe.
Podían despreciarse con facilidad las no linealidades pequeñas. Quienes efectúan experimentos aprenden en seguida que viven en un mundo imperfecto. La búsqueda de la regularidad en los experimentos ha sido fundamental en los siglos transcurridos desde Galileo a Newton. Se buscan cantidades que permanecen inalterables, idénticas, u otras que son cero. Pero eso significa pasar por alto minúsculos defectos, pizcas irregulares, que estropean la lisura del panorama. Si encuentra dos sustancias que un día tienen la proporción constante de 2,001, y de 2,003 al siguiente, y de 1,998 al tercero, será majadero el químico que no busque una teoría justificativa de la proporción perfecta de dos a uno.
Para lograr resultados impecables, también Galileo hubo de despreciar no linealidades de las que tenía conocimiento: la fricción y la resistencia del aire. Ésta es una notoria molestia experimental, una complicación que hay que podar para llegar a la esencia de la nueva ciencia de la mecánica. ¿Cae una pluma tan rápidamente como una piedra? La experiencia con objetos que descienden da respuesta negativa. Que Galileo dejara caer balas de cañón desde la cima de la torre de Pisa es una patraña, la historia de cómo se cambian las intuiciones con la invención de un mundo científico ideal, en el que las regularidades son separables del desorden de la experiencia.
Aislar los efectos de la gravedad en una masa determinada de los efectos de la resistencia del aire fue brillante proeza intelectual. Permitió que Galileo se acercara a la esencia de la inercia y el impulso. A pesar de ello, los péndulos del mundo real hacen exactamente lo que predijo el pintoresco paradigma de Aristóteles. Se detienen.
Al sentar los cimientos del nuevo cambio paradigmático, los físicos comenzaron a enfrentarse con lo que muchos interpretaron como una deficiente educación en sistemas sencillos tales como el péndulo. En los alrededores de este siglo, se reconocieron los procesos disipativos como la fricción y los estudiantes aprendieron a incluirlos en sus ecuaciones. Aprendieron también que los sistemas no lineales acostumbraban ser insolubles, y no se equivocaban, y que propendían a ser excepciones, lo que no era verdad. La mecánica clásica describía el comportamiento de una suma de objetos móviles, péndulos y dobles péndulos, muelles espirales, varas dobladas, y cuerdas tañidas y encorvadas. Las matemáticas se aplicaban a los sistemas fluidos y eléctricos. Casi nadie, en la era clásica, sospechaba que el caos podía agazaparse en sistemas dinámicos si se concedía lo debido a la no linealidad.
Un físico no entendía a fondo la turbulencia o la complejidad a menos que comprendiera los péndulos, y los comprendiera de modo inaudito en la primera mitad del siglo XX. Así que el caos empezó a unir el estudio de los diferentes sistemas, la dinámica pendular se amplió hasta abarcar técnicas refinadas, que iban desde el láser a las conexiones superconductoras de Josephson. Había reacciones químicas de comportamiento pendular, el cual también se mostraba en el latido del corazón. Las inesperadas posibilidades se extendían, escribió un físico, a «la medicina fisiológica y psiquiátrica, la previsión económica, y, acaso, la evolución de la sociedad».
Pensemos en un columpio. Se acelera al bajar y pierde velocidad al subir, y mientras tanto cede algo de rapidez por culpa de la fricción. Recibe un empujón regular, supongamos que de algún mecanismo de relojería. La intuición nos dice que, dondequiera que empiece el balanceo, el movimiento acabará por convertirse en pauta regular —adelante y atrás—, en la que el columpio llegará siempre a la misma altura. Es posible. Pero, por extraño que parezca, el movimiento también puede hacerse inconstante, primero alto, luego bajo, sin jamás convertirse en estado estable y sin jamás repetir puntualmente la pauta de las oscilaciones antes ejecutadas.
Este comportamiento, sorprendente y caprichoso, emana de una desviación no lineal de la corriente de energía en el interior de este oscilador sencillo y fuera de él. El columpio es moderado e impulsado: aquello porque la fricción intenta pararlo y esto porque recibe empuje periódico. Incluso cuando un sistema moderado e impelido está en equilibrio no se halla en equilibrio. El mundo está lleno de ellos, empezando por el tiempo atmosférico, que moderan la fricción del aire en movimiento, el agua y el calor, que se disipa hacia el espacio exterior, y que impulsa el constante empuje de la energía solar.
La impredecibilidad, empero, no fue el motivo de que los físicos y matemáticos tomaran otra vez en serio los péndulos en los años sesenta y setenta. Sirvió sólo de toque de atención. Los que estudiaban las dinámicas caóticas descubrieron que el proceder desordenado de sistemas sencillos actuaba como un proceso creativo. Generaba complejidad: pautas de rica organización, bien estables, bien inestables, ya finitas, ya infinitas, pero provistas siempre de la fascinación de las cosas vivas. Por tal razón, los científicos se dedicaron al estudio de juguetes.
Uno de ellos, vendido con el nombre de «bolas espaciales» o «trapecio espacial», se compone de un par de esferas colocadas en los extremos de una barrita, dispuesta como la tilde de la te sobre un péndulo, con otra esfera, más pesada, como lenteja. Esta bola se balancea, mientras la barrita superior gira libremente. Las tres esferas contienen pequeños imanes, y, una vez iniciado el movimiento, el juguete sigue su marcha, gracias a un electromagneto, alimentado con una pila eléctrica que hay en la base. El aparato percibe el acercamiento de la bola inferior y le propina al pasar un leve impulso magnético. En ocasiones el artificio hace gala de balanceo rítmico continuo; en otras, su movimiento se vuelve caótico, pues cambia de modo constante y siempre asombroso.
Otro juego común es el llamado péndulo esférico, cuya libertad le permite oscilar en cualquier sentido. Tiene pequeños imanes alrededor de la base. Son ellos los que atraen la pesa, cuando el péndulo se para, habrá sido capturada por uno. El propósito del juego consiste en provocar la oscilación y adivinar qué imán la apresará. Aunque haya sólo tres imanes, situados en triángulo, resulta imposible vaticinar el movimiento del péndulo. Oscilará durante un rato entre A y B, se mudará luego a B y C, y después, cuando parece detenerse en C, regresará a A. Supóngase que un científico estudia sistemáticamente el comportamiento de este pasatiempo, trazando un diagrama, como sigue: Elige un punto de partida; sujeta la pesa sobre él y la suelta; colorea el punto de rojo, azul o verde, según el imán que se apodere de la pesa. ¿Qué aspecto tendrá el gráfico? Habrá en él regiones rojas, azules o verdes compactas, como es de esperar, regiones en las que la pesa se balanceará concretamente hacia un imán dado. Pero también puede haber unas en que los colores se mezclen con infinita complicación. Junto a un punto rojo, por muy cerca que se mire, por mucho que se agrande el diagrama, habrá puntos verdes y azules. El destino de la pesa es imposible de adivinar.
Un estudioso de la dinámica creerá, por tradición, que escribir las ecuaciones de un sistema equivale a entender éste. ¿Hay forma mejor de captar sus rasgos esenciales? En el caso de un columpio o de un juguete, las ecuaciones enlazan el ángulo, velocidad, fricción e impulso motor del péndulo. Pero, a consecuencia de las migajas de no linealidad latentes en tales ecuaciones, el estudioso sufrirá la impotencia de no poder contestar la pregunta práctica más fácil sobre el futuro del sistema. Un ordenador resolverá el problema con la simulación, calculando en un abrir y cerrar de ojos cada ciclo. Mas la simulación acarrea un problema propio: la minúscula imprecisión incluida en cada cálculo se impone velozmente, porque se trata de un sistema con dependencia sensitiva de las condiciones iniciales. No tarda mucho en desaparecer la señal y lo único que queda es ruido parásito.
¿De veras? Lorenz había encontrado impredecibilidad, pero también pauta. Otros descubrieron asomos de estructura en comportamientos aparentemente casuales. El ejemplo del péndulo podía desdeñarse, pero quienes no lo hicieron hallaron un mensaje provocativo. Comprendieron que, en algún sentido, la física entendía a la perfección los mecanismos básicos del movimiento pendular, pero no podía ampliar tal entendimiento a un plazo más largo. Las piezas microscópicas eran de claridad meridiana; el comportamiento macroscópico quedaba envuelto en el misterio. La tradición de considerar localmente los sistemas —aislando los mecanismos y sumándolos después— comenzaba a quebrarse. En lo que concernía a los péndulos, fluidos, circuitos electrónicos y lásers, el reino de las ecuaciones fundamentales no se presentaba ya como la especie de conocimiento idóneo.
Durante el transcurso de la década de 1960, hubo científicos que realizaron descubrimientos paralelos al de Lorenz, por ejemplo, un astrónomo francés al analizar las órbitas galácticas y un ingeniero eléctrico japonés al modelar circuitos electrónicos. Pero el primer intento deliberado y coordinado de comprender cómo difería la conducta global de la local se debió a los matemáticos. Entre ellos figuró Stephen Smale, de la Universidad de California, en Berkeley, célebre por haber descifrado los problemas más esotéricos de la topología pluridimensional. Un físico joven, durante una conversación superficial, le preguntó en qué trabajaba. La respuesta le dejó atónito: «En osciladores». Era absurdo. Los osciladores —péndulos, muelles o circuitos eléctricos— eran cosas que los físicos dejaban atrás al principio de su formación. Demasiado fáciles. ¿Por qué un gran matemático estudiaría física elemental? Discurrieron los años antes de que el joven se diera cuenta de que Smale se ocupaba de osciladores no lineales, caóticos, y que veía en ellos cosas que los físicos no habían aprendido a ver.
§. El invento de la herradura
Smale se equivocó en su conjetura. Propuso en los términos más rigurosamente matemáticos que casi todos, por no decir todos, los sistemas dinámicos se inclinaban casi siempre a adoptar un comportamiento no muy extraño. Pronto averiguó que las cosas no eran tan sencillas.
Era un matemático que no sólo resolvía problemas, sino también preparaba programas de ellos para que los solucionaran otros. Su conocimiento de la historia y su intuición de la naturaleza se resumían en la habilidad de anunciar, sin alardes, que un área intacta aún merecía la atención de los matemáticos. Como un próspero hombre de negocios, calculaba los riesgos y planeaba fríamente su estrategia, y, además, disfrutaba de un encanto semejante al del flautista de Hamelin. Muchos iban en la dirección que él tomaba. Su reputación no se reducía a las ciencias exactas. En los primeros momentos de la guerra de Vietnam, organizó con Jerry Rubin «Días Internacionales de Protesta» y patrocinó los esfuerzos destinados a impedir que los trenes con soldados cruzaran California. En 1966, mientras el Comité de Actividades Antiamericanas del Congreso trataba de convocarle para que declarase, viajó a Moscú para asistir al Congreso Internacional de Matemáticos. En aquella ciudad recibió la Medalla Fields, el galardón más grande de su profesión.
Lo ocurrido en Moscú en aquel verano se transformó en parte indeleble de la leyenda de Smale. Se habían congregado cinco mil matemáticos agitados y agitadores. Las tensiones políticas eran intensas. Circulaban las peticiones. Se avecinaba el fin del congreso, cuando Smale, a petición de un periodista del Vietnam del Norte, dio una conferencia de prensa en la amplia escalinata de la Universidad de Moscú. Empezó condenando la intervención estadounidense en Vietnam; pero, en el instante en que los anfitriones principiaban a sonreír, condenó asimismo la invasión soviética de Hungría y la falta de libertad política en la URSS. En cuanto hubo pronunciado la última palabra, le metieron en un santiamén en un auto para que los policías soviéticos le interrogasen. De vuelta a California, la National Science Foundation (Fundación de la Ciencia Nacional) anuló su subvención.
La Medalla Fields que recibió Smale premiaba un famoso trabajo suyo sobre topología, rama de las matemáticas que ha florecido en el siglo XX y que tuvo particular apogeo en el decenio de 1950. Estudia las propiedades que siguen inalteradas cuando las formas se desfiguran por torsión, extensión o compresión. No se interesa en si la forma es cuadrada o redonda, grande o pequeña, porque la deformación cambia tales atributos. Los topólogos se preocupan de si está acoplada, tiene agujeros o está anudada o enredada. Conciben las superficies, no en los universos euclídeos unidimensional, bidimensional y tridimensional, sino en espacios de dimensiones múltiples, imposibles de imaginar de manera visible. La topología es la geometría en trozos de goma. Se preocupa de lo cualitativo más que de lo cuantitativo. Se pregunta qué puede decirse de la estructura total, cuando se ignoran las medidas. Smale había solventado uno de los problemas históricos, sobresalientes, de la topología, la conjetura de Poincaré sobre espacios de cinco o más dimensiones, y al hacerlo se convirtió en un personaje en la especialidad. A pesar de ello, en la década de 1960, renunció a la topología por un territorio inexplorado. Se puso a estudiar los sistemas dinámicos.
La topología y dichos sistemas se remontan a Henri Poincaré, que los tenía por las dos caras de la misma moneda. A fines del siglo pasado, fue el último gran matemático que aportó imaginación geométrica para tratar de las leyes del movimiento en el mundo físico. Fue el primero en darse cuenta de la posibilidad del caos; sus escritos insinuaron una especie de impredecibilidad casi tan acusada como la que Lorenz había descubierto. Muerto Poincaré, floreció la topología y se atrofiaron los sistemas dinámicos. Hasta el nombre cayó en desuso; la materia a la que Smale se encaminó nominalmente eran las ecuaciones diferenciales, las cuales describen cómo cambian los sistemas de modo continuo a lo largo del tiempo. Por tradición, tales cosas se buscaban de manera local, por lo que ha de entenderse que los ingenieros y físicos consideraban sólo un grupo de posibilidades tras otro. Smale, como Poincaré, quería comprenderlas en su totalidad, quería comprender todo el reino de posibilidades sin distingos.
Cualquier conjunto de ecuaciones que describa un sistema dinámico —el de Lorenz, por ejemplo— permite establecer al principio ciertos parámetros. En el caso de la convección térmica, uno concierne a la viscosidad del fluido. Grandes cambios en los parámetros pueden implicar importantes diferencias en un sistema, como, por ejemplo, la que hay entre llegar a un estado estable y oscilar periódicamente. Los físicos daban por sentado que cambios pequeñísimos introducirían sólo pequeñísimas diferencias en las cifras, y no alteraciones cualitativas en el comportamiento.
Relacionando la topología y los sistemas dinámicos, cabe la posibilidad de usar una forma que ayude a visualizar toda la esfera de comportamientos de un sistema. Uno sencillo puede representarse con algún género de superficie curva; uno complicado, con una pluridimensional. Un punto único en tal clase de superficie indica el estado de un sistema en un instante quieto en el tiempo. A medida que el sistema progresa temporalmente, el punto se mueve, trazando una órbita en tal superficie. El hecho de curvar un poco la forma equivale a cambiar los parámetros del sistema, haciendo un fluido más viscoso o meneando un péndulo con fuerza algo mayor. Las formas que se parecen de manera amplia tienen, en sentido lato, un comportamiento similar. Si se consigue visualizar la fuerza, se entiende el sistema.
En las fechas en que Smale se encaró con los sistemas dinámicos, la topología, como la mayor parte de las matemáticas puras, se ejercitaba con manifiesto desdén de las aplicaciones mundanales. Sus orígenes habían sido cercanos a la física, pero los matemáticos se olvidaron de tal circunstancia y las formas se estudiaron por sí mismas. Smale creía firmemente en la bondad de este proceder —era el más puro de los puros—; pero tenía la idea de que el desarrollo abstracto, esotérico, de la topología tal vez aportase algo a la física, como Poincaré lo había entendido hacía ya muchos años.
Sin embargo, una de sus primeras contribuciones fue una conjetura deficiente. Propuso en términos físicos una ley natural del jaez siguiente: Un sistema puede portarse de modo irregular, pero ese comportamiento variable no será estable. La estabilidad —«estabilidad en la acepción de Smale», decían en ocasiones los matemáticos— era una propiedad crucial. El comportamiento estable era aquel que no desaparecía cuando un número se modificaba un pelillo. Todo sistema podía albergar las conductas estable e inestable. Las ecuaciones referentes a un lápiz que se mantiene de pie sobre la punta logran buena solución matemática, si el centro de gravedad está directamente sobre dicho extremo; pero no se consigue colocar el lápiz de ese modo, porque la solución es inestable. La menor perturbación aleja el sistema de ella. Por otro lado, una canica permanece en el fondo de una taza, porque, si se la mueve un poco, rueda y nada más. Los físicos imaginaron estable todo comportamiento que observaban dotado de regularidad, pues son inevitables en los sistemas reales minúsculas perturbaciones e incertidumbres. Jamás se saben los parámetros con exactitud. Razonaron que, si se quiere un modelo físicamente realista y sólido frente a leves alteraciones, ha de buscarse uno estable.
Las malas noticias llegaron por correo, algo después de la Navidad de 1959. Entonces, Smale vivía en un piso de Río de Janeiro con su esposa, dos hijos de corta edad y una inundación de pañales. Su conjetura había definido una clase de ecuaciones diferenciales que, sin excepción, eran estables desde el punto de vista estructural. Cualquier sistema caótico, aseguraba, podía representarse por uno de su clase. No era así. Un colega le informó por carta que muchos sistemas no eran tan fáciles como él había imaginado, y describía como ejemplo contradictorio uno que encerraba en su seno la estabilidad y el caos. Era sólido. Si se le perturbaba un poquillo, como todo sistema natural lo es constantemente por el ruido, su rareza no desaparecía. Sólido y raro. Smale leyó la carta con una incredulidad que se disipó poco a poco.
El caos y la inestabilidad, conceptos que entonces empezaban a tener definiciones precisas, no eran lo mismo. Un sistema caótico sería estable si un linaje particular de irregularidad persistía frente a pequeñas perturbaciones. El de Lorenz era uno de ellos, aunque transcurrirían años antes de que Smale oyese hablar del meteorologista. El caos que éste había descubierto, a pesar de su impredecibilidad, era tan estable como la canica en la taza. Se le podía añadir ruido, sacudirlo, agitarlo e interferir en su movimiento, y cuando todo hubiese cesado, y lo transitorio se amortiguase como los ecos en una serranía, recuperaría la misma pauta de irregularidad. En suma, era localmente impredecible y globalmente estable. Los sistemas dinámicos reales se atenían a una porción más complicada de reglas de lo que había imaginado. El ejemplo que el colega de Smale describió en su carta era otro sistema sencillo, descubierto hacía más de una generación y del todo olvidado. Quiso la casualidad que fuese un péndulo disfrazado: un circuito electrónico oscilante. Era no lineal y se le compelía de manera periódica, como un niño en un columpio.

Retratos en el espacio de fases.
Las series temporales, tradicionales (arriba), y las trayectorias en el espacio de fases (abajo), son dos formas de poner de manifiesto los mismos datos y de conseguir una imagen del comportamiento a largo plazo de un sistema. El primer sistema (izquierda) converge en un estado estable, un punto en el espacio de fases. El segundo se repite de forma periódica, formando una órbita cíclica. El tercero se reitera en un ritmo de vals más complejo, un ciclo de «período tres». El cuarto es caótico.

La herradura de Smale.
Esta transformación topológica proporcionó una base para comprender las propiedades caóticas de los sistemas dinámicos. Expuesta de modo elemental: Un espacio se estira en una dirección, se aprieta en otra y se dobla. Cuando se repite, el procedimiento produce una especie de mezcla estructurada, que reconocerá quien haya heñido una masa de harina. Dos puntos que acaban por estar contiguos acaso estuvieron muy separados al principio.
A despecho de ser errónea, su conjetura puso a Smale directamente en el camino de un nuevo modo de concebir la entera complejidad de los sistemas dinámicos. Varios matemáticos habían revisado las posibilidades del oscilador de Van der Pol. Smale trasladó su trabajo a un terreno distinto. Su única pantalla osciloscópica se hallaba en su mente, pero ésta había sido modelada por años de exploración del universo topológico. Imaginó todo el ámbito de posibilidades del oscilador, el entero espacio de fases, como lo denominaban los físicos. Cualquier estado del sistema parado durante un instante se representaba como un punto en el espacio mencionado; toda la información sobre su posición o velocidad existía en las coordenadas de aquel punto. Cuando el sistema cambiaba, el punto se movía a otra posición del espacio de fases. Y si se modificaba sin tregua, trazaba una trayectoria. En un sistema sencillo como el péndulo, el espacio de fases podía ser un rectángulo: el ángulo del péndulo en un momento dado determinaría la posición este-oeste de un punto, y su velocidad, la norte-sur. En uno que se balanceara con regularidad, la trayectoria en el espacio de fases sería un lazo, de un lado a otro, mientras el sistema iterase la misma serie de posiciones.
Smale, en lugar de fijarse en cualquier trayectoria, se concentró en el comportamiento de todo el espacio durante el cambio del sistema, cuando, por ejemplo, se le agregaba más energía impulsora. Su intuición brincó de la esencia física a una especie nueva de esencia geométrica. Como instrumentos empleó transformaciones topológicas de formas en el espacio de fases, tales como estiramientos y compresiones. Tales modificaciones tenían a veces significado físico evidente. La disipación en un sistema, la pérdida de energía a causa de la fricción, implicaba que la figura en el espacio de fases se contraería como el globo que pierde aire, hasta que, finalmente, se transformaría en un punto, en el instante en que el sistema se parase del todo. Para representar la complejidad total del oscilador de Van der Pol, el espacio de fases —pensó— habría de experimentar un género, nuevo y complicado, de combinación de transformaciones. En seguida convirtió su idea de la visualización del comportamiento total en una distinta clase de modelo. Su innovación —duradera imagen del caos en años venideros— fue una estructura que se conoció con el nombre de herradura.
Una versión simple de ésta se obtiene con un rectángulo, cuya parte superior e inferior se aprietan hasta tener una barra horizontal. Un extremo de ésta se estira y curva para crear una C, como una herradura. Se imagina luego la herradura encajada en otro rectángulo, que se desfigura de la misma manera: reduciendo, doblando y estirando.
El proceso remeda el funcionamiento de la máquina que confecciona el azúcar hilado o algodón de azúcar, en la que brazos giratorios estiran de la masa, la doblan, la vuelven a estirar y doblar hasta que se convierte en una especie de algodón, muy largo, muy delgado y muy enredado. Smale sometió la herradura a variedad de andaduras topológicas y, dejando de lado el aspecto matemático, la herradura proporcionó una elegante analogía visual de la dependencia sensitiva de las condiciones iniciales, que Lorenz descubriría en la atmósfera pocos años después. Escójanse dos puntos próximos en el espacio original, y jamás se sabrá dónde terminarán. Los apartarán arbitrariamente los plegados y estiramientos. Más tarde, dos puntos que están juntos habrán empezado, también arbitrariamente, muy apartados.
Al principio, Smale había esperado explicar todos los sistemas dinámicos por medio de alargamientos y presiones, sin plegamientos, al menos no con aquellos que minasen de modo drástico la estabilidad de un sistema. Pero lo suprimido resultó imprescindible, y la plegadura permitió que hubiera cambios tajantes en la conducta dinámica. La herradura de Smale fue la primera de muchas formas geométricas nuevas que ofrecieron a matemáticos y físicos una intuición desconocida de las posibilidades del movimiento. En algunos aspectos, era demasiado artificial para tener utilidad, y en exceso criatura de la topología matemática para que atrajese a los físicos. Pero sirvió de punto de partida. Durante el decenio de 1960, Smale formó en Berkeley un grupo de matemáticos jóvenes que compartían su entusiasmo por la labor sobre los sistemas dinámicos. Transcurrirían diez años antes de que sus trabajos cautivasen la atención de ciencias menos puras; pero cuando ocurrió, los físicos advirtieron que Smale había devuelto toda una rama de las matemáticas al mundo real. Era una edad de oro, dijeron.
—Es el cambio paradigmático de los cambios paradigmáticos —exclamó Ralph Abraham, colega de Smale, que llegó a ser profesor de matemáticas en la Universidad de California, en Santa Cruz—. Cuando empecé mi trabajo profesional en 1960, de lo que no hace tanto tiempo, la matemática contemporánea sin excepción —sin excepción— era rechazada por los físicos, incluso por los que ocupaban las avanzadillas de la física matemática. Por lo tanto, la dinámica diferenciable, el análisis global, los proyectos múltiples, la geometría diferencial, a saber, todo lo que tenía un par de años más que lo que Einstein había usado, fue rechazado sin contemplaciones. El noviazgo de los matemáticos con los físicos acabó en ruptura en los años treinta. Los antiguos enamorados dejaron de dirigirse la palabra. Se despreciaban mutuamente, y nada más. Los físicos matemáticos negaron a los estudiantes graduados el permiso de ampliar conocimientos en los cursos de sus despreciados compañeros antiguos: Estudie matemáticas con nosotros. Le enseñaremos lo que necesita saber. Los matemáticos se han entregado a una horrible orgía de ego y destrozarán su mente. Eso sucedía en 1960. Hacia 1968 la situación había cambiado por completo.
Por fin, todos los físicos, astrónomos y biólogos sabían que tenían que escuchar las noticias.
§. Un misterio resuelto: La gran Mancha Roja de Júpiter
Un modesto enigma cósmico: la gran Mancha Roja de Júpiter, óvalo colosal y giratorio, semejante a una tempestad titánica, que jamás se desplaza y jamás se debilita. Quien vio las imágenes enviadas a través del espacio por el Voyager 2, en 1978, reconocerá el familiar aspecto de la turbulencia a una escala desproporcionada, nada familiar. Era uno de los hitos más venerables del sistema solar: «La Mancha Roja alborotada como un ojo angustiado / En medio de una turbulencia de cejas en ebullición», según la describió John Updike. Pero ¿qué era? Veinte años después de Lorenz, Smale y otros científicos pusieron en marcha una manera nueva de entender los flujos naturales, y el tiempo extra mundanal de Júpiter fue uno de los muchos problemas que aguardaban a la alterada percepción de las posibilidades de la naturaleza que había surgido con la ciencia del caos.
Durante tres siglos había sido ejemplo de que cuanto más se conoce menos se sabe. Los astrónomos habían advertido una tacha en el planeta gigante poco después de que Galileo hubiese asestado, por primera vez, sus telescopios en su dirección. Robert Hooke la vio en los años iniciales del siglo XVII. Donati Creti la retrató en la pinacoteca vaticana. Como pincelada de color, la Mancha apenas exigía explicación. Pero los telescopios se perfeccionaron y el conocimiento generó ignorancia. En la pasada centuria se formuló una retahíla de conjeturas que se pisaron los talones. He aquí algunas:
La teoría de la corriente de lava. Científicos de la última parte del siglo XIX imaginaron un gigantesco lago de lava fundida, que brotaba de un volcán. O tal vez la lava manaba del agujero abierto por un planetoide en la fina corteza.
La teoría de la nueva luna. Un científico alemán propuso, en cambio, que la Mancha era una luna a punto de emerger de la superficie del planeta.
La teoría del huevo. Hecho desconcertante: la Mancha se vio como si se desplazara levemente sobre el fondo planetario. Por ello, en 1939, se pensó que era un cuerpo, más o menos sólido, que flotaba en la atmósfera como un huevo lo hace en el agua. Variantes de esta teoría —incluida la noción de una pompa movediza de hidrógeno o helio— se formularon durante décadas.
La teoría de la columna de gas. Otro hecho nuevo: aunque se desplace, la Mancha jamás lo hace a mucha distancia. Por lo tanto, los científicos propusieron, en los años sesenta, que era la parte superior de una columna gaseosa que se alzaba, posiblemente desde un cráter.
Tocó el turno al Voyager. Casi todos los astrónomos creían que el enigma se disiparía tan pronto como pudieran contemplarlo suficientemente de cerca. El vuelo del Voyager suministró un álbum espléndido de datos ignorados, los cuales, sin embargo, no bastaron. Las imágenes que proporcionó la nave espacial en 1978 revelaron vientos potentes y mareas llenas de color. Los astrónomos observaron, con pormenor espectacular, la Mancha como un sistema huracanado de flujo arremolinado, que barría las nubes, encajado en zonas de viento, el cual soplaba de este a oeste y trazaba fajas horizontales alrededor del planeta. Huracán fue la mejor descripción con que se acertó, pero, por varias razones, resultaba inadecuada. Los terrestres obedecen al calor liberado cuando la humedad se condensa en lluvia; tal proceso no impulsa a la Mancha Roja. Los huracanes, como todas las tempestades de la Tierra, giran en dirección ciclónica, contraria al avance de las saetas del reloj en el hemisferio septentrional, y en el mismo sentido que ellas en el meridional: la Mancha es anticiclónica. Y, más importante todavía, los huracanes amainan al cabo de unos días.
Cuando estudiaron las imágenes del Voyager, los astrónomos se percataron también de que el planeta era, en resolución, sólo fluido en movimiento. Se habían habituado a buscar un cuerpo sólido, rodeado de una tenue atmósfera, como la terrestre; pero, si Júpiter poseía un núcleo compacto y firme, debería de tenerlo muy lejos de la superficie. El planeta adquirió de pronto la apariencia de experimento enorme de mecánica de fluidos, y en él se hallaba la Mancha Roja, girando continuamente, sin descanso, imperturbable, pese al caos que la rodeaba.
El fenómeno se convirtió en test proyectivo de la personalidad. Los científicos veían en él lo que sus intuiciones les permitían percibir. Un estudioso de la dinámica de los fluidos, que concibiera la turbulencia como fortuita, accidental, estaba desprovisto de base para comprender la existencia de una isla de estabilidad en medio de ella. El Voyager duplicó lo exasperante del misterio pues mostró rasgos del fluido, tan pequeños, que no podían observarse siquiera con los telescopios más potentes. Aquellos rasgos a escala reducida delataban una rauda desorganización, mareas que aparecían y desaparecían el mismo día, y en ocasiones en menos tiempo. Pero la Mancha seguía indemne. ¿Qué la conservaba? ¿Qué la mantenía en su sitio?
La NASA guarda sus imágenes en archivos, alrededor de media docena, dispersos por los Estados Unidos. Uno está en la Universidad de Cornell. En los primeros años de esta década, tenía su despacho cerca de él Philip Marcus, joven astrónomo y cultivador de las matemáticas aplicadas. Luego de la misión del Voyager, fue uno de los seis científicos estadounidenses y británicos que buscaron el medio de crear un modelo de la Mancha Roja. Libres de la teoría del huracán ersatz (sucedáneo), encontraron símiles más adecuados. Por ejemplo, la corriente del Golfo, que serpea por el Atlántico occidental se retuerce y ramifica de maneras sutilmente reminiscentes. Produce olitas, que se cambian en aros y éstos en anillos, y salen dando vueltas de la corriente principal: forman vórtices lentos, duraderos y anticiclónicos. Otro paralelo se tuvo en el peculiar fenómeno meteorológico llamado «estancamiento». A veces un sistema de altas presiones se sitúa frente a las costas y gira despacio durante semanas o meses, desafiando la usual corriente aérea que va de este a oeste. El estancamiento estropeaba los modelos de previsión global, pero daba algunas esperanzas a los pronosticadores, porque creaba rasgos ordenados de longevidad inusual.
Marcus estudió durante muchas horas las fotografías de la NASA, las vistosas de hombres en la Luna y las de la turbulencia de Júpiter. Como las leyes de Newton rigen por doquier, programó un ordenador con un sistema de ecuaciones fluidas. Con el fin de remedar el tiempo del planeta, había de escribir reglas para una masa de hidrógeno y helio, semejante a una estrella apagada. Júpiter rota con mucha velocidad: cada día suyo dura diez horas terrestres. Su rotación provoca una violenta fuerza de Coriolis, la lateral que empuja a la persona que ande de un lado a otro en un tiovivo, la cual impulsa la Mancha.
Lorenz utilizó su diminuto modelo del tiempo atmosférico de la Tierra para imprimir líneas imperfectas en un papel enrollado; en cambio, Marcus empleó la mayor potencia de su ordenador para reunir extraordinarias imágenes policromas. Ante todo, trazó los contornos. A duras penas veía lo que ocurría. Después hizo transparencias, y por último congregó las imágenes en una película animada. Fue una revelación. En azules, encarnados y amarillos brillantes, el patrón cuadriculado de vórtices giratorios se transformó en un óvalo, que tenía inverosímil semejanza con la gran Mancha Roja, tal como aparecía en el filme que había facilitado la NASA.
—Uno ve a gran escala esa maca, tranquila como una almeja en pleno flujo caótico, a pequeña escala, y ese flujo absorbe energía como una esponja —explicó Marcus—. Se perciben minúsculas estructuras filamentosas sobre un fondo oceánico de caos.
La Mancha es un sistema que se auto organiza, creado y regulado por las mismas contorsiones no lineales que producen el impredecible tumulto circunstante. Es caos estable.
Siendo estudiante graduado, Marcus había estudiado la física tradicional, resuelto ecuaciones lineales y efectuado experimentos destinados a ajustarse al análisis lineal. Era una existencia segura, porque, en el fondo, las ecuaciones no lineales se resisten a ser solucionadas, y no había motivo para malgastar en ellas el tiempo de un estudiante graduado. El contento formaba parte del programa docente. Mientras mantuviera los experimentos dentro de ciertos límites, bastaría el tratamiento lineal y le recompensaría la contestación esperada. De cuando en cuando, inevitablemente, se entremetía el mundo real, y veía lo que años más tarde comprendió que habían sido síntomas del caos. Se detenía y exclamaba: « ¡Eh! ¿Qué es esta especie de pelusilla?». Y le replicaban: « ¡Bah! Se trata de un error experimental. No te preocupes».
Pero, a diferencia de la mayoría de los físicos, Marcus llegó a aprender la lección de Lorenz: que un sistema determinista puede producir mucho más que un comportamiento periódico. Sabía buscar el desorden desenfrenado, y sabía también que islas de estructura podían surgir en el desorden. Por consiguiente, aportó al problema de la gran Mancha Roja el conocimiento de que un sistema complejo puede suscitar, a la vez, turbulencia y coherencia. Le era posible trabajar en una disciplina naciente, que creaba la tradición de utilizar el ordenador como instrumento experimental. Y estaba dispuesto a imaginarse como una especie distinta de científico: no, primariamente, como un astrónomo, un perito en dinámica de los fluidos o un cultivador de las matemáticas aplicadas, sino como un experto en caos.

La mancha roja: auténtica y simulada.
La sonda espacial Voyager reveló que la superficie de Júpiter es un fluido bullidor y turbulento, con bandas horizontales que corren de este a oeste. La Mancha Roja se ve desde el ecuador del planeta y, también, desde el polo meridional. La simulación de ordenador de Philip Marcuso la presenta vista desde dicho polo. El color muestra la dirección de giro de partes especiales de fluido: las que voltean en sentido contrario al de las agujas del reloj aparecen en rojo, y las que rotan en la dirección de ésas, en azul. Sea cual fuere la configuración de partida, las agrupaciones azules propenden a separase, y las rojas, a unirse en una sola mancha, estable y coherente, en medio del tumulto circunstante.
Capítulo 3
Altibajos de la vida
El resultado de un desarrollo matemático debe compararse siempre con la intuición propia de lo que constituye una conducta biológica razonable. Si tal cotejo revela que hay desacuerdo, habrá que tener en cuenta las posibilidades siguientes:
a) Se ha cometido un error en el desarrollo matemático formal.
b) Los supuestos iniciales son incorrectos y/o representan una simplificación por demás excesiva.
c) La intuición propia de lo biológico adolece de desarrollo inadecuado.
d) Se ha descubierto un principio penetrante.
HARVEY I. GOLD,
Mathematical Modeling of Biological Systems
(Modelos matemáticos de sistemas biológicos)
§. Modelos de poblaciones silvestres§. Modelos de poblaciones silvestres
§. Ciencia no lineal: «el estudio de animales no elefantes»
§. Bifurcaciones ahorquilladas y un paseo por el Spree
§. Una película del caos y un llamamiento mesiánico
Pez famélico y plancton apetitoso. Selva ecuatorial en que gotea la lluvia desde las ramas, con reptiles innominados, aves que se deslizan bajo doseles de frondas, insectos que zumban como electrones en el acelerador de partículas. Zonas heladas donde las ratas de campo y los lémmings proliferan y decaen con puntual periodicidad cada cuatro años, en combate encarnizado con la naturaleza. El mundo ofrece un desordenado laboratorio a los ecologistas, una caldera de cinco millones de especies que se influyen recíprocamente. ¿O son cincuenta millones? Los naturalistas lo ignoran aún.
Los biólogos del siglo XX dotados de aficiones matemáticas forjaron una disciplina, la ecología, que eliminó el ruido y el color de la vida real y trató los grupos de criaturas como sistemas dinámicos. Los ecologistas emplearon las herramientas elementales de la física matemática para describir las mareas y corrientes de la vida. Una especie que se multiplica en un lugar en que el alimento es limitado, varias especies que rivalizan para subsistir, epidemias que se extienden en poblaciones innúmeras: todo podía aislarse, ya que no en los laboratorios, al menos en la mente de los teóricos de la biología.
Los ecologistas estaban destinados a desempeñar una función especial en el nacimiento del caos como ciencia en el decenio de 1970. Usaron modelos matemáticos, pero lo hicieron con plena conciencia de que eran endebles imitaciones del bullidor mundo auténtico. Con harta malicia, la comprensión de sus limitaciones les permitió notar la importancia de ideas que los matemáticos habían considerado rarezas interesantes. Que ecuaciones regulares tuvieran desarrollo irregular fue algo que hizo sonar la voz de alerta entre ellos. Las aplicadas en la biología de la población fueron sencillas réplicas de los modelos empleados por los físicos en el estudio aparcelado del universo. Pero la complejidad de los fenómenos reales que interesaban a las ciencias de la vida superaba cuanto hubiese en un laboratorio de física. Los modelos matemáticos de los biólogos se inclinaban a ser caricaturas de lo real, como los de los economistas, demógrafos, psicólogos y urbanistas, cuando aspiraban a dar rigor a sus exámenes de los sistemas que se modificaban con el tiempo. Los criterios eran distintos. Para un físico un sistema de ecuaciones como el de Lorenz resultaba tan simple, que rayaba en lo transparente. Para un biólogo incluso las ecuaciones de Lorenz eran formidablemente complicadas: tridimensionales, sin cesar variables e intratables desde el punto de vista analítico.
La necesidad creó un modo diferente de actuación en el caso de los biólogos. La aplicación de las descripciones matemáticas a los sistemas reales pedía otro rumbo. El físico, al estudiar uno dado (verbigracia, dos péndulos acoplados por un muelle), comienza por elegir las ecuaciones adecuadas. Por lo común, las busca en un manual; si no figuran en él, las deduce de los principios originales. Sabe cómo funcionan los péndulos y los muelles. A partir de ello resuelve las ecuaciones, si puede. El biólogo, en cambio, jamás conseguiría inferir las idóneas, reflexionando sobre esta o aquella población animal. Tendría que cosechar datos e intentar deducir las que rindieran un output similar. ¿Qué sucede si se coloca un millar de peces en un vivero con una cantidad limitada de alimento? ¿Qué ocurre si se agregan cincuenta tiburones a los que entusiasma devorar dos peces al día? ¿Qué pasa con un virus que mata a determinado ritmo y que se propaga con una rapidez que depende de la densidad de la población? Los científicos idealizaron cuestiones como éstas en busca de fórmulas bien definidas.
Tuvieron éxito a menudo. Los biólogos de la población aprendieron bastantes cosas sobre la historia de la vida, cómo los depredadores y sus presas se influyen mutuamente, y cómo un cambio en la densidad demográfica de un país afecta a la propagación de una enfermedad. Si cierto modelo matemático seguía adelante, llegaba a un equilibrio o se anulaba, los ecologistas barruntaban algo acerca de las circunstancias en que una población o una epidemia haría lo mismo en la realidad. Una simplificación útil consistía en modelar el mundo en intervalos temporales separados, como una manecilla de reloj que saltase de un segundo a otro en vez de deslizarse a lo largo de ellos. Las ecuaciones diferenciales describen procesos que cambian suavemente en el decurso del tiempo, pero no son fáciles de resolver. Otras más asequibles, las «ecuaciones en diferencias», pueden utilizarse en los procesos que brincan de estado en estado. Por fortuna, muchas especies animales se comportan de modo característico en claros intervalos de un año. Estos cambios suelen ser más importantes que los que ocurren sucesivamente. A diferencia del hombre, muchos insectos, por ejemplo, presentan una sola estación de reproducción, de suerte que sus generaciones no traslapan. El ecologista no necesita saber más que la cifra correspondiente de ese año, para colegir la población de la mariposa lagarta en la primavera que viene, o el número de afectados por una epidemia de sarampión en el próximo invierno. Un facsímil anual no representa sino una sombra de las complicaciones del sistema, pero en muchos casos prácticos esa sombra proporciona al científico toda la información que requiere.
La matemática de la ecología es a la de Steve Smale lo que el Decálogo es al Talmud: un conjunto de reglas útiles para trabajar y, además, nada enrevesado. En la descripción del cambio anual de una población, el biólogo usa un formalismo que entenderá un estudiante de los últimos cursos de la enseñanza secundaria. Supóngase que la población de mariposas lagartas del próximo año depende de la de éste. Imagínese una tabla que catalogue todas las posibilidades específicas: 31.000 mariposas actuales significan 31.000 venideras, y así en adelante. O que se establece como regla la relación entre todas las cifras de este año y todas las del próximo: una función. La población futura (x) es una función (F) de la actual:xpróx= F(x). Como toda función puede representarse con una gráfica, se posee instantáneamente una noción de su forma general.
En un modelo tan simple como el anterior, seguir una población a lo largo del tiempo consiste en tomar una cifra como punto de partida y aplicar la misma función cuantas veces se quiera: para obtener la del tercer año, hay que aplicar la función al resultado que atañe al precedente, etc. Este proceso de iteración funcional proporciona acceso a la historia total de la población: un bucle (loop) de realimentación (feedback), en el que la salida (output) de un año sirve de entrada (input) al siguiente. La realimentación puede salirse de madre, como sobreviene cuando el sonido de un altavoz se filtra en un micrófono y es amplificado al punto en un ruido insoportable. O acarrea estabilidad, como el termostato que regula la temperatura de una habitación: la que excede de un índice prefijado motiva enfriamiento, y la que no llega a él, caldeamiento.
Hay muchos tipos posibles de función. Una visión ingenua de la biología de la población es proponer una función que le aumente cierto porcentaje anual. Será una función lineal −xpróx= rx − y corresponderá al clásico esquema maltusiano del crecimiento demográfico, que no limita la provisión de alimentos, ni la restricción moral. El parámetro r representa la razón del aumento de la población. Convéngase que es 1,1; por lo tanto, si la de este año es 10, la del que viene será 11. Si el input es 20.000, el output será 22.000. O sea, la población crece de continuo, como el dinero dejado para siempre, al interés compuesto, en una caja de ahorros.
Han nacido generaciones desde que los ecologistas comprendieron que habrían de perfeccionar el procedimiento. El que estudiaba peces auténticos en un vivero auténtico tenía que hallar una función que casase con las crudas realidades de la vida, como, por ejemplo, la del hambre o la de la competencia. La proliferación de los peces hace que el alimento escasee. Unos pocos se multiplicarán velozmente. Un majal demasiado nutrido menguará. O también pueden considerarse las cetonias. En plena canícula, uno las cuenta en el jardín y, para evitar complicaciones, ignora los pájaros y las enfermedades propias de los coleópteros; sólo tiene en cuenta la cantidad presupuesta de alimento que requieren. Unas pocas cetonias se multiplicarán; si hay muchas, destruirán las plantas y acabarán por perecer de hambre.
En el supuesto maltusiano de crecimiento sin trabas, la función de aumento lineal siempre se eleva. En busca de mayor realismo, el ecologista pide una ecuación con un término que reduzca el crecimiento, cuando la población se vuelve muy numerosa. La más lógica será aquella función que aumente decididamente cuando la población sea reducida, reduzca casi a cero el crecimiento en los valores intermedios, y se desplome en caso de proliferación denodada. Repitiendo el proceso, el ecologista verá que la población se remansa en su comportamiento a largo plazo, en el que alcanzará presumiblemente un estado estable. Una incursión saludable en las matemáticas dirá al ecologista, más o menos, algo como lo que sigue: Aquí hay una ecuación; aquí hay una variable que representa la tasa de reproducción; aquí hay otra variable que indica el índice de muertes naturales; aquí hay una tercera variable que corresponde a las muertes por hambre o por ataques de depredadores; y, así, la población aumentará a tal velocidad hasta que alcance tal nivel de equilibrio.
¿Cómo se averigua una función como ésa? Muchas ecuaciones pueden servir; quizá la más sencilla sea una modificación de la versión lineal maltusiana: xpróx = rx (1 − x), donde r simboliza una razón de crecimiento que puede situarse más alta o más baja. El nuevo término, 1 − x, mantiene dicho crecimiento dentro de límites, puesto que cuando x aumenta, 1 − x decrece.[1]Cualquiera puede, con una calculadora, elegir un punto de partida y una razón de crecimiento, y efectuar la operación aritmética de la que se derive la población del próximo año.
Varios ecologistas estudiaron, en la década de 1950, variaciones de esa fórmula especial, denominada ecuación de diferencia logística. Por ejemplo, W. E. Ricker la aplicó en Australia a las pesquerías. Los investigadores se percataron de que el parámetro r representaba un rasgo esencial del modelo. En los sistemas físicos de los que tales ecuaciones se tomaban en préstamo, el parámetro correspondía a la cantidad de calor, de fricción o de otra manifestación complicada. En resumen, la cantidad de no linealidad. En un vivero, podía corresponder a la fecundidad de los peces, o sea, a la propensión de la población animal no sólo a la multiplicación súbita, sino también a estallar («potencial biótico» es la expresión ennoblecedora). La cuestión era cómo afectaban tales parámetros distintos el destino definitivo de una población mutable. La respuesta evidente es la de que un parámetro bajo hará que la población ideal acabe en un nivel bajo. Uno más alto la conducirá a un estado estable más elevado. Ello resulta correcto para muchos parámetros, pero no para todos. Parece indudable que, de tarde en tarde, investigadores como Ricker buscaron sin duda algunos aún más altos y que, al hacerlo, tuvieron que ver el caos.

Una población se equilibra tras elevarse, excederse en su trayectoria y caer.
Los libros de consulta y los de texto, que trataban de la ecuación logística y de sus primos más abstrusos, por lo común ni siquiera admitían la posibilidad del comportamiento caótico. J. Maynard Smith, en el volumen clásico de Mathematical Ideas in Biology (Las ideas matemáticas en biología), de 1968, proporcionó un criterio normal sobre las posibilidades: las poblaciones suelen permanecer aproximadamente constantes, o bien se mueven, «con periodicidad bastante regular», alrededor de un presunto punto de equilibrio. No quería decir aquello que fuese tanta su ingenuidad que supusiera que las poblaciones reales jamás se portaban de manera caprichosa. Pensó, meramente, que el comportamiento anómalo no tenía relación alguna con la clase de modelos matemáticos que describía. De todas suertes, los biólogos debían emplearlos con cautela. Si empezaban a desmentir el conocimiento que su autor tenía del comportamiento de la población real, siempre cabía justificar la discrepancia con algún rasgo no tenido en cuenta: la distribución de las edades, alguna peculiaridad territorial o geográfica, o la complicación de la existencia de dos sexos.
Más trascendental era la sospecha persistente, escondida en algún rincón de la mente del ecologista, de que la desconcertante serie de números implicaba que la calculadora traveseaba o que no poseía la precisión apetecible. Las soluciones interesantes eran las estables, y el orden, su recompensa. Al fin y al cabo, ya era dura la tarea de acertar con las ecuaciones más aptas y encima resolverlas. Nadie quería malgastar su tiempo en la averiguación del porqué de aquella consecuencia desconcertante de sus esfuerzos, la cual no aportaba estabilidad. Y ningún buen ecologista olvidó nunca que sus ecuaciones eran versiones colosalmente simplificadas de los fenómenos naturales. La única finalidad de la super simplificación estribaba en obtener regularidad. ¿Quién iba a molestarse para encararse con el caos?
§. Ciencia no lineal: «el estudio de animales no elefantes»
Se diría posteriormente que James Yorke había descubierto a Lorenz y había bautizado la ciencia del caos. La segunda parte del rumor era verdadera.
Yorke era un matemático al que gustaba de imaginarse como filósofo, aunque fuese peligroso admitirlo profesionalmente. Brillante y de voz suave, se presentaba como admirador algo desaliñado del algo desaliñado Steve Smale. Como a todo el mundo, le costaba comprender a éste, pero, a diferencia de los demás, sabía por qué. A los veintidós años de edad, Yorke ingresó en una institución interdisciplinaria de la Universidad de Maryland, el Institute for Physical Science and Technology (Instituto de Ciencia Física y Tecnológica), que dirigiría más tarde. Pertenecía a los matemáticos que se sentían impelidos a dar fin práctico a sus ideas sobre la realidad. Su informe sobre cómo se propagaba la gonorrea hizo que el gobierno federal alterase su programa nacional para atajar la enfermedad. Prestó testimonio oficial ante el Estado de Maryland, durante la crisis petrolera de los años setenta, afirmando correctamente (pero sin fuerza persuasiva) que el método de limitar con cupos la venta de gasolina sólo lograría que las colas fuesen más largas. En la época de las manifestaciones antibélicas, cuando el gobierno publicó una fotografía aérea con el propósito de mostrar cuán pocas personas hubo alrededor del monumento a Washington en el momento culminante de una de ellas, analizó la sombra que proyectaba la obra pública y demostró que la fotografía había sido tomada media hora después, cuando el gentío se dispersaba.
En el instituto, Yorke disfrutaba de una libertad poco común para trabajar en problemas que se salían de los caminos trillados. Tenía trato frecuente con expertos de todas las disciplinas. Uno de ellos, especialista en dinámica de los fluidos, había encontrado en 1972 el artículo de Lorenz «Deterministic Nonperiodic Flow», redactado nueve años antes y, enamorado de él, regaló copias a todos los que estaban dispuestos a aceptarlas. Yorke recibió una.
El artículo era un ejemplo de la magia que Yorke había buscado, incluso sin saberlo. Ante todo, le produjo un trauma matemático: un sistema caótico que violaba el optimista esquema original de clasificación de Smale. Pero no se reducía sólo a eso, pues contenía un vívido modelo físico, la imagen de un fluido en movimiento. Yorke se hizo cargo al instante de que se trataba de una de las cosas que ansiaba que los físicos vieran. Smale había pilotado las matemáticas hacia tales problemas, pero, como Yorke entendió muy bien, el lenguaje de las ciencias exactas representaba un serio obstáculo para la comunicación. ¡Ojalá en el mundo académico hubiera espacio para un híbrido físico-matemático! Más no lo había. A pesar de que la obra de Smale sobre los sistemas dinámicos había empezado a henchir el hueco, los matemáticos hablaban todavía un lenguaje y los físicos otro. Como uno de esos últimos, Murray Gell-Mann, comentó en una ocasión:
—Los miembros de la facultad están al corriente de la existencia de un tipo de individuo que mira a los matemáticos como buen físico, y a los físicos como buen matemático. Hacen muy mal al no querer acogerlo entre ellos.
Los criterios de las dos profesiones discrepaban. Los físicos enunciaban teoremas, y los matemáticos, conjeturas. Los objetos que componían su universo eran distintos. También lo eran los ejemplos que aducían.
Smale se sentía dichoso con uno como el siguiente: tómese un número, una fracción entre cero y uno, y dóblese. Prescíndase de la porción entera, la que hay a la izquierda de la coma decimal. Repítase el proceso. Como la mayoría de los números es irracional e impredecible, el procedimiento sólo producirá una impredecible secuencia numérica. Un físico, ante lo que se acaba de exponer, no vería sino una trivial rareza matemática, totalmente vacía de sentido, y demasiado sencilla y abstracta para tener utilidad alguna. No obstante, la intuición decía a Smale que aquella travesura numérica comparecería sin duda en la esencia de muchos sistemas naturales.
El físico concebía como ejemplo legítimo una ecuación diferencial que pudiera escribirse de manera simple. Yorke, al leer el artículo de Lorenz, pese a que estaba enterrado en una revista de meteorología, supo que presentaba un ejemplo que los físicos entenderían. Entregó una copia a Smale, incluyendo su dirección para que se la devolviera. Su colega se maravilló de que un meteorologista hubiese descubierto—diez años antes— un caos del género que él mismo había considerado imposible matemáticamente. Hizo muchas fotocopias de «Deterministic Nonperiodic Flow», y así nació la leyenda de que Yorke había sido el descubridor de Lorenz. Cada copia del artículo que apareció en adelante, en Berkeley, llevó el remitente de Yorke.
Éste pensó que los físicos habían aprendido a no ver el caos. La cualidad lorenziana de la dependencia sensitiva de las condiciones iniciales despunta por doquier en la vida cotidiana. Un hombre sale de su casa por la mañana con un retraso de treinta segundos, un tiesto de flores no se estrella contra su cabeza por cuestión de milímetros y le atropella luego un camión. O, para no dramatizar, pierde un autobús que pasa cada diez minutos, y que enlaza con el tren que ha de tomar, el cual sale cada hora. Las pequeñas perturbaciones de la rutina diaria personal llegan a tener consecuencias abultadas. El bateador que se enfrenta a la pelota arrojada sabe que el mismo lanzamiento no tiene aproximadamente el mismo resultado, porque el béisbol es un deporte de centímetros. Sin embargo, la ciencia… La ciencia era distinta.
Desde el punto de vista didáctico, una buena porción de la física y la matemática era —y es— escribir ecuaciones diferenciales en una pizarra y enseñar a los estudiantes cómo se resuelven. Representan la realidad como un continuo, que cambia sin brusquedad de un sitio a otro y de un tiempo a otro, sin que lo rompan soluciones de continuidad de la clase que fuere. Resolver ecuaciones diferenciales es cosa dura, como lo saben los aprendices de las ciencias. Pero, en el decurso de dos siglos y medio, los científicos han reunido un tremendo acervo de conocimientos sobre ellas: manuales, catálogos y varios métodos para solucionarlas o, como diría el especialista, «encontrar un integral de forma cerrada». No se exagera al afirmar que el vasto quehacer del cálculo diferencial posibilitó casi todos los triunfos prácticos de la ciencia pos medieval; ni al decir que sobresale como una de las creaciones más ingeniosas del espíritu humano en el intento de establecer un diseño del mundo que nos rodea. De manera que, cuando domina esta manera de pensar sobre la naturaleza y se siente a sus anchas con la teoría y la difícil, la ardua práctica, es probable que el científico haya perdido de vista un hecho nada desdeñable. La mayor parte de las ecuaciones diferenciales no pueden resolverse.
—Si se puede escribir la solución de una —dijo Yorke—, necesariamente no será caótica, porque, para expresar esa solución, se han de encontrar invariantes regulares, cosas que se conserven, como el impulso angular. El hecho de que esas cosas abunden permite establecer un resultado. Pero ése es el modo preciso de eliminar la posibilidad del caos.
Los sistemas resolubles se incluyen en los libros de texto. Se portan como Dios manda. Los científicos, ante un sistema no lineal, habrían de sustituir las aproximaciones lineales o buscar otro incierto recurso semejante. Los libros de texto exhibían a los estudiantes los contadísimos no lineales que permitían tales técnicas. No evidenciaban dependencia sensitiva de las condiciones iniciales. Los que albergaban el caos auténtico se enseñaban y aprendían rarísimas veces. Cuando topaba con rasgos como aquéllos —y topaba con ellos—, la gente, por su formación, razonaba con el fin de evitar tales aberraciones. Sólo unas cuantas personas recordaban que también lo eran los sistemas lineales, ordenados y solubles. Sólo unas pocas, para expresarlo de modo distinto, comprendían hasta qué extremo la naturaleza no lineal ocupaba sus entrañas. Enrico Fermi exclamó en una ocasión:
—La Biblia no dice que todas las leyes naturales sean expresables linealmente.
El matemático Stanislaw Ulam ironizó que llamar «ciencia no lineal» al estudio del caos era definir la zoología como «el estudio de los animales no elefantes».
Yorke comprendió. «El primer mensaje es que hay desorden. Los físicos y matemáticos quieren descubrir regularidades. La gente se pregunta para qué sirve el desorden. Sin embargo, ha de conocerlo si aspira a habérselas con él. El mecánico de coches que ignore la suciedad de las bujías no será buen profesional». Tanto científicos como profanos, pensó Yorke, se engañarán en lo que se refiere a la complejidad, si no armonizan adecuadamente con ella. ¿Por qué los inversores insisten en la existencia de ciclos en los precios del oro y la plata? Porque la periodicidad es el comportamiento ordenado más complicado que logran imaginar. Cuando ven una estructura compleja de precios, buscan alguna periodicidad confundida en una mota de barullo accidental. Y los científicos que hacen experimentos, en física, química o biología, no son distintos.
—La gente vio en el pasado la conducta caótica en una infinidad de circunstancias —dijo Yorke—. Efectuaron un experimento físico y éste se portó de manera extravagante. Procuraron enmendarlo o renunciaron a hacerlo. Justificaron el comportamiento caprichoso asegurando que había inconvenientes o que el experimento estaba mal proyectado.
Yorke decidió que el trabajo de Lorenz y Smale enviaba un mensaje que los físicos no escuchaban. Así, pues, escribió un artículo para la revista de más amplia difusión, y más dispuesta a aceptarlo, la American Mathematical Monthly. (Por ser matemático, se sintió impotente para expresar sus ideas de modo que las publicaciones de física consideran aceptable; sólo años más tarde se le ocurrió la estratagema de colaborar con físicos). El artículo sobresalió por méritos propios, pero, en el fondo, su virtud más influyente fue su título, intrigante y malicioso: «Period Three Implies Chaos» (El período tres implica el caos). Sus colegas le aconsejaron que utilizase uno más sobrio, pero él se aferró a un vocablo que llegaría a simbolizar el conjunto —creciente— de la cuestión del desorden determinista. Habló asimismo con su amigo el biólogo Robert May.
§. Bifurcaciones ahorquilladas y un paseo por el Spree
Ocurría que May había llegado a la biología por la puerta trasera. Dio los primeros pasos como físico teórico en la ciudad australiana de Sydney, que le había visto nacer. Era hijo de un distinguido abogado. Llevó a cabo su trabajo posdoctoral en matemáticas aplicadas en Harvard. En 1971, pasó un año en el Institute for Advanced Study, en Princeton; en lugar de cumplir su deber, contrajo el hábito de visitar la universidad princetoniana para conversar con los biólogos.
Incluso al presente, estos últimos no dominan las matemáticas más allá del cálculo diferencial. Las personas a quienes gustan las ciencias exactas y tienen aptitudes para ellas, se inclinan a seguirlas, o se deciden por la física, antes que por las que estudian la vida. May era una excepción. Sus intereses le acercaron, de momento, a los problemas abstractos de la estabilidad y la complejidad, explicaciones matemáticas que permiten que coexistan los competidores. Pronto empezó a concentrarse en la cuestión ecológica más sencilla de cuál es el comportamiento de cada población en el transcurso del tiempo. Los modelos, inevitablemente simples, parecían un compromiso menor. Cuando se unió definitivamente al cuerpo académico de Princeton —en el que llegaría a ser decano de la actividad investigadora—, había pasado ya muchas horas estudiando una versión de la ecuación de diferencia logística, con la ayuda del análisis matemático y, también, de una primitiva calculadora manual.
Cierta vez había escrito, en Sydney, en una pizarra colocada en un pasillo, la ecuación como problema destinado a los estudiantes graduados. Principiaba a encocorarle. « ¿Qué diablos sucede cuando lambda se hace mayor que el punto de acumulación?». O sea, qué ocurría cuando la razón de crecimiento de una población, su tendencia a aumentar y prosperar, excedía de un punto crítico. Durante el ensayo de diferentes valores para ese parámetro no lineal, May reparó en que podía cambiar de forma asombrosa el carácter del sistema. Acrecentar el parámetro equivalía a acrecentar la no linealidad, y eso alteraba no sólo la cantidad del resultado, sino su cualidad. Afectaba no sólo a la población en equilibrio, sino al hecho de si la población se equilibraría.
El modelo simple de May adquiría estado estable si el parámetro era bajo. Si era alto, se rompía el estado estable, y la población oscilaba entre dos valores alternantes. Si era altísimo, el sistema —el mismísimo sistema— comenzaba a portarse de forma impredecible. ¿Por qué? ¿Qué acaecía exactamente en los límites de las distintas clases de comportamiento? May no acertó con ello. (Ni tampoco los estudiantes graduados).
Puso en práctica un programa de exploración numérica intensa sobre el proceder de esta ecuación, la más sencilla de todas. El programa era análogo al de Smale: quería entender aquella simple ecuación de golpe, global y no localmente. Era mucho más sencilla que todo lo que Smale había estudiado. Parecía increíble que sus posibilidades para crear orden y desorden no se hubieran agotado mucho antes. Seguían ternes. Ciertamente, el programa de May acababa de empezar. Investigó centenares de valores distintos del parámetro, dando movimiento al bucle del feedback o realimentación, y esperando ver dónde —y si— la sarta de números se detenía en un punto dado. Se centró cada vez más en el límite crítico entre la estabilidad y la oscilación. Fue como si poseyera un vivero en el que ejerciese delicada autoridad sobre el aumento y la prosperidad de los peces. Utilizando todavía la ecuación logística, xpróx=rx (1 − x), acrecentó el parámetro con la mayor lentitud posible. Si era 2,7, la población sería 0,6292. Mientras el parámetro ascendía, la población final se acrecentó levemente, trazando una línea que se elevó de forma imperceptible, en tanto que se movía de derecha a izquierda en la gráfica. Más, de pronto, cuando el parámetro pasó a 3, la línea se partió en dos. La imaginaria población íctica de May se negó a permanecer en un solo valor y osciló entre dos puntos en años alternos. Cuando partía de un número bajo, la población crecía y fluctuaba hasta que aleteaba adelante y atrás. La oscilación se rompía girando el mando algo más —aumentando algo más el parámetro—, y así se produjo una serie de cifras que se resolvió en cuatro valores diferentes, cada uno de los cuales reaparecía cada cuatro años.[2] Por consiguiente, la población subía y bajaba según un programa cuatrienal regular. El ciclo se había vuelto a doblar: primero de un año a dos, y entonces a cuatro. Y de nuevo el comportamiento cíclico resultante fue estable; distintos valores de partida convergían siempre en el mismo ciclo de cuatro años.
Como Lorenz había descubierto hacía una década, la única manera de interpretar números como aquéllos, y conservar la vista, era recurrir a una gráfica. May diseñó un perfil escueto, destinado a sumar todo el conocimiento de la conducta de tal sistema en diferentes parámetros. El nivel de éstos se proyectó en sentido horizontal, de izquierda a derecha, y la población, verticalmente. May estableció para cada parámetro un punto que indicaba el resultado final, después de que el sistema alcanzara el equilibrio. A la izquierda, donde el parámetro era bajo, ese resultado sería un punto, de suerte que todos se significarían con una línea que ascendería lentamente de derecha a izquierda. Cuando el parámetro hubiese dejado atrás el primer punto, May tendría que señalar dos poblaciones: la línea se dividiría en dos en forma de Y inclinada u horquilla. La partición correspondería a una población que se deslizaba de un ciclo anual a otro bianual.

Duplicación de período y caos.
En vez de utilizar gráficas para representar el comportamiento de poblaciones con grados distintos de fecundidad, Robert May y otros científicos recurrieron a un «diagrama de bifurcación» para reunir toda la información en una sola imagen. El diagrama muestra cómo los cambios en un parámetro —en este caso, «el florecimiento y la proliferación» de una población silvestre— transformarán el comportamiento definitivo de un sistema tan simple. Los valores del parámetro se representan de izquierda a derecha; la población final se indica en el eje vertical. En cierto sentido, dirigir el valor del parámetro hacia arriba significa influir mucho más en el sistema, aumentando su no linealidad. La población se extingue donde el parámetro es bajo (izquierda). Así que aumenta, también se acrecienta el nivel de equilibrio de la población (centro). Si sigue creciendo, el equilibrio se divide en dos, de la misma manera que intensificar el calor en un fluido en convección hace que aparezca la inestabilidad; la población principia a alternar en dos niveles distintos. Las divisiones, o bifurcaciones, se hacen cada vez más rápidas. Entonces el sistema se vuelve caótico (derecha), y la población pasa por muchos valores, infinitamente diferentes. (En las dos siguientes ilustraciones se presenta una ampliación de la región caótica).
Las bifurcaciones se aceleraban —4, 8, 16, 32, etc.— y se interrumpían de pronto. Allende cierta situación, el «punto de acumulación», la periodicidad se somete al caos, a fluctuaciones que jamás se asientan. Regiones enteras del gráfico se ennegrecen. Si se examina una población gobernada por la más sencilla de estas ecuaciones lineales, llega a creerse que los caminos anuales dependen del azar, como si los anulase el alboroto ambiental. No obstante, en el seno de esta complejidad reaparecen de súbito los ciclos estables. A pesar de que el parámetro ascienda, como prueba de que la no linealidad se adueña del sistema con intensidad creciente, aparece de repente una ventana con un período irregular: uno excéntrico, como 3 o 7. La pauta de la población cambiante se repite en un ciclo de tres o siete años. A renglón seguido, las bifurcaciones propias del período de duplicación se reinician con rapidez mayor, de manera que recorre velozmente ciclos de 3, 6, 12, etc., o de 7, 14, 28, etc., tras lo cual se interrumpe de golpe y el caos se renueva.
May no pudo, al principio, abarcar de una mirada la totalidad de lo antes descrito; pero eran bastante desconcertantes los fragmentos accesibles a sus cálculos. En un sistema del mundo real, el observador vería cada vez la tajada vertical de un solo parámetro, únicamente una clase de comportamiento, ya un estado estable, ya un ciclo de siete años, ya azar aparente. No tendría forma de saber que el mismo sistema, con algún cambio imperceptible en un parámetro, podía exhibir pautas de género por completo distinto.
James Yorke analizó con rigor matemático este comportamiento en su artículo «Period Three Implies Chaos» (El período tres implica caos). Probó que cualquier sistema unidimensional, si aparece un período regular de tres, mostrará no sólo ciclos regulares de extensión diferente, sino otros completamente caóticos. Tal fue el descubrimiento que afectó como una «descarga eléctrica» a físicos de la categoría de Freeman Dyson. Era algo tan contrario a la intuición… Se hubiera imaginado como trivial la presentación de un sistema que se repitiese a sí mismo en una oscilación de período tres, sin generar caos ni por asomo. Yorke demostró que se trataba de algo imposible.
Estaba convencido de que el valor en relaciones públicas de su artículo sobrepasaba el de su sustancia matemática, bien que fuera detonante. Acertó en parte. Pocos años después, mientras asistía a una conferencia internacional en el Berlín oriental, aprovechó la ocasión para visitar los alrededores y tomó una embarcación que recorría el Spree. Se le acercó de sopetón un ruso, con el ánimo evidente de comunicarle algo con urgencia. Gracias a la ayuda de un amigo polaco, Yorke consiguió enterarse de que el ruso pretendía haber probado el mismo resultado. Su inesperado interlocutor se negó a proporcionar más detalles; sólo se comprometió a enviarle su artículo. Yorke lo recibió, en efecto, cuatro meses después. A. N. Sarkovski se le había anticipado con un artículo titulado «Coexistencia de ciclos de un diagrama continuo de una línea en sí mismo». Pero Yorke había ofrecido más que un resultado matemático. Había despachado un mensaje a los físicos: el caos es ubicuo, estable y estructurado. También proporcionó motivo para creer que los sistemas complejos, que, tradicionalmente, se modelaban con arduas ecuaciones diferenciales continuas, se entenderían en términos de diagramas individuales fáciles.

Ventanas de orden en el interior del caos.
Incluso con la ecuación más elemental, la región de caos en un diagrama de bifurcación tiene una estructura intrincada, pero mucho más ordenada de lo que Robert May sospechó al pronto. Ante todo, las bifurcaciones producen períodos de 2, 4, 8, 16, etc. Después empieza el caos, sin períodos regulares. Luego, cuando se fuerza aún más el sistema, aparecen ventanas con períodos impares. Surge un período 3 estable (ampliación arriba), y a continuación se reinicia la duplicación de períodos: 6, 12, 24, etc. La estructura tiene profundidad infinita. Cuando se amplían porciones de ella (como la parte central de la ventana del período 3, —ampliación abajo—), se asemejan al diagrama entero.

Ampliaciones
Por consiguiente, los científicos de la URSS estaban preparados a escuchar a Smale: su herradura provocó notable conmoción en los años sesenta. Un distinguido físico matemático, Yasha Sinai, tradujo en seguida sistemas similares a expresiones termodinámicas. De manera parecida, cuando la actividad de Lorenz llegó por fin a la física occidental, en la década de 1970, se divulgó también por la Unión Soviética. Y en 1975, cuando Yorke y May se esforzaban en encender el interés de sus colegas, Sinai y otros congregaron prontamente un poderoso grupo de físicos con centro en Gorki. En los últimos años, algunos expertos occidentales en el caos han convertido en norma las visitas regulares a la URSS, con el fin de estar al corriente de los nuevos avances; con todo eso, los más han de darse por satisfechos con la versión de su ciencia en Occidente.
Yorke y May fueron los primeros en el mundo occidental en sentir el pleno impacto de la duplicación de período y en transmitirlo a la comunidad científica. Los escasos matemáticos que habían advertido el fenómeno lo trataron como asunto técnico, como rareza numérica, casi como un juego. No lo juzgaron insignificante, pero sí algo que pertenecía a su universo personal.
Los biólogos no habían tenido en cuenta las bifurcaciones que llevan al caos, tanto porque carecían de refinamiento matemático, como porque no les asistían motivos para explorar el comportamiento desordenado. Los matemáticos habían reparado en las bifurcaciones, pero sin detenerse en ellas. May, que tenía un pie en cada mundo, comprendió que entraba en un campo asombroso y hondo.
§. Una película del caos y un llamamiento mesiánico
Para calar en el sistema, el más sencillo de todos, los científicos habían menester ordenadores más eficaces y potentes. Frank Hoppensteadt, del Courant Institute of Mathematical Sciences (Instituto Courant de Ciencias Matemáticas), de la Universidad de Nueva York, disponía de uno que lo era tanto, que decidió grabar una película.
Hoppensteadt, matemático que luego sintió encendido interés en los problemas biológicos, estudió la ecuación no lineal logística en su Control Data 6600, alimentándola centenares de millones de veces. Tomó fotogramas de la pantalla del ordenador a cada millar de valores distintos del parámetro, a cada mil sintonizaciones diferentes. Comparecieron las bifurcaciones, después el caos y… luego, dentro del caos, las puntitas de orden, efímeras a consecuencia de su inestabilidad. Fugaces granillos de conducta periódica. Al contemplar la película que había hecho, Hoppensteadt creyó volar por encima de un paisaje desconocido. Por un instante, no parecía caótico; al siguiente, se henchía de tumulto impredecible. Jamás se libró del todo del pasmo de aquel momento.
May vio la película. Se puso a cosechar muestras análogas de otros campos, como el genético, el económico y el de la dinámica de fluidos. Tenía dos ventajas, como pregonero del caos, sobre los matemáticos puros. Una era que las ecuaciones sencillas no representaban, a su juicio, la realidad perfectamente. Sabía que se trataba sólo de metáforas, y, por ello, comenzó a preguntarse con cuánta amplitud podían aplicarse las metáforas. La otra ventaja consistía en que las revelaciones del caos afectaban de modo directo a una vehemente controversia que reinaba en su especialidad.

El perfil del diagrama de bifurcación tal como May lo vio en el primer momento, antes de que ordenadores más potentes revelasen su rica estructura.
Al principio de los años setenta, dentro de la ecología conforme May la concebía, una polémica esencial versaba sobre la índole del cambio de la población. Los ecologistas discrepaban de forma que casi correspondía a la personalidad de cada cual. Unos veían el mensaje del mundo como algo ordenado: las poblaciones son regulares y constantes… con excepciones. Otros interpretaban lo contrario: las poblaciones fluctúan de forma inconstante… con excepciones. Puestos a no coincidir, los bandos discrepaban también sobre la aplicación de las matemáticas elevadas a confusas cuestiones biológicas. Quienes estaban convencidos de que las poblaciones eran uniformes, argüían que algunos mecanismos deterministas tenían que regularlas. Y quienes decían que eran irregulares, defendían que las trastornaban factores ambientales impredecibles, lo cual anulaba cualquier sombra de determinismo que pudiera existir. O las matemáticas deterministas producían comportamiento constante, o el fortuito barullo externo acarreaba comportamiento azaroso. No cabía otra posibilidad.
El caos aportó un mensaje sorprendente al debate: sencillos modelos deterministas eran capaces de acarrear lo que parecía comportamiento pletórico de azar. Éste tenía estructura exquisita; pero una parte de él casi no se distinguía del error, al menos en apariencia. El hallazgo dio en lo vivo de la controversia.
Prosiguiendo en su búsqueda en el campo de los sistemas biológicos, con la intención de encontrar modelos caóticos simples, May continuó obteniendo resultados que chocaban con la opinión corriente entre los profesionales. Por ejemplo, se sabía de sobras en epidemiología que las enfermedades generales transitorias se inclinan a presentarse en ciclos regulares o irregulares. El sarampión, la poliomielitis, la rubéola, etc., se extienden y reducen de forma cíclica. May comprendió que tales oscilaciones podían representarse con un modelo no lineal, y rumió qué sucedería si un sistema como aquél sufría un impulso inesperado, una perturbación como una campaña de vacunación. Lo más elemental es pensar que el sistema se encaminará sin sobresaltos en la dirección ansiada. Pero, en realidad, May halló que era probable que se originasen grandes oscilaciones. Incluso cuando la tendencia a largo plazo descendía sin titubeos, la senda hacia un equilibrio nuevo se interrumpía con cúspides llamativas. De hecho, en los datos de programas prácticos, tales como una campaña para eliminar la rubéola del Reino Unido, los médicos habían percibido oscilaciones como las que había vaticinado el modelo de May. Y cualquier funcionario de la sanidad pública, ante una crisis aguda a corto plazo de rubéola, creería que el programa había fracasado.
El estudio del caos imprimió en pocos años un fuerte impulso a la biología teórica, y unió a biólogos y físicos en doctas asociaciones, inconcebibles en el período inmediato anterior. Los ecologistas y epidemiólogos exhumaron datos que los científicos precedentes habían descartado por ser demasiado engorrosos. Se descubrió caos determinista en los registros de epidemias de sarampión en Nueva York, así como en dos siglos de fluctuaciones que habían señalado los tramperos de la Compañía de la Bahía de Hudson. Los biólogos moleculares empezaron a concebir las proteínas como sistemas en movimiento. Los fisiólogos contemplaron los órganos no como estructuras estáticas, sino como complejos de oscilaciones, ya regulares, ya irregulares.
May estaba al corriente de que los especialistas siempre habían notado el complicado comportamiento de los sistemas, y que habían discutido sobre él. Cada ciencia pensó que su género privativo de caos era especial en sí mismo. Aquello desesperó a todos. ¿Y si el azar aparente brotaba de modelos simples? ¿Y si los mismos modelos simples se aplicaran a la complejidad en diferentes campos? May advirtió con claridad que las asombrosas estructuras, que apenas habían empezado a explorar, no estaban vinculadas de modo intrínseco, exclusivo, con la biología. Se preguntó cuántos cultivadores de otros saberes se sentirían tan desconcertados como él. Puso manos a la obra en lo que imaginó como su artículo «mesiánico», la reseña que Nature publicó en 1976.
El mundo mejoraría, aseguró May, si se daba a todos los estudiantes una calculadora de bolsillo y se les animaba a entretenerse con la ecuación de diferencia logística. Ese cálculo fácil, que detalló cuidadosamente en su artículo de Nature, enmendaría la deformada visión de las posibilidades del mundo que se deriva de la educación científica corriente. Corregiría el modo como la gente concebía todo, desde la teoría cíclica de los negocios hasta la propagación de bulos.
Defendió que debía enseñarse el caos. Había llegado el momento de reconocer que la formación ordinaria de un científico daba una impresión equivocada. Por mucho que se esmerasen las matemáticas lineales, con transformadas de Fourier, funciones ortogonales y regresiones técnicas, le desviaban inevitablemente de su mundo, de abrumadora no linealidad.
«La intuición matemática, que tanto se cultiva, equipa mal al estudiante para enfrentarse con el extravagante comportamiento del más sencillo de los sistemas no lineales discontinuos», escribió May. «No sólo en la investigación, sino también en el orbe cotidiano de la política y la economía, saldríamos ganando si más personas comprendieran que los sistemas no lineales simples no poseen obligatoriamente propiedades dinámicas sencillas».
Capítulo 4
Una geometría de la naturaleza
Y, sin embargo, hay relación.
Una relación minúscula que se amplía como la sombra
de una nube en la arena, una figura en la ladera de una colina.
WALLACE STEVENS,
«Connoisseur of Chaos» (Perito en caos)
§. Un descubrimiento sobre los precios del algodón§. Un descubrimiento sobre los precios del algodón
§. Un refugiado de Bourbaki
§. Errores un la transmisión y cotas melladas
§. Nuevas dimensiones
§. Los monstruos de la geometría fractal
§. Terremotos en la esquizosfera
§. De las nubes a los vasos sanguíneos
§. Los cubos de basura de la ciencia
§. «Ver el mundo en un grano de arena»
Una imagen de la realidad forjada durante años en la mente de Benoît Mandelbrot. En 1960, era el asomo de una idea, visión tenue y borrosa. Pero la reconoció al percibirla, y ello sucedió en la pizarra del gabinete de trabajo de Hendrik Houthakker.
Mandelbrot era un factótum matemático, adoptado y cobijado por el ala de investigación pura de la International Business Machines Corporation (Sociedad International de Máquinas para Negocios, IBM). Se había dedicado, casi como aficionado, al estudio de la actividad económica, para precisar la distribución de las rentas grandes y pequeñas. Houthakker, profesor de economía en Harvard, le había invitado a pronunciar una charla, y cuando llegó al Littauer Center, majestuoso edificio situado al norte del Harvard Yard, el joven matemático se sobresaltó al ver sus hallazgos escritos en la pizarra de su anfitrión. Mandelbrot bromeó con acento quejumbroso — ¿Cómo se ha materializado mi diagrama antes de que diese la conferencia?— y Houthakker no entendió a qué se refería. Lo anotado no tenía relación alguna con la distribución de las rentas; representaba ocho años del precio del algodón.
También desde el punto de vista del profesor, la gráfica resultaba algo anómala. Los economistas solían dar por supuesto que el precio de una mercancía bailaba a dos ritmos distintos, uno ordenado y otro sometido al azar. A largo plazo, los precios experimentaban el empuje de fuerzas reales en la economía: la prosperidad y la debilitación de la industria textil de Nueva Inglaterra, o la apertura de rutas comerciales internacionales. A corto plazo, se agitaban de forma más o menos impensada. Desgraciadamente, los datos de Houthakker no casaban con sus expectativas. Había demasiados saltos importantes. Desde luego, la mayor parte de los cambios de precio era pequeña, pero la relación entre ellos y los grandes no era tan notable como había esperado. La distribución no se interrumpía con suficiente rapidez. Tenía cola larga.

La curva acampanada
Por mucho que los combinara y fraguara con ellos una gráfica, Houthakker no conseguía que los cambios de precios del algodón encajaran en el modelo de la curva acampanada. En cambio, presentaban una imagen cuya silueta Mandelbrot veía ya en los sitios más dispares. A diferencia de muchísimos matemáticos, se enfrentaba con los problemas confiando en su intuición de las pautas y formas. Desconfiaba del análisis y confiaba en sus imágenes mentales. Y ya había tenido el pensamiento de que otras leyes, con diferente comportamiento, podían gobernar los fenómenos estocásticos, fortuitos. Regresó al gigantesco centro de investigación de la IBM en Yorktown Heights (Nueva York), situado en los montes del septentrión del condado de Westchester, con los datos de Houthakker sobre el algodón en una caja de fichas de ordenador. Después solicitó del Ministerio de Agricultura, en Washington, el envío de muchos más, que se remontaron hasta el año 1900.
Como los científicos de otras disciplinas, los economistas salvaban el umbral de la era del ordenador, y descubrían paulatinamente que tendrían la posibilidad de reunir, organizar y manipular información a escala antes inconcebible. Sin embargo, no se disponía de todo género de información, y la que se lograba acopiar había de ser modificada de manera utilizable. También amanecía la era de la perforadora de teclado (keypunch). Los investigadores de las ciencias «duras» encontraron más fácil la tarea de acumular sus miles o millones de datos. Los economistas, como los biólogos, se las habían con un mundo de voluntariosos seres vivos. Y aquéllos estudiaban las criaturas más elusivas de todas.
Pero, al menos, el medio de los economistas suministraba provisión constante de números. Desde el punto de vista de Mandelbrot, los precios del algodón eran fuente ideal de datos. Tenían registros completos y antiguos, puesto que se remontaban a más de un siglo. El algodón formaba parte del universo de la compraventa con un mercado centralizado —y por lo tanto, con archivos centralizados—, pues, desde fines de la centuria anterior, todo el algodón del sur pasaba por la lonja neoyorquina, camino de Nueva Inglaterra, y los precios de Liverpool estaban vinculados a los de Nueva York.
Bien que tuviesen poca cosa en que apoyarse, cuando querían analizar los precios de los artículos de consumo, o los del mercado de valores, eso no significaba que los economistas careciesen de criterio fundamental sobre cómo se obraban los cambios de precios. Antes bien, compartían algunos artículos de fe. Uno consistía en que los cambios pequeños y transitorios no tenían nada en común con los grandes a largo plazo. Las fluctuaciones rápidas sobrevienen de modo ocasional. Los leves altibajos, durante las transacciones de un día, no son sino ruidos parásitos, impredecibles y nada interesantes. Sin embargo, las alteraciones a largo término son de especie enteramente distinta. Los vaivenes acusados de los precios durante meses, años o decenios suceden por la intervención de profundas fuerzas macroeconómicas, las orientaciones de la guerra o la recesión, fuerzas que en teoría eran comprensibles. En un lado, el zumbido de las fluctuaciones de vida corta; en otro, el pitido del cambio a largo plazo.
Ocurrió, no obstante, que la dicotomía no tenía cabida en la imagen de la realidad que Mandelbrot desarrollaba. En vez de separar los cambios minúsculos de los abultados, la imagen los unía. Buscaba pautas no en esta o aquella escala, sino en el seno de las de cualquier tamaño. Andaba muy lejos de saber cómo plasmar aquella criatura de su mente, pero sabía, en cambio, que habría una especie de simetría, no una de izquierda y derecha o de arriba y abajo, sino, más bien, una simetría de escalas grandes y pequeñas.
Mandelbrot halló los asombrosos resultados que perseguía, cuando pasó los datos de los precios del algodón por los ordenadores de la IBM. Los números que introducían aberraciones, desde el punto de vista de la distribución normal, producían simetría desde el de la medición por escalas. Cada cambio particular del precio era azaroso e impredecible. Pero la secuencia de los cambios no dependía de la escala: se hermanaban perfectamente las curvas de los cambios diarios y las de los mensuales. Parecía increíble, pero, según el análisis privativo de Mandelbrot, el grado de variación había permanecido constante durante un período de sesenta años tumultuosos, que presenció las dos guerras mundiales y una depresión económica.
En las resmas de datos más desordenados bullía una especie inesperada de orden. Considerando lo arbitrario de los números que examinaba, ¿por qué, se preguntó Mandelbrot, había de mantenerse en pie cualquier ley? ¿Y por qué se aplicaba igualmente bien a los ingresos personales y a los precios del algodón?
A decir verdad, el conocimiento económico de Mandelbrot era tan parco como su habilidad para comunicarse con los economistas. El artículo que publicó sobre sus hallazgos fue precedido por otro explicativo de uno de sus alumnos, que repitió el material de aquél con el léxico propio de los expertos en economía. Mandelbrot se dedicó a otras cosas, pero retuvo su determinación, cada vez mayor, de investigar el fenómeno de la medición por escalas. Parecía ser una cualidad provista de vida propia: una firma.
§. Un refugiado de Bourbaki
Presentado años más tarde en el prólogo de una conferencia («… enseñó economía en Harvard, ingeniería en Yale, fisiología en la Einstein School of Medicine [Escuela Einstein de Medicina]…»), Mandelbrot comentó con orgullo:
—A menudo, al oír la lista de mis pasadas ocupaciones, llego a dudar de mi existencia. La intersección de tales conjuntos está indudablemente vacía.
Ciertamente, desde sus días en la IBM, ha fracasado en arraigar en una larga lista de campos científicos. Fue siempre un extraño, que abordaba de forma heterodoxa un rincón poco favorecido de las matemáticas, exploraba disciplinas en que en contadas ocasiones tenía buena acogida, disimulaba sus ideas más notables con el fin de que sus artículos se publicaran, y sobrevivía gracias sobre todo a la confianza de sus jefes en Yorktown Heights. Efectuó incursiones en materias como la economía y se retiró, dejando tras sí ideas intrigantes, pero, raramente, obras bien fundadas.
Mandelbrot siguió un camino personal en la historia del caos. La imagen de la realidad que apuntó en su mente en 1960 se transformó de rareza en geometría sazonada. Para la física que se expandía con el trabajo de personas como Lorenz, Smale, Yorke y May, aquel quisquilloso matemático era algo secundario; pero sus técnicas y léxico llegaron a ser parte inseparable de la nueva ciencia.
Esta descripción habría parecido inadecuada a quienes le conocieron en años posteriores, con su frente alta e imponente y su lista de títulos y galardones. No obstante, Benoît Mandelbrot se concibe mejor como refugiado. Nació en Varsovia en 1924 en el seno de una familia judía lituana; su padre era vendedor al por mayor de trajes, y su madre, dentista. Los Mandelbrot, atentos a la situación geopolítica, se trasladaron a París en 1936, atraídos parcialmente por la presencia en aquella ciudad del tío de Benoît, el matemático Szolem Mandelbrojt. Declarada la guerra, la familia se anticipó una vez más a los nazis. Abandonó sus bienes, salvo unas cuantas maletas, y se incorporó a la riada de fugitivos que atascó las carreteras del sur de París. Llegó, al fin, a la ciudad de Tulle.
Durante cierto tiempo, Benoît vivió como aprendiz de fabricante de herramientas, peligrosamente visible a causa de su estatura y su educación. Fue época de visiones y miedos inolvidables; pero, más tarde, recordó escasas penalidades personales, y rememoró, en cambio, su amistad en Tulle y otros lugares con profesores, algunos de ellos eruditos distinguidos, también desplazados por la contienda. En conjunto, su formación fue irregular y entrecortada. Afirmó después que jamás había aprendido el alfabeto, ni, lo que resultaba más singular, la tabla de multiplicar más allá del cinco. Con todo, estaba muy bien dotado.
Tras la liberación de París, a despecho de su falta de preparación, se presentó a los exámenes orales y escritos, que duraban un mes, de ingreso en la École Normale (Escuela Normal) y la École Polytechnique (Escuela Politécnica), y los aprobó. Entre otras pruebas, había una de dibujo rudimentario, y Mandelbrot descubrió que poseía facilidad latente para copiar la Venus de Milo. En matemáticas —álgebra formal y análisis integrado— logró rebozar su falta de conocimientos con el socorro de su intuición geométrica. Había descubierto que casi siempre conseguía pensar en los problemas analíticos gracias a que una forma surgía en su mente. Acertaba a transformar la figura que fuere, alterando su simetría y haciéndola más armoniosa. A menudo sus transformaciones le llevaban directamente a la solución de los problemas análogos. Tuvo notas bajas en física y química, en las que no podía recurrir a la geometría. En cambio, en matemáticas solventó cuestiones, que jamás hubiera resuelto con la técnica correcta, mediante su manipulación de las formas.
La École Normale y la École Polytechnique eran centros selectos de enseñanza. Preparaban no menos de trescientos alumnos por clase para carreras en las universidades francesas y la administración civil. Mandelbrot empezó en la Normale, la más pequeña y prestigiosa de ambas, pero la abandonó a los pocos días por la Polytechnique. Era ya un refugiado de Bourbaki.
Tal vez en nación alguna excepto en Francia, con su debilidad por las academias autoritarias y las reglas establecidas sobre la enseñanza, pudo crearse Bourbaki. Nació como club, fundado durante la inquieta estela de la primera guerra mundial por Szolem Mandelbrojt y un grupito de jóvenes, que buscaban el modo de reedificar las matemáticas francesas. Las tristes consecuencias de la lucha habían abierto un hueco entre los profesores universitarios y los estudiantes, rompiendo la tradición de continuidad académica, y aquellos jóvenes sobresalientes se dispusieron a sentar nuevos cimientos para la práctica matemática. El nombre de la agrupación era una broma esotérica, adoptado por su sonido exótico y atractivo —así se supuso más tarde—: el apellido de un general francés de origen griego que vivió en el siglo XIX. Bourbaki se originó de un impulso travieso que pronto desapareció.
Sus miembros se reunían en secreto. Ni siquiera se sabe cómo se llamaban todos. Su número era fijo. Cuando dimitía un componente, a los cincuenta años de edad, como había sido pactado, los demás elegían su sustituto. Eran los matemáticos mejores y más brillantes, y su influencia no tardó en abarcar todo el continente europeo.
Bourbaki se formó, en parte, como reacción a Poincaré, el gran hombre de la segunda mitad del siglo XIX, pensador de formidable producción y escritor al que el rigor preocupaba menos que a otros hombres de ciencia. Si sé que tengo razón, ¿por qué he de probarla?, solía decir. Bourbaki opinaba que Poincaré había legado una base insegura a las matemáticas, y se puso a escribir un tratado enorme, de corte cada vez más fanático, para llevar a la disciplina por el buen camino. El meollo estaba en el análisis lógico. El matemático debía comenzar con principios sólidos y deducir de ellos el resto. El grupo insistía en la primacía de su especialidad sobre las restantes ciencias, así como en su independencia de ellas. Las matemáticas eran matemáticas, y no había que evaluarlas según su aplicación a los fenómenos físicos naturales. Y, por encima de todo, Bourbaki rechazaba el empleo de figuras. El aparato visual podía engañar a cualquier matemático. La geometría no era digna de confianza. Las matemáticas tenían que ser puras, formales y austeras.
No se trataba de una manifestación estrictamente francesa. Los matemáticos estadounidenses se apartaban de las demandas de las ciencias físicas con la misma determinación con que los artistas y escritores se alejaban de las exigencias del gusto popular. Prevalecía una sensibilidad hermética. Los temas de las matemáticas se hicieron autónomos, y su método, formalmente axiomático. Quienes se especializaban en ellas se jactaban de que su trabajo no atañía al mundo ni a la ciencia. Atesoraron los grandes beneficios que rindió tal actitud. Steve Smale, aun cuando se esforzaba en unir las matemáticas y las ciencias naturales, creía, con la intensidad con que acostumbraba creer, que las matemáticas habían de ser algo aparte. La independencia iba acompañada de claridad. Y ésta asía de la mano al rigor del método axiomático. Cualquier matemático serio comprende que el rigor es la fuerza distintiva de la disciplina, su armazón de acero, a falta del cual todo se desmoronaría. Es lo que autoriza a los matemáticos a seguir una trayectoria del pensamiento que dura hace siglos, y a avanzar conforme a ella, con inagotable garantía de eficacia.
Ello no obstante, las demandas de rigor tuvieron consecuencias inesperadas para los matemáticos en el siglo XX. Su ciencia está sometida a una clase especial de evolución. El investigador elige un problema y empieza tomando una decisión sobre qué camino debe emprender. A menudo, la decisión implica la elección entre una vía matemáticamente posible y otra interesante desde el punto de vista de la interpretación de la naturaleza. Para el matemático la elección es evidente: abandonar de momento toda relación clara con la naturaleza. Sus alumnos optarán por algo similar y tomarán una decisión parecida.
En ningún lugar estos valores estaban tan codificados como en Francia, y en ella Bourbaki triunfó como sus fundadores jamás hubiesen imaginado. Sus preceptos, estilo y notación se hicieron obligatorios. Alcanzó la invencible rectitud que nace de imponerse a los mejores estudiantes y de producir un caudal constante de matemáticas logradas. Su dominio en la École Normale era absoluto, e insoportable para Mandelbrot. Huyó de aquella escuela por culpa de Bourbaki y, diez años después, de Francia por la misma razón, y se acogió a los Estados Unidos. Al cabo de pocas décadas, la despiadada abstracción de Bourbaki agonizaría a causa del ordenador, capaz de proporcionar una desconocida matemática visible. Pero eso ocurrió demasiado tarde para Mandelbrot, que soportó el formalismo de Bourbaki y fue reacio a abandonar su intuición geométrica.
§. Errores un la transmisión y cotas melladas
Mandelbrot, fervoroso creyente en la necesidad de inventar una mitología propia, añadió esta declaración a su entrada en Who’s Who: «La ciencia se irá al traste si (como los deportes) coloca el afán competitivo por encima de todo, y si precisa del reglamento de la competición acogiéndose a especialidades estrictamente definidas. Los poquísimos eruditos que son nómadas por elección individual resultan esenciales para el bienestar intelectual de las disciplinas establecidas». Este nómada por voluntad propia, que se llamaba pionero por necesidad, se apartó de la academia cuando se fue de Francia y aceptó la hospitalidad del Thomas J. Watson Research Center (Centro de Investigaciones Thomas J. Watson), de la IBM. Durante un viaje de treinta años de la oscuridad a la eminencia, jamás vio su obra aceptada por las muchas disciplinas a las que la destinó. Incluso los matemáticos decían, sin malicia aparente, que, fuese lo que fuere, Mandelbrot no pertenecía a su número.
Encontró su camino despacio, siempre con la complicidad de un extravagante conocimiento de las sendas desviadas de la historia científica. Se aventuró en la lingüística matemática, explicando una ley de la distribución de las palabras. (Disculpándose del simbolismo, insistió en que el problema le había llamado la atención en la reseña de un libro, rescatado de la papelera de un matemático puro para tener algo que leer en el metro parisiense). Investigó la teoría del juego. Entró y salió de la economía. Escribió sobre la escala de las regularidades en la distribución de las ciudades grandes y pequeñas. El armazón general que trababa su obra siguió disimulado en el fondo, incompletamente formado.
En el tiempo inicial de su estancia en la IBM, poco después de su estudio del precio de las mercancías, encontró un problema práctico que preocupaba mucho a la entidad. Tenía perplejos a los ingenieros el ruido que había en las líneas telefónicas que transmitían información de un ordenador a otro. La corriente eléctrica lleva la información en grupos aislados, y los ingenieros sabían que bastaba intensificar la corriente para que apagase el ruido con mayor eficacia. Pero descubrieron que nunca llegaba a eliminarse cierto ruidillo espontáneo. De tarde en tarde, anulaba un fragmento de señal y producía un error.
Si bien por su índole el ruido de transmisión era caprichoso, se sabía que llegaba en cúmulos. A períodos de comunicación intachable sucedían otros erróneos. Mandelbrot pronto se enteró, en sus charlas con los ingenieros, de que había una idea folklórica sobre el fenómeno, la cual no se había legitimado, porque discrepaba de todos los criterios usuales: cuanto más estrechamente se examinaban los cúmulos, tanto más complicadas parecían las pautas de los errores. Mandelbrot suministró un método para describir la distribución de lo erróneo que predecía certeramente las pautas observadas. No obstante, era sobremanera peculiar. Entre otras cosas, imposibilitaba calcular una proporción media de equivocaciones, un número de promedio por hora, minuto o segundo. Por término medio, en el esquema de Mandelbrot, los errores se acercaban a la difusión infinita.
Su descripción se efectuó estableciendo separaciones cada vez más repetidas entre los períodos de transmisión limpia y los que no lo eran. Supóngase que se divide un día en horas. Pueden transcurrir sesenta minutos exentos de errores. Después una hora puede contenerlos. Luego llega otra sin ellos.
Pero, si se distribuía la hora con equivocaciones en segmentos de veinte minutos, se advertía que algunos no contenían errores, y otros una suma de ellos. De hecho, explicó Mandelbrot —en contra de la intuición—, nunca se encontraría un momento en que las equivocaciones se distribuyeran de forma continua. En una manifestación súbita de errores, por breve que fuese, habría indefectiblemente períodos de transmisión limpia. Además, descubrió una consistente relación geométrica entre los estallidos de errores y los espacios correctos. En escalas de una hora o de un segundo, la proporción entre ambos permanecía constante. (En una ocasión, con espanto de Mandelbrot, un paquete de datos semejó contradecir su esquema; pero resultó que los ingenieros no habían registrado los casos extremos en la persuasión de que no tenían importancia).
Los ingenieros no estaban preparados para entender la descripción de Mandelbrot, pero los matemáticos sí. En efecto, Mandelbrot copiaba una construcción abstracta denominada conjunto de Cantor, de Georg Cantor, matemático del siglo XIX. Se obtiene representando con un segmento de recta el intervalo de los números de cero a uno. Se divide en tres partes, de las cuales se elimina la central. De esta manera, restan dos segmentos, cuyo tercio medio se anula (de un noveno a dos novenos, y de siete novenos a nueve novenos). Persisten cuatro segmentos, de los cuales se elimina la tercera parte media, y así hasta el infinito. ¿Qué resta? Un extraño «polvo» de puntos, dispuestos en grupos, en cantidad infinita, e infinitamente dispersos. Mandelbrot concebía la transmisión de errores como un conjunto de Cantor temporalmente concebido.
Esta descripción tan abstracta tenía valor práctico para los científicos deseosos de optar entre maneras distintas de controlar el error. De modo particular, significaba que, en lugar de acrecentar la fuerza de la señal con el propósito de amortiguar progresivamente el ruido, los ingenieros debían escoger una señal modesta, aceptar lo inevitable de las equivocaciones y emplear una estrategia de redundancia para apresarlas y corregirlas. Mandelbrot cambió asimismo la forma como los ingenieros de la IBM pensaban en la causa del ruido. Los estallidos de error les habían inducido siempre a buscar a alguien culpable de meter un destornillador donde no debía. Mas las pautas de escala de Mandelbrot apuntaban a que jamás se explicaría el ruido achacándolo a hechos locales específicos.
Tras lo anterior, Mandelbrot se concentró en datos referentes a los ríos. Los egipcios han conservado durante milenios registros de la altura del nivel del Nilo. Y no por afición gratuita. El Nilo suele experimentar grandes variaciones de caudal: unos años se desborda inconteniblemente, y otros su corriente se apoca. Mandelbrot clasificó esta variación según dos clases de efectos, comunes también en economía, a los que dio el nombre de efectos de Noé y de José.

El polvo de Cantor.
Empiécese con una recta; retírese su tercio central; después quítese el tercio medio de los segmentos restantes, etc. El conjunto de Cantor es el polvo de puntos que subsiste. Son infinitos, pero su longitud total es 0. Las cualidades paradójicas de construcciones como éstas desconcertaron a los matemáticos del siglo XIX; pero Mandelbrot vio en el conjunto de Cantor un modelo de la aparición de errores en una línea electrónica de transmisión. Los ingenieros observaban períodos de transmisión libre de fallos, mezclados con otros en que los fallos sobrevenían en tropel. Estudiadas con atención, aquellas rachas contenían también períodos exentos de errores, y así sucesivamente. Era una muestra de tiempo fractal. En cada escala temporal, desde horas a segundos, Mandelbrot descubrió que permanecía constante la relación de los errores con la transmisión pura. Esos polvos, afirmó, son indispensables para establecer modelos de intermitencia.
El efecto de José significa persistencia. He aquí que vienen siete años en que habrá abundancia en toda la tierra de Egipto. Luego les sucederán siete años de hambre. Si la leyenda bíblica pretendía indicar periodicidad, lo hacía con excesiva simplificación. Pero las inundaciones y las sequías persisten. A pesar de la intervención siempre posible del azar, cualquier lugar que haya sufrido sequía se halla expuesto a sufrirla de nuevo. Además, el análisis matemático del nivel del Nilo mostró que la persistencia tenía vigor tanto durante siglos como durante décadas. Los efectos de Noé y de José van en direcciones opuestas, pero equivalen a decir: las tendencias son reales en la naturaleza, pero pueden desvanecerse tan prontamente como aparecieron.
Discontinuidad, ruidos súbitos, polvos de Cantor… Fenómenos como ellos no habían tenido acogida en la geometría de los dos milenios anteriores. Las figuras de la clásica son líneas y planos, círculos y esferas, triángulos y conos. Representan una abstracción poderosa de la realidad, e inspiran una atractiva filosofía de armonía platónica. Euclides hizo de ellas una geometría que duró dos mil años, la única que estudia todavía la inmensa mayoría de los seres humanos. Los artistas encontraron en ellas una belleza ideal; los astrónomos tolemaicos construyeron una teoría del universo con ellas. Mas, para entender la complejidad, su abstracción resulta inconveniente.
Mandelbrot suele decir que las nubes no son esferas. Ni los montes conos. Ni el rayo fulmina en línea recta. La nueva geometría refleja un universo áspero, no liso, escabroso, no suave. Es la geometría de lo picado, ahondado y quebrado, de lo retorcido, enmarañado y entrelazado. La comprensión de la complejidad de la naturaleza convenía a la sospecha de que no era fortuita ni accidental. Exigía fe en que el interesante fenómeno de la trayectoria del rayo, por ejemplo, no dependía de su dirección, sino de la distribución de sus zigzags. La obra de Mandelbrot era una reivindicación del mundo, la exigencia de que formas tan raras gozaban de significado. Los hoyos y marañas eran algo más que distorsiones que afeaban las figuras de la geometría euclidiana. Con frecuencia servían de clave de la esencia de una cosa.
Por ejemplo, ¿cuál era la esencia de la línea de una costa? Mandelbrot hizo esta pregunta en un artículo que se convirtió en punto decisivo de su pensamiento: «How Long Is the Coast of Britain?» (¿Qué longitud tiene la costa de Gran Bretaña?).
Había encontrado la cuestión del litoral en un oscuro artículo póstumo de un científico inglés, Lewis F. Richardson, que anduvo a tientas en una cantidad sorprendente de temas que luego serían parte del caos. Escribió sobre la predicción numérica del tiempo atmosférico en el decenio de 1920, estudió la turbulencia de los fluidos vaciando un saco de chirivías blancas en el canal de Cape Cod y quiso saber en un artículo de 1926 «Does the Wind Possess a Velocity?» (¿Posee velocidad el viento?) («La pregunta, estúpida de buenas a primeras, mejora con el estudio», escribió). Intrigado por las líneas costeras y el trazado retorcido de las fronteras nacionales, Richardson compulsó enciclopedias sobre España y Portugal, Bélgica y Holanda, y encontró un veinte por ciento de discrepancias en la longitud calculada de sus límites comunes.
El análisis de este asunto que realizó Mandelbrot chocó a los demás como algo dolorosamente evidente o absurdamente falso. Comprobó que casi todas las personas respondían de una de dos formas: «Lo ignoro; no es mi especialidad» o «No lo sé, pero consultaré una enciclopedia».
Pues bien, afirmó, cualquier litoral es —en cierto sentido— de longitud infinita. En otro sentido, la contestación depende de la largura de la regla. Considérese un método plausible de medición. Un agrimensor abre un compás de cuadrante y lo fija en la amplitud de un metro. Recorre con él la línea costera. La cantidad resultante de metros es sólo una aproximación de la longitud auténtica, porque el agrimensor prescinde de las concavidades y retorcimientos menores de un metro; no obstante, anota los números conseguidos. A continuación, fija el compás en una amplitud inferior —por ejemplo, un palmo— y repite el procedimiento. Obtiene así una largura algo mayor, porque el compás habrá seguido mejor los detalles y recorrido en algo más de tres veces la misma distancia salvada antes con la proporción de un metro. Anota el resultado. Después gradúa el compás en diez centímetros, y empieza nuevamente. Este experimento mental con un compás de cuadrante imaginario es una forma de expresar el efecto de observar un objeto desde distancias distintas y a escalas diferentes. Quien calcule la longitud del litoral británico desde un satélite artificial obtendrá un resultado inferior que quien recorra sus abras y playas, el cual será menor que el del caracol que se deslice por cada guijarro.

Una costa fractal.
Un litoral generado con un ordenador. Los detalles son fortuitos; como, sin embargo, la dimensión fractal resulta constante, el grado de escabrosidad o irregularidad tiene el mismo aspecto por mucho que se amplíe la imagen.
§. Nuevas dimensiones
Puesto que las mediciones euclídeas —largura, anchura y espesor— no alcanzaban a apresar la esencia de las formas irregulares, Mandelbrot recurrió a una noción diversa, la de dimensión. Ésta es una cualidad de vida mucho más rica para los científicos que para los profanos. Ocupamos un mundo tridimensional, lo que significa que necesitamos números para especificar un punto, como, por ejemplo, longitud, latitud y altitud. Las tres se figuran como direcciones situadas en ángulo recto una con otra. Es otra muestra del legado geométrico de Euclides, en que el espacio tiene tres dimensiones, el plano dos, la línea una y el punto cero.
El procedimiento de abstracción que permitió a Euclides concebir objetos unidimensionales o bidimensionales irrumpe en nuestra utilización de las cosas cotidianas. Un mapa de carreteras es, en la práctica, un objeto de dos dimensiones, el fragmento de un plano. Utiliza su quintaesencia bidimensional para aportar información de una clase precisa de dos dimensiones. En realidad, claro está, los mapas de carreteras son tridimensionales como todas las cosas, pero tienen tan poco espesor (y éste es tan desdeñable para su cometido), que se puede olvidar. Persiste en ser bidimensional hasta cuando se le dobla. Por lo mismo, un hilo es efectivamente unidimensional y una partícula carece efectivamente de dimensión.
Entonces, ¿qué dimensión posee un ovillo de bramante? Mandelbrot contestó: Depende del punto de vista. Observado desde mucha distancia, el ovillo se aprecia como un punto adimensional. Desde más cerca llena un espacio esférico, de tres dimensiones. A un palmo de distancia, se ve el bramante, y el objeto se hace efectivamente unidimensional, aunque esa sola dimensión esté enmarañada alrededor de sí misma de manera que emplea el espacio tridimensional. Persiste la utilidad de la idea de cuántos números se necesitan para especificar un punto. Desde lejos, no requiere ninguno: el punto es todo lo que hay. Desde más cerca, necesita tres. Y, desde más cerca todavía, uno basta: cualquier posición dada a lo largo de la extensión del bramante es única, esté estirado, o desenrollado, o forme un ovillo.
Y siguiendo adelante, hacia las perspectivas microscópicas, se transforma en columnas tridimensionales, las columnas se reducen a fibras unidimensionales y el material sólido se disuelve en punto de dimensiones nulas o iguales a cero. Mandelbrot apeló, amatemáticamente, a la relatividad: «La noción de que un resultado numérico depende de la relación del objeto con el observador está en el espíritu de la física de este siglo, y es incluso ilustración ejemplar de ello».
Pero, filosofías aparte, la dimensión efectiva de una cosa resulta diferente de sus tres dimensiones mundanales. Un extremo endeble de la argumentación de Mandelbrot parecía consistir en su confianza en ideas vagas tales como «desde lejos» y «desde más cerca». ¿Qué había en medio? Desde luego, no existía un límite preciso en el que un ovillo de bramante se convertía de objeto tridimensional en uno unidimensional. Distando mucho de ser una debilidad, la índole mal definida de aquellas transiciones condujo a una noción nueva del problema de las dimensiones.
Mandelbrot fue más allá de las 0, 1, 2, 3…; fue a una imposibilidad aparente: las dimensiones fraccionales. La idea es un funambulismo conceptual. De quienes no son matemáticos exige una obediente suspensión de la incredulidad. A pesar de ello, tiene extraordinaria eficacia.
La dimensión fraccional representa el medio de ponderar cualidades que, de otra suerte, carecerían de definición clara, como el grado de escabrosidad, discontinuidad o irregularidad de un objeto. Una costa serpenteante, por ejemplo, pese a su inmensurabilidad en cuanto a la longitud, posee cierto grado característico de escabrosidad. Mandelbrot especificó modos de calcular la dimensión fraccional de los objetos reales, dada una técnica para construir una figura o dados algunos datos, y permitió que su geometría reclamase ciertos presupuestos sobre las pautas irregulares que había estudiado en la naturaleza. Un presupuesto era que el grado de irregularidad permanece constante a diferentes escalas. Esta pretensión acostumbra ser sorprendentemente afinada. Una y mil veces, el mundo exhibe irregularidad regular.
En una tarde invernal del año 1975, consciente de las orientaciones paralelas que surgían en la física, y mientras preparaba la publicación de su primera obra importante, Mandelbrot pensó que sus figuras, dimensiones y geometría debían tener nombre. Su hijo había vuelto de la escuela, y Mandelbrot se puso a hojear el diccionario latino del muchachito. Dio con el adjetivo fractus, derivado del verbo frangere, romper. La resonancia de los principales vocablos ingleses afines—fracture, fractura, y fraction, fracción— se le antojó idónea. Y creó la palabra fractal (sustantivo y adjetivo).

El copo de nieve de Koch.
«Un tosco, pero vigoroso modelo de línea costera», al decir de Mandelbrot. Para construir una curva de Koch, empiécese con un triángulo cuyos lados tienen longitud 1. En el centro de cada uno, agréguese otro nuevo triángulo, que mida un tercio del original, etc. La largura del límite es 3 × 4/3 × 4/3 × 4/3…: infinito. No obstante, su área es menor que la de un círculo trazado alrededor del triángulo primitivo. Por lo tanto, una línea infinitamente larga rodea un área finita.

La curva de Koch.
Un fractal es una manera de ver lo infinito con el ojo de la mente. Imagínese un triángulo; cada uno de sus lados mide treinta centímetros. Imagínese también una transformación: un conjunto de reglas particulares, bien definido y fácil de aplicar en todas las ocasiones que se desee. En la tercera parte central de cada lado, aplíquese otro triángulo, de forma idéntica, pero de un tercio del tamaño del primitivo.
Se obtiene una estrella de David. En lugar de tres segmentos de treinta centímetros, el contorno de la figura se compone ahora de doce de diez centímetros. Seis puntos han sustituido los tres originales.
A renglón seguido, repítase la transformación en cada uno de los doce lados, en cuyo tercio central se colocará un triangulito. Y así sucesivamente hasta el infinito. El contorno presentará detalles más numerosos tras cada nueva división, del mismo modo que un conjunto de Cantor se esparce cada vez más. Adquiere el aspecto de un ideal copo de nieve. Es lo que se conoce por una curva de Koch —por curva se entiende cualquier línea enlazada, sea recta, sea arqueada—, llamada así en honor de Helge von Koch, de Suecia, que la describió originalmente en 1904.
La reflexión muestra algunos rasgos interesantes de la curva de Koch. Ante todo, es continua, pues jamás se interseca: los nuevos triángulos de cada lado son siempre lo bastante pequeños para entremeterse en los otros. Cada mutación añade una pequeña área en el interior de la curva; pero el área total se mantiene finita, es decir, en realidad no mucho más grande que el triángulo primitivo. Si se trazase un círculo alrededor de éste, la figura de Koch nunca se extendería más allá de él.
Con todo, la curva es en sí infinitamente larga, tanto como una línea recta euclidiana que se extiende hasta los bordes de un universo ilimitado. Así como la primera transformación sustituye un segmento de treinta centímetros con cuatro de diez, así cada modificación multiplica la longitud total por cuatro tercios. Este resultado paradójico, el de una longitud infinita en un espacio finito, desconcertó a muchos matemáticos del comienzo de este siglo que lo estudiaron. La curva de Koch era monstruosa, irrespetuosa de toda intuición razonable sobre las figuras y —casi no merece la pena decirlo— patológicamente distinta de todo lo que podía encontrarse en la naturaleza.

Una construcción efectuada con agujeros.
Unos pocos matemáticos concibieron, a principio del siglo XX, objetos en apariencia monstruosos, utilizando la técnica de añadir o quitar sin límite muchas de sus partes. Una de tales figuras es la alfombra de Sierpinski. Se construye cortando en el centro una novena parte del cuadrado; después se hace lo mismo con los centros de los ocho cuadraditos que quedan, etc. Un parangón tridimensional es la esponja de Menger, enrejado de aspecto sólido, que tiene área superficial infinita y volumen nulo o cero.
La mente no puede visualizar la interminable auto inclusión de la complejidad. Sin embargo, para quien dispone de la capacidad de pensar sobre la forma como un geómetra, este género de repetición de la estructura, a escala de tenuidad creciente, abre un mundo entero. Explorar aquellas figuras, apretar con los dedos de la inteligencia los bordes elásticos de sus posibilidades, era como un juego, y Mandelbrot se divirtió como un niño en ver variaciones que nadie había percibido, o entendido, antes de él. Cuando carecían de nombre, se lo daba: cuerdas y láminas, esponjas y espumas, cuajadas y tomadores.
La dimensión fraccional probó que era precisamente la vara idónea de medir. En algún sentido, el grado de irregularidad correspondía a la eficacia del objeto para ocupar espacio. Una simple línea euclídea unidimensional no ocupa ninguno. Pero sí lo hace el contorno de la curva de Koch, de longitud infinita condensada en una superficie finita. Es algo más que una línea y menos que un plano. Es mayor que una forma unidimensional y menor que una bidimensional. Mandelbrot caracterizó la dimensión fraccional con ayuda de técnicas de matemáticos del principio de este siglo, que habían sido olvidadas. En cuanto a la curva de Koch, la multiplicación infinitamente persistente por cuatro tercios da una dimensión de 1,2618.
Al seguir este camino, Mandelbrot tenía dos grandes ventajas sobre los escasos matemáticos que habían reflexionado sobre aquellas figuras. Una era su acceso a los recursos informáticos que condicen con el nombre de la IBM. Se trataba de una tarea ideal para la especial forma de rapidísima necesidad del ordenador. Si los meteorologistas necesitaban efectuar unos pocos cálculos sobre millones de puntos vecinos en la atmósfera, Mandelbrot había de realizar una y mil veces una transformación, programada con sencillez. El ingenio podía concebir transformaciones, y los ordenadores diseñarlas, en ocasiones con resultados inesperados. Los matemáticos de los años iniciales de este siglo llegaban en seguida a una barrera de cálculo enrevesado, semejante a la que se oponía a los protobiólogos desprovistos de microscopios. La imaginación era lo único que avanzaba en la contemplación de un universo de detalles progresivamente más sutiles. En palabras de Mandelbrot:
—Había un ancho hiato, de un centenar de años, en que el dibujo careció de función en las matemáticas, porque la mano, el lápiz y la regla estaban agotados. Se entendían bien y habían quedado rezagados. Y el ordenador no existía.La segunda ventaja de Mandelbrot se basaba en la imagen de la realidad que había comenzado a moldear en sus tratos con los precios del algodón, el ruido en la transmisión electrónica y las riadas. Y ese concepto principiaba a concretarse. Sus estudios de las pautas irregulares en los procesos naturales, y su exploración de las formas infinitamente complejas, tenían una intersección intelectual: una cualidad de auto semejanza. Fractal significaba, sobre todo, auto semejante.
»Había una total ausencia de intuición cuando entré en este juego. Tenía que crearse. La intuición, dirigida por los instrumentos usuales —mano, lápiz y regla—, pensó que estas figuras eran monstruosas, patológicas. Pero inducía a error. Las primeras formas me sorprendieron mucho; después reconocí varias por haberlas encontrado antes, luego otras por la misma razón, etc.
»La intuición no es algo dado. Adiestré la mía para que aceptase como lógicas figuras que se rechazaban inicialmente por absurdas, y creo que todo el mundo puede hacer lo mismo.
La auto semejanza quiere decir simetría dentro de una escala. Implica recurrencia, pauta en el interior de pauta. Los gráficos de precios y de ríos la mostraban, pues no sólo producían detalles a escala constantemente menor, sino también los brindaban con ciertas medidas persistentes. Figuras monstruosas como la curva de Koch revelan auto semejanza, porque tienen aspecto idéntico incluso bajo gran aumento óptico. Se encuentra en la técnica de construcción de curvas; la misma transformación se reitera a escala cada vez más pequeña. La auto semejanza es cualidad que se reconoce con facilidad. Sus imágenes se encuentran en todas partes: en el reflejo infinitamente interminable de una persona situada entre dos espejos, o en la noción, propia de los dibujos animados, de un pez que engulle a otro más chico, y éste a otro, etc. Mandelbrot se complace en citar a Jonathan Swift:
«Así, como el naturalista observa, una mosca§. Terremotos en la esquizosfera
Tiene moscas más pequeñas que la devoran,
Y estas otras más minúsculas que las pican,
Y en adelante hasta el infinito»
El mejor lugar para estudiar los terremotos, en el nordeste de los Estados Unidos, es el Lamont-Doherty Geophysical Observatory (Observatorio Geofísico de Lamont-Doherty), conjunto de edificios poco atractivos escondidos en los bosques del mediodía del estado de Nueva York, justo al oeste del río Hudson. En esa institución, Christopher Scholz, profesor de la Universidad de Columbia y especialista en la forma y la estructura de la tierra sólida, comenzó a reflexionar sobre los fractales.
Los matemáticos y físicos teóricos hacían caso omiso de la obra de Mandelbrot; en cambio, Scholz era un científico pragmático y eficaz y estaba más que dispuesto a empuñar las herramientas de la geometría fractal. Había conocido en la década de 1960 el nombre de Benoît Mandelbrot, cuando éste se dedicaba a la economía, y él, Scholz, era estudiante graduado del MIT, en el que invertía la mayor parte de su tiempo en luchar con una cuestión irreductible acerca de los seísmos. Desde hacía veinte años, se sabía que la distribución de los terremotos, intensos y débiles, obedecía a una especial pauta matemática, la misma precisamente que regía la distribución de las rentas individuales en una economía de mercado libre. Dicha distribución se observaba en todos los lugares terrestres en que los seísmos se registraban y medían. Si se tenía en cuenta cuán irregulares e imprevisibles eran los terremotos, merecía la pena preguntarse qué género de procesos físicos explicaba tal regularidad. O, al menos, así lo creía Scholz. La generalidad de los sismólogos se había contentado con tomar nota del fenómeno sin detenerse en él.
Scholz recordaba el nombre de Mandelbrot. En 1978 compró un libro, muy ilustrado, de erudición extravagante y cuajado de ecuaciones, titulado Fractals: Form, Chance and Dimension (Fractales: Forma, casualidad y dimensión). Mandelbrot había reunido, por lo visto, en un volumen divagador todo lo que sabía o sospechaba del universo. En pocos años tanto aquel libro como su sustituto, ampliado y refinado, The Fractal Geometry of Nature (La geometría fractal de la naturaleza), habían sido más vendidos que cualquier otro de matemáticas superiores. Su estilo era abstruso y exasperante, ya ocurrente, ya literario, ya opaco. El mismo Mandelbrot lo llamaba «manifiesto y registro de casos».
Como contados especialistas en otras disciplinas, en especial científicos que trabajaban en partes materiales de la naturaleza, Scholz había tratado de averiguar durante varios años qué debía resolver sobre aquel volumen. No era cuestión meridiana. Fractals, como expresó Scholz, «no era un libro práctico, sino de magia». No obstante, le interesaban mucho las superficies, y las superficies llenaban la obra. Scholz notó que era incapaz de dejar de meditar sobre la promesa que encerraban las ideas de Mandelbrot. Buscó el modo de emplear los fractales para describir, clasificar y medir lo que atañía a sus intereses científicos.
Pronto descubrió que no estaba solo, a pesar de que transcurriría bastante tiempo antes de que se multiplicaran las conferencias y los seminarios sobre los fractales. Las ideas unificadoras de la nueva geometría apiñaron a hombres de ciencia convencidos de que sus observaciones eran excéntricas, y de que no había método sistemático para entenderlas. Las visiones intuitivas de la geometría fractal ayudaron a los científicos que investigaban cómo se unían las cosas, cómo se ramificaban o cómo se quebraban. Era un procedimiento para examinar la materia: las caras de los metales microscópicamente dentadas, los agujeros y canales minúsculos de la roca petrolífera porosa y los paisajes fragmentados de una comarca asolada por un terremoto.
En opinión de Scholz, los geofísicos debían describir la superficie terrestre, aquella que, por coincidir con los océanos, forma los litorales. Dentro de la parte superior de la tierra sólida hay superficies de otra clase, superficies de hendiduras. Las fallas y fracturas abundan tanto, que se convierten en clave de toda buena descripción, y son más importantes, en conjunto, que la materia que recorren. Atraviesan la corteza terrestre en tres dimensiones, creando lo que Scholz denominó eutrapélicamente «la esquizosfera». Gobiernan el paso de fluidos por el terreno: el del agua, el petróleo y el gas natural. Rigen el comportamiento de los terremotos. Por lo tanto, era esencial entender las superficies, y Scholz creía que su profesión se hallaba en un brete, porque no existía método alguno para hacerlo.
Los geofísicos consideraban las superficies como todo el mundo, a saber, como figuras. Tenían que ser planas. O poseer forma especial. Era posible contemplar la silueta de un «escarabajo» Volkswagen, por ejemplo, y dibujar su superficie como una curva, la cual sería mensurable del modo euclídeo familiar. Se podía adaptar una ecuación a ella. Pero en el criterio de Scholz, se la vería entonces sólo a través de una estrecha banda espectral, lo mismo que si se contemplase el universo por medio de un filtro rojo: se percibiría lo que había en esa particular longitud de onda luminosa, pero no en la de los demás colores, para no mencionar el vasto ámbito de actividades en porciones del espectro correspondiente a la radiación infrarroja o a las ondas de radio. En este símil, el espectro equivalía a la escala. Pensar en la superficie de un Volkswagen, considerando sólo su figura euclídea, era concebirla únicamente a la escala de un observador apostado a diez o a cien metros del coche. ¿Y si estuviera a un kilómetro, o a cien, de distancia? ¿Y si se hallase a un milímetro o a una micra de él?
Supóngase que se traza la superficie terrestre vista desde el espacio, a una distancia de un centenar de kilómetros. La línea sube y baja por los árboles, montes, edificios y —aparcado en algún sitio— un Volkswagen. A esa escala, la superficie no es sino un bulto entre muchos bultos, una pizca de acaso.
O supóngase que se examina el Volkswagen de manera cada vez más contigua, primero con una lupa y después con un microscopio. Al pronto, la superficie parecerá hacerse más lisa, porque la redondez de los parachoques y de la capota desaparecen de los ojos. Mas la superficie microscópica del acero presenta abultamientos caprichosos. Parece caótica.
Scholz comprobó que la geometría fractal suministraba un procedimiento eficacísimo para describir la redondez entrecortada de la superficie de la tierra; y los metalúrgicos pudieron certificar lo mismo en lo referente a la de diferentes clases de acero. La dimensión fractal de la superficie, por ejemplo, suele proporcionar información sobre la fuerza del metal. Y la de la terrestre, indicaciones sobre cualidades importantes. Scholz recordó una formación geológica clásica: un talud en la ladera de un monte. A cierta distancia es una figura euclídea de dos dimensiones. El geólogo, a medida que se aproxima a ella, nota que anda en el talud más que sobre el talud, pues se ha convertido en peñas del tamaño de automóviles. Su dimensión efectiva ha llegado a ser 2,7, puesto que las superficies rocosas se encorvan y rodean, y casi llenan el espacio tridimensional, como la de una esponja.
Las descripciones fractales encontraron aplicación inmediata en problemas relacionados con las propiedades de superficies que están en contacto. El que hay entre la superficie de rodadura de un neumático y el asfalto es uno de esos problemas. Y también las junturas de las máquinas o la conexión eléctrica. Los contactos de superficies tienen propiedades por completo independientes de los materiales que las componen. Hay cualidades que penden de la fractal de las protuberancias, y éstas de otras protuberancias, y así en adelante. Una consecuencia, sencilla, pero poderosa, de la geometría fractal de las superficies es que éstas, cuando se hallan en contacto, no se tocan en todas sus partes. La condición de la protuberancia a todas las escalas lo impide. Hasta en una roca sometida a presión colosal, resulta claro que, a escala pequeña, hay grietas, lo cual permite la circulación del fluido. Era, para Scholz, el efecto de «si te caes, no te levantas». Por ello, dos trozos de una taza rota jamás llegan a unirse, aunque parezcan encajar a gran escala. A una pequeña, los bultos irregulares no coinciden. Scholz pasó a ser conocido en su especialidad como una de las raras personas que aceptaba las técnicas fractales. Sabía que varios colegas suyos consideraban esperpentos a los componentes del grupito. Si escribía el vocablo fractal en el título de un artículo, sentía que le miraban como si siguiera admirablemente la moda, o como si estuviera —no tan admirablemente— chiflado. Incluso la redacción de artículos imponía decisiones difíciles: hacerlo para un público reducido de aficionados a los fractales, o para uno más nutrido de geofísicos, que necesitarían explicaciones de los conceptos básicos. Pese a ello, Scholz proclamó indispensables los útiles que le daba la nueva geometría.
—Es un modelo único. Nos permite hacer frente a las dimensiones mutables de la Tierra —explicó—. Proporciona instrumentos matemáticos y geométricos para describir y predecir. Una vez se salva la dificultad, y se comprende el paradigma, se consigue medir bien las cosas y pensar en ellas de manera nueva. Se ven de modo distinto. Se tiene una visión desconocida. No es, en absoluto, la antigua, sino mucho más vasta.
§. De las nubes a los vasos sanguíneos
¿Cuán grande es? ¿Cuánto dura? He aquí las preguntas más básicas que el científico formula. Tan fundamentales son para la concepción del mundo, que cuesta notar que suponen cierto prejuicio. Insinúan que el tamaño y la duración, cualidades dependientes de proporciones, tienen significado, puesto que contribuyen a representar un objeto o a clasificarlo. Cuando el biólogo describe un ser humano, o un físico un quark, resultan adecuadas. Los animales, en su estructura corpórea general, se hallan íntimamente ligados a esa escala particular. Concíbase un hombre cuyo tamaño se duplique, sin alterar ninguna de sus proporciones, y se habrá concebido una estructura cuyos huesos serán aplastados por el peso. La escala tiene importancia.
En cambio, la física del comportamiento de un terremoto es casi independiente de ella. Uno intenso no es sino la versión ampliada de uno débil. Eso distingue los terremotos de los animales, por ejemplo: de éstos uno de un palmo de longitud ha de estructurarse de manera muy diferente de uno de dos centímetros, y uno de dos metros necesita una arquitectura distinta, para que su osamenta no rompa bajo el peso del aumento de masa. Por otro lado, las nubes, como los seísmos, son fenómenos escalares. Su irregularidad peculiar —descriptible en términos de dimensión fractal— no se altera sea cual fuere la escala en que se la observe. A eso obedece que los pasajeros de los aviones pierdan toda perspectiva de la distancia a que se halla una nube. Si no hay algunos indicios, tales como la calina, una situada a seis metros de distancia llega a ser tan indistinguible como la que dista seiscientos. De hecho, el análisis de fotografías tomadas por un satélite artificial ha mostrado una dimensión fractal inmutable en nubes vistas a centenares de kilómetros.
Cuesta vencer el hábito de pensar en las cosas conforme al tamaño y la duración. La geometría fractal asegura que buscar la escala característica de algunos elementos naturales se convierte en confusión o perturbación. Huracán. Por definición, es una tempestad de cierta magnitud. Pero es la gente la que impone tal definición a la naturaleza. En realidad, los especialistas de la atmósfera empiezan a comprender que el tumulto aéreo forma un continuo, desde el remolino de polvo y suciedad en una esquina ciudadana hasta los vastos sistemas ciclónicos visibles desde el espacio. Las categorías desorientan. Los extremos del continuo constituyen un solo cuerpo con su parte media.
Las ecuaciones de la corriente de fluidos son adimensionales en muchos contextos, lo cual quiere decir que se aplican sin considerar la escala. Las maquetas reducidas de alas de avión y de hélices de barcos pueden ensayarse en túneles de pruebas y dársenas de laboratorio. Con algunas limitaciones, las tormentas débiles actúan como las recias.
Los vasos sanguíneos, de la aorta a los capilares, forman otra especie de continuo. Se ramifican y dividen, y vuelven a ramificarse, hasta hacerse tan angostos que las células de la sangre han de pasar en fila india. La índole de su ramificación es fractal. Su estructura se asemeja a uno de los monstruosos objetos imaginarios, tan caros a Mandelbrot, que concibieron los matemáticos en los primeros años de este siglo. Por obligación fisiológica, los vasos sanguíneos deben efectuar un poco de magia dimensional. Así como la curva de Koch, por ejemplo, apretuja una línea de longitud infinita en un espacio exiguo, así el sistema circulatorio tiene que comprimir una enorme superficie en un volumen limitado. Desde el punto de vista del cuerpo, la sangre es costosa y el espacio muy valioso. La estructura fractal natural cumple su cometido con tal eficacia, que, en la mayor parte de los tejidos, ninguna célula dista otras tres o cuatro células de un vaso sanguíneo. Sin embargo, éstos y la sangre ocupan escaso espacio, apenas más allá del cinco por ciento del cuerpo. Es, como lo pintó Mandelbrot, el «síndrome del Mercader de Venecia»: es no sólo imposible cortar una libra de carne sin derramar sangre, sino también un miligramo.
Esta estructura exquisita —dos árboles entrelazados de venas y arterias— anda muy lejos de ser excepcional. El cuerpo humano está lleno de ellas. El tracto digestivo posee un tejido con ondulaciones dentro de ondulaciones. Los pulmones necesitan incluir la mayor superficie posible en el espacio más reducido. La capacidad de un animal para absorber oxígeno es aproximadamente proporcional a la superficie pulmonar. Los pulmones humanos típicos comprimen un área más grande que una pista de tenis. A ello se agrega otra complicación: el laberinto de los conductos aéreos ha de enlazar correctamente con las arterias y venas.
Cualquier estudiante de medicina sabe que los pulmones están diseñados para acomodar una gran superficie. Pero los anatomistas han sido adiestrados de suerte que ven una sola escala por turno, como los millones de alvéolos, sacos microscópicos, en que acaban los bronquios. El léxico de la anatomía tiende a oscurecer la unidad existente a través de las escalas. El punto de vista fractal, al contrario, abarca toda la estructura, fijándose en la ramificación que la genera, ramificación que se comporta de manera consistente desde las escalas grandes a las mínimas. Los anatomistas estudian el sistema vascular, clasificando los vasos sanguíneos en categorías basadas en el tamaño: arterias y arteriolas, venas y vénulas, lo que, con determinados propósitos, tiene utilidad. Pero, en otros casos, desconcierta. En ocasiones, el tratamiento de los libros de texto parece una danza alrededor de la verdad: «A veces cuesta clasificar la región media en la transición gradual de un tipo de arteria a otro. Algunas de calibre intermedio poseen tabiques propios de las más grandes, y asimismo algunas arterias grandes ostentan tabiques como las de tamaño mediano. Las regiones de transición… se denominan a menudo arterias de tipo mixto».
No inmediatamente, sino una década después de que Mandelbrot hubiese publicado sus especulaciones fisiológicas, varios biólogos teóricos notaron que la organización fractal imponía estructuras en todo el cuerpo. La descripción «exponencial» clásica de la ramificación de los bronquios no era satisfactoria; la fractal, como se comprobó, encajaba con los datos. El sistema colector urinario resultó ser fractal. También el conducto biliar, en el hígado. Asimismo la red de fibras especiales que, en el corazón, transporta impulsos eléctricos a los músculos contráctiles. Esta última estructura, que los cardiólogos llaman red de His-Purkinje, inspiró un linaje de investigación de importancia particular. Mucha actividad en corazones sanos y anormales estribaba, según se reconoció, en los detalles de cómo coordinaban su ritmo las células musculares de las cámaras derecha e izquierda de bombeo. Varios cardiólogos que simpatizaban con el caos descubrieron que el espectro de frecuencia del ritmo cardíaco se ajustaba, como los terremotos y los fenómenos económicos, a leyes fractales, y aseguraron que una clave para comprenderlo era la organización fractal de la red de His-Purkinje, laberinto de caminos ramificados constituido de modo tal que era similar a sí mismo a escala cada vez más pequeña.
¿Cómo logró la naturaleza desarrollar una arquitectura tan complicada? Mandelbrot responde que sólo hay complicaciones dentro de la tradicional geometría de Euclides. Las estructuras ramificadas se describen como fractales con sencillez transparente, con nimios fragmentos de información. Tal vez las transformaciones simples que produjeron las figuras de Koch, Peano y Sierpinsky, tengan homólogos en las instrucciones codificadas de los genes. El ADN no puede ciertamente concretar la enorme cifra de bronquios, bronquiolos y alvéolos, o la peculiar estructura del árbol resultante; en cambio, puede especificar un proceso repetido de bifurcación y desarrollo. Esos procesos convienen a los fines de la naturaleza. E. I. Dupont de Nemours and Company y el ejército de los Estados Unidos fabricaron la imitación sintética de plumón de ganso, cuando entendieron que la fenomenal capacidad para retener el aire del producto natural se debía a los nudos y ramas de la proteína esencial de la pluma, es decir, la queratina. Como quien no hace nada, Mandelbrot se trasladó de los árboles pulmonar y vascular a los del reino de las plantas, los verdaderos, que apresan los rayos solares y resisten el viento con ramas y hojas fractales. Y los biólogos teóricos se pusieron a especular que, en morfogénesis, la disposición fractal de las escalas era no sólo corriente, sino universal. Afirmaron que era trascendental para la biología comprender cómo se codificaban y procesaban aquellas pautas.
§. Los cubos de basura de la ciencia
—Me puse a buscar esos fenómenos en los cubos de basura de la ciencia, porque sospeché que lo que yo observaba no era excepcional, sino, quizá, algo muy común. Asistí a conferencias y leí revistas poco distinguidas, casi siempre con fruto escaso o nulo; pero, de tarde en tarde, acertaba con cosas interesantes. En cierta manera, mi método era de naturalista, no de teórico. No obstante, gané en el juego. Tras haber consolidado en un libro la colección de ideas de toda una vida sobre la naturaleza y la historia matemática, Mandelbrot fue premiado con una medida inhabitual de éxito académico. Se convirtió en elemento indispensable del circuito de conferencias científicas, con su imprescindible equipo de diapositivas en color y sus mechones canosos. Obtuvo premios y galardones profesionales, y su nombre llegó a ser tan bien conocido de la gente corriente como el de cualquier otro matemático de talla. Se debió en parte al atractivo estético de sus fotografías e imágenes fractales; y, en parte, a que muchos millares de aficionados, dueños de microordenadores, podían explorar personalmente el mundo de Mandelbrot. También obedeció a que supo hacerse valer. Su nombre apareció en la corta lista que propuso I. Bernard Cohen, historiador de la ciencia en Harvard. Cohen había escudriñado durante años los anales científicos, en busca de especialistas que hubiesen declarado que su obra era una «revolución». Sólo halló dieciséis. Robert Symmer, escocés coetáneo de Benjamin Franklin, cuyas ideas sobre la electricidad fueron radicales, pero erróneas. Jean-Paul Marat, conocido hoy día exclusivamente por su sangrienta contribución a la Revolución francesa. Von Liebig. Hamilton. Charles Darwin, naturalmente. Virchow. Cantor. Einstein. Minkowski. Von Laue. Alfred Wegener (deriva de los continentes). Compton. Just. James Watson (estructura del ADN). Y Benoît Mandelbrot.
No obstante, éste seguía siendo para los matemáticos un intruso, que contendía tan encarnizadamente como siempre con la política de la ciencia. Hallándose en el cenit de la fama, algunos colegas le denigraron, pues creían que adolecía de una ilógica obsesión por ocupar un puesto en las páginas históricas. Le acusaron de haberlos atropellado para que reconocieran su mérito. Es indiscutible que en sus años de hereje profesional, había mendigado la aprobación de sus tácticas y de su tino científico. Hubo ocasiones en que, a la vista de artículos que utilizaban ideas de la geometría fractal, telefoneaba o escribía a los autores, quejándose de que no hicieran mención de él ni de su libro.
Sus admiradores perdonaban con facilidad la hinchazón de su ego, porque recordaban los obstáculos que había vencido para que su obra fuese reconocida.
—Ciertamente, es algo megalomaníaco, con un yo como una casa; pero lo que hace es hermoso y casi todo el mundo le excusa lo demás —dijo uno.
—Tuvo que vencer tantas dificultades con sus colegas matemáticos —explicó otro—, que, aunque fuese sólo para sobrevivir, hubo de recurrir a la estrategia de realzar su ego. Si no lo hubiera hecho, si no hubiera estado tan convencido de la certeza de sus visiones, jamás hubiera triunfado.
La actividad de dar y quitar mérito llega a transformarse en obsesión en la ciencia. Mandelbrot no se mostró parco en ella. Su libro resuena con la utilización del pronombre personal «yo»: Yo aseguro… Yo concebí y desarrollé… y llevé a cabo… Yo he confirmado… Yo pruebo… Yo he acuñado… En mis viajes por territorios ignorados o apenas colonizados, me sentí a menudo impulsado a ejercer el derecho de dar nombre a los accidentes del terreno. Este estilo disgustó a muchos científicos. No los aplacó el hecho de que Mandelbrot no escatimara las referencias a sus predecesores, algunos totalmente oscuros. (Y, además, notaron sus detractores, convenientemente difuntos). Pensaron que era su modo de intentar situarse de lleno en el centro, apareciendo como sumo pontífice que bendice en todas las direcciones. Y replicaron. No podían evitar la palabra fractal, pero si ansiaban eludir el apellido de Mandelbrot, les quedaba el recurso de referirse a lo fraccional como la dimensión de Hausdorff-Besicovitch. Les ofendía también —en especial a los matemáticos— cómo entraba y salía de distintas disciplinas expresando aseveraciones y conjeturas, y descargando en otros el peso de demostrarlas.
No andaban descaminados. Si un científico anuncia la verdad probable de algo, y otro la prueba con rigor, ¿cuál de los dos ha hecho más por el progreso científico? ¿Conjeturar es lo mismo que descubrir? ¿O es sólo una manera calculada de acotar un campo? Los matemáticos se han hallado siempre en tal situación, y el debate se encendió más aún cuando los ordenadores comenzaron a cumplir su nueva función. Quienes los usaban para ejecutar experimentos se convirtieron en científicos de laboratorio, pues emplearon reglas que permitían descubrir sin el habitual teorema probatorio, el teorema típico y bendecido de los artículos corrientes sobre matemáticas.
El libro de Mandelbrot abarcó muchas cosas y estuvo henchido de minucias de la historia de las ciencias exactas. Donde había caos, Mandelbrot tenía alguna justificación para pretender que era el primero en haberlo conocido. Nada importaba que muchísimos lectores pensaran que sus referencias pecaban de oscuras y hasta de inanes. Habían de reconocer su extraordinaria intuición de los progresos en campos que jamás había estudiado, desde la sismología a la fisiología. Era, ora prodigioso, ora irritante.
—Mandelbrot no tuvo los pensamientos de todos antes que ellos —exclamó con exasperación uno de sus admiradores.
Apenas importa. El rostro del genio no ha de tener siempre la expresión de santo de un Einstein. Con todo, Mandelbrot opina que hizo juegos de manos con su trabajo, durante decenios, para expresar sus ideas sin ofender a nadie. Tuvo que enmendar los prefacios, casi visionarios, de sus artículos para conseguir que los publicaran. Al escribir la primera versión de su libro, publicado en francés en 1975, se creyó forzado a simular que no contenía cosas muy sensacionales. Por eso redactó su última versión explícitamente como «manifiesto y registro de casos». Se amoldaba a la política de la ciencia.
—La política afectaba al estilo en un sentido del que luego llegué a arrepentirme. Decía yo: «Es natural… Es una observación interesante que…». Ahora bien, no era en absoluto natural, y la observación interesante equivalía, de hecho, al resultado de larguísimas investigaciones, así como a la búsqueda de pruebas y de autocrítica. Esta actitud filosófica y distante me pareció necesaria para que lo aceptasen. Según la política, se apagaría el interés del lector si yo decía que proponía un desvío radical. Más tarde, me arrepentí de algunas de aquellas declaraciones, porque la gente decía: «Es natural observar…». Yo no esperaba eso.
Volviendo la vista atrás, Mandelbrot advirtió que los especialistas en diferentes disciplinas reaccionaban a su planteamiento de las cosas de modos penosamente vaticinables. El primero fue siempre el mismo: ¿Quién es usted y por qué le atrae nuestra ciencia? Segundo: ¿Cómo se relaciona con lo que hemos estado haciendo y por qué no lo explica a partir de la base de lo que conocemos? Tercero: ¿Está usted seguro de que son matemáticas normales? (Sí, lo estoy). Entonces, ¿por qué no las conocemos? (Porque, a pesar de ser normales, resultan muy oscuras).
Las matemáticas se diferencian en esto de la física y otras ciencias aplicadas. Una rama de la física, en cuanto se vuelve anticuada o improductiva, propende a ser en adelante parte del pasado, una curiosidad histórica, o una fuente de inspiración para el científico moderno, pero está por lo general muerta y con buenas razones. Las matemáticas, en cambio, abundan en canales y caminos desviados, que, en una época, parecen no acabar en parte alguna, y, en otra, se transforman en terreno fértil en estudios importantes. Nunca se predice bien la aplicación potencial de un fragmento de pensamiento puro. He ahí por qué los matemáticos valoran los trabajos estéticamente, y buscan la elegancia y la belleza como los artistas. Y también, por esta razón, Mandelbrot encontró, como un arqueólogo, tantas teorías valiosas esperando que las desempolvasen.
Por consiguiente, el cuarto modo era éste: ¿Qué piensa de su trabajo la gente dedicada a estas ramas de las ciencias exactas? (Se despreocupan de él, porque no amplían las matemáticas. En realidad, se sorprenden de que sus ideas representen la naturaleza).
En fin, el vocablo fractal denotó un procedimiento de descripción, cálculo y pensamiento sobre las figuras irregulares y fragmentadas, dentadas y descoyuntadas, figuras que iban desde las líneas cristalinas de los copos de nieve al polvo discontinuo de las galaxias. Una curva fractal implica una estructura organizadora oculta en la detestable complicación de esas formas. Los estudiantes de segunda enseñanza podían comprender los fractales y jugar con ellos; eran tan primarios como los elementos de Euclides. Sencillos programas, que diseñaban imágenes fractales, circularon entre los aficionados propietarios de ordenadores.
La acogida más entusiástica fue la que dispensaron a Mandelbrot los profesionales de las ciencias aplicadas, que trabajaban en el petróleo, petrología y metales, sobre todo en entidades de investigación industrial. Así, verbigracia, amplios grupos de científicos de los grandes centros investigadores de la Exxon, a mediados del decenio de 1980, se atarearon en problemas fractales. Éstos, en la General Electric, se convirtieron en principio organizador del estudio de los polímeros y también —aunque en este caso a la chita callando— en cuestiones de seguridad de los reactores nucleares. Los fractales tuvieron en Hollywood su aplicación más singular con la creación de paisajes de enorme realismo, tanto terrestres como extraterrestres en los efectos especiales de las películas.
Las pautas que gente como Robert May y James Yorke habían descubierto a principios de la década anterior, con límites intrincados entre el comportamiento ordenado y el caótico, poseían regularidades insospechadas, sólo descriptibles si se atendía a la relación de las escalas amplias con las pequeñas. Se comprobó que eran fractales las estructuras que proporcionaron la clave de la dinámica no lineal. Y, en el terreno inmediato más práctico, la geometría fractal proporcionó instrumentos a físicos, químicos, sismólogos, metalúrgicos, teóricos de la probabilidad y fisiólogos. Estos investigadores estaban convencidos, y trataron de convencer a otros, de que la nueva geometría de Mandelbrot era la propia de la naturaleza.
Causaron impresión irrefutable en las matemáticas y la física ortodoxas, pero Mandelbrot nunca conquistó el respeto total de sus especialistas. Sin embargo, hubieron de reconocerle. Un matemático contó a sus amigos que se había despertado una noche estremecido por una pesadilla. En ella, estaba muerto y oía de pronto la voz inconfundible de Dios, que le decía:
— ¿Sabes? Ese Mandelbrot tenía ciertamente algo.
§. «Ver el mundo en un grano de arena»
La noción de auto semejanza pulsa cuerdas antiguas en nuestra cultura. La honra un viejo acorde del pensamiento occidental. Leibniz imaginó que una gota de agua contenía un universo pululante, el cual encerraba otras gotas de agua y nuevos universos. «Ver el mundo en un grano de arena», escribió Blake, y los científicos se mostraban a menudo dispuestos a verlo. Cuando se descubrió la esperma, se pensó que sus componentes eran homúnculos, seres humanos diminutos y completamente formados.
No obstante, la auto semejanza se marchitó, y con buen motivo, como principio científico. No concertaba con los hechos. Los espermatozoides no son sólo hombres a escala reducida —guardan mucho más interés por otras razones—, y el proceso de desarrollo ontogenético resulta mucho más interesante que la mera ampliación. La primitiva idea de la auto semejanza como causa organizativa se debía a las limitaciones de la experiencia humana de la escala. ¿Podía concebirse lo muy grande y lo muy pequeño, lo muy veloz y lo muy lento, de otra suerte que como extensiones de lo conocido?
El mito tuvo larga agonía cuando la visión del hombre creció con los telescopios y microscopios. Los primeros hallazgos demostraron que cada cambio de escala aportaba fenómenos desconocidos e ignorados géneros de comportamiento. La situación no ha terminado para los modernos físicos subatómicos. Cada acelerador más avanzado, con su aumento de energía y velocidad, dilata el campo de la ciencia con la visión de partículas menores y escalas temporales más fugaces, y cada expansión proporciona más información.
A primera vista, la idea de consistencia a escalas desconocidas parece suministrar menos informes. Ello se debe, en parte, a que ha habido en la ciencia una tendencia paralela al reduccionismo. Los científicos descomponen las cosas y examinan sus componentes uno tras otro, por turno. Y si desean reconocer la interacción de las partículas subatómicas, reúnen dos o tres. Con ello hay suficiente complicación. Sin embargo, la fuerza de la auto semejanza empieza a niveles mucho más grandes de complejidad. Es cuestión de mirar el conjunto.
Aunque Mandelbrot efectuó el uso geométrico más comprensivo de ellas, la reaparición de las ideas escalares en la ciencia, en las décadas de 1960 y 1970, fue una corriente intelectual cuyos efectos se sintieron en muchos lugares simultáneamente. La auto semejanza se hallaba implícita en la obra de Edward Lorenz. Fue elemento integrante de su comprensión intuitiva de la estructura fina de los diagramas obtenidos con su sistema de ecuaciones, estructura que presentía, pero no veía en los ordenadores de 1963. La utilización de las escalas fue también ingrediente del movimiento que condujo en la física, más directamente que la obra de Mandelbrot, a la disciplina del caos. Hasta en campos más alejados, los científicos comenzaron a pensar conforme a teorías que empleaban jerarquías de escalas, como en la biología evolutiva, en la que se hizo evidente que una teoría totalizadora habría de reconocer pautas de comportamiento en los genes, organismos individuales, especies y familias de especies, todo a la vez.
Paradójicamente, la apreciación de los fenómenos escalares tal vez debía provenir del mismo crecimiento de la visión humana que había acabado con las primitivas e ingenuas ideas sobre la auto semejanza. Muy avanzado el siglo XX, de maneras hasta entonces inconcebibles, las imágenes de lo incomprensiblemente pequeño y de lo inimaginablemente grande llegaron a ser parte de la experiencia de todos los hombres. Se contemplaron fotografías de galaxias y de átomos. Nadie tenía que fantasear, como Leibniz, cuál sería el universo a escala telescópica o microscópica, porque los telescopios y microscopios habían convertido esas imágenes en patrimonio del conocimiento cotidiano. Dado el anhelo de la mente de encontrar analogías en éste, fueron inevitables nuevas clases de comparación entre lo grande y lo pequeño, algunas de las cuales resultaron fecundas.
Los científicos atraídos por la geometría fractal encontraron a menudo paralelos emocionales entre su nueva estética matemática y los cambios de las artes en la segunda mitad del siglo presente. Sintieron que cosechaban entusiasmo interior de la cultura ambiental. Para Mandelbrot, el epítome de la sensibilidad euclídea, abstracción hecha de las matemáticas, era la arquitectura de la Bauhaus. Podía serlo también el estilo pictórico ejemplificado por los cuadrados de color de Josef Albers: sobrio, ordenado, lineal, reduccionista y geométrico. Geométrico: la palabra denota lo que ha significado durante milenios. Los edificios descritos como geométricos se componen de figuras simples, rectas y círculos, que pueden describirse con pocos números. La moda de esta especie de arquitectura y pintura iba y venía. Los arquitectos no sentían ya afición a proyectar rascacielos cuadrangulares como el Seagram neoyorquino, antaño tan ensalzado y copiado. La causa de ello es clara para Mandelbrot y sus secuaces. No sintonizan con el modo como se organiza la naturaleza o con la manera en que ve el mundo el ser humano. Como dice Gert Eilenberger, físico alemán que optó por la ciencia no lineal después de especializarse en la superconductividad:
— ¿Por qué se declara bello un árbol deshojado y enarcado por la tempestad contra el cielo invernal, y no la silueta correspondiente de un edificio universitario polivalente, a pesar de los esfuerzos ímprobos del arquitecto? Creo que la respuesta, algo especulativa, es que depende de las recientes concepciones de los sistemas dinámicos. Nuestra percepción de la belleza se inspira en la armoniosa disposición del orden y del desorden, tal como aparece en los objetos naturales: nubes, árboles, serranías o cristales de nieve. Las formas de todos ellos son procesos dinámicos vaciados en figuras físicas. Las tipifican combinaciones especiales de orden y desorden.
Una figura geométrica posee una escala, un tamaño característico. Según Mandelbrot, el arte satisfactorio carece de escala porque contiene elementos importantes de todos los tamaños. Al edificio Seagram opone la arquitectura del de las Beaux-Arts, sembrado de esculturas y gárgolas, piedras angulares y jambas pétreas, cartelas decoradas con espirales y volutas, y cornisas coronadas de canalones y tapizadas de dentellones. Un parangón, como la Ópera de París, no tiene escala porque posee todas las escalas. Quien contempla el edificio desde cierta distancia siente atraída su mirada por este o aquel detalle. La composición cambia a medida que uno se aproxima a él y entran en juego elementos de la estructura no apreciados hasta entonces.
Estimar la estructura armoniosa de cualquier obra arquitectónica es una cosa; y otra, muy diferente, admirar la selvatiquez de la naturaleza. La matemática reciente de la geometría fractal, en términos de valores estéticos, puso el tono de la ciencia de acuerdo con la inclinación, típicamente moderna, a lo natural indomeñado, libre de trabas e incivilizado. Hubo una edad en que las selvas tropicales, desiertos, regiones de matorrales y parameras representaron lo que la sociedad se esforzaba en someter. La gente contempló jardines cuando buscó el placer estético en la vegetación. Como John Fowles escribió en la Inglaterra del siglo XVIII: «Aquel período no simpatizó con la naturaleza indómita o primordial. Era barbarie agresiva, recordatorio feo y omni-abarcante de la Caída, del eterno destierro del hombre del jardín del Edén… Aun sus ciencias naturales… se mostraron sustancialmente hostiles a la naturaleza libre, y la miraron sólo como algo que debía ser sometido, clasificado, utilizado y explotado». En los años postreros del siglo XX, la cultura había cambiado y la ciencia se transformaba con ella.
Por lo tanto, el saber científico acabó por usar los primos oscuros y caprichosos del conjunto de Cantor y la curva de Koch. Al pronto, aquellas figuras pudieron haber servido como pruebas en el divorcio de las matemáticas y las ciencias físicas en los primeros años del siglo, el fin de un matrimonio que había sido el tema científico dominante desde Newton. Su originalidad había deleitado a matemáticos como Cantor y Koch. Creyeron ser más listos que la naturaleza, cuando, en realidad, no se habían puesto siquiera a la altura de sus creaciones. Asimismo, la prestigiosa corriente principal de la física se apartó del mundo de la experiencia diaria. Únicamente después, luego que Steve Smale devolvió los matemáticos a los sistemas dinámicos, pudo escribir un físico: «Tenemos que agradecer a los astrónomos y los cultivadores de las ciencias exactas que nos restituyeran, a los físicos, el campo de estudios en un estado más decoroso que aquel en que lo dejamos hace setenta años».
Mas, a pesar de Smale y a pesar de Mandelbrot, serían precisamente los físicos quienes transformarían el caos en ciencia. Mandelbrot proporcionó el léxico indispensable y un catálogo de sorprendentes imágenes naturales. Como él mismo reconoció, su programa describía mejor que explicaba. Hizo una lista de elementos de la naturaleza con sus dimensiones fractales —litorales, tramas de ríos, cortezas de árboles y galaxias—, y los científicos pudieron usar aquellos números para hacer predicciones. Pero los físicos anhelaron saber más. Quisieron conocer el porqué. Había formas en el mundo natural —formas no visibles, sino incrustadas en el tejido del movimiento— que esperaban ser reveladas.
Los torbellinos grandes tienen torbellinitos
que se nutren de su velocidad,
y los torbellinitos tienen torbellinos menores,
y así en adelante hasta la viscosidad.
LEWIS F. RICHARDSON
§. Un problema para Dios§. Un problema para Dios
§. Transiciones en el laboratorio
§. Cilindros rotantes y un punto decisivo
§. La idea de David Ruelle sobre la turbulencia
§. Curvas en el espacio de fases
§. Hojaldre y salchicha
§. El diagrama de un astrónomo
§. «Fuegos de artificio o galaxias»
La turbulencia era un problema linajudo. Todos los grandes físicos habían pensado en ella, formal o informalmente. Una corriente uniforme se rompe en espirales y remolinos. Pautas anómalas quebrantan la frontera de lo fluido con lo sólido. La energía se achica raudamente de los movimientos grandes a los pequeños. ¿Por qué? Las mejores ideas surgieron entre los matemáticos; para la mayor parte de los físicos, la turbulencia era demasiado espinosa para invertir tiempo en su estudio. Parecía casi imposible conocerla. Se cuenta sobre Werner Heisenberg, teórico de los cuanta, que, en el lecho de muerte, murmuró que preguntaría dos cosas a Dios: por qué la relatividad y por qué la turbulencia.
—Creo que tendrá una contestación para la primera pregunta —dijo.
La física teórica había llegado a una especie de armisticio con el fenómeno de la turbulencia. En efecto, había trazado una raya en el suelo y declarado: No podemos ir más allá. En el lado de acá de la línea, donde los fluidos se portan de manera ordenada, se podía trabajar mucho. Por suerte, un fluido que se mueve con regularidad no actúa como si poseyera un número casi infinito de moléculas independientes, cada una capaz de actividad libérrima. En lugar de ello, pizcas que están contiguas tienden a seguir juntas, como caballos uncidos al carro. Los ingenieros disponen de técnicas eficientes para calcular la corriente, con tal que no se encrespe. Utilizan una suma de conocimientos que se remonta al siglo XIX, cuando la comprensión de los movimientos de los líquidos y gases se situó en la vanguardia de la física.
En la época actual, ya no la ocupaba. Para los teóricos, la dinámica de los fluidos no encerraba misterios, salvo uno, inabordable incluso en el cielo. Lo práctico se entendía tan bien, que podía cederse a los técnicos. Los físicos decían que aquella dinámica no formaba ya parte de su ciencia. Era ingeniería corriente y moliente. Los peritos en dinámica de los fluidos solían hallarse en los departamentos universitarios, donde se enseñaba a los futuros ingenieros. Siempre ha ocupado el primer plano el interés práctico por la turbulencia y ese interés acostumbra ser unilateral: el de librarse de ella. Es deseable en algunas aplicaciones, como en el interior de un motor de retropropulsión, en el cual la combustión eficaz depende de la rapidez de la mezcla. En otros casos, la turbulencia equivale a desastre. La de una corriente aérea en un ala destruye el impulso de elevación. Un flujo turbulento origina en un oleoducto un estorbo asombroso. Enormes cantidades de dinero gubernamental y de las industrias se invierten en el diseño de aviones, turbomotores, hélices, cascos de submarinos y otras formas que se mueven a través de fluidos. Los investigadores se preocupan de la circulación en los vasos sanguíneos y válvulas cardíacas. Por la manifestación y la evolución de las explosiones. Por los vórtices y torbellinos, llamas y ondas de impacto. La bomba atómica de la segunda guerra mundial fue, en teoría, un problema de física nuclear. No obstante, éste había sido resuelto en su mayor parte antes de que se iniciara el proyecto, y lo que atosigó a los científicos reunidos en Los Álamos fue una cuestión de dinámica de los fluidos.
Entonces, ¿qué es la turbulencia? Un cúmulo de desorden a todas las escalas, torbellinos pequeños dentro de otros mayores. Inestable. Y sumamente disipativo, lo cual significa que consume energía y engendra trabas. Es movimiento metamorfoseado en azar. Pero ¿cómo pasa la corriente de uniforme a alborotada? Supóngase que uno tiene una cañería perfectamente lisa y un suministro de agua perfectamente regular y protegido de las vibraciones: ¿Cómo llega a crear semejante flujo algo fortuito?
Todas las reglas parecen fallar. Si la corriente es uniforme, o laminar, los pequeños trastornos se extinguen. Pero, declarada la turbulencia, las perturbaciones crecen de modo catastrófico. Esa declaración —esa transición— se elevó a misterio crucial en la ciencia. El canal que hay debajo de una roca, en un riachuelo, se transforma en remolino, que crece, se ramifica y da vueltas aguas abajo. El humo de cigarrillo se remonta suavemente desde el cenicero, se acelera hasta que sobrepasa una velocidad crítica y se divide en torbellinos desordenados. La irrupción de la turbulencia se percibe y puede medirse en los experimentos de laboratorio; puede estudiarse experimentalmente en el caso de alas o hélices en el túnel de pruebas. Pero su naturaleza continúa siendo elusiva. El conocimiento obtenido ha sido siempre particular, no universal. La investigación por tanteo del ala de un Boeing 707 no aporta nada a la investigación por tanteo del ala de un caza F-16. Hasta los superordenadores caen en la impotencia cuando se quiere estudiar el movimiento irregular de un fluido.
Algo agita a éste, lo excita. Es viscoso, pegajoso, y por ello pierde energía; y si se cesara de agitarlo, se posaría. Cuando se le mueve, se añade energía a baja frecuencia, o a gran longitud de onda, y lo primero que se observa es que las ondas largas se descomponen en cortas. Aparecen remolinos, que encierran otros más pequeños, y cada uno disipa la energía del fluido y produce un ritmo característico. En los años treinta, A. N. Kolmogorov propuso una descripción matemática que dio cierta idea de cómo actúan esos torbellinos. Imaginó la cascada de la energía total recorriendo escalas cada vez más reducidas, hasta que se llegaba a un límite en que los remolinos eran tan minúsculos, que se imponían los efectos, relativamente grandes, de la viscosidad.
En pro de la claridad de la descripción, Kolmogorov concibió que los torbellinos llenaban todos los espacios del fluido, haciendo que fuese igual en todas partes. Este supuesto, el de homogeneidad, es equivocado, y Poincaré lo supo cuarenta años antes, pues había visto, en la superficie agitada de un río, que los remolinos se mezclan siempre con parcelas de deslizamiento liso. La calidad de torbellino es limitada. La energía se disipa, en realidad, sólo en una porción del espacio. En cada escala, mientras se observa a fondo una turbulencia, surgen nuevas parcelas en calma. Por lo tanto, el supuesto de homogeneidad cede ante el de intermitencia. Cuando se la idealiza, la imagen intermitente adquiere un aspecto sumamente fractal, con lugares en que lo escabroso se confunde con lo suave, a escalas que van de lo grande a lo pequeño. También esta imagen se aparta algo de lo real.
Emparentada con ello, aunque fuese muy distinta, había la cuestión de qué sucede cuando se inicia la turbulencia. ¿Cómo salva una corriente la frontera que separa lo uniforme de lo turbulento? ¿Qué estados intermedios existen antes de que la turbulencia se imponga? Había sobre ello una teoría algo más consistente. Este paradigma ortodoxo se debió a Lev D. Landau, preclaro científico ruso cuya obra sobre la dinámica de los fluidos es aún fundamental. El cuadro que Landau traza es el de una acumulación de ritmos competidores. Cuando entra más energía en un sistema —conjeturó—, empiezan, una tras otra, nuevas frecuencias, incompatible cada una con la anterior, de la misma forma que una cuerda de violín responde a una mayor presión del arco, vibrando en un segundo tono disonante, y luego en un tercero y un cuarto, hasta que el sonido se trueca en cacofonía incomprensible.
Cualquier líquido o gas es un conjunto de pedazos individuales, tantos que muy bien pudieran ser infinitos. Si cada uno se moviera con independencia, el fluido tendría otras posibilidades infinitas, otros infinitos «grados de libertad», como se dice en la jerga especializada, y las ecuaciones que describen el movimiento habrían de tratar con otras variables infinitas. Pero cada partícula no se mueve con independencia: su movimiento depende del de sus vecinas, y en uno uniforme, los grados de libertad llegan a ser escasos. Los movimientos potencialmente complejos siguen acoplados. Los fragmentos continúan próximos o se apartan de modo lineal uniforme, que produce líneas concretas en las imágenes del túnel de pruebas. Las partículas de una columna de humo de cigarrillo se remontan, durante un rato, como si fuesen una sola.
Después, se manifiesta la confusión, una cohorte de movimientos desordenados y misteriosos. Algunos tienen nombres: oscilatorio, varicosis sesgada, transversal, nudo o zigzag. En opinión de Landau, estos movimientos inestables no hacen sino acumularse, uno encima de otro, y crean ritmos de velocidades y dimensiones traslapadas. Desde el punto de vista conceptual, esta idea ortodoxa de la turbulencia parecía convenir a los hechos, y era cuestión de mala suerte que la teoría resultara matemáticamente inútil, lo que, en efecto, ocurría. El paradigma de Landau permitía perder todo, salvo el honor.
El agua recorre una cañería, o gira en torno de un cilindro, emitiendo un siseo débil. Se aumenta la presión, mentalmente. Empieza un ritmo, atrás y adelante. Topa despacio, como una ola, contra la cañería. Ábrase de nuevo el grifo. Procedente de alguna parte, entra una segunda frecuencia, que no sincroniza con la primera. Los ritmos se mezclan, competen y chocan. Crean un movimiento tan complicado, en el que las ondas embisten las paredes, que apenas puede seguirse. Ábrase otra vez el grifo. Penetra una tercera frecuencia, una cuarta, una quinta, una sexta, todas inconmensurables. La corriente se hace extremadamente complicada. Quizá sea esto una turbulencia. Los físicos aceptaron este cuadro, pero ninguno tuvo noción de cómo predecir cuándo un incremento de energía produciría una frecuencia distinta, o cómo sería ésta. Nadie había visto tales frecuencias, que sobrevenían de manera arcana durante un experimento, porque nadie había comprobado la teoría de Landau sobre el inicio de la turbulencia.
§. Transiciones en el laboratorio
Los teóricos realizan los experimentos en sus cerebros. Los experimentadores utilizan, además, las manos. Aquéllos son pensadores y éstos artesanos. Aquéllos no necesitan cómplices. Éstos han de juntar estudiantes graduados, dar coba a maquinistas y halagar a los ayudantes de laboratorio. El teórico actúa en un lugar prístino, limpio de ruido, vibración y suciedad. El experimento desarrolla intimidad con la materia, como el escultor con la arcilla, batallando con ella, modelándola, estimulándola. El teórico inventa sus compañeros, como ingenuo Romeo que sueña su Julieta ideal. Los amores del experimentador son sudor, quejas y esperanza.
Se necesitan mutuamente, pero uno y otro han consentido que se infiltrasen ciertas desigualdades en sus relaciones, desde los antiguos tiempos en que eran uno solo. Si los mejores experimentadores conservan aún una mota de teórico en su constitución, no puede decirse lo mismo de los teóricos. En los últimos tiempos, el prestigio se acumula en el lado de éstos. La gloria les corresponde, sobre todo en la física de alta energía. Los experimentadores se han convertido en técnicos muy especializados, que regentan equipos costosos e intrincados. Durante los años transcurridos desde la segunda guerra mundial, en que la física se ha definido por el estudio de las partículas fundamentales, los experimentos que se publicaron de preferencia fueron los efectuados con aceleradores. Espín, simetría, color (propiedad de los quarks), flavor (designación de los tipos de quarks), etc., eran las abstracciones que fascinaban. Para la mayor parte de los profanos aficionados a la ciencia, y para bastantes científicos, el estudio de las partículas subatómicas era la física. Mas su exploración a escalas temporales brevísimas demandaba niveles más altos de energía. Así, pues, la maquinaria requerida para llevar a cabo buenos experimentos se complicó con el paso de los años, y la naturaleza de la experimentación cambió definitivamente en este campo. La especialidad estaba atestada porque los experimentos importantes estimulaban la formación de equipos de colaboradores. Los artículos de física subatómica solían destacar en la revista Physical Review Letters: una nómina típica de autores ocupaba una cuarta parte de la extensión del escrito.
Algunos experimentadores, sin embargo, preferían trabajar solos o en parejas. Lo hacían con cosas más accesibles. Si, por ejemplo, la hidrodinámica había perdido categoría, el estudio del estado sólido había prosperado tanto que su crecimiento justificó la utilización de un nombre más amplio: «física de la materia condensada», o de la materia pura y simple. La maquinaria utilizada era más sencilla. La distancia que separaba al teórico del experimentador, menos perceptible. El primero daba muestras de haber moderado su presunción, y el segundo se hallaba bastante libre de su anterior actitud defensiva.
Con todo eso, las perspectivas diferían. Era muy característico de un teórico interrumpir la conferencia de un experimentador con la pregunta: ¿No sería más convincente la expresión de los datos? ¿No le parece algo confusa esa gráfica? ¿No tendrían que extenderse esas cifras varios órdenes más de magnitud arriba y abajo de la escala?
Y, por otro lado, era muy propio de Harry Swinney erguirse cuan alto era —alrededor de ciento sesenta y cinco centímetros—, para exclamar «Es verdad», con una mezcolanza de innato encanto de Louisiana y de adquirida irascibilidad de Nueva York: «Es verdad, si se dispone de una infinidad de datos exentos de confusión»; y volverse hacia la pizarra con aire de quien despide a otra persona, agregando: «En realidad, sólo se dispone de una cantidad limitada de datos confusos».
Swinney experimentaba con la materia. Su momento decisivo había llegado cuando era estudiante graduado en la Johns Hopkins. La excitación que provocaba la física de las partículas se palpaba en el aire. El inspirador Murray Gell-Mann pronunció una conferencia y cautivó a Swinney. Pero, cuando curioseó qué hacían sus condiscípulos, vio que todos escribían programas de ordenador o soldaban cámaras de chispas. Entonces trató con un físico de más edad que él sobre el trabajo en las transiciones de fase: cambios de sólido a líquido, de no magnético a magnético, de conductor a superconductor. Poco después Swinney poseía una habitación, apenas más grande que una alacena, pero indiscutidamente suya. Catálogo en mano, se puso a encargar equipo. No tardó en contar con una mesa, un láser, unos aparatos de refrigeración y algunas sondas. Diseñó un artefacto para medir si el dióxido de carbono conducía bien el calor en el punto crítico en que se transformaba de vapor en líquido. Casi todo el mundo habría pensado que la conductividad térmica cambiaría levemente. Swinney descubrió que se alteraba en un factor de 1.000. Fue emocionante: solo, en una diminuta habitación, había dado con algo que nadie sabía. Vio la luz sobrenatural que despide un vapor, cualquiera, cerca del punto crítico, llamada «opalescencia» porque la suave dispersión de los rayos le proporciona el reflejo de un ópalo.
Como tantas otras cosas del caos, las transiciones de fase incluyen un comportamiento macroscópico, difícil de predecir con el estudio de los detalles microscópicos. Las moléculas de un sólido calentado vibran con la energía adicional. Fuerzan sus límites hacia el exterior y hacen que la sustancia se expanda. Cuanto más alto sea el calor, tanto más intensa será la expansión. Pero, a temperatura y presión determinadas, el cambio se vuelve repentino y discontinuo. Se ha tirado de una cuerda y se rompe. La forma cristalina se deshace y las moléculas se apartan unas de otras. Obedecen a leyes de los fluidos que hubieran sido imposibles de inferir de cualquier aspecto del sólido. El promedio de energía atómica casi no ha cambiado, pero la materia —ahora líquida, o un imán, o un superconductor— ha entrado en un reino nuevo.
Günter Ahlers, en los AT&T Bell Laboratories de Nueva Jersey, había examinado la llamada transmisión superfluida en el helio líquido, en el que, cuando la temperatura baja, el material se convierte en líquido mágico, que fluye sin viscosidad o fricción perceptible. Otros habían estudiado la superconductividad. Swinney había investigado el punto crítico en que la materia se cambia entre líquido y vapor. Swinney, Ahlers, Pierre Bergé, Jerry Gollub, Marzio Giglio… Mediado el decenio de 1970, estos experimentadores y otros, en los Estados Unidos, Francia e Italia, cautivados por la joven tradición de explorar las transiciones de fase, buscaban otros problemas. Tan bien como un cartero sabe con la experiencia las entradas y callejones de su demarcación, habían aprendido los postes indicadores de sustancias que cambiaban su estado fundamental. Habían estudiado un borde en que la materia se balanceaba.
La marcha de la investigación de la transición de fase había avanzado por las pasaderas de la analogía: una de no imán a imán resultaba ser como una de líquido a vapor. La transición de fase de fluido a superfluido venía a ser como una de conductor a superconductor. Las matemáticas de un experimento se aplicaban a muchos otros. El problema había sido solventado en buena parte en la década de 1970. Existía, empero, la cuestión de hasta dónde podía extenderse la teoría. ¿Cuáles otros cambios, examinados de cerca, evidenciarían que eran transiciones de fase?
No era la idea más original, ni la más evidente, aplicar las técnicas de las transiciones de fase al movimiento de los fluidos. Y no era la más original, porque los grandes precursores de la hidrodinámica, Reynolds, Rayleigh y sus seguidores, al principio del siglo XX, habían notado ya que el experimento cuidadosamente controlado con un fluido acarrea un cambio en la cualidad del movimiento: una bifurcación, en términos matemáticos. Los físicos sintieron la tentación de suponer que el carácter físico de la bifurcación se parecía a los cambios de una sustancia que cabían en el concepto de las transiciones de fase.
Y no era la clase más evidente de experimento, porque, a distinción de las auténticas transiciones de fase, las bifurcaciones no imponían modificación alguna en la sustancia del fluido. En vez de ello, sumaban un elemento nuevo: el movimiento. Un líquido quieto se convierte en líquido fluido. ¿Por qué habían de corresponder las matemáticas de este cambio a las de un vapor que se condensa?

El flujo entre cilindros giratorios.
El flujo característico del agua entre dos cilindros proporcionó a Harry Swinney y Jerry Gollub el medio de estudiar el origen de la turbulencia. La estructura se hace más compleja a medida que aumenta la velocidad de giro. De momento, el agua forma una pauta peculiar de flujo, que se parece a una acumulación de rosquillas. Después éstas comienzan a ondear. Los físicos utilizaron un láser para medir la velocidad cambiante del agua así que aparecía una nueva inestabilidad.
Swinney daba clases en 1973 en el City College de Nueva York. Jerry Gollub, graduado de Harvard, serio y de aspecto juvenil, hacía lo mismo en Haverford. Esta institución de enseñanza blandamente bucólica de las artes liberales, próxima a Filadelfia, no era el lugar más idóneo para un físico. No había estudiantes graduados que ayudasen en las operaciones de laboratorio, y que ocupasen la mitad inferior de la importantísima relación mutua del mentor y el protegido. Pero complacía a Gollub enseñar a discípulos de menos fuste e hizo del departamento de física de Haverford un centro famoso por la calidad de su trabajo experimental. En el año antes mencionado, obtuvo un semestre sabático y se fue a Nueva York a colaborar con Swinney.
Los dos hombres, recordando la analogía de las transiciones de fase con las inestabilidades de los fluidos, decidieron examinar un sistema clásico de líquido confinado entre dos cilindros verticales. Uno rotaba dentro del otro, revolviendo el líquido con él. El sistema confinaba su flujo entre superficies. Así se restringía el movimiento posible del líquido en el espacio, a diferencia de los chorros y estelas que se producen en el agua libre. Los cilindros giratorios creaban lo que se denomina corriente de Couette-Taylor. El interior voltea típicamente dentro de una pieza hueca estacionaria. La primera inestabilidad se presenta cuando la rotación se acelera: el líquido forma un diseño elegante, semejante a un rimero de tubos interiores de una gasolinera. Bandas en figura de rosquilla surgen alrededor del cilindro, una sobre otra. Una gota en el fluido gira no sólo de este a oeste, sino hacia arriba y adentro, y hacia abajo y afuera, en torno de las rosquillas. Aquello era ya cosa sabida y comprendida. G. I. Taylor lo había visto y medido en 1923. Para estudiar el flujo de Couette, Swinney y Gollub construyeron un aparato que cabía en la tabla de un escritorio, consistente en un cilindro externo de vidrio, del tamaño de un envase delgado de pelotas de tenis, de unos treinta centímetros de alto y unos cinco de diámetro, el cual daba cabida exacta a un cilindro interior de acero, con una parte hueca, de unos tres milímetros de ancho, para acoger el agua. —Tenía la apariencia de improvisación endeble —dijo Freeman Dyson, uno de los prominentes e inesperados visitantes de los meses siguientes—. Había que ver a aquellos dos caballeros en un laboratorio de bolsillo, casi sin un céntimo, llevando a cabo un experimento de indecible belleza. Fue el principio de una buena obra cuantitativa sobre la turbulencia.
Swinney y Gollub pensaban en una tarea científica decorosa que les aportase cierto reconocimiento por sus trabajos, aunque luego cayese en el olvido. Querían confirmar la idea de Landau sobre la irrupción de la turbulencia. No tenían motivos para dudar de ella. Sabían que los especialistas en dinámica de los fluidos la aceptaban. Les agradaba como físicos, pues encajaba con la imagen general de las transiciones de fase, y el propio Landau había proporcionado el marco más adecuado para estudiarlas, basado en su intuición de que aquellos fenómenos podían obedecer a leyes universales, con regularidades que superaban las diferencias en determinadas sustancias. Cuando estudió el punto crítico de líquido-vapor en el dióxido de carbono, Harry Swinney lo hizo con la convicción de Landau de que sus hallazgos le llevarían al punto crítico de líquido-vapor en el xenón, lo que, en efecto, sucedió. ¿No sería la turbulencia una acumulación de ritmos contrapuestos en un fluido en movimiento?
Gollub y Swinney se prepararon a desentrañar el enredo de los fluidos movientes con un arsenal de precisas técnicas experimentales, creadas durante años de estudio de las transiciones de fase en las circunstancias más delicadas. Contaban con métodos de laboratorio y equipo de medición que un especialista en dinámica de los fluidos jamás hubiera soñado. Usaron el láser para sondar las corrientes rodantes. Un rayo de luz cruzando el agua producía un desvío, o dispersión, mensurable con la técnica llamada interferometría doppler de láser. Y el raudal de datos se almacenó y procesó en un ordenador, aparato que se veía raras veces en 1975 en un experimento de laboratorio.
Landau había asegurado que aparecerían nuevas frecuencias, una tras otra, a medida que la corriente se acrecentara. Swinney recordó:
—Lo leímos y exclamamos, estupendo, echaremos una mirada a las transiciones de las que salen esas frecuencias. Las miramos y, vaya que sí, había una transición muy bien definida. Fuimos adelante y atrás por ella, aumentando y acortando la velocidad de rotación del cilindro. Todo estaba perfectamente definido.
Swinney y Gollub comenzaron a comunicar sus resultados y chocaron con un límite sociológico de la ciencia, el que separaba el dominio de la física del de la dinámica de los fluidos. Aquella barrera poseía vívidos rasgos característicos. En particular, establecía qué burocracia administraba su financiación dentro la National Science Foundation. En los años ochenta, el experimento de Couette-Taylor pertenece a la física; pero, en 1973, era patrimonio de la dinámica de los fluidos, y para quienes estaban acostumbrados a ella, los primeros números que salían del pequeño laboratorio del City College fueron demasiado —sospechosamente— nítidos. Los expertos no podían creer en ellos. No estaban habituados a experimentos ejecutados en el claro estilo de la física de transición de fase. Además, desde el punto de vista de la dinámica de los fluidos, costaba entender la intención teórica de aquél. La National Science Foundation respondió a Swinney y Gollub con una negativa en la siguiente ocasión en que intentaron obtener fondos. Unos ponentes no dieron crédito a los resultados y otros sentenciaron que no eran una novedad.
Pero el experimento no se detuvo.
—Allí teníamos la transición, bien definida —dijo Swinney—. Se trataba de algo grande. Después fuimos adelante en busca de otra.
Entonces se interrumpió la esperada secuencia de Landau. El experimento no confirmaba la teoría. En la transición siguiente la corriente saltó sin tregua a un estado confuso, carente de ciclos distinguibles. Nada de frecuencias, nada de formación gradual de complejidad.
—Fuese lo que fuere, lo que encontramos se hizo caótico.
Al cabo de pocos meses, un belga enjuto, dotado de intenso encanto, apareció en la puerta de su laboratorio.
§. La idea de David Ruelle sobre la turbulencia
David Ruelle decía que había dos clases de físicos: una que creció desmontando aparatos de radio —aquello sucedía en la era anterior al estado sólido, cuando se contemplaban cables y tubos de vacío que resplandecían con color anaranjado, y se imaginaba cualquier cosa sobre la circulación de los electrones—, y otra que jugaba con equipos químicos. Ruelle jugó con ellos, o con ninguno, en el posterior sentido estadounidense. Fueron sustancias químicas, explosivas o venenosas, que vendían sin reparos, en el septentrión de Bélgica donde había nacido, los farmacéuticos locales. El mismo Ruelle las mezclaba, removía, calentaba, cristalizaba y, a veces, hacía estallar. Había venido al mundo en 1935, en Gante, hijo de un maestro de gimnasia y de una profesora universitaria de lingüística, y aunque pensó en consagrarse al reino de la ciencia abstracta, siempre sintió debilidad por las sorpresas que oculta la naturaleza en las setas venenosas, o en la combinación del salitre con azufre y carbón.
No obstante, aportó una perdurable contribución a la exploración del caos con la física matemática. Ingresó en 1970 en el Institute des Hautes Études Scientifiques (Instituto de Altos Estudios Científicos), situado en las afueras de París e inspirado en el Institute for Advanced Study de Princeton. Ya había iniciado lo que se transformaría en hábito constante en su existencia: abandonar el instituto y su familia periódicamente para emprender excursiones solitarias, que llegaban a durar semanas, con una simple mochila, por los espacios desiertos de Islandia o México. A menudo no encontraba a nadie. Cuando hallaba seres humanos y aceptaba su hospitalidad —tal vez un yantar de tortillas de maíz, sin grasa animal o vegetal—, pensaba que contemplaba el mundo tal como había sido hacía dos milenios. De vuelta al instituto, reemprendía la vida científica, con el rostro más flaco y la piel más ceñida a su frente redonda y su agudo mentón. Había asistido a conferencias de Steve Smale sobre la herradura y las posibilidades caóticas de los sistemas dinámicos. Había reflexionado sobre la turbulencia de los fluidos y la imagen clásica de Landau. Sospechó que aquellas ideas estaban emparentadas… y que eran contradictorias.
Ruelle no poseía experiencia de las corrientes fluidas, pero aquello no le desanimó, como no había desanimado a sus muchos predecesores desafortunados.
—La gente no especializada siempre descubre las novedades —dijo—. No hay una sólida teoría natural de la turbulencia. Todas las preguntas que pueden hacerse sobre ella son de índole más general, y, por consiguiente, accesibles a los que no son expertos.
Se comprendía sin esfuerzo por qué la turbulencia se resistía a ser analizada. Las ecuaciones de la corriente de los fluidos son diferenciales parcialmente no lineales, insolubles excepto en casos especiales. A pesar de ello, Ruelle ingenió una alternativa abstracta de la imagen de Landau, expuesta en el léxico de Smale, con representaciones del espacio parecidas a una materia moldeable, que podía ser apretada, estirada y plegada en figuras tales como las herraduras. Escribió en el instituto un artículo en colaboración con Floris Takens, matemático holandés visitante, y lo publicaron en 1971. Su expresión fue inconfundiblemente matemática —¡mucho ojo, físicos!—, o sea, encabezaron los párrafos con vocablos tales como definición, proposición o prueba, a los que seguía la inevitable arremetida: Sea…
«Proposición (5.2). Sea X μ una familia de un parámetro de Ck campos vectoriales en un espacio H de Hilbert tal que…».
En cambio, el título prometía relación con el mundo real: «On the Nature of Turbulence» (Sobre la naturaleza de la turbulencia), eco deliberado del célebre de Landau, «On the Problem of Turbulence». La clara finalidad de la argumentación de Ruelle y Takens iba más allá de las matemáticas; se proponían ofrecer un sustituto del criterio tradicional sobre el arranque de la turbulencia. En lugar de amontonar frecuencias, lo que llevaba a una infinidad de movimientos traslapados independientes, declararon que tres movimientos independientes bastaban para generar la complejidad total de la turbulencia. Desde el punto de vista de las ciencias exactas, parte de su lógica resultó ser oscura, equivocada o tomada en préstamo, o todo al mismo tiempo. Las opiniones al respecto variaban todavía quince años más tarde.
Pero la intuición, el comentario, las cosas marginales y la física entretejidos en el artículo la convirtieron en don inagotable. Lo más seductor fue lo que los autores denominaron atractor extraño. Ruelle meditó después que tal denominación era psicoanalíticamente «sugestiva». Su importancia en el estudio del caos fue tal que él y Takens se disputaron, con apariencia cortés, el honor de haber inventado el nombre. Era la verdad que ninguno de ambos lo recordaba bien.
Takens, alto, rubicundo y fieramente nórdico, decía:
— ¿Acaso se pregunta a Dios si ha creado este maldito universo?… No recuerdo nada… Creo a menudo sin acordarme de ello.
Ruelle, el autor más calificado del artículo, comentaba sin alterarse:
—Takens visitaba el Institut des Hautes Études Scientifiques. Cada persona trabaja a su modo. Algunas prefieren escribir los artículos sin colaboradores, para que el mérito sea sólo de ellas.
El atractor extraño vive en el espacio de fases, una de las invenciones más vigorosas de la ciencia moderna. Dicho espacio proporciona el modo de convertir los números en imágenes, abstrayendo cada miga de información esencial de un sistema de partes móviles, mecánicas o fluidas, y trazando un diagrama flexible de caminos que conducen a todas sus posibilidades. Los físicos trabajaban ya con dos clases simples de «atractores»: puntos fijos y ciclos límites, que representaban el comportamiento a que llegaba un estado estable, o que se repetía continuamente. En el espacio de fases, el conocimiento completo de un sistema dinámico, en un instante temporal único, se transforma en un punto. Éste es el sistema dinámico…, en aquel instante. Pero, en el siguiente, el sistema habrá cambiado, aunque sea muy poco. Por lo tanto, el punto se mueve. La historia del sistema temporal puede registrarse con el punto móvil, que describe su órbita a través del espacio de fases en el transcurso del tiempo.
¿Cómo se almacena en un punto toda la información sobre un sistema complejo? La respuesta es simple, si tiene sólo dos variables. Se deriva de la geometría cartesiana que se explica en la segunda enseñanza: una variable en el eje horizontal y otra en el vertical. Si es un péndulo, que oscila sin fricción, una variable será la posición y otra la velocidad; las dos cambian continuamente, creando una línea de puntos que traza una curva más o menos cerrada, la cual se repite una y otra vez, siempre. El mismo sistema, con mayor índice de energía —a saber, oscilando más de prisa y más lejos—, forma en el espacio de fases una curva similar a la descrita, aunque más amplia.
Algo de realismo, con el aspecto de fricción, cambia la imagen. No se necesitan las ecuaciones del movimiento para comprender la suerte de un péndulo expuesto a fricción. Cada órbita acabará, al fin, en el mismo sitio, en el centro: posición 0, velocidad 0. Ese punto fijo central «atrae» las órbitas. En vez de formar curvas para siempre, describe una espiral hacia el interior. La fricción disipa la energía del sistema, y la disipación se revela en el espacio de fases como un impulso hacia el centro, desde las regiones externas de alta energía a las internas de baja energía. El atractor —del género más sencillo posible— es como un imán del tamaño de una cabeza de alfiler metido en una lámina de goma.

Otra manera de ver el péndulo.
Un punto en el espacio de fases (derecha) contiene toda la información sobre el estado de un sistema dinámico en cualquier instante (izquierda). En un péndulo sencillo, dos números —velocidad y posición— es cuanto se requiere saber.

El punto traza una trayectoria, la cual proporciona una manera de visualizar el comportamiento continuo, a largo plazo, de un sistema dinámico. Un arco reiterado representa un sistema que se repite para siempre a intervalos regulares. Si el comportamiento repetido es estable, como en el péndulo de un reloj de pared, el sistema regresa a su órbita tras pequeñas perturbaciones. En el espacio de fases, la órbita arrastra las trayectorias que pasan cerca de ella: es un atractor.

Un solo punto puede ser un atractor. En un péndulo que pierde constantemente energía a causa de la fricción, todas las trayectorias decrecen en espiral hacia un punto interior, que representa el estado estable, en este caso, el de la inmovilidad absoluta.
Incluso las imágenes bidimensionales de espacios de fases reservaban muchas sorpresas, y hasta los ordenadores de mesa podían demostrar algunas de ellas, mudando las ecuaciones en trayectorias móviles llenas de color. Algunos físicos rodaron películas y cintas de vídeo para mostrarlas a sus colegas, y algunos matemáticos de California publicaron libros con diseños verdes, azules y rojos por el estilo de los dibujos animados, que ciertos de sus cofrades definieron, con un toque de malicia, como «historietas del caos». Las dos dimensiones no satisficieron las exigencias de los sistemas que los físicos necesitaban estudiar. Requerían más de dos variables, y eso demandaba más dimensiones. Cada porción de un sistema dinámico capaz de moverse con independencia es otra variable, otro grado de libertad. Y cada uno de éstos exige otra dimensión en el espacio de fases, con el fin de asegurarse de que un solo punto contiene información suficiente para determinar de modo único el estado del sistema. Las ecuaciones sencillas que estudió Robert May eran unidimensionales: se contentaban con un solo número, que podía representar la temperatura o la población, y ese número definía la posición de un punto en una línea, unidimensional por su naturaleza. El sistema simplificado de Lorenz de la convección de los fluidos tenía tres dimensiones, no porque el fluido se moviera por ellas, sino porque se necesitaron tres números diferentes para precisar el estado del fluido en un instante dado.
Los espacios de cuatro, cinco o más dimensiones abruman la imaginación visual de los topólogos más dotados. Pero los sistemas complejos tienen muchas variables independientes. Los matemáticos habían de aceptar el hecho de que los sistemas con infinitos grados de libertad —la naturaleza indomeñada que se expresa en la cascada turbulenta o en el cerebro impredecible— requerían un espacio de fases de dimensiones infinitas. Pero ¿quién podía manejar aquello? Era una hidra, despiadada e ingobernable, y se trataba de la imagen de Landau de la turbulencia: modos infinitos, infinitos grados de libertad, dimensiones infinitas.
§. Curvas en el espacio de fases
El físico tenía buenas razones para que le desagradase un modelo que ostentaba tan poca claridad natural. Los superordenadores más rápidos del mundo, que empleaban las ecuaciones no lineales del movimiento de los fluidos, eran impotentes cuando habían de rastrear durante escasos segundos un flujo alborotado, incluso de un centímetro cúbico. La culpa correspondía más a la naturaleza que a Landau, pero incluso así la imagen de éste iba a contrapelo. Sin conocimiento alguno, el físico tenía derecho a sospechar que algún principio se resistía a ser descubierto. Richard P. Feynman, el gran teórico cuántico, manifestó tal sensación: «Siempre me preocupa que, según las leyes tal como las entendemos hoy día, una máquina calculadora haya de efectuar un número infinito de operaciones lógicas, para resolver qué sucede en cualquier minúscula región del espacio, y en no importa cuál minúscula región del tiempo. ¿Cómo ocurre eso en ese diminuto espacio? ¿Por qué se requiere infinita cantidad de lógica para dilucidar lo que hará un fragmento exiguo de espacio-tiempo?».
Como tantos otros que se pusieron a estudiar el caos, Davis Ruelle conjeturó que las formas visibles de una corriente confusa —líneas entremezcladas de dirección, torbellinos espirales, giros retorcidos, que se asoman fugazmente y desaparecen— debían de reflejar pautas que justificaban leyes aún no descubiertas. Pensó que la disipación de la energía en tal caso tenía que llevar a una especie de contracción del espacio de fases, a un tirón hacia un atractor. Éste, desde luego, no sería un punto fijo, porque el flujo jamás se tranquilizaría. La energía tanto entraba en el sistema como salía de él. ¿Qué otro género de atractor podía ser? Conforme al dogma, no existía sino otro género, un atractor periódico, o ciclo límite: una órbita que atraía todas las cercanas. Si un péndulo recibe energía de un resorte y la pierde a consecuencia de la fricción —es decir, si es a la vez impulsado y retenido—, una órbita estable puede ser, en el espacio de fases, la curva cerrada que representa el movimiento oscilatorio regular de un reloj de pared. Dondequiera que se ponga en movimiento, el péndulo adoptará esa órbita. ¿De veras? En el caso de ciertas condiciones iniciales —las que poseen la energía más baja—, acaba por detenerse, de suerte que el sistema se compone de dos atractores, uno de ellos una curva cerrada y otro un punto fijo. Cada atractor tiene «cuenca» propia, lo mismo que dos ríos próximos poseen territorios propios de recogida de aguas.
A corto plazo, cualquier punto del espacio de fases puede salir fiador del comportamiento de un sistema dinámico. A plazo largo, los únicos comportamientos posibles son los atractores. Las otras clases de movimiento resultan transitorias. Los atractores tienen por definición la importante propiedad de ser estables: en un sistema real, en que las partes móviles están sujetas a los choques y resonancias del mundo real, el movimiento propende a regresar al atractor. Un choque llega a desviar la trayectoria por breve tiempo, pero los movimientos transitorios resultantes se extinguen. Aunque el gato le propine un zarpazo, el péndulo de un reloj de pared nunca marca un minuto de sesenta y dos segundos. La turbulencia en un fluido era comportamiento de orden distinto, pues jamás producía un ritmo determinado con exclusión de los demás. Una de sus características harto conocida era que se presentaba, al mismo tiempo, el amplio espectro total de los ciclos posibles. La turbulencia es como los ruidos parásitos que crepitan en el aparato de radio. ¿Podía aquello surgir de un sistema sencillo y determinista de ecuaciones?
Ruelle y Takens se preguntaron si alguna otra clase de atractor no tendría el conjunto de propiedades adecuadas. Estable, representativo del estado final de un sistema dinámico en un mundo alborotado. De pocas dimensiones, esto es, una órbita en un espacio de fases que fuese un rectángulo o una caja, con escasos grados de libertad. No periódico, sin jamás repetirse y sin jamás incurrir en el ritmo constante de un reloj de pared. Desde el punto de vista geométrico, el problema frisaba en rompecabezas: Qué órbita podía trazarse en un espacio limitado, de manera que nunca se repitiese y nunca se cruzase a sí misma, pues, en cuanto vuelve a un estado anterior, un sistema debe seguir idéntico camino en adelante. Para producir todos y cada uno de los ritmos, la órbita tendría que ser una línea infinitamente larga en un área finita. En resolución —la palabra no se había inventado todavía—, habría de ser fractal. El razonamiento matemático hizo que Ruelle y Takens afirmasen que aquello tenía que existir. Jamás lo habían visto, y no lo diseñaron. Pero la afirmación era bastante. Más tarde, al pronunciar una conferencia en el Congreso Internacional de Matemáticas de Varsovia, Ruelle declaró, con la cómoda suficiencia con que se juzga lo pasado:
—La reacción del estamento científico a nuestras proposiciones fue glacial. Sobre todo la noción de que el espectro continuo se asociaría con pocos grados de libertad, fue considerada herética por muchos físicos.
Pero éstos —un puñado, desde luego— reconocieron la trascendencia del artículo de 1971 y trabajaron en sus inferencias.
§. Hojaldre y salchicha
En realidad, la bibliografía científica contenía, en 1971, un pequeño dibujo de la inimaginable bestia que Ruelle y Takens intentaban vivificar. Edward Lorenz había adjuntado a su artículo de 1963 sobre el caos la representación de dos curvas a la derecha, y una dentro de otra, y cinco a la izquierda. La obtención de las siete había necesitado de quinientos cálculos continuos en el ordenador. Un punto, que se movía según aquella trayectoria en el espacio de fases, alrededor de las curvas, ilustraba la lenta rotación caótica de un fluido, tal como lo simulaban las tres ecuaciones de Lorenz referentes a la convección. Como el sistema contaba con tres variables independientes, aquel atractor se hallaba en un espacio tridimensional de fases. Aunque sólo había dibujado un fragmento de él, Lorenz vio más de lo que había dibujado: una especie de espiral doble, como las alas de una mariposa entretejidas con destreza infinita. Cuando el calor creciente de su sistema impelía el fluido en una dirección, la trayectoria permanecía en el ala derecha; cuando el movimiento de rotación se paraba y cambiaba de sentido, la trayectoria se trasladaba a la otra ala.
El atractor era estable, de pocas dimensiones y no periódico. Nunca se cortaba a sí mismo, porque, si lo hacía, volviendo a un sitio en que ya había estado, el movimiento se hubiera repetido en adelante en una curva periódica. Aquello nunca ocurrió; era lo singular, lo precioso, del atractor. Sus lazos y espirales eran infinitamente hondos; jamás se juntaban y jamás se intersecaban. Sin embargo, permanecían dentro de un espacio finito, confinados en una casilla. ¿Cómo acontecía aquello? ¿Cómo cabían en un espacio finito innumerables, infinitas, trayectorias?

El primer atractor extraño.
En 1963, Edward Lorenz logró computar sólo unos pocos ramales iniciales del atractor, en su sistema sencillo de ecuaciones. No obstante, comprendió que el entrelazamiento de las dos alas espirales debía de tener una estructura extraordinaria a escalas invisibles.
El esfuerzo de aprovechar las indicaciones de Ruelle y Takens se orientó en dos sentidos. Uno fue la lucha teórica por visualizar los atractores extraños. ¿Era típico el de Lorenz? ¿Qué clases distintas de figuras serían posibles? Otro consistió en el trabajo experimental destinado a confirmar o refutar el acto de fe, acusadamente anti matemático, que reclamaba la aplicabilidad de los atractores extraños al caos en la naturaleza.
En Japón, el estudio de los circuitos eléctricos que imitaban el comportamiento de los resortes mecánicos —aunque con velocidad muy superior—, hizo que Yoshisuke Ueda descubriese un conjunto bellísimo de extraños atractores. (Conoció la versión oriental de la frialdad que había acogido a Ruelle: «Su resultado no pasa de ser una oscilación casi periódica. No se forme un concepto ególatra de los estados estables»). En Alemania Otto Rössler, médico no practicante que llegó al caos por el camino de la química y la biología teórica, vio con rara habilidad los atractores extraños como objetos filosóficos, y dejó las matemáticas en segundo término. El nombre de Rössler quedó unido a un atractor notablemente sencillo, de figura de cinta, con un doblez, y muy estudiado porque no costaba dibujarlo; pero también visualizó otros de más dimensiones.
—Una salchicha dentro de una salchicha dentro de una salchicha —solía decir—. Sáquela, pliéguela, oprímala y colóquela de nuevo.
En verdad, doblar y apretar el espacio era el secreto de construir atractores extraños, y tal vez el de la dinámica de los sistemas reales que los originaban. Rössler sentía que aquellas formas encarnaban en el mundo un principio auto organizador. Imaginaba algo semejante a una manga de viento en un aeródromo, «una funda abierta con un agujero en el extremo, en la cual el viento se interna», dijo. «Y queda atrapado. La energía hace algo productivo contra su voluntad, como el diablo en una conseja medieval. El principio es que la naturaleza efectúa algo contra su propio querer y, por enmarañarse en sí misma, crea belleza».
Concretar las imágenes de atractores extraños no era asunto trivial. Las órbitas abrían, de manera típica, vericuetos cada vez más complicados en tres o más dimensiones, originando en el espacio un garabato confuso cuya estructura interna no se percibía desde el exterior. Los científicos emplearon ante todo, para convertir aquellas madejas tridimensionales en figuras planas, la técnica de la proyección, en la que un dibujo representaba la sombra que el atractor arrojaba sobre una superficie. Pero, en el caso de los complejos, la proyección no hacía sino emborronar el detalle en un revoltijo indescifrable. Una técnica más reveladora consistía en el mapa de restitución o mapa de Poincaré, el cual se lograba cortando una rebanada del laberíntico corazón del atractor para sacar de él una porción bidimensional, como el patólogo que prepara un corte muy fino de tejido para un portaobjetos utilizable en el microscopio.
El mapa de Poincaré retira una dimensión del atractor y vuelve una línea continua en una colección de puntos. En cuanto obtiene tal mapa, el científico supone que ha conservado buena parte del movimiento esencial. Puede imaginar, por ejemplo, que un atractor extraño se ajetrea delante de sus ojos, con órbitas que suben y bajan, van de derecha a izquierda y viceversa, y recorren sin dirección fija la pantalla de su ordenador. La órbita deja un punto resplandeciente en el lugar de la intersección, y los puntos constituyen un borrón al azar o insinúan una forma en el fósforo.
El procedimiento comprueba el estado de un sistema a retazos, no de modo continuo. Cuándo ha de ejecutarse la comprobación —dónde se debe sajar la rebanada del atractor extraño— es cuestión que concede cierta flexibilidad al investigador. El intervalo más informativo tal vez corresponda a algún rasgo físico del sistema dinámico. Por ejemplo, un mapa de Poincaré sacaba una muestra de la velocidad de la pesa del péndulo en cada ocasión que recorría su punto más bajo. O el investigador escogía algún intervalo temporal regular frenando los sucesivos estados con un estroboscopio ideal. Con este o con aquel método, tales imágenes acabaron por revelar la fina estructura fractal que Edward Lorenz había barruntado.
§. El diagrama de un astrónomo
El más revelador de los atractores extraños, por ser el más simple, se debió a alguien muy distante de los misterios de la turbulencia y de la dinámica de los fluidos. Era el astrónomo Michel Hénon, del Observatorio de Niza, en la costa sudoriental de Francia. En cierto sentido, la astronomía puso en acción los sistemas dinámicos: los movimientos cronométricos de los planetas proporcionaron el triunfo a Newton e inspiraron a Laplace. Pero la mecánica celeste se diferencia de la inmensa mayoría de los sistemas terrestres en algo fundamental. Los que pierden energía con la fricción son disipativos. Y eso no sucede con los astronómicos: son conservativos o hamiltonianos. En el fondo, a escala casi infinitesimal, incluso los astronómicos experimentan un entorpecimiento o traba, porque las estrellas irradian energía y la fricción periódica resta algo de velocidad a los cuerpos que se desplazan a lo largo de sus órbitas; pero los astrónomos ignoran la disipación con fines prácticos. Y, sin ella, el espacio de fases no pliega ni contrae como se necesita para que haya estratificación fractal infinita. Jamás comparecería un atractor extraño. ¿Y el caos?

Exposición de la estructura de un atractor.
El atractor extraño aquí representado —una órbita, diez y cien— muestra el comportamiento caótico de un rotor, o sea, un péndulo que oscila en círculo pleno, impulsado a intervalos regulares por una descarga energética. Cuando se han trazado mil órbitas (abajo), el atractor se ha convertido en una madeja de maraña impenetrable. Para ver el interior de la estructura, un computador corta una tajada del atractor, denominada sección de Poincaré. Esta técnica reduce la imagen tridimensional a dos dimensiones. Cada vez que pasa por un plano, la trayectoria marca un punto. Así surge poco a poco una pauta muy detallada. La presente muestra tiene más de ocho mil puntos, cada uno de los cuales representa una órbita alrededor del atractor. En efecto, el sistema es «catado» a intervalos regulares. Se pierde una clase de información, pero se hace resaltar otra.
En lo dinámico, un cúmulo globular es un enorme problema, porque en él intervienen muchos cuerpos. Una incógnita de dos se solventa con facilidad, y Newton lo hizo de modo total y satisfactorio. Cada cuerpo —la Tierra y la Luna, por ejemplo— se desplazan en una elipse perfecta alrededor del común centro de gravedad del sistema. Pero si se agrega otro objeto gravitante, la situación cambia como por ensalmo. El problema de los tres cuerpos es arduo, e incluso peor que eso: a menudo casi irresoluble, como descubrió Poincaré. Las órbitas pueden calcularse numéricamente durante un ratito, y, con la ayuda de ordenadores poderosos, seguirse durante bastante tiempo, antes de que las incertidumbres se impongan. Pero, como las ecuaciones no pueden resolverse analíticamente, no hay modo de responder a las cuestiones, a largo plazo, sobre un sistema de tres cuerpos. ¿Es estable el solar? Parece serlo a plazo corto; incluso hoy nadie sabe con seguridad si algunas órbitas planetarias no se harán cada vez más excéntricas, hasta que los planetas abandonen el sistema para siempre.
El cúmulo globular es un sistema demasiado complicado para tratarlo como un problema de muchos cuerpos; en cambio, es posible estudiar su dinámica con la ayuda de algunos supuestos. Parece razonable pensar, verbigracia, que cada estrella recorre un campo gravitatorio promedio con un centro particular de gravedad. No obstante, con la frecuencia que fuere, dos estrellas se acercarán una a otra lo suficiente para que su interacción haya de tratarse por separado. Y los astrónomos comprendieron que los cúmulos globulares no han de ser, generalmente, estables. Tienden a formarse en su interior sistemas de estrellas binarias, que se emparejan en órbitas estrechas, y cuando una tercera las encuentre, cualquiera de las tres se expone a recibir una fuerte patada. De tarde en tarde, una obtendrá bastante energía de la interacción para alcanzar la velocidad de escape y separarse del cúmulo para siempre; entonces, el cúmulo se contraerá levemente. Al enfrentarse con este problema en su tesis doctoral en 1960, en París, Hénon partió de un supuesto más bien arbitrario: que, cuando cambiaba de escala, el cúmulo continuaba siendo similar a sí mismo. Sus cálculos acabaron un resultado asombroso. El núcleo del cúmulo se abatiría, adquiriendo energía cinética y tendiendo a un estado de densidad infinita. Apenas era concebible tal cosa, que, encima, no recibía soporte en los cúmulos observados hasta entonces. Pero, bien que despacio, la teoría de Hénon, que luego recibiría el nombre de «colapso gravotérmico», echó raíces.
Así robustecido, dispuesto a emplear las matemáticas en cuestiones antiguas y a llevar los resultados inesperados hasta sus improbables consecuencias, se dedicó a problemas mucho más fáciles de la dinámica estelar. En 1962, durante una visita a la Universidad de Princeton, había tenido acceso por primera ocasión a los ordenadores, precisamente cuando Lorenz comenzaba a aplicarlos a la meteorología en el Massachusetts Institute of Technology. Hénon principió con modelos de las órbitas de las estrellas en derredor de su centro galáctico. De forma razonablemente simple, las de las galaxias pueden representarse como las de planetas alrededor de un sol, con una excepción: una fuente de la gravedad central no es un punto, sino un disco tridimensional.
Llegó a un compromiso con las ecuaciones diferenciales. «Para disfrutar de mayor libertad de experimentación —escribió— nos olvidamos de momento del origen astronómico del problema». Aunque no lo dijese entonces, la «libertad de experimentación» significaba, en parte, la de representar el problema en un ordenador primitivo. Éste poseía menos de una milésima parte de la memoria que tiene un solo chip de un ordenador personal de la actualidad, y además era lento. Pero, como los experimentadores en los fenómenos del caos que le siguieron, Hénon vio que la hipersimplificación resultaba provechosa. Abstrayendo la esencia de su sistema, descubrió cosas aplicables a otros, incluso más importantes. Años después, las órbitas galácticas eran todavía un ejercicio teórico; pero la dinámica de aquellos sistemas se hallaba sometida a la investigación, intensa y costosa, de los interesados en las órbitas de las partículas en aceleradores de alta energía, y a la de aquellos a quienes importaba el confinamiento de plasmas magnéticos para crear la fusión nuclear.
Las órbitas estelares, en las galaxias, a una escala temporal de unos doscientos millones de años tienen carácter tridimensional en lugar de describir elipses perfectas. Son muy difíciles de visualizar tanto si son reales como si son construcciones imaginarias en el espacio de fases. Por ello, Hénon adoptó una técnica comparable a la de la confección de los mapas de Poincaré. Concibió una lámina plana, colocada verticalmente a un lado de la galaxia, que cada órbita atravesaba, como los caballos cruzan la meta en un hipódromo. Después señaló el punto en que la órbita perforaba el plano y rastreó el movimiento del punto de órbita en órbita.
Hénon tuvo que trazar los puntos a mano, pero, con el tiempo, los numerosísimos científicos que usaron su técnica se limitaron a contemplar cómo aparecían en la pantalla del ordenador, como luces callejeras que se encienden al atardecer una tras otra. Por ejemplo, una órbita típica empezaba con un punto en la parte inferior de la izquierda; después, en la vuelta siguiente, otro punto comparecía algunos centímetros más a la derecha; luego, otro, más a la derecha y algo más alto, etc. Al pronto, no había diseño concreto, pero, marcados de diez a veinte puntos, empezaba a formarse una curva ovalada. El conjunto de puntos sucesivos recorrían un circuito alrededor de aquella figura, pero, como no se presentaban en idéntico lugar, la curva quedaba bien delineada sólo tras la aparición de centenares o millares de ellos.
Las órbitas no eran completamente regulares, porque jamás se repetían de modo exacto, pero podían predecirse y distaban mucho de ser caóticas. Los puntos nunca surgían dentro de la curva o fuera de ella. Transportadas a la imagen tridimensional, las órbitas esbozaron un toro o rosquilla, y el diagrama de Hénon fue su sección transversal. Hasta entonces sólo había ilustrado lo que sus predecesores consideraron evidente. Las órbitas eran periódicas. En el observatorio de Copenhague, entre 1910 y 1930, una generación de astrónomos las observó y calculó trabajosamente a cientos; sin embargo, únicamente las periódicas interesaron a los daneses. «Como todo el mundo en aquel período, yo estaba convencido de que todas las órbitas eran tan regulares como aquélla», escribió Hénon. A despecho de ello, con la colaboración de Carl Heiles, estudiante graduado que le auxiliaba en Princeton, persistió en el cómputo, aumentando paulatinamente el nivel de energía en su sistema abstracto. Pronto observaron algo nuevo.

Órbitas en torno al centro galáctico.
Michel Hénon computó las intersecciones de una órbita con un plano para comprender la trayectoria de las estrellas en una galaxia. Las pautas resultantes dependieron de la energía total del sistema. Los puntos de una órbita estable produjeron gradualmente una curva continua y coherente (arriba izquierda). Sin embargo, otros niveles energéticos ofrecieron intrincadas mezclas de estabilidad y caos, representadas por regiones de puntos dispersos.
Hénon trasladó su atención a otras cuestiones; pero catorce años después, cuando por fin se enteró de los atractores extraños de David Ruelle y Edward Lorenz, estaba dispuesto a servirse de ellos. Desde 1976 se hallaba en el Observatorio de Niza, sito a buena altura sobre el Mediterráneo, en la Grande Corniche. Asistió a una conferencia de un físico invitado sobre el atractor de Lorenz. El visitante había probado varias técnicas para aclarar la tenue «micro estructura» del atractor, y el éxito no le había sonreído. Los sistemas disipativos no eran su campo («En ocasiones los astrónomos temen los sistemas disipativos… Son desordenados»), pero Hénon creyó tener una idea.
Nuevamente optó por renunciar al origen físico del sistema y concentrarse en la esencia geométrica que deseaba explorar. Lorenz y otros se habían apegado a las ecuaciones diferenciales —corrientes, con cambios continuos en el espacio y el tiempo—; en cambio, él recurrió a las ecuaciones en diferencias, discontinuas temporalmente. La clave consistía, a su juicio, en el repetido estiramiento y plegamiento del espacio de fases, como un pastelero extiende la masa y la dobla, y la vuelve a extender y a doblar, produciendo una estructura que acabará en un conjunto de capas delgadas. Hénon dibujó en un papel un óvalo plano. Para estirarlo, escogió una breve función numérica, que movería cualquier punto del óvalo a otro nuevo, en una figura que se alargaría hacia arriba en el centro: un arco. Aquello era ejecutar un mapa o diagrama: punto a punto, el óvalo entero quedaba «proyectado» en el arco. Luego confeccionó un segundo mapa, de contracción, que reduciría el arco hacia dentro, estrechándolo. Y después, un tercer mapa volvió de lado el arco estrecho, para que se alinease bien con el óvalo original. Los tres podían combinarse con fines de cálculo en una sola función.
Obedecía en espíritu a la idea de la herradura de Smale. El proceso era numéricamente tan sencillo que podía llevarse a cabo con una máquina calculadora. Cualquier punto tenía una coordenada x y otra y que establecían sus posiciones horizontal y vertical. Para averiguar la nueva x, la regla estribaba en tomar la vieja y, sumar 1 y sustraer 1,4 veces la antigua x al cuadrado. Para hallar la vieja y, se multiplicaba 0,3 por la x antigua. Es decir, x nueva = y + 1 − 1,4x2, e y nueva = 0,3x. Henón tomó un punto más o menos al acaso, y, con la calculadora, estableció otros nuevos sucesivamente, hasta que hubo precisado millares de ellos. Hecho esto, recurrió a un ordenador de cuerpo entero, un IBM 7040, y en un santiamén estableció cinco millones. Quienquiera que disponga de uno individual y de un dispositivo de visualización gráfica, hará lo mismo con facilidad.
Al principio, los puntos parecen saltar a su antojo a lo largo y a lo ancho de la pantalla. El efecto es el de una sección de Poincaré de un atractor tridimensional, que se agite sin rumbo fijo. Pero en seguida comienza a emerger una figura, un perfil curvo como una banana. Los detalles aumentan cuanto más se prolonga el programa. Porciones del perfil ostentan cierto grosor aparente; a continuación, el grosor se precisa en dos líneas claras, y éstas en cuatro, un par muy junto y otro más separado. Ampliadas, cada una de las cuatro resulta componerse de dos más, y así sucesivamente, hasta el infinito. Como el atractor de Lorenz, el de Hénon muestra una interminable retrogradación, semejante a una inacabable serie de muñecas metidas una dentro de otra.
El detalle así graduado, líneas en el interior de líneas, se ve con forma final en una sucesión de imágenes que se amplían cada vez más. Pero el efecto fantástico del atractor extraño se aprecia de otra manera, cuando la figura surge, andando el tiempo, punto tras punto. Brota como un fantasma de la niebla. Los nuevos puntos se diseminan tan fortuitamente por la pantalla, que nadie pensaría que exista una estructura, y menos una tan intrincada y fina. Dos puntos consecutivos cualesquiera se hallan arbitrariamente separados, como los que estuvieron juntos al principio en una corriente turbulenta. Considerando el número que fuere de ellos, es imposible adivinar dónde aparecerá el siguiente, excepto, claro está, que se encontrará en un lugar del atractor.
Esta característica de los puntos y lo vago del diseño dificultan que se recuerde que la figura es un atractor. Es no sólo una determinada trayectoria de un sistema dinámico, sino también aquella a la que las restantes trayectorias convergen. Por tal razón, no importan las condiciones iniciales elegidas. Con tal de que el punto de partida esté cerca del atractor, unos pocos de los siguientes convergerán al atractor con gran velocidad.

El atractor de Hénon.
Una sencilla combinación de plegamiento y estiramiento produce un atractor fácil de computar, pero apenas comprendido por los matemáticos. Aparecen detalles cada vez más ricos, a medida que surgen primero millares y después millones de puntos. La ampliación evidencia que lo que parecen líneas sencillas son pares de ellas, y pares de pares. No obstante, es imposible predecir si dos puntos sucesivos estarán juntos o muy separados.
Años antes, en 1974, cuando David Ruelle llegó al laboratorio que Gollub y Swinney tenían en el City College, los tres físicos poseían un leve vínculo entre la teoría y la experimentación. Algo de matemáticas, osada filosofía e incierta técnica. Un cilindro de fluido alborotado, nada impresionante, que no armonizaba con la teoría acreditada. Los hombres pasaron la tarde charlando, y Swinney y Gollub se fueron de vacaciones con sus esposas a una cabaña que el segundo tenía en las Andirondacks. No habían contemplado un atractor extraño, y apenas habían medido qué ocurría en realidad al empezar la turbulencia. Pero estaban convencidos de que Landau se equivocaba, y presumían que Ruelle había dado en el blanco.
Como elemento natural, revelado por la exploración con ordenador, el atractor extraño nació como mera posibilidad, señalando un lugar al que no habían conseguido ir muchas de las grandes imaginaciones del siglo XX. Pronto, cuando los científicos vieron lo que los ordenadores podían mostrar, fue como algo que habían percibido por doquier, en la música de las corrientes turbulentas, o en las nubes desplegadas como velos sobre el firmamento. Se había reprimido a la naturaleza. El desorden estaba encauzado —todo parecía indicarlo— en pautas que tenían un común tema subyacente.
Más tarde, el reconocimiento de los atractores extraños atizó la revolución del caos, proporcionando a los exploradores numéricos un programa que habían de ejecutar. Los buscaron en todas partes, en todas donde la naturaleza daba motivos para creer que se portaba a la buena de Dios. Muchos pensaron que el tiempo atmosférico podía depender de un atractor extraño. Otros acopiaron millones de noticias del mercado bursátil para buscar en ellas un atractor, observando lo fortuito con las lentes graduables del ordenador.
En el comedio del decenio de 1970 estos descubrimientos eran cosa futura. Nadie había visto realmente un atractor extraño en un experimento, y no se sabía con certeza qué se debía hacer para encontrarlo. En teoría, concedía esencia matemática a las nuevas propiedades fundamentales del caos. Una era la dependencia sensitiva de las condiciones iniciales. Otra, la «mezcla», en el mismo sentido lleno de significado para un diseñador de aviones de retropropulsión, por ejemplo, preocupado por la combinación eficaz del combustible con el oxígeno. Pero todo el mundo ignoraba cómo se medían aquellas propiedades, cómo se las numeraba. Los atractores extraños parecían fractales, lo cual implicaba que su dimensión auténtica era fraccional; pero nadie sabía cómo se mensuraba la dimensión, o cómo se aplicaba aquella medida en el contexto de los problemas de ingeniería.
Más importante aúna. Se desconocía si los atractores extraños aclararían algo más la cuestión más profunda de los sistemas no lineales. A distinción de los lineales, que se calculaban y clasificaban con soltura, los no lineales se hallaban todavía, en esencia, más allá de toda clasificación, pues cada uno difería de los restantes. Acaso sospechasen los científicos que compartían ciertas propiedades, pero, en el momento de la medida y el cálculo, todo sistema no lineal era un orbe aparte. La comprensión de uno no contribuía al entendimiento del siguiente. Un atractor como el de Lorenz ilustraba la estabilidad y la estructura de un sistema que, por otra parte, parecía carecer de pautas, pero ¿qué ayuda prestaba aquella doble espiral peculiar a quienes investigaban sistemas no emparentados con ella? Nadie podía decirlo.
La impresión que causaron había ido más allá de la ciencia estricta. Los científicos que contemplaron aquellas figuras se permitieron olvidar momentáneamente las reglas por las que se gobernaban. Ruelle, por ejemplo, escribió: «No he hablado de la fascinación estética de los atractores extraños. Esos conjuntos de curvas y esas nubes de puntos hacen pensar, ya en fuegos de artificio o galaxias, ya en proliferaciones vegetales extrañas e inquietantes. Se esconden en ellos formas que deben explorarse y armonías que esperaban ser descubiertas».

Agrupaciones fractales.
La agrupación fortuita de partículas, generadas por un ordenador, produce una «red de filtración», uno de los muchos modelos visuales que ha inspirado la geometría fractal. Los físicos descubrieron que esos modelos imitan una variedad de procesos del mundo real, tales como la formación de polímeros y la difusión del petróleo a través de rocas fracturadas. Cada color en la red de filtración representa una agrupación, que está siempre en conexión consigo misma.
La repetición de estas líneas aporta oro;
el cerco de este círculo en el suelo
trae remolinos de viento, tempestades, trueno y centella.
MARLOWE,
El doctor Fausto
§. Nuevo inicio en Los Álamos§. Nuevo inicio en Los Álamos
§. La re normalización de grupo
§. Desciframiento del color
§. El auge de la experimentación numérica
§. El hallazgo de Michael Feigenbaum
§. Una teoría universal
§. Cartas de rechazo
§. Reunión en Como
§. Nubes y pinturas
A algunas docenas de metros, corriente arriba, del filo de una cascada, un manso riachuelo parece presentir el salto que se avecina. El agua se acelera y estremece. Chorros individuales se destacan como venas abultadas y palpitantes. Mitchell Feigenbaum está junto al raudal. Suda un poquito dentro de su chaqueta y pantalón de pana, y fuma. Está paseando con unos amigos, los cuales se le han anticipado hacia las aguas más sosegadas del caudal. De pronto, en lo que pudiera ser parodia veloz y desalentada del espectador de un partido de tenis, se pone a mover la cabeza de un lado a otro. «Uno se fija en algo, como, por ejemplo, un bultito de espuma. Si menea la cabeza con rapidez suficiente, tiene de repente una percepción de toda la estructura de la superficie, y se nota en el estómago». Extrae más humo del cigarrillo. «Pero cualquiera con formación matemática sabe que no sabe nada cuando mira este líquido, o contempla las nubes con sus protuberancias encima de protuberancias, o está en un rompeolas durante una tempestad».
Orden en el caos. El tópico científico más antiguo. La idea de unidad recóndita y de forma común oculta en la naturaleza había tenido fascinación intrínseca, así como una desdichada historia de seudocientíficos y maniáticos inspirados. Cuando llegó al Los Álamos National Laboratory en 1974, a un año de su trigésimo cumpleaños, Feigenbaum estaba convencido de que si deseaban sacar algo de aquella idea, los físicos necesitarían un marco práctico, un método que la redujera al cálculo. Apenas se comprendía cómo podía abordarse aquel problema.
Feigenbaum había sido contratado por Peter Carruthers, físico tranquilo y engañosamente afable, que, en 1973, procedente de Cornell, se encargó de la Sección Teórica. Lo primero que hizo fue despedir a media docena de científicos de categoría —Los Álamos recluta su personal de modo diferente de las universidades—, y llenó el hueco con investigadores jóvenes y prometedores seleccionados por él. Era muy ambicioso como jefe científico, pero conocía por experiencia que no siempre es posible planear los buenos resultados.
—Si se establece un comité en el laboratorio, o en Washington, y se dice: «La turbulencia nos sale al paso y debemos entenderla. La falta de comprensión anula nuestras posibilidades de progresar en una porción de campos». Entonces, lógicamente, se contrata un equipo. Se obtiene un ordenador gigante. Se meten en él grandes programas y no se consigue nada. En vez de ello, disponemos de este tipo listo, que no alborota. Claro que habla con la gente, pero casi siempre trabaja a solas.
Habían conversado sobre la turbulencia, pero pasó el tiempo y ni siquiera Carruthers estaba ya seguro de cuál era la meta de Feigenbaum.
—Creí que se había dado por vencido y encontrado otro problema. Poco suponía yo que el problema nuevo era el mismo. Parece haber sido aquel en que muchas y muy diferentes actividades científicas se habían atascado: se habían atollado en ese aspecto del comportamiento no lineal de los sistemas. Ahora bien, nadie hubiese pensado que la formación adecuada para esa cuestión fuese estar enterado de la física subatómica, saber algo de la teoría del cuanto de campo, y hallarse al corriente de que en esa teoría hay las estructuras denominadas re normalización de grupo. Todo el mundo ignoraba que se necesitaría entender la teoría general de los procesos estocásticos, así como las estructuras fractales.
»Mitchell tenía la preparación adecuada. Hizo lo preciso en el momento preciso y lo hizo muy bien. Nada de manera parcial. Se desembarazó de todo el problema. Feigenbaum proporcionó a Los Álamos el convencimiento de que la ciencia había fracasado en entender las cuestiones no lineales. Aunque como físico apenas había aportado algo, había acumulado un fondo intelectual poco corriente. Poseía un agudo conocimiento práctico del análisis matemático más difícil, nuevos géneros de técnicas de cálculo que ponían a casi todos los científicos entre la espada y la pared. Había conseguido retener algunas ideas, de aspecto anticientífico, del romanticismo. Quería hacer ciencia nueva. Comenzó por apartar de sí toda intención de entender la complejidad de lo real y recurrió, en cambio, a las ecuaciones no lineales más simples que logró encontrar.
§. La re normalización de grupo
El misterio del universo compareció por primera vez ante Mitchell Feigenbaum a los cuatro años de edad, poco después de la segunda guerra mundial, mediante una radio Silverstone. El aparato se hallaba en la sala de estar paterna, en el barrio de Flatbush de Brooklyn. Le intrigó que la música sonase sin causa tangible. Le parecía, por otro lado, que entendía el fonógrafo. Su abuela le había otorgado licencia especial para poner discos de setenta y ocho revoluciones.
Su padre estuvo empleado como químico en la junta directiva del puerto neoyorquino y luego en Clairol. Su madre era maestra en las escuelas públicas de la ciudad. Mitchell se propuso al principio ser ingeniero eléctrico, profesión que gozaba fama en Brooklyn de ser muy remuneradora. Se hizo cargo después de que la física le informaría mejor de las cosas que quería saber acerca de la radio. Perteneció a una generación de científicos, educados en los distritos externos de Nueva York, que se encaminaron a un futuro espléndido gracias a los grandes centros públicos de segunda enseñanza —en su caso, el Samuel I. Tilden— y el City College.
Crecer despabilado en Brooklyn era hasta cierto punto consecuencia de seguir un rumbo incierto entre el mundo de la mente y el de las personas. En los primeros tiempos de su vida fue inmensamente sociable, cualidad que consideró esencial para no sufrir malos tragos. Pero algo se iluminó en su interior cuando advirtió su capacidad para aprender cosas. Se apartó paulatinamente de sus amigos. Las conversaciones corrientes no atraían su interés. Durante el último curso en el colegio, pensó que había malgastado su adolescencia, y decidió de manera deliberada recobrar el contacto con sus semejantes. Sentado en la cafetería, escuchaba la charla de los estudiantes sobre el arte de afeitarse o sobre la comida, y poco a poco re aprendió la ciencia de conversar con la gente.
Se graduó en 1964 e ingresó en el Massachusetts Institute of Technology, en el que se doctoró, en 1970, en la especialidad de las partículas elementales. Luego pasó cuatro años estériles en Cornell y en el Virginia Polytechnic Institute (Instituto Politécnico de Virginia), es decir, estériles en cuanto a la publicación regular de trabajos sobre problemas útiles, lo cual es imprescindible para un joven científico universitario. Se daba por sentado que los posdoctorados debían publicar artículos. A veces un asesor le preguntaba qué había sucedido en el caso de un problema y él respondía: « ¡Oh! Ya lo he entendido».
Carruthers, científico formidable por derecho propio, recién instalado en Los Álamos, presumía de su tino para descubrir individuos talentudos. No buscaba inteligencia, sino la creatividad especial que parecía segregar una glándula mágica. Siempre recordaba el ejemplo de Kenneth Wilson, otro físico de habla suave de Cornell, que, en apariencia, no producía absolutamente nada. Quienquiera que hablase con él el tiempo necesario descubría su notable capacidad para contemplar las entrañas de la física. Por estas dos razones el puesto de Wilson motivó un grave debate. Se impusieron los colegas dispuestos a apostar por sus facultades indemostradas…, y fue como si un dique hubiera reventado. No un artículo, sino una catarata de ellos brotó de los cajones del escritorio de Wilson, y entre ellos un trabajo que mereció el Premio Nobel en 1982.
La gran contribución de Wilson a la física, y la de otros dos especialistas en ella, Leo Kadanoff y Michael Fisher, fue el principal antecesor de la teoría del caos. Con independencia total, pensaron de modo distinto sobre lo que ocurría en las transiciones de fase. Estudiaron el comportamiento de la materia en la inmediación del punto en que cambia de un estado a otro: de líquida a gaseosa, o de inmagnetizada a magnética. Como límites singulares entre dos reinos de la existencia, las transiciones de fase propenden en matemáticas a ser altamente no lineales. El comportamiento constante y predecible de la materia en una fase tiende a ser inútil para entender las transiciones. El agua de un cazo puesto al fuego se calienta hasta que alcanza el punto de ebullición. Entonces se interrumpe el cambio de temperatura y sobreviene algo muy interesante en la superficie molecular de contacto que media entre el líquido y el gas.
Tal como Kadanoff consideró el problema en la década de 1960, las transiciones de fase componen un rompecabezas intelectual. Un bloque de metal se magnetiza. Ha de tomar una decisión a medida que llega a un estado desordenado. El imán puede orientarse en esta o en aquella dirección. Es libre de escoger. Pero cada fragmentito de metal tiene que hacer la misma elección. ¿Cómo?
De alguna forma, en el proceso de elegir, los átomos metálicos deben de traspasarse información. La intuición de Kadanoff fue que la comunicación se describe con mucha sencillez en términos de escalas. Para ello, imaginó que dividía el metal en cajas. Cada una comunica con sus vecinas inmediatas. Esa comunicación se describe de la misma forma que la de los átomos con sus vecinos. He aquí la utilidad de las escalas: la mejor manera de pensar en el metal es la de un modelo análogo a los fractales, con cajas de distinto tamaño.
Se necesitaba intenso análisis matemático y muchas experiencias con los sistemas reales para sentar la eficacia de la idea escalar. Kadanoff tuvo la sensación de haber captado algo difícil de manejar y creado un mundo autónomo y de belleza extrema. En parte, la belleza consistía en su universalidad. Su idea dio consistencia al hecho más extraordinario de los fenómenos críticos, el de que tales transiciones, en apariencia carentes de relación —la ebullición de líquidos, la imantación de metales—, siguen las mismas reglas.
Después Wilson llevó a cabo la actividad que unió todo bajo la denominación de teoría de renormalización de grupo, con lo que proporcionó un método poderoso para efectuar cálculos reales sobre sistemas reales. La renormalización había entrado en la física en los años cuarenta como parte de la teoría cuántica, que posibilitó calcular las interacciones de electrones y fotones. Un engorro de aquellos cálculos, como los que preocupaban a Wilson y Kadanoff, fue que algunos elementos parecían requerir que se los tratase como cantidades infinitas, cosa por demás complicada y desagradable. Los infinitos desaparecieron con la renormalización del sistema con procedimientos debidos a Richard Feynman, Julian Schwinger, Freeman Dyson y otros físicos.
Sólo mucho después, en el decenio de 1960, Wilson excavó hasta los cimientos ocultos del éxito de la renormalización. Pensó, como Kadanoff, en los principios escalares. Algunas cantidades, tales como la masa de una partícula, siempre se habían considerado fijas, como la de cualquier objeto de la experiencia cotidiana. El atajo de la renormalización alcanzó su propósito, obrando como si una cantidad como la de la masa no fuera fija. Cantidades como aquéllas parecían flotar arriba o abajo, según la escala a que se concibiesen. Era absurdo. Sin embargo, respondía exactamente a lo que Benoît Mandelbrot percibía sobre las figuras geométricas y el litoral inglés. Su longitud no podía medirse sin tener en cuenta la escala. Era una especie de relatividad en que la posición del observador, cercana o lejana, en la playa o en una astronave, afectaba a la medida. Como había visto también Mandelbrot, la variación a lo largo de las escalas no era arbitraria; obedecía a reglas. La variabilidad en las mediciones corrientes de masa o longitud implicaba que permanecía inalterable una especie diferente de cantidad. En el caso de los fractales, era la dimensión fraccional, constante que podía calcularse y emplearse como instrumento en cálculos posteriores. Permitiendo que la masa variara conforme a la escala, los matemáticos podrían reconocer lo similar en todas las escalas.
Así, pues, en cuanto al duro trabajo de calcular, la teoría de la renormalización de grupo de Wilson fraguaba una ruta distinta para problemas muy densos. Hasta entonces la única que daba acceso a los no lineales muy complicados había sido el recurso denominado teoría de la perturbación. Con fines de cálculo, se supone que el problema no lineal está razonablemente próximo a uno lineal resoluble, a una levísima perturbación de distancia. Se resuelve el lineal y se efectúa una artimaña, bastante complicada, con la porción sobrante, ampliándola en lo que se llama diagramas de Feynman. Cuanta mayor exactitud se desee, tantos más diagramas de ese género torturante hay que producir. La suerte mediante, los cálculos convergen hacia una solución. No obstante, la suerte tiene el don especial de esfumarse siempre que un problema encierra mucho interés. Feigenbaum, como todos los jóvenes físicos de partículas de los años sesenta, se encontró haciendo interminables diagramas de Feynman. Acabó convencido de que la teoría de la perturbación era tediosa, nada esclarecedora y estúpida. Por ello, se enamoró de la nueva teoría de la renormalización de grupo de Wilson. El reconocimiento de la auto semejanza proporcionaba un método para sacar lo complejo, estrato tras estrato.
En la práctica, la renormalización de grupo no era tan segura como prometía. Reclamaba mucho ingenio para elegir los cálculos que captasen la auto semejanza. Con todo, daba buenos resultados con la frecuencia suficiente para inspirar a algunos físicos, incluido Feigenbaum, el propósito de acometer con ella la cuestión de la turbulencia. En el fondo, la auto semejanza aparentaba ser la característica de lo turbulento, fluctuaciones dentro de fluctuaciones, espirales dentro de espirales. Pero ¿qué había del principio de la turbulencia, del instante misterioso en que un sistema ordenado se volvía caótico? No existían pruebas de que la re normalización de grupo fuese capaz de decir algo sobre aquella transición. No las había, por ejemplo, de que la transición obedeciera a las leyes de la escala.
§. Desciframiento del color
Feigenbaum, siendo estudiante graduado en el MIT, había tenido una experiencia que le acompañó en el decurso de muchos años. Se paseaba con unos amigos alrededor del Lincoln Reservoir de Boston. Adquiría ya el hábito de caminar durante cuatro o cinco horas diarias, poniéndose en armonía con el chaparrón de ideas e impresiones que cruzaban su cerebro. En el día en cuestión, se separó del grupo y anduvo solo. Dejó atrás unas personas que merendaban y, mientras avanzaba, se volvió de cuando en cuando a escuchar sus voces y observar el movimiento de sus manos, que gesticulaban o cogían alimentos. De repente, sintió que aquel cuadro había cruzado el umbral desconocido y entrado en lo incomprensible. Las figuras eran tan pequeñas que no se precisaban. Sus actos parecían inconexos, arbitrarios, fortuitos. Los leves sonidos que llegaban a él carecían de sentido.
«El movimiento incesante y bullicio incomprensible de la vida». Feigenbaum se acordó de las frases de Gustav Mahler al describir la sensación que quería plasmar en el tercer movimiento de su Segunda Sinfonía. «Como los movimientos de personas que danzan en un salón brillantemente iluminado, que se ve desde el exterior en la noche oscura y desde tanta distancia, que la música no se oye… La vida puede parecernos desprovista de sentido». Feigenbaum escuchaba a Mahler y leía a Goethe, sumiéndose en sus actitudes, tan románticas. Inevitablemente, le entusiasmaba el Fausto de Goethe, y se empapaba de su combinación de ideas apasionadísimas sobre el mundo con las más intelectuales. Si hubiera carecido de inclinaciones románticas, no cabe duda de que habría echado de sí una sensación como su confusión en el Reservoir. Total, ¿por qué los fenómenos no habían de perder significado al ser contemplados desde lejos? Las leyes físicas proporcionaban una explicación trivial de su empequeñecimiento. Pero, bien pensado, no era tan evidente la relación de su disminución con la pérdida de significado. ¿Por qué, cuando se empequeñecen, las cosas se vuelven incomprensibles?
Analizó aquella experiencia con herramientas de la física teórica, preguntándose qué diría él sobre el mecanismo de percepción del cerebro. Se perciben unas acciones humanas y se hacen deducciones sobre ellas. Dada la colosal suma de información ofrecida a nuestros sentidos, ¿cómo las entresaca nuestro aparato de desciframiento? Con seguridad —o casi con seguridad—, el cerebro no posee copias directas de las cosas del mundo. No hay biblioteca de formas e ideas con que comparar las imágenes de la percepción. Existe algún caos en el exterior, y el encéfalo posee a todas luces más flexibilidad que la física clásica para hallar orden en él.
Al propio tiempo, Feigenbaum reflexionó sobre el color. Una de las escaramuzas menores de la ciencia, en los primeros años del siglo XIX, fue la diferencia de opinión entre los seguidores de Newton, en Inglaterra, y de Goethe, en Alemania, sobre la naturaleza del color. Para aquéllos, las ideas goethianas eran desvarío seudocientífico. Goethe se negaba a considerarlo una cantidad estática, que se medía con el espectómetro y se clavaba como una mariposa en el corcho. Afirmaba que el color era asunto de la percepción. «Cuando la luz se cierne y contrapesa, la naturaleza oscila dentro de los límites que ha prescrito —escribió—; no obstante, surgen así todas las variedades y condiciones de los fenómenos que se nos aparecen en el espacio y el tiempo».
Piedra angular de la teoría newtoniana era su notorio experimento con un prisma. Éste descompone el rayo de luz blanca en el arco iris, que ocupa todo el espectro visible. Newton comprendió que aquellos colores puros eran los componentes elementales que, sumados, producen el blanco. Además, con inspiración profética, propuso que correspondían a frecuencias. Imaginó que unos cuerpos vibratorios —corpúsculos en la terminología antigua— los generaban de acuerdo con la velocidad de las vibraciones. Fue algo tan injustificado como admirable, en vista de la escasez de pruebas que apoyaban la noción. ¿Qué es el rojo? Para el físico, luz que se propaga en ondas, cuya longitud oscila entre 600 y 800 mil millonésimas de metro. La óptica de Newton fue probada y comprobada hasta la saciedad, en tanto que la hipótesis de Goethe quedó envuelta en oscuridad piadosa. Feigenbaum buscó su libro en las bibliotecas de Harvard y comprobó que había desaparecido.
Por último, encontró un ejemplar y se enteró de que Goethe había efectuado una extraordinaria serie de experimentos en su investigación. Había principiado con un prisma, como Newton. El inglés lo situó en el trayecto de una luz, cuya descomposición proyectó en una superficie blanca. Goethe aplicó el prisma a su ojo y miró a través de él. No vio color: ni arco iris, ni tonos individuales. El efecto era el mismo si utilizaba el prisma para observar una superficie blanca o un cielo azul: uniformidad.
Pero contemplaba una manifestación de color en cuanto una manchita interrumpía la albura o una nube aparecía en el firmamento. Era «el intercambio de luz y sombra» lo que causaba el color, concluyó Goethe. Pasó a explorar la forma en que la gente percibía las sombras de diversas fuentes de luz coloreada. Usó bujías y lápices, espejos y cristales colorados, la luz de la luna y la del sol, vidrios, líquidos y ruedas policromas, en una escrupulosa colección de experimentos. Por ejemplo, encendió una bujía delante de un papel blanco en el crepúsculo e interpuso un lápiz. La sombra fue azul brillante. ¿Por qué? El papel blanco sólo se ve como tal a la luz del día declinante o la que agregaba la bujía. ¿Cómo una sombra divide lo blanco en una región azul y en otra rojo-amarillenta? El color es «un grado de oscuridad», afirmó Goethe, «aliado a la sombra». Sobre todo, en lenguaje más moderno, el color proviene de condiciones y singularidades fronterizas.
Goethe fue holista donde Newton era reduccionista. El inglés descompuso la luz y encontró la explicación física más básica del color. El alemán anduvo por parques floridos y estudió pinturas, buscando una explicación grande, omni-abarcante. Aquél hizo que su teoría del color se ajustase a un esquema matemático válido para toda la física. Éste, afortunada o desdichadamente, aborrecía las ciencias exactas.
Feigenbaum creyó que Goethe había acertado. Sus ideas se asemejan a una noción asequible, popular entre los psicólogos, la cual distingue la firme realidad material de su variable percepción subjetiva. Los colores que vemos cambian según las circunstancias, y de persona a persona. Es fácil decirlo. Pero, como Feigenbaum las entendía, las ideas de Goethe poseían más ciencia, ciencia verdadera. Eran concretas y empíricas. El genial alemán había insistido sobradamente en lo serio de sus experimentos. Para él, lo universal y objetivo era la percepción del color. ¿Qué prueba científica había de una cualidad, definible y real, de lo rojo, independiente de nuestra percepción?
Feigenbaum se sorprendió meditando qué clase de formalismos matemáticos corresponderían a la percepción humana, en particular a una que cribaba la intrincada multiplicidad de la experiencia y descubría cualidades universales. La calidad de rojo no es, inevitablemente, una determinada anchura de banda de la luz, como pretendían los newtonianos. Es territorio de un universo caótico, cuyos límites cuesta describir, a pesar de lo cual nuestras mentes encuentran lo rojo con consistencia regular y comprobable. Éstos eran los pensamientos de un joven físico, muy alejados, en apariencia, de problemas tales como la turbulencia de los fluidos. Sin embargo, para entender cómo la mente humana entresaca algo del caos de la percepción, había que entender de qué manera el desorden produce universalidad.
§. El auge de la experimentación numérica
Feigenbaum descubrió que su educación no le había enseñado nada útil cuando empezó a meditar en Los Álamos sobre la no linealidad. Era imposible solucionar un sistema de ecuaciones diferenciales no lineales, a pesar de los ejemplos especiales que constan en los libros de texto. Parecía desatentada la técnica perturbativa, consistente en introducir sucesivas correcciones en un problema solventable del que se esperaba que se aproximara algo al real. Leyó escritos sobre corrientes y oscilaciones no lineales, y llegó a la conclusión de que existía muy poco capaz de ayudar a un físico razonable. Su equipo informático se componía sólo de lápiz y papel, y por ello decidió comenzar con una analogía de la sencilla ecuación de Robert May sobre la biología de la población.
Era la misma que los estudiantes de enseñanza secundaria emplean en geometría para representar una parábola. Puede escribirse como y = r(x − x2). Cada valor de x produce uno de y, y la curva resultante expresa la relación de los dos números en la serie de valores. Si x (la población de este año) es pequeño, y (la del año que viene) también lo es, aunque sea mayor que x, la curva se eleva. Si x se halla en medio de la serie, y es grande. Pero la parábola se nivela y desciende, y, por lo tanto, si x es grande, y volverá a ser pequeño. En eso estriba el equivalente de las caídas de la población en el modelo ecológico, impidiendo un crecimiento irreal desenfrenado.
Tanto para May como, luego, para Feigenbaum, el quid se centraba en utilizar aquel cálculo sencillo no una vez, sino en repetirlo interminablemente como un bucle de realimentación. El resultado de un cálculo se introducía como entrada del siguiente. La parábola fue utilísima para comprobar gráficamente lo que sucedía. Elíjase un valor de partida en el eje x. Trácese una recta hacia arriba hasta que encuentre la parábola. Léase el valor resultante en el eje y. Y repítase la operación con el nuevo valor. La secuencia salta, al principio, de un lugar a otro, en la parábola, y después, tal vez, adopta un equilibrio estable, en que x e y son iguales y el valor, por consiguiente, no cambia.
Nada podía estar más remoto de los cálculos complicados de la física corriente. En lugar de un esquema laberíntico, que debía resolverse de una vez, aquél era sencillo y repetido sin cesar. El experimentador matemático podía observar como el químico que vigila una reacción en un vaso de precipitados. El resultado, el output, no pasaba de ser una sucesión de cifras, y no convergía siempre en un estado estable final. Podía acabar oscilando entre dos valores. O, como May había explicado a los biólogos de la población, mantenerse en un cambio caótico todo el tiempo que se observara tal situación. La elección de aquellos diferentes comportamientos posibles dependía del valor del parámetro sintonizador.
Feigenbaum realizó esfuerzos numéricos de esta especie, levemente, experimental y, a la vez, empleó métodos teóricos más clásicos en el análisis de funciones no lineales. Ello no obstante, no vio todo el cuadro de lo que podía hacer aquella ecuación. Comprobó, eso sí, que las posibilidades eran tan complejas, que sería espantosamente arduo analizarlas. Sabía asimismo que tres matemáticos de Los Álamos —Nicholas Metropolis, Paul Stein y Myron Stein— habían estudiado aquellos «mapas» o diagramas en 1971. Paul Stein le advirtió que la complejidad era tremenda. Si tal ecuación, la más sencilla de todas, se presentaba como intratable, ¿qué serían otras, mucho más complicadas, que un científico podía utilizar en el caso de los sistemas reales? Feigenbaum archivó el problema.
En la breve historia del caos, aquella ecuación de aire inocente sirve de ejemplo sucinto de cómo diferentes científicos consideraban el mismo problema de forma muy distinta. La ecuación tenía un mensaje para los biólogos: los sistemas sencillos hacen cosas complejas. Metropolis, Stein y Stein deseaban catalogar una colección de ejemplares topológicos sin referirse a valores numéricos. Iniciaban el proceso de realimentación en un punto dado y veían cómo saltaban los valores sucesivos de un lugar a otro en la parábola. Escribían las series de D y de I a medida que los valores se movían a la derecha o a la izquierda. Pauta número uno: D. Pauta número dos: DID. Pauta número ciento noventa y tres: DIIIIIDDII. Las series poseían ciertos rasgos interesantes para los matemáticos: parecían repetirse siempre en el mismo orden especial. En cambio, a un físico se le antojaban oscuras y tediosas.
Nadie lo advirtió entonces, pero Lorenz había considerado la misma ecuación, en 1964, como metáfora de una cuestión radical sobre el clima. Era tan profunda que casi nadie había pensado en formularla antes: ¿Existe un clima? O sea, ¿posee el tiempo terrestre un promedio a largo plazo? La mayor parte de los meteorólogos, entonces como ahora, daban la respuesta por sabida. Cualquier comportamiento mensurable, fuese cuál fuere su fluctuación, había de tener un promedio. Pero, si se recapacitaba, la cosa no era tan evidente. El tiempo medio en los últimos 12.000 años, como Lorenz señaló, había sido muy distinto del promedio de los 12.000 años anteriores, cuando el hielo cubría casi toda América del Norte. ¿Un clima se cambiaba en otro por algún motivo físico? ¿O había un clima a plazo todavía mayor dentro del cual aquellos períodos sólo eran fluctuaciones?
Lorenz hizo una segunda pregunta. Supóngase que se puede escribir el juego completo de ecuaciones que rigen el tiempo atmosférico. Dicho de otro modo, supóngase que se tiene el código de Dios. ¿Sería posible entonces calcular con esas ecuaciones los promedios estadísticos de la temperatura o la lluvia? La contestación sería una afirmación inmediata, si las ecuaciones fuesen lineales. Pero no lo son. Como Dios no ha suministrado las idóneas, Lorenz examinó la ecuación de diferencia cuadrática.
Examinó ante todo, como May, qué sucedía cuando la ecuación, dado algún parámetro, se iteraba. Con parámetros bajos llegaba a un punto fijo estable. El sistema producía un «clima» en la acepción más vulgar posible: el «tiempo» nunca cambiaba. Con parámetros más elevados, vio la posibilidad de oscilar entre dos puntos, y en ella el sistema se dirigió a un promedio sencillo. Pero Lorenz descubrió que el caos brotaba más allá de cierto punto. Puesto que pensaba en el clima, quiso saber no sólo si la continua realimentación generaría un comportamiento periódico, sino asimismo cuál sería el resultado promedio. Y reconoció que la contestación diría que el promedio fluctuaría inestablemente. Cuando el valor del parámetro se modificaba, aunque de manera leve, el término medio podía alterarse de modo impresionante. Por analogía, el clima terrestre tal vez jamás se acomodase a un equilibrio aceptable, durante el comportamiento a largo término promedio.
Desde el punto de vista editorial y matemático, el trabajo de Lorenz sobre el clima quizá hubiese sido un fracaso: no probaba nada en la acepción axiomática. También era muy deficiente como artículo de física, porque no justificaba la utilización de ecuación tan simple para sacar conclusiones sobre el clima de la Tierra. Con todo, Lorenz supo lo que decía. «El autor presiente que esta semejanza no es mero accidente, pues la ecuación en diferencias capta gran parte de la expresión matemática, ya que no la física, de las transiciones de un régimen de flujo a otro, y, ciertamente, la del fenómeno total de la inestabilidad». Veinte años más tarde nadie entendía aún qué intuición justificaba pretensión tan osada, publicada en Tellus, revista sueca de meteorología. («¡Tellus! Nadie lee eso», exclamó un físico con acritud). Lorenz entendía mejor, despacio, pero constantemente, las peculiares posibilidades de los sistemas caóticos, mucho mejor de lo que era capaz de expresar con la terminología meteorológica.
Mientras persistía en la exploración de los aspectos mutables de los sistemas dinámicos, Lorenz se dio cuenta de que otros, algo más complicados que el diagrama cuadrático, acaso produjeran otras especies de pautas inesperadas. Oculta en el interior de un sistema dado, pudiera haber más de una solución estable. Quizá se viese durante largo tiempo una clase de comportamiento, pero otro, totalmente diverso, podía ser tan natural como él. Este género de sistema se llama intransitivo. Se halla en este o en aquel equilibrio, pero no en ambos a la vez. Sólo una fuerza externa le obligará cambiar de estado. Un reloj de pared con péndulo sirve de modelo corriente de sistema intransitivo. Recibe un flujo uniforme de energía de un resorte, al que se da cuerda, o de una batería, a través de un mecanismo de escape. La fricción resta una porción constante de energía. El estado evidente de equilibrio es un movimiento oscilatorio regular. Si alguien choca con el reloj, el péndulo se acelerará o irá más despacio a consecuencia del impulso momentáneo, mas no tardará en recuperar el equilibrio. Sin embargo, tiene otro equilibrio —una segunda solución válida de sus ecuaciones de movimiento—, y es cuando el péndulo cuelga inmóvil. Tal vez fuese un sistema intransitivo menos sencillo —con varias regiones distintas de comportamiento completamente diferente— el que el clima representaba.
Desde hace algunos años, los climatólogos saben que sus modelos —los globales de ordenador, con los que simulan el comportamiento de la atmósfera y los océanos— admiten cuando menos un equilibrio absolutamente distinto. Ese clima alternativo jamás existió en el pasado geológico, pero pudiera ser una solución asimismo válida en el conjunto de ecuaciones que gobiernan el globo terráqueo. Algunos climatólogos le atribuyen el nombre de clima de la Tierra Blanca, en que los continentes se hallan cubiertos de nieve, y los océanos, helados. Un mundo como ése reflejaría el setenta por ciento de la radiación solar, y por lo tanto, sería gélido. La capa inferior de la atmósfera, o troposfera, tendría mucho menos espesor. Las tempestades que azotarían la fría superficie carecerían de la intensidad de las que conocemos. En general, el clima sería más hostil a la vida que el de ahora. Los modelos de ordenador tienen tendencia tan acusada a buscar el equilibrio de la Tierra Blanca, que los especialistas se extrañan de que nunca haya existido. Tal vez sea cuestión de suerte.
Sólo la intervención vigorosa de una fuente externa lograría que el clima terrestre pasara al estado glacial. Lorenz describió otro comportamiento plausible llamado «cuasi intransitividad». Un sistema de esta especie exhibe, durante mucho tiempo, algo así como un comportamiento promedio, que fluctúa dentro de ciertos límites. Después, sin causa alguna, se metamorfosea en otro diferente, también fluctuante, mas con un promedio distinto. Los diseñadores de modelos de ordenador están enterados del descubrimiento de Lorenz; no obstante, tratan a toda costa de evitar la cuasi intransitividad. Es demasiado impredecible. Por querencia natural hacen modelos dotados de fuerte tendencia al equilibrio que medimos cada día en el planeta real. Luego, con el fin de explicar los grandes cambios climáticos, buscan motivos externos, como, por ejemplo, las alteraciones de la órbita de la Tierra alrededor del Sol. A pesar de ello, el climatólogo no necesita fervorosa imaginación para notar que la cuasi intransitividad explicaría satisfactoriamente por qué el clima terrestre ha experimentado, y dejado de experimentar, largas eras glaciales, durante intervalos misteriosos e irregulares. Si la empleara, no habría de descubrir una causa física para explicar su aparición. Las eras glaciales no serían más que un subproducto del caos.
§. El hallazgo de Michael Feigenbaum
El científico contemporáneo siente alguna nostalgia de la calculadora manual HP-65, nostalgia comparable a la del coleccionista de armas de fuego que recuerda el Colt 45 en la época del armamento automático. Dicha máquina, en los pocos años en que gozó de supremacía, cambió para siempre los hábitos de trabajo de muchos científicos. Para Feigenbaum, fue el puente entre el lápiz y el papel y una utilización de los ordenadores que todavía no se había concebido.
No sabía nada de Lorenz; pero, en el estío de 1975, en una reunión celebrada en Aspen (Colorado), oyó hablar a Steve Smale de algunas cualidades matemáticas de la ecuación en diferencias cuadráticas. Smale pensaba, por lo visto, que había interesantes cuestiones irresueltas sobre el punto exacto en que el diagrama se transforma de periódico en caótico. Como siempre, Smale mostraba su agudo instinto de los problemas merecedores de ser explorados. Feigenbaum decidió echar otra mirada. Con su calculadora, utilizó una combinación de álgebra analítica y de investigación numérica para comprender el mapa cuadrático, concentrándose en la región limítrofe del orden y el caos.
Metafóricamente —sólo metafóricamente— sabía que aquella región era como la frontera misteriosa entre el flujo uniforme y la turbulencia en un fluido. Robert May había llamado sobre ella la atención de los biólogos de la población, que no habían percibido la posible existencia de ciclos irregulares en el cambio de las comunidades animales. En aquella región, camino del caos, había un alud de duplicaciones de período, de divisiones de dos ciclos en cuatro, de cuatro en ocho, etc. Aquellos desdoblamientos componían un diseño fascinador. Eran los puntos en que un leve cambio de la fecundidad, por ejemplo, podía hacer que una población de mariposas lagartas fuese de un ciclo de cuatro años a uno de ocho. Feigenbaum optó de momento por calcular los valores paramétricos exactos que originaban los desdoblamientos.
A la postre, la lentitud de la calculadora le llevó a un descubrimiento en aquel mes de agosto. Tardaba siglos —minutos, de hecho— en calcular el valor paramétrico exacto de cada duplicación de período. Cuanto más se remontaba por la cadena, tanto más tiempo requería. Con un ordenador rápido y un papel de impresión, quizá no hubiese observado la pauta. Pero había de escribir los números a mano, después reflexionar durante la espera y, en fin, para ganar tiempo, imaginar cuál sería la respuesta siguiente.
De pronto, comprendió en un instante que no tenía que imaginar. El sistema ocultaba una regularidad inesperada: los números convergían geométricamente, lo mismo que, en un dibujo en perspectiva, una línea de postes idénticos de teléfono converge hacia el horizonte. Si se proporciona el tamaño justo a un par de postes, se conoce el del resto; la relación del segundo con el primero será también la del tercero con el segundo, etc. Las duplicaciones de período aparecían no sólo con progresiva rapidez, sino también en orden constante.
¿Por qué? Por lo regular, la presencia de una convergencia geométrica sugiere que algo, en alguna parte, se repite a escalas diferentes, pero nadie había visto una pauta escalar en aquella ecuación, en caso de que la hubiese. Feigenbaum calculó la razón de convergencia con la mayor precisión posible en su máquina —tres decimales— y obtuvo una cifra: 4,669. ¿Significaba algo? Efectuó lo que hubiera hecho cualquier matemático. Pasó el resto del día intentando ajustar la cifra a las constantes conocidas: 7r, e y todas las demás. No era variante de ninguna.
Robert May recordó más tarde que también él había observado aquella convergencia geométrica, y que la olvidó en seguida. Desde su punto de vista de ecologista, se trató de una curiosidad numérica y nada más. En los sistemas del mundo real que estudiaba, los de poblaciones animales e incluso los de modelos económicos, el barullo inevitable anularía un detalle tan preciso como aquél. La misma confusión que le había guiado hasta allí le hizo hacer alto en el punto crucial. May se sentía excitado por la conducta general de la ecuación. Jamás sospechó que los detalles numéricos tuvieran importancia.
Feigenbaum sabía lo que se le ofrecía. La convergencia geométrica significaba que algo en aquella ecuación era escalar, y estaba convencido de que tenía importancia. De ello dependía cuanto afectaba a la teoría de la re normalización. En un sistema de aspecto en apariencia irregular, la escala implicaba que cierta cualidad se mantenía, mientras que el resto se alteraba. La turbulenta superficie de la ecuación ocultaba regularidad. Pero ¿dónde? ¿Qué debía hacerse a continuación?
El verano se transforma pronto en otoño en el aire sutil de Los Álamos. Octubre terminaba cuando Feigenbaum tuvo un pensamiento curioso. Estaba enterado de que Metropolis, Stein y Stein habían examinado otras ecuaciones y habían reparado en que determinadas pautas pasaban de una clase de función a otra. Aparecían las mismas combinaciones de D e I, y lo hacían en el mismo orden. Una función había incluido el seno de un número, desviación que restaba pertinencia a los meticulosos desvelos con que Feigenbaum había abordado la ecuación de la parábola. Tendría que recomenzar. Cogió de nuevo su HP-65 y computó las duplicaciones de período para xt+i =r sen π xt. El cálculo de una función trigonométrica imponía gran lentitud al proceso, y Feigenbaum se preguntó si sería capaz de emplear un atajo, como en el caso de la versión más sencilla de la ecuación. Y así, escrutando las cifras, percibió que convergían una vez más geométricamente. En el fondo, había de calcular la razón de convergencia de la nueva ecuación. Nuevamente, la precisión quedó afectada, pero obtuvo un resultado con tres decimales: 4,669.
Era el mismo número. Por increíble que pareciera, la función trigonométrica no mostraba regularidad geométrica consistente, sino una numéricamente idéntica a la de una función mucho más simple. No existía teoría matemática o física que explicara por qué dos ecuaciones, de forma y de significado tan distintos, daban el mismo resultado.
Feigenbaum visitó a Paul Stein. Éste no estaba dispuesto a admitir la coincidencia con pruebas tan escasas. En realidad, la precisión era discutible. Sin embargo, Feigenbaum telefoneó a sus padres, que estaban en Nueva Jersey, para comunicarles que había topado con algo muy profundo. Aseguró a su madre que le haría célebre. Después compulsó otras funciones, todas las que se le ocurrieron con tal de que tuvieran una secuencia de bifurcaciones en su avance hacia el desorden. Y todas produjeron la misma cifra.
Feigenbaum había jugado con números toda su vida. En su adolescencia, sabía calcular logaritmos y senos que casi todo el mundo buscaba en las tablas. En cambio, nunca había aprendido a manejar una calculadora más grande que la manual de su propiedad. En ello coincidía con los físicos y matemáticos, que sentían desdén típico por el pensamiento mecanicista que significaba el trabajo con ordenadores. Había llegado el momento de recurrir a ellos. Rogó a un colega que le enseñase el Fortran, y, al terminar el día, había calculado la constante de una variedad de funciones hasta cinco decimales: 4,66920. Aquella noche leyó en el manual lo que había sobre la precisión doble, y al día siguiente computó hasta 4,6692016090, a saber, hasta obtener la precisión suficiente que convenciera a Stein. No obstante, Feigenbaum no estaba seguro de haberse convencido a sí mismo. Había partido en busca de regularidad —lo que implicaba comprender las matemáticas—; pero también había partido conociendo que aquella clase especial de ecuaciones, como ciertos sistemas físicos, se comporta de modo característico. Las ecuaciones eran sencillas, en resumidas cuentas. Feigenbaum entendía la cuadrática y la del seno, y calcularlas no era ejecutar una hazaña extraordinaria. Sin embargo, algo en el meollo de todas creaba una sola cifra reiteradamente. Había tropezado, acaso con una curiosidad, acaso con una ley desconocida de la naturaleza.
Figúrese que un zoólogo prehistórico decide que unas cosas son más pesadas que otras, que poseen una cualidad abstracta que llama peso, y desea investigar la idea de manera científica. Jamás ha medido el peso, pero cree tener una intuición de él. Contempla serpientes grandes y pequeñas, osos grandes y pequeños, y presume que el peso de aquellos animales guarda cierta relación con su tamaño. Construye una báscula y se pone a pesar serpientes. Y se queda atónito al comprobar que todas pesan lo mismo. Su consternación arrecia cuando descubre que los osos tienen asimismo peso idéntico. El de todos es 4,6692016090. Por consiguiente, el peso no es lo que suponía. El concepto exige emprender de nuevo la meditación desde el principio.
Las corrientes undosas de agua, el balanceo del péndulo, los osciladores electrónicos y muchos sistemas físicos experimentaban una transición en el camino del caos, y aquellas transiciones habían manifestado tanta complejidad, que se resistían al análisis. Todas eran sistemas cuyo mecanismo creía comprenderse muy bien. Los físicos conocían las ecuaciones oportunas; pero aparecía como imposible el hecho de ir de las ecuaciones a la comprensión del comportamiento global a largo plazo. Por desdicha, las ecuaciones sobre los fluidos, incluso sobre los péndulos, resultaban mucho más arcanas que el simple diagrama logístico unidimensional. Pero el descubrimiento de Feigenbaum indicaba que eran incongruentes. Que no hacían al caso. El orden, al surgir, parecía de pronto haber olvidado cuál era la ecuación original. No importaba que fuese cuadrática o trigonométrica: el resultado era el mismo.
—Toda la tradición de la física reza que se aíslan los mecanismos y después el resto sigue adelante —dijo—. Eso se desmorona. Se conocen las ecuaciones precisas, mas no sirven para nada. Se suman todos los fragmentos microscópicos y se advierte la imposibilidad de extenderlos hasta el largo plazo. No son lo importante en el problema. Eso modifica por completo lo que significa saber algo. Pese a lo tenue del nexo de las ciencias exactas y la física, Feigenbaum tenía pruebas de la necesidad de inventar un procedimiento para calcular problemas no lineales complejos. Hasta entonces todas las técnicas de que disponía habían dependido de los detalles de las funciones. Si era una función de seno, sus cálculos fueron los apropiados para ella. Su hallazgo de la universalidad indicaba que habría que arrojar todas aquellas técnicas por la ventana. La regularidad nada tenía que ver con los senos. Ni con las parábolas. Ni con ninguna función especial. Pero, ¿por qué? Era desconcertante. La naturaleza había descorrido una cortina durante un instante, ofreciendo vislumbres de un orden inesperado. ¿Qué habría detrás de aquella cortina?

Ataque al caos.
Una ecuación simple, repetida muchísimas veces: Mitchell Feigenbaum se centró en funciones claras, en las cuales tomó un número como entrada (input) y otro como salida (output). En cuanto a los animales, una función puede expresar la relación entre la población de un año y la del siguiente. Un modo de visualizar tales funciones consiste en utilizar un diagrama en que el eje horizontal representa la entrada y el vertical la salida. Para cada entrada posible, x, hay sólo una salida, y, y forman una figura que se indica con la línea gruesa. Después, como representación del comportamiento a largo plazo del sistema, Feigenbaum trazó una trayectoria que empezaba en una xarbitraria. Puesto que cada y era realimentada en la misma función como nueva entrada, logró utilizar una especie de atajo esquemático: la trayectoria se apartaría de la línea de 45 grados, en la que x igualaba a y. La función más obvia del crecimiento de la población es, para el especialista en ecología, la lineal, a saber, el planteamiento maltusiano de aumento constante e ilimitado según un porcentaje fijo anual (izquierda). Funciones más realistas formaban un arco, que hacía disminuir la población cuando crecía demasiado. Se evidencia con el «diagrama logístico», parábola perfecta, definida por la función y =rx (1 − x), en que el valor de r, de 0 a 4, determina la pendiente de la parábola. Feigenbaum descubrió que lo de menos era la clase de arco que empleaba; los detalles de la ecuación no venían al caso. Lo que importaba era que la función tuviese una «joroba». El comportamiento dependía sensitivamente de la pendiente, del grado de linealidad o de lo que Robert May consideraba «el florecimiento y la proliferación». Una función demasiado plana acarrearía la extinción: la población inicial acabaría en cero. El aumento de la pendiente produciría el equilibrio estable que los estudiosos tradicionales de la ecología esperaban; ese punto, actuando en todas las trayectorias, era un «atractor» unidimensional. Más allá de cierto límite, una bifurcación ocasionaba una población oscilante de período dos. A continuación, había más duplicaciones de período y, por último (abajo, derecha), la trayectoria se negaba en redondo a fijarse. Tales imágenes sirvieron de base inicial a Feigenbaum cuando intentó edificar una teoría. Pensó en términos recurrentes: funciones de funciones, funciones de funciones de funciones, etc.; diagramas con dos jorobas, después con cuatro…
La inspiración llegó ofreciendo algo plástico, la imagen mental de dos pequeñas formas onduladas y una grande. Aquello fue todo: una imagen brillante y clara grabada en su cerebro, tal vez sólo la punta visible de un colosal iceberg de trabajo mental, efectuado por debajo de la línea de flotación de la consciencia. Tenía que ver con las escalas. Y brindó a Feigenbaum el camino que necesitaba.
Estudió los atractores. El equilibrio estable de sus gráficas era un punto fijo que atraía a los demás. Fuese cual fuere la que despuntara, la «población» saltó indefectiblemente hacia el atractor. Después, con el primer período de duplicación, el atractor se partió en dos como una célula que se divide. Al pronto, aquellos dos puntos estuvieron casi juntos; luego, al aumentar el parámetro, flotaron aparte. Más tarde, hubo otro período de duplicación: cada punto del atractor se dividió de nuevo, en el mismo momento. Su número permitió a Feigenbaum predecir cuándo sucedería el período de duplicación. Descubrió entonces que podía también vaticinar los valores precisos de cada punto en aquel atractor, cada vez más complejo: dos puntos, cuatro, ocho… Le era posible adivinar las poblaciones que aparecían en las oscilaciones de un año a otro. Había otra convergencia geométrica. Aquellas cifras obedecían también a una ley escalar.
Feigenbaum exploraba un campo intermedio olvidado entre las matemáticas y la física. ¿Cómo definir su trabajo? No se trataba de ciencias exactas, pues no demostraba nada. Desde luego, exploraba números, pero los números son para el matemático lo que una bolsa de monedas para el banquero dedicado a las inversiones: en principio, la sustancia de su profesión, pero, en realidad, demasiado engorrosos y especiales para gastar tiempo en ellos. Las ideas son las monedas en curso de los matemáticos. Feigenbaum cumplía un programa de física y, por extraño que fuese, era casi una faceta de la física experimental.
Los números y funciones representaban el objeto de su estudio, en vez de mesones y quarks. Poseían trayectorias y órbitas. Había de penetrar en su comportamiento. Necesitaba —la expresión llegaría a ser un tópico de la nueva ciencia— crear intuición. El ordenador era su acelerador y su cámara de niebla. Forjaba una metodología al mismo tiempo que una teoría. Por lo común, quien empleaba un ordenador planteaba un problema, lo alimentaba con él y guardaba a que la máquina calculase la solución: un problema, una solución. Feigenbaum y los investigadores del caos que le siguieron exigían más. Tenían que hacer lo mismo que Lorenz, a saber, formar universos en miniatura y observar su evolución. Podían modificar este o aquel rasgo, y ver qué caminos distintos resultarían. Estaban convencidos de que, los cambios imperceptibles de ciertos rasgos llevaban a alteraciones de bulto del comportamiento general.
Feigenbaum averiguó en seguida lo inconveniente del equipo de ordenadores de Los Álamos para la clase de cálculo que deseaba efectuar. No obstante la enormidad de sus recursos, muy superiores a los de casi todas las universidades, Los Álamos disponía de escasos terminales capaces de mostrar gráficas e imágenes, y ésos pertenecían a la Sección de Armamento. Feigenbaum quería representar los números como puntos en un mapa. Tuvo que recurrir al método más primitivo: largos rollos de papel con líneas marcadas por hileras de espacios de la impresora, seguidas de un asterisco o del símbolo de la suma. La creencia oficial de Los Álamos pretendía que un ordenador grande valía más que muchos pequeños, creencia que andaba del brazo con la tradición de un problema, una solución. Se desaprobaban los ordenadores pequeños. Por otra parte, cualquier compra divisional de uno habría chocado con rigurosas normas gubernamentales y una inspección formal. Sólo más tarde, con la complicidad presupuestaria de la Sección Teórica, Feigenbaum recibió un «ordenador de mesa» de veinte mil dólares. Con él modificó sus ecuaciones e imágenes sobre la marcha, retocándolas y afinándolas, como si el ordenador fuera un instrumento musical. Por entonces, los únicos terminales idóneos para realizar gráficas importantes se hallaban en lugares de alta seguridad, detrás de la valla, como se decía en Los Álamos. A causa de ello hubo de emplear un terminal conectado por línea telefónica con un ordenador central.
Trabajar de aquella forma impedía apreciar en toda su extensión la potencia neta de la máquina situada al otro extremo del cable. Hasta las operaciones más sencillas tardaban minutos en verificarse. Editar una línea de un programa obligaba a oprimir la tecla de Retorno o Nueva línea, y a esperar, mientras el terminal zumbaba incesantemente y el ordenador central atendía a las peticiones de otros usuarios del laboratorio.
Feigenbaum pensaba mientras usaba el ordenador. ¿Qué expresión matemática adoptarían las múltiples pautas escalares que observaba? Algo en aquellas funciones debía de ser recurrente, se dijo, debía de autorelacionarse, el comportamiento de una guiarse por el comportamiento de otra, oculta en su interior. La imagen ondulada que había tenido en un instante de inspiración manifestaba algo sobre cómo una función podía disponerse en una escala para ajustarse a otra. Aplicó el procedimiento matemático de la teoría de re normalización de grupo, que recurre a las escalas para reducir los infinitos a cantidades manejables. En la primavera de 1976, su existencia adquirió intensidad superior a la que había conocido hasta entonces. Se concentraba como si estuviera en trance, programaba con furia, garabateaba con el lápiz y volvía a programar. No tenía el recurso de telefonear a la Sección C, porque habría tenido que interrumpir el funcionamiento del ordenador para emplear el teléfono, y el restablecimiento de la conexión era incierto. Si se detenía a pensar más de cinco minutos, el ordenador desconectaría automáticamente su línea. De todas suertes, hacía alto con relativa frecuencia, lo que le dejaba temblando a causa de la sobrecarga de adrenalina. Se esforzó sin respiro durante dos meses. Su jornada era de veintidós horas. Intentaba dormir como si fuera una pausa breve, y se despertaba ciento veinte minutos más tarde con los pensamientos esperándole exactamente donde los había interrumpido. Su dieta estricta consistía en café. (En ocasiones más saludables y apacibles, Feigenbaum se nutría sólo de carne muy poco hecha, café y vino tinto. Sus amigos sospechaban que obtenía vitaminas de los cigarrillos).
Por último, un médico cortó por lo sano aquel régimen de vida. Le recetó moderadas dosis de válium y vacaciones. Pero Feigenbaum ya había creado una teoría universal.
§. Cartas de rechazo
La universalidad estableció la diferencia entre lo bello y lo útil. Los matemáticos, pasado cierto punto, se despreocupan de proporcionar una técnica para los cálculos. Los físicos, pasado cierto punto, requieren números. La universalidad prometía que los físicos, habiendo solventado un problema fácil, conseguirían resolver otros mucho más difíciles. La respuesta sería la misma. Además, al situar su teoría dentro del marco de la re normalización, Feigenbaum le daba un aspecto que los físicos reconocerían como instrumento de cálculo, casi como norma.
Con todo, aquello que hacía útil a la universalidad era lo mismo en que los físicos apenas podían creer. La universalidad significaba que sistemas diferentes se portarían de manera idéntica. Desde luego, Feigenbaum estudiaba sólo funciones numéricas simples. Pero estaba convencido de que su teoría expresaba una ley natural sobre sistemas en el punto de transición del orden a la turbulencia. Todo el mundo sabía que la última denotaba un espectro continuo de frecuencias distintas, y se había preguntado de dónde procedían éstas. De repente se veía que llegaban en secuencias. La inferencia física era que los sistemas reales se comportarían de la misma manera reconocible, y que, también, serían igualmente mensurables. La universalidad de Feigenbaum era no sólo cualitativa, sino cuantitativa; no sólo estructural, sino métrica. Abarcaba números precisos, además de pautas. Aquello, para un físico, era abusar de la credulidad.
Años después Feigenbaum guardaba aún en un cajón del escritorio, donde podía encontrarlas en un santiamén, las cartas de rechazo.
Entonces disfrutaba de todo el reconocimiento que anhelaba. Su trabajo en Los Álamos había recibido premios y honores, y con ellos, prestigio y dinero. No obstante, todavía le escocía que los directores de las principales revistas académicas hubiesen juzgado su obra impropia para ser publicada a los dos años de haber empezado a ofrecerla. La idea de un descubrimiento científico tan original e inesperado, que no admite ser publicado, parece un mito trasnochado. Se supone que la ciencia moderna, con su gran caudal de información y su sistema imparcial de críticas cuidadosas, no incurre en exquisiteces de paladar. Un director, que devolvió el original a Feigenbaum, reconoció tiempo después haber rechazado un artículo que señalaba un punto decisivo en la especialidad; sin embargo, se excusó diciendo que era inadecuado para sus lectores, dedicados a las matemáticas aplicadas. Mientras tanto, bien que no se hubiese publicado, el hallazgo de Feigenbaum se convirtió en noticia candente en algunos círculos de matemáticos y físicos. El núcleo de la teoría se propagó como suele ocurrir en la mayor parte de la ciencia actual: gracias a conferencias y resúmenes previos de ellas. Feigenbaum describió su obra en disertaciones y recibió peticiones de fotocopias de sus artículos, primero a docenas y luego a centenares.
§. Reunión en Como
La economía moderna se fía por entero de la teoría eficiente del mercado. Se da por sentado que el conocimiento discurre sin trabas de un lugar a otro. Quienes toman decisiones importantes, así se cree, tienen acceso, más o menos, a la misma masa de información. Hay aquí y allí, como es de suponer, rincones de ignorancia o de información incompartida; pero, en conjunto, los economistas imaginan que, una vez que se ha hecho público, el conocimiento se halla por doquier. Los historiadores de la ciencia dan a menudo por sabida una teoría eficiente del mercado de su propia cosecha. Cuando se descubre algo, cuando se expresa una idea, se piensa que es propiedad común del mundo científico. Cada hallazgo y cada noción nuevos arraigan en los anteriores. La ciencia crece como un edificio, ladrillo a ladrillo. Desde el punto de vista práctico, las crónicas intelectuales pueden ser lineales.
Esta concepción de la ciencia surte más efecto cuando una disciplina bien definida espera la solución de un problema bien definido. Nadie interpretó mal el descubrimiento de la estructura molecular del ADN, por ejemplo. Con todo, la historia de las ideas no es siempre tan segura. Al despuntar la ciencia no lineal en rincones extraños de las diferentes disciplinas, la corriente de ideas no siguió la lógica típica de los historiadores. La aparición del caos como entidad propia fue cuestión no solamente de teorías y descubrimientos insospechados, sino también de la comprensión tardía de viejas ideas. Hacía mucho tiempo que se habían visto numerosas piezas del rompecabezas —por Poincaré, por Maxwell y hasta por Einstein—, que luego se olvidaron. Los matemáticos comprenden un descubrimiento matemático, los físicos uno físico y nadie uno meteorológico. Cómo se propagaban las ideas llegó a ser tan esencial como la manera en que se originaban.
Cada científico poseía una constelación propia de padres intelectuales. Cada uno tenía una imagen privada del panorama de las ideas, y cada imagen era limitada de forma personal. El conocimiento adolecía de imperfecto. En el científico influían las costumbres de sus disciplinas o las trayectorias accidentales de su educación individual. El mundo de la ciencia se hizo asombrosamente finito. No fue una comisión la que guió la historia científica a una vía nueva, sino un puñado de personas, de percepciones y de metas individuales.
Posteriormente, se definió un consenso sobre qué innovaciones y contribuciones habían influido más. El consenso, sin embargo, incluyó cierto revisionismo. En la agitación de los descubrimientos, sobre todo en la última parte de la década de 1970, no hubo dos físicos o dos matemáticos que entendieran el caos de modo idéntico. El científico acostumbrado a los sistemas clásicos, libres de fricción o de disipación, se incorporaría a una estirpe descendiente de rusos como A. N. Kolmogorov y V. I. Arnold. El matemático habituado a los sistemas dinámicos clásicos elegiría un linaje que iba desde Poincaré a Birkhoff, Levinson y Smale. Más tarde, el olimpo de un cultivador de las ciencias exactas se centraría en Smale, Guckenheimer y Ruelle. O preferiría precursores partidarios de los ordenadores y asociado con Los Álamos: Ulam, Metropolis y Stein. Un físico teórico muy bien podría escoger a Ruelle, Lorenz, Rössler y Yorke. Un biólogo pensaría en Smale, Guckenheimer, May y Yorke. Un científico que estudiase la Tierra —un geólogo o sismólogo— reconocería la influencia directa de Mandelbrot; un físico teórico raras veces conocería tal apellido.
El papel de Feigenbaum sería fuente de controversia especial. Pasado mucho tiempo, cuando se había transformado en semi celebridad, hubo físicos que se desvivieron por citar a otras personas, las cuales, según ellos, lidiaban con el mismo problema en la misma fecha, año más o año menos. Algunos le acusaron de haberse concentrado, con escasa amplitud de miras, en un mínimo fragmento del vasto espectro del comportamiento caótico. La «feigenbaumología» se valoraba en exceso, dijo un físico; era un buen trabajo, desde luego, pero no tan influyente, por ejemplo, como el de Yorke. Invitaron a Feigenbaum en 1984 a hablar en el Simposio Nobel, en Suecia, en el que rugió la polémica. Benoît Mandelbrot pronunció una charla de mordacidad intencionada que el auditorio describió como su «conferencia anti Feigenbaum». Mandelbrot había desempolvado, no se sabía cómo, un artículo sobre la duplicación de período que había publicado veinte años antes Myrberg, matemático finlandés, e insistió en llamar «secuencias de Myrberg» a las de Feigenbaum.
Éste, sin embargo, había descubierto la universalidad e ideado una teoría para explicarla. Era el eje alrededor del cual giraba la nueva ciencia. Incapaz de propagar la letra impresa resultado tan asombroso y contraintuitivo, lo hizo público en una serie de exposiciones orales: en una reunión celebrada en New Hampshire, en el mes de agosto de 1976; en un congreso internacional de matemáticas, que tuvo efecto en Los Álamos en septiembre; y en charlas dadas en la Universidad de Brown, en noviembre. El hallazgo y la teoría fueron acogidos con sorpresa, incredulidad y excitación. Cuanto más reflexionaba un físico sobre la no linealidad, tanto más percibía la fuerza de la universalidad de Feigenbaum.
—Fue un descubrimiento muy feliz y desconcertante enterarse de que había en los sistemas no lineales estructuras siempre iguales, si se consideraban adecuadamente —confesó uno sin reservas.
Algunos recogieron no sólo las ideas, sino las técnicas. Les ponía la piel de gallina jugar —únicamente jugar— con aquellos mapas. Gracias a sus ordenadores, experimentaban el asombro y la satisfacción que habían sostenido a Feigenbaum en Los Álamos. Y refinaron la teoría. Tras oír su charla en el Institute for Advanced Study, en Princeton, Predrag Cvitanović, físico de las partículas, le ayudó a simplificar la teoría y ampliar la universalidad. En el ínterin, Cvitanović simuló que era un pasatiempo; no osaba admitir ante sus colegas lo que hacía.
La actitud de reserva prevaleció también entre los matemáticos, sobre todo porque Feigenbaum no aportaba pruebas precisas. Hubo que esperar a 1979 para que las hubiese en términos de las ciencias exactas, y ello se debió a Oscar E. Lanford III. Feigenbaum evocaba a menudo la presentación de su teoría a un auditorio selecto, durante el congreso de Los Álamos del mes de septiembre. Apenas comenzó a describir el trabajo, se puso en pie el eminente matemático Mark Kac.
—Caballero, ¿nos ofrecerá operaciones numéricas o una prueba? —inquirió.
Más que lo primero y menos que lo segundo, repuso Feigenbaum.
— ¿Es lo que un hombre razonable llamaría prueba?
Feigenbaum contestó que los presentes habrían de sacar conclusiones propias. Cuando hubo terminado, interpeló a Kac, quien contestó arrastrando sardónicamente la r:
—Sí, es una prueba para alguien razonable. De los detalles pueden encargarse los matemáticos r-r-rigurosos.
El descubrimiento de la universalidad impulsó el movimiento recién nacido. Los físicos Joseph Ford y Giulio Casati organizaron, en el estío de 1977, el primer congreso de una ciencia llamada caos. Se celebró en una atractiva villa de la pequeña ciudad italiana de Como, en la parte meridional del lago del mismo nombre, cuenca indescriptiblemente azul que recoge las aguas de la fusión de la nieve de los Alpes de Italia. Asistieron a ella cien personas, en su mayor parte físicos, aunque también hubo especialistas en otras ciencias, llenos de curiosidad. —Mitch había visto la universalidad, descubierto la forma en que se disponía en escalas e inventado un procedimiento, intuitivamente tentador, de alcanzar el caos —explicó Ford—. Poseíamos, por primera vez, un modelo claro que todo el mundo entendía. Y era de esas cosas a las que llega la sazón. Desde la astronomía a la zoología, la gente hacía algo por el estilo y lo publicaba en revistas muy especializadas, sin enterarse de que otras personas se preocupaban por materias análogas. Creían estar solos, y se les tenía por algo excéntricos en sus disciplinas. Habían agotado las preguntas sencillas, y empezado a dedicarse a fenómenos un poco más complicados. Y todos derramaron lágrimas de agradecimiento al enterarse de que muchos otros se habían metido en lo mismo.
§. Nubes y pinturas
Feigenbaum vivió después en un lugar austero, con la cama en una habitación, el ordenador en otra y tres torres electrónicas negras para tocar su colección de discos, declaradamente germánica, en la tercera. Su único intento de amueblar la casa, la compra de una cara mesita de mármol en Italia, acabó en fracaso, pues recibió una caja de fragmentos de mármol. Montones de papeles y libros tapizaban las paredes. Hablaba con rapidez, con la larga melena castaña salpicada de canas peinada hacia atrás.
—Algo dramático sucedió en los años veinte. Sin razón justificativa, los físicos toparon con una descripción, correcta en esencia, del mundo que los rodeaba, puesto que la teoría de la mecánica cuántica lo es. Explica cómo pueden hacerse ordenadores con tierra. Así aprendimos a manipular nuestro universo. Así se fabrican productos químicos, los plásticos y el resto. Uno sabe calcular con ella. Es sobremanera buena, con el defecto de que, a cierto nivel, carece de sentido.
»Falta una parte de las imágenes. Si se quiere saber qué significan en realidad las ecuaciones, y qué descripción del mundo está de acuerdo con esa teoría, la respuesta no proporciona algo vinculado con nuestra intuición del mundo. No podemos concebir una partícula moviéndose como si tuviera una trayectoria. No se nos permite visualizarla de ese modo. Y si nos ponemos a preguntar cosas cada vez más sutiles — ¿qué nos cuenta la teoría del aspecto del mundo?—, al final estamos tan lejos de la forma ordinaria de imaginar lo que nos rodea, que nos exponemos a toda clase de conflictos. Quizá sea el mundo realmente así. Pero no sabemos, en el fondo, que no haya otra manera de reunir toda esa información, una manera que no imponga desvío tan radical de nuestro procedimiento de intuir las cosas.
»Un supuesto fundamental de la física consiste en que, para comprender el mundo, debemos aislar sus partes componentes hasta que nos cercioremos de que es verdaderamente básico aquello en lo que pensamos. Presumimos a continuación que lo que no entendemos son detalles. El presupuesto consiste en dar por seguro que hay una cantidad reducida de principios, y que los discernimos al observar los objetos en estado puro —es el auténtico modo de ver analítico—, y después nos las ingeniamos para juntarlos de forma mucho más complicada, para resolver problemas de menor monta. Si podemos.
»Por último, hay que utilizar el cambio de marchas. Debemos revisar nuestra concepción de los hechos importantes. Podríamos simular un sistema fluido en un ordenador, lo que empieza a ser posible. Pero sería un esfuerzo vano, pues lo que pasa en realidad no tiene relación con un fluido o una ecuación. Es una descripción general de lo que acontece, en una rica variedad de sistemas, cuando las cosas obran sobre sí mismas una y otra vez. Hay que pensar en el problema de otra manera.
»Cuando miran esta habitación —se ven trastos ahí, una persona sentada acá y puertas allí—, creen que observan los principios de la materia y escriben las funciones ondulatorias para representarlos. Pues bien, eso no es factible. Tal vez Dios pueda hacerlo, pero no existe pensamiento analítico para entender semejante problema.
»No es ya retórico preguntar qué pasará a una nube. La gente está muy interesada en saberlo, y eso denota que hay dinero para efectuar la investigación. El problema encaja en el reino de la física, y tiene el mismo calibre que los demás. Se observa algo complicado, y se resuelve en la actualidad buscando todos los indicios posibles, bastantes para decir dónde está la nube, la temperatura del aire, la velocidad aérea, etc. Se mete todo ello en el ordenador más potente que se pueda y se procura obtener una idea de lo que hará a renglón seguido. Pero eso no es muy realista.
Feigenbaum aplastó la colilla en el cenicero y encendió otro cigarrillo.
—Se han de buscar otros procedimientos. Se deben encontrar estructuras escalares: cómo se relacionan los grandes detalles con los pequeños. Se observan perturbaciones fluidas, estructuras complicadas, cuya complejidad se deriva de un proceso persistente. En algún nivel, no les importa la magnitud del proceso, sea del tamaño de un guisante, sea de la dimensión de una pelota del baloncesto. Y no afecta al proceso su situación, ni tampoco su duración. Las cosas escalares son lo único que llega a ser, en algún sentido, universal.
»Hasta cierto punto, el arte es una teoría sobre el mundo tal como aparece a los seres humanos. Es evidente hasta la saciedad que nadie conoce al dedillo el mundo que le rodea. Los artistas han comprendido que sólo interesa una reducida cantidad de sustancia, y después han comprobado qué era. Por ello, pueden efectuar algo de esa investigación en mi lugar. En las obras de Van Gogh hay millones de detalles, y por eso sus pinturas encierran una inmensa suma de información. Desde luego, se le ocurrió pensar en la cantidad irreducible de materia que habría de plasmar. O pueden estudiarse los horizontes de los dibujos de tinta holandeses, en torno al 1600, con arbolitos y vacas diminutos, que se antojan reales. Vistos de cerca, los árboles poseen una especie de límites hojosos, pero no causarían efecto si se redujeran a eso; hay también pedacitos de materia semejantes a ramas. Existe una interrelación definida entre las texturas más suaves y los objetos de líneas más acusadas. Esa correlación proporciona, por alguna razón, la percepción correcta. Si se examina cómo Ruysdael y Turner construyen la complejidad del agua, se nota que lo hacen iterativamente. Hay un nivel de materia, y luego la pintada sobre ella, y después las correcciones de ésta. Para esos pintores los fluidos turbulentos son siempre algo que encierra la idea de escala.
»Ansío saber describir las nubes. Pero tengo por erróneo decir que acá hay un pedazo de esta densidad, y allá otro de aquélla, y, además, acumular tanta información detallada. Los seres humanos, desde luego, no perciben así las cosas, ni tampoco los artistas. En algún punto, la tarea de escribir ecuaciones diferenciales parciales no significa haber trabajado en el problema.
»En cierto modo, la promesa portentosa de la Tierra reside en que hay en ella cosas bellas, cosas maravillosas y seductoras, y que, a causa de nuestra profesión, anhelamos entenderlas.
Feigenbaum dejó el cigarrillo. El humo se elevó del cenicero, primero en una columna fina, y después (como amable inclinación de cabeza destinada a la universalidad) en zarcillos inconexos que se retorcieron hacia el techo.
Es experiencia sin parangón con otras que pudiera escribir, lo mejor que puede acontecer a un científico, comprobar que algo ocurrido en su mente corresponde punto por punto a algo que ocurre en la naturaleza. Sobresalta siempre que sucede. Asombra que una criatura de la mente de uno goce de vida en el honrado y limpio mundo exterior. Una gran impresión, y una grande, grandísima alegría.
LEO KADANOFF
§. Helio en una cajita§. Helio en una cajita
§. «Ondulación asólida de lo sólido»
§. Flujo y formas en la naturaleza
§. El delicado triunfo de Albert Libchaber
§. El experimento se junta a la teoría
§. De una dimensión a muchísimas
—Albert está madurando.
Tal cosa dijeron en la École Normale Supérieure, institución que ocupa, con la École Polytechnique, la cima de la jerarquía didáctica de Francia. Pensaron que la edad empezaba a surtir efecto en Albert Libchaber, quien había conquistado fama como físico de bajas temperaturas, estudiando el comportamiento cuántico del helio superfluido a un pelo de distancia del cero absoluto. Y entonces, en 1977, dispendiaba su tiempo y los recursos de la entidad en un experimento aparentemente fútil. El mismo Libchaber, temeroso de malbaratar la carrera de cualquier estudiante graduado empleándole en el proyecto, buscó la colaboración de un ingeniero profesional.
Libchaber nació en París un lustro antes de que los nazis ocupasen la metrópolis. Era hijo de un judío polaco y nieto de un rabino. Sobrevivió con el mismo método que había salvado a Benoît Mandelbrot. Se refugió en el campo, lejos de sus progenitores, cuyo acento era demasiado acusador. Sus padres consiguieron burlar la muerte; el resto de la familia pereció a manos de los invasores. Por capricho de la casualidad política, Libchaber conservó la vida gracias a la protección de un jefe local de la policía secreta de Pétain, cuyas fervientes creencias derechistas sólo admitían comparación con su ferviente antirracismo. Terminada la contienda, el niño de diez años le devolvió el favor. Atestiguó, comprendiendo sólo a medias la importancia de su declaración, ante la comisión de crímenes de guerra, y su testimonio salvó a su protector.
En su recorrido de la escala de la ciencia académica francesa, Libchaber progresó en su profesión sin que jamás se discutiera su valía. Sus colegas pensaron en ocasiones que estaba algo chiflado: un judío místico entre racionalistas, un gaullista en un ambiente científico de mayoría comunista. Le embromaron por su teoría del Gran Hombre en la historia, pasión por Goethe y su obsesión por los libros antiguos. Tenía centenares de ediciones originales de obras de ciencia, algunas de las cuales se remontaban a los años iniciales del siglo XVII. Los leía no como curiosidades, sino como fuente de ideas frescas sobre la naturaleza de la realidad, la misma que sondaba con sus láseres y sus refinadísimos serpentines de refrigeración. Había encontrado en el ingeniero Jean Maurer un alma gemela, un francés que trabajaba sólo cuando tenía ganas de hacerlo. Libchaber creyó que Maurer encontraría divertido su proyecto, moderado eufemismo de lo intrigante, emocionante o profundo. Los dos emprendieron en 1977 un experimento destinado a revelar el inicio de la turbulencia.
Libchaber era famoso como experimentador por su estilo propio del siglo XIX: mente despierta, manos ágiles y preferencia por lo ingenioso y no por la actividad bruta. Le repugnaban la tecnología colosal y el empleo excesivo del ordenador. Su concepto de un buen experimento era como el de un matemático de una buena prueba. La elegancia importaba tanto como los resultados. Incluso así, algunos colegas pensaron que llevaba las cosas demasiado lejos en aquel caso. El montaje del experimento era tan pequeño, que podía meterlo en una caja de cerillas. En ocasiones, lo transportaba como muestra de arte conceptual. Lo llamaba «helio en una cajita». El corazón del experimento era todavía más minúsculo, una celdilla del tamaño de una pepita de limón, cincelada en acero inoxidable, de bordes y caras delgadísimos. En ella introducían helio líquido a una temperatura que distaba alrededor de cuatro grados de la del cero absoluto, la cual resultaba elevada en comparación con sus anteriores experimentos sobre los superfluidos.
El laboratorio ocupaba el segundo piso del edificio de física de la École, en París, a unos centenares de metros del viejo lugar de trabajo de Louis Pasteur. Como todos los de uso general, el de Libchaber se hallaba en estado de desorden constante, con el pavimento y las mesas cubiertas de latas de pintura y herramientas manuales, y con retazos de material plástico y metálico diseminados por todos los lugares. En medio de la confusión, el aparato que albergaba la diminuta celdilla era una chocante exhibición de finalidad. Tenía una lámina inferior, como base, de cobre de gran pureza, y otra, como tapa, de cristal de zafiro. Los materiales se habían elegido atendiendo a su capacidad conductora de calor. Había minúsculos serpentines de calefacción y rellenos teflón. El helio líquido descendía de un depósito, un dado de ciento veinticinco milímetros. Todo ocupaba un recipiente mantenido en el vacío más riguroso, que se hallaba en un baño de nitrógeno líquido con el cual se estabilizaba la temperatura.
Las vibraciones preocuparon siempre a Libchaber. Los experimentos, como los verdaderos sistemas no lineales, existían sobre un fondo de alteraciones incesantes que entorpecían las medidas y corrompían los datos. Como todos los flujos sensibles —y el de Libchaber lo sería tanto como le fuese posible—, uno no lineal se exponía a sufrir notables alteraciones, que podrían llevar de un comportamiento a otro. Pero la no linealidad tanto desestabiliza un sistema como lo estabiliza. La realimentación no lineal regula el movimiento y lo robustece. Cualquier perturbación tiene efecto constante en un sistema lineal. En presencia de la no linealidad, se alimenta a expensas de sí misma, hasta que se extingue y el sistema vuelve automáticamente al estado estable. Libchaber creía que los sistemas empleaban su no linealidad para defenderse de las alteraciones. La transferencia de energía por las proteínas, el movimiento ondulatorio de la electricidad cardíaca, el sistema nervioso, todos mantenían su versatilidad en un mundo de perturbaciones. Libchaber tenía la esperanza de que la estructura, fuera cual fuese, subyacente al flujo del fluido poseería fuerza suficiente para captarla en su experimento.

«Helio en una cajita».
El delicado experimento de Albert Libchaber: su corazón era una celdilla rectangular, primorosamente construida, que contenía helio líquido; diminutos «bolómetros» de zafiro medían la temperatura del fluido. La minúscula celda estaba en el interior de una envoltura, que debía protegerla del ruido y la vibración, y permitir la regulación precisa del calentamiento.
Libchaber sabía qué experimentos estadounidenses y franceses habían debilitado la idea de Landau sobre el inicio de la turbulencia, mostrando que se presentaba en una transición súbita, y no a causa de una acumulación de frecuencias diferentes. Experimentadores como Jerry Gollub y Harry Swinney, con su flujo en un cilindro rotatorio, habían demostrado que se necesitaba una nueva teoría, pero no habían percibido con claridad la transición al caos. Libchaber estaba al corriente de que en los laboratorios no se había obtenido una imagen diáfana del comienzo de la turbulencia, y había decidido que su minúscula celdilla con un fluido proporcionase una de la mayor claridad posible.
§. «Ondulación asólida de lo sólido»
Una reducción de la visión mantiene la ciencia en movimiento. Según sus luces, quienes estudiaban la dinámica de los fluidos tenían derecho a dudar del alto nivel de precisión que, como pretendían, habían alcanzado en un flujo de Cuette-Taylor. Según las suyas, los matemáticos tenían derecho a irritarse, como lo hacían, con Ruelle. Había quebrantado las reglas. Había propuesto una ambiciosa teoría física con el disfraz de formulación matemática estricta. Había complicado la tarea de distinguir lo que presumía de lo que probaba. El matemático que se niega a sancionar una idea, hasta que cumpla la regla de teorema, prueba, teorema, prueba, representa el papel que su disciplina ha escrito para él: monta guardia contra la impostura y el misticismo, conscientemente o no. Cree guardar el bastión, en nombre de sus colegas aceptados, el director de revista que rechaza las ideas desconocidas y manifestadas en estilo desacostumbrado, y lo mismo piensan sus víctimas; pero también él representa un papel en una comunidad que tiene razones suficientes para mostrarse cauta con lo indemostrado. «La ciencia se edificó contra un montón de majaderías», decía el propio Libchaber. Cuando sus colegas le tildaban de místico, el epíteto no tenía siempre intención afectuosa.
Como experimentador era prudente y disciplinado, y célebre por la precisión con que sondeaba la materia. Pero le apasionaba aquella cosa abstracta, mal definida, fantasmal, llamada flujo. Era forma más cambio, movimiento más figura. Un físico, al concebir sistemas de ecuaciones diferenciales, daría ese nombre a su movimiento matemático. El flujo era una idea platónica, pues suponía que el cambio en sistemas reflejaba una realidad independiente del instante preciso. Libchaber abrazó la presunción de Platón de que las formas ocultas llenan el universo.
— ¡Claro que se sabe que es así! Todos hemos visto hojas. Cuando miramos todas las hojas, ¿no nos choca el hecho de que sea reducido el número de figuras genéricas? No costaría dibujar la forma matriz. Tendría interés tratar de entender eso. U otras figuras. Se ha visto en experimentos que un líquido penetra en otro.
Su escritorio estaba lleno de imágenes de aquellos experimentos, gruesos dedos fractales líquidos.
—Pues bien, si usted enciende el gas de su cocina, notará que la llama tiene esa forma. Es muy esencial. Universal. Me tiene sin cuidado lo que sea —llama, líquido en líquido o cristal sólido que crece—, porque es esa figura lo que me interesa. Desde el siglo XVIII, hubo una especie de sueño en que la ciencia perdía la evolución de la forma en el espacio y el tiempo. Si piensa usted en un flujo, puede hacerlo de múltiples maneras, en la economía o en la historia, por ejemplo. Primero será laminar, luego se bifurcará en un estado más complicado, acaso con oscilaciones, y acabará siendo caótico.
La universalidad de las figuras, las semejanzas a lo largo de las escalas y la potencia recursiva de flujos dentro de flujos, todo ello se encontraba al alcance del cálculo diferencial clásico para las ecuaciones de cambio. Pero no era cosa que se viese con facilidad. Los problemas científicos se expresan en el léxico de que dispone la ciencia. Hasta aquel momento, el mejor modo del siglo XX de expresar la intuición de Libchaber sobre el flujo consistía en recurrir al lenguaje poético. Wallace Stevens, entre otros, manifestó una percepción del mundo que se anticipó al conocimiento de los físicos. Tuvo una impresión misteriosa sobre el flujo, sobre cómo se repetía mientras cambiaba:
El río manchado de luzLa poesía de Stevens provoca a menudo una visión de tumulto en el aire y el agua. Y también la fe en las formas invisibles del orden en la naturaleza, la creencia de
Que fluía sin cese y jamás
de manera igual, que fluía
Por muchos lugares, como
si estuviera quieto en uno solo.
Que, en la atmósfera sin sombras,Cuando, en el decenio de 1970, examinaron el movimiento de los fluidos, Libchaber y otros experimentadores lo hicieron con algo que se aproximaba a aquella subversiva intención poética. Barruntaron una relación entre el movimiento y la forma universal. Acumularon datos con el único método posible, escribiendo números o registrándolos en un ordenador digital. Buscaron, en cambio, procedimientos para organizarlos de modo que revelasen sus formas. Tenían la esperanza de expresarlas en términos de movimiento. Estaban convencidos de que las dinámicas, como las llamas, y las orgánicas, como las hojas, debían su aspecto a una textura de fuerzas aún no bien entendida. Aquellos experimentadores, los que acosaron al caos implacablemente, triunfaron por negarse a aceptar que una realidad inmovilizara. Ni siquiera Libchaber se habría atrevido a manifestarlo de tal manera, pero sus concepciones se acercaban mucho a lo que Stevens sentía como «ondulación asólida de lo sólido»:
El conocimiento de las
cosas existe, aunque
inadvertido.
El vigor glorioso, esplendor en las venas,§. Flujo y formas en la naturaleza
Cuando las cosas brotaron
y movieron y se disolvieron,
O en la distancia, o en el cambio o en la nada,
Las visibles transformaciones de la noche estival,
Una forma que se acerca
como abstracción argéntea
Y que se hace de pronto
esquiva, huyendo a lo lejos.
Libchaber obtuvo inspiración mística de Goethe, no de Stevens. Mientras Feigenbaum buscaba la Teoría de los colores goethiana en la biblioteca de Harvard, Libchaber había logrado ya sumar a su colección un ejemplar de la edición original de una monografía, todavía más oscura: Sobre la transformación de las plantas. Era el ataque lateral de Goethe a los físicos que, creía, se preocupaban de los fenómenos estáticos más que de las fuerzas y los flujos vitales productores de las formas que vemos de un instante a otro. Parte del legado goethiano —prescindible, desde el punto de vista de los historiadores de la literatura— era una prole seudocientífica, en Alemania y Suiza, que mantenían viva filósofos tales como Rudolf Steiner y Theodor Schwenk. Libchaber también los admiraba con la pasión de que un físico era capaz.
«Caos sensible» —Das sensible Chaos— fue la expresión que empleó Schwenk para denotar la relación entre fuerza y forma. Sirvió de título a un librito extraño, publicado en 1965, cuyas ediciones se agotaron esporádicamente. Versaba en especial sobre el agua. La edición inglesa ostentó un prefacio admirativo del comandante Jacques Y. Cousteau, así como testimonios de admiración del Water Resources Bulletin y el Journal of the Institute of Water Engineers. La exposición de Schwenk apenas tenía aspiraciones científicas, y ninguna matemática. No obstante, sus observaciones eran intachables. Exponía multitud de fluidas figuras naturales y docenas de dibujos precisos, como los esbozos del biólogo celular que usa por primera vez el microscopio. Poseía una amplitud mental y una ingenuidad que habrían llenado de satisfacción a Goethe.
Los flujos llenan sus páginas. Grandes ríos como el Mississippi y la cuenca de Arcachon, en Francia, describen amplias curvas hacia el mar. En éste, la corriente del Golfo serpea hacia el este y el oeste. Es un gigantesco río de agua cálida en el seno de la fría, como dijo Schwenk, uno que «crea riberas propias en la linfa de temperatura más baja». Aunque desaparezca o sea invisible, persiste la huella del flujo. Ríos de aire dejan su marca en la arena del desierto, mostrando sus ondas. El flujo de la bajamar inscribe una red de venas en la playa. Schwenk no creía en las coincidencias, sino en principios universales, y más que en la universalidad, en cierto espíritu de la naturaleza, lo que hizo su prosa antropomórfica hasta extremos molestos. Su «principio arquetípico» era que el flujo «ansía realizarse haciendo caso omiso de la materia circunstante».

Flujos serpeantes y en espiral.
Theodor Schwenk describió las corrientes de flujos naturales como fibras a las que complican movimientos secundarios. «No son simples ramales —escribió—, sino superficies enteras que se entremezclan espacialmente».

Gotas que descienden.
D’Arcy Wentworth Thompson mostró los hilos y columnas colgantes de gotas de tinta que descienden en el agua (izquierda) y la configuración de una medusa (derecha). «Un resultado curiosísimo… es cuán sensibles estas… gotas son a las condiciones físicas. Usando siempre la misma gelatina, y variando sólo una milésima la densidad del fluido, obtenemos un cúmulo de aspectos, desde la gota corriente a la misma con rebordes…».
La vida era la especialidad de D’Arcy Wentworth Thompson. Este extraordinario naturalista escribió en 1917: «Pudiera ser que todas las leyes de la energía, todas las propiedades de la materia, y toda la química de todos los coloides, fuesen tan impotentes para explicar el cuerpo como lo son para comprender el alma. Por mi parte, no creo que sea así». D’Arcy Thompson aportó al estudio de la vida precisamente lo que Schwenk, por desgracia, carecía: las matemáticas. Schwenk argumentaba por analogía. Su tesis —espiritual, florida, enciclopédica— concluyó en un despliegue de semejanzas. La obra maestra de D’Arcy Thompson, On Growth and Form (Sobre el desarrollo y la forma), compartió algo del talante y el método de Schwenk. El lector moderno se pregunta cuánto crédito ha de conceder a las meticulosas imágenes de gotitas de líquido que caen dividiéndose en púas múltiples, pendientes de rabillos sinuosos, que se muestran junto a medusas vivas, asombrosamente similares. ¿Es sólo un caso de coincidencia rebuscada? Si dos formas se parecen, ¿se deben buscar causas parecidas?
D’Arcy Thompson aparece sin duda alguna como el biólogo más influyente que pisó los bordes de la ciencia legítima. La revolución biológica del siglo XX, que sobrevino durante su existencia, no le afectó. Desdeñó la química, no comprendió la célula y no soñó siquiera en el desarrollo explosivo de la genética. Sus escritos fueron incluso en su época demasiado clásicos y literarios —demasiado bellos— para merecer la confianza de la ciencia. Ningún biólogo moderno tenía que leer las obras de D’Arcy Thompson. Y pese a ello, los biólogos más preclaros se sienten atraídos por su libro. Sir Peter Medawar lo llamó, «más allá de toda comparación, la más bella obra literaria de los anales de la ciencia registrados en lengua inglesa». Stephen Jay Gould no encontró mejor origen del linaje intelectual de su creciente sensación de que la naturaleza constriñe las figuras de las cosas. Descontado D’Arcy Thompson, pocos biólogos modernos han buscado la unidad innegable de los organismos vivos. «Escasean los que se han preguntado si todas las pautas podrían reducirse a un solo sistema de fuerzas generadoras», expresó Gould. «Y contados parecieron notar el alcance que esa prueba de unidad tendría para la ciencia de la forma orgánica».
D’Arcy Thompson, clasicista, políglota, matemático y zoólogo, procuró ver la vida como un todo, en el momento preciso en que la biología recurría fructíferamente a métodos que reducían los organismos a sus partes funcionales constitutivas. Triunfaba el reduccionismo, más espectacularmente en la biología molecular, pero también en las restantes ciencias, desde el estudio de la evolución hasta la medicina. ¿Cómo se comprenderían las células si no se entendían las membranas y los núcleos, y más aún, las proteínas, enzimas, cromosomas y pares básicos? Cuando analizó el funcionamiento interno de los senos, retinas, nervios y tejido cerebral, la biología se hizo demasiado refinada para preocuparse de la forma del cráneo. D’Arcy Thompson fue el último en dedicarse a ello. Y, por lo mismo, fue también el último de los grandes biólogos que, en el lapso de muchos años, consagró energía retórica a un cuidadoso tratamiento de la causa, en particular a distinguir la final de la eficiente o física. La causa final se basa en la intención o designio: la rueda es redonda porque esa figura posibilita el transporte. La causa física es mecánica: la redondez de la Tierra se debe a que la gravedad transforma el fluido giratorio en un esferoide. La distinción no resulta siempre tan clara. Un vaso es redondo porque ésa es la forma más apta y cómoda para contener un líquido o para beberlo. También lo es porque es la forma que adopta naturalmente el barro en el torno o el vidrio al ser soplado.
En conjunto, la causa física domina en la ciencia. Como la astronomía y la física nacieron a la sombra de la religión, una parte nada despreciable del esfuerzo se aplicó a eliminar los argumentos de designio o de teleología: la Tierra es tal como es para que la humanidad haga lo que hace. Sin embargo, en la biología, Darwin estableció la teleología como centro del pensar sobre la causa. Tal vez el mundo biológico no cumpla la finalidad divina, pero responde al designio modelado por la selección natural. Ésta actúa no sobre los genes o embriones, sino sobre el producto definitivo. Por ello, una explicación adaptacionista de la figura de un organismo, o de la función de un órgano, repara siempre en la causa, no en la física, sino en la final. Ésta persiste en la ciencia en donde la idea darwiniana se ha hecho habitual. El antropólogo moderno, al especular acerca del canibalismo o el sacrificio ritual, tiende, con razón o equivocadamente, a preguntarse sólo a qué propósito obedece. D’Arcy Thompson advirtió que eso sucedería. Solicitó que la biología recordase también la causa física, es decir, que lo mecánico y lo teleológico se considerasen al mismo tiempo. Se dedicó a explicar las fuerzas matemáticas y físicas que actúan en la vida. Cuando el adaptacionismo echó raíces, explicaciones como aquéllas carecían de sentido. Se convirtió en un problema rico y fértil interpretar una hoja atendiendo a cómo la selección natural formaba un panel solar tan efectivo. Únicamente mucho después algunos científicos volvieron a sentirse intrigados por el lado inexplicado de la naturaleza. Las formas de las hojas son muy pocas de las muchas imaginables, y no las dicta su función.
Las matemáticas de que disponía D’Arcy Thompson no probaban lo que le interesaba. Le quedó, por ejemplo, el recurso de dibujar cráneos de especies emparentadas con coordenadas entrecruzadas, en demostración de que una simple transformación geométrica convertía uno en otro. En cuanto a los organismos sencillos —cuyas figuras recordaban de manera tan tentadora a chorros líquidos, salpicadura de gotitas y otras manifestaciones del flujo—, sospechó la existencia de causas físicas, tales como la gravedad y la tensión superficial, las cuales no podían realizar la obra de formación que esperaba. Entonces, ¿por qué Albert Libchaber pensó en On Growth and Form al emprender su experimento?
La intuición de D’Arcy Thompson sobre las fuerzas que modelan la vida era la que más se aproximaba, en la corriente principal de la biología, a la perspectiva de los sistemas dinámicos. Para él la vida era eso, vida, siempre en movimiento, respondiendo siempre a ritmos, los «arraigados ritmos del crecimiento», a los que atribuía la creación de las formas universales. Consideró propio de su estudio no las figuras materiales de las cosas, sino su dinámica: «La interpretación, en términos de fuerza, de las operaciones de la energía». Tenía los conocimientos matemáticos suficientes para saber que la catalogación de las formas no probaba nada. Pero era lo bastante poeta para confiar en que los accidentes y la finalidad explicaran la asombrosa universalidad de las que había coleccionado durante sus largos años de contemplación de la naturaleza. Las leyes físicas debían justificarla, gobernando la fuerza y el desarrollo de modo que se escapaba del alcance de la comprensión. Platón, de nuevo. Detrás de las figuras especiales y visibles de la materia habría quizá otras fantasmales que servirían de modelos invisibles. Formas en movimiento.
§. El delicado triunfo de Albert Libchaber
Libchaber eligió helio líquido para su experimento, pues, por tener viscosidad bajísima, se movería al más mínimo impulso. El experimento equivalente con un fluido de viscosidad media, como el agua o el aire, habría impuesto una caja mucho más grande. Aquella característica del helio hacía que el experimento fuese muy sensible al calor. Para que surgiese la convección en su celdilla milimétrica, le bastaba crear, entre la superficie inferior y la superior, una diferencia térmica de una milésima de grado. Por eso el recipiente era tan minúsculo. En uno mayor, en que el helio tendría más espacio para moverse, la convección hubiese exigido menos, mucho menos, calentamiento. Y en uno diez veces más grande en cada dirección, del tamaño de una uva —de volumen mil veces superior—, el movimiento habría empezado con una diferencia calórica de una millonésima de grado. Variaciones tan exiguas de la temperatura no podían controlarse.
Tanto en el planteamiento como el diseño y la construcción, Libchaber y su ingeniero se esforzaron por eliminar cualquier sombra de confusión. De hecho, hicieron lo posible por eliminar el movimiento que se proponía estudiar. El de un fluido, desde el flujo suave a la turbulencia, se concibe como movimiento en el espacio. Su complejidad se muestra como espacial, y sus trastornos y torbellinos, como caos espacial. Pero Libchaber buscaba ritmos que se revelasen como cambios en el tiempo. El tiempo era el campo de juego y la vara de medir. Redujo el espacio casi hasta lo unidimensional. Llevaba a la exageración una técnica que habían utilizado sus precursores en la experimentación con fluidos. Todo el mundo sabía que un flujo aprisionado —convección de Rayleigh-Bénard en una caja, o rotación de Couette-Taylor en un cilindro— tenía mejor comportamiento que uno libre, como las olas en el océano o las ondas en el aire. Un flujo exento posee superficie limítrofe libre y su complejidad se multiplica.
La convección en una caja rectilínea produce rollos de fluido semejantes a salchichas calientes —o, en este caso, a semillas de sésamo—. Eligió cuidadosamente las dimensiones de la celdilla con el fin de que diese cabida a dos rollos únicos. El helio líquido se elevaría en el centro, ascendería, se encorvaría en lo alto y bajaría por los lados externos de la celdilla. Era una geometría confinada. El balanceo estaría preso. Las líneas limpias y las proporciones cuidadosas evitarían fluctuaciones espurias. Libchaber dominó el espacio para jugar con el tiempo.
Así que comenzara el experimento, con el helio agitándose en el interior de la celdilla, ésta dentro del recipiente sometido al vacío, y éste metido en el baño de nitrógeno, Libchaber observaría lo que ocurriese. Introdujo dos sondas microscópicas de la temperatura en la superficie del zafiro que cubría la celdilla. Registró los resultados una plumilla trazadora. Así comprobó las temperaturas en dos lugares de la superficie del fluido. Fue algo tan sensible, tan inteligente, comentó un físico, que Libchaber logró engañar a la naturaleza.
Aquella obra maestra en miniatura de la precisión empleó dos años en su exploración total, pero fue, como dijo el experimentador, el pincel que necesitaba para su cuadro, ni muy grande ni muy complicado. Acabó por ver todo. Efectuando el experimento hora tras hora, de día y de noche, Libchaber descubrió, en el inicio de la turbulencia, una pauta de comportamiento más intrincada de lo que jamás se había atrevido a imaginar. Apareció en su plenitud la cascada de la duplicación de período. Libchaber había confinado y purificado el movimiento de un líquido que asciende al ser calentado. El proceso empieza con la primera bifurcación, el principio del movimiento en cuanto se calienta la lámina inferior, de cobre de gran pureza, con la intensidad requerida para romper la tendencia del fluido a permanecer inmóvil. A poca distancia del cero absoluto, una mera milésima de grado lo consigue. El líquido del fondo se caldea y expande lo suficiente para ser más ligero que el que pesa sobre él. La parte fría ha de hundirse para que suba la cálida. En seguida, para que ambos movimientos se cumplan, el líquido se organiza en dos cilindros o rollos giratorios, que adquieren velocidad constante, y el sistema se asienta en un equilibrio, en uno móvil, porque la energía térmica se convierte sin cesar en movimiento, se disipa, a consecuencia de la fricción, en calor y se escapa por la lámina fría superior.
Libchaber repitió hasta aquel punto un experimento harto conocido en la mecánica de los fluidos, tan conocido que se desdeñaba.
—Era física clásica —dijo Libchaber—. Lo que significaba, por desgracia, que tenía muchos años y que, por lo tanto, no interesaba.
Daba la casualidad, al propio tiempo, de que era el mismo flujo que Lorenz había modelado con su sistema de tres ecuaciones. Pero un experimento práctico y real —líquido verdadero, caja construida adrede, laboratorio expuesto a las vibraciones del tráfico de París— hacía que la tarea de cosechar datos fuese empresa mucho más ardua que la de generar simples cifras en un ordenador.
Los experimentadores como Libchaber empleaban una plumilla trazadora para registrar la temperatura, tal como la medía una sonda introducida en la superficie superior. Durante el movimiento equilibrado que sigue a la primera bifurcación, la temperatura permanece estable en cualquier punto —más o menos—, y la plumilla marca una recta. La inestabilidad se acrecienta, si se intensifica el calor. Cada cilindro muestra un retorcimiento, que se agita adelante y atrás. Esa vacilación u oscilación señala un cambio de temperatura, que sube y baja entre los valores. Y la plumilla traza en el papel una línea sinuosa.
Es una línea térmica sencilla, que se modifica continuamente y se estremece con el ruido experimental, resulta imposible leer el momento exacto en que aparecerán nuevas bifurcaciones, o deducir su índole. La línea dibuja cumbres y valles caprichosos, que parecen casi tan fortuitos como la gráfica de la trayectoria bursátil en período de altibajos. Libchaber analizó aquellos datos convirtiéndolos en un diagrama espectral que revelara las frecuencias principales ocultas en las temperaturas mutables. Obtener un diagrama espectral de un experimento se parece a la tarea de trazar el gráfico de las frecuencias acústicas de un acorde complejo en una sinfonía. Una línea irregular de imprecisión recorre siempre la parte inferior del gráfico: el ruido o confusión experimental. Los tonos principales aparecen como púas verticales: cuanto más fuerte el tono, tanto más alta será la púa. Asimismo, si los datos producen una frecuencia dominante —un ritmo que se destaca una vez cada segundo, por ejemplo—, esa frecuencia aparecerá como una púa en el diagrama espectral.
Ocurrió que, en el experimento de Libchaber, la primera longitud de onda surgió alrededor de los dos segundos. La bifurcación siguiente aportó un cambio sutil. El rollo continuó oscilando y la temperatura bolométrica no modificó su ascenso y descenso, sometidos a un ritmo dominante. Pero, en los ciclos impares, subió algo más que antes, y en los pares, descendió algo más. De hecho, la temperatura máxima se dividió en dos, por lo que hubo dos máximas y dos mínimas. La línea de la plumilla, difícil de interpretar, trazó una oscilación encima de otra: una meta oscilación. Aquello se apreció mejor en el diagrama espectral. La antigua frecuencia acusó todavía su presencia, pues la temperatura crecía aún cada dos segundos. Sin embargo, una frecuencia distinta apareció exactamente en la mitad de la anterior, porque el sistema había desarrollado un componente que se repetía cada cuatro segundos. Como las bifurcaciones no cesaron, se distinguió una pauta extrañamente consistente: las nuevas frecuencias doblaban las antiguas, de suerte que el diagrama se llenó en las partes cuartas, octavas y decimosextas, y fue adquiriendo el aspecto de una valla en las que se alternasen tablas cortas y largas.
Incluso para quien buscaba formas escondidas en datos confusos, fueron necesarias decenas y, después, centenares de pruebas antes de que se precisaran los hábitos de la celdilla. Sobrevenían cosas singulares cuando Libchaber y el ingeniero aumentaban despacio la temperatura y el sistema pasaba de un equilibrio a otro. En ocasiones, comparecían frecuencias transitorias, se deslizaban lentamente por el diagrama espectral y desaparecían. En otras, pese a la geometría definida, se desarrollaban tres rollos en lugar de dos. Por consiguiente, ¿cómo sabrían lo que pasaba en realidad en el interior de la celdilla?

Dos modos de ver una bifurcación.
Cuando un experimento como el de Libchaber con la celda de convección produce una oscilación uniforme, la imagen de su espacio de fases es una curva, que se repite a intervalos regulares (arriba, izquierda). El experimentador que mida las frecuencias en los datos obtendrá un diagrama espectral con una púa acusada para este ritmo único. Después de una bifurcación de duplicación de período, el sistema describe dos curvas antes de repetirse de modo exacto (centro). Entonces el experimentador observa un nuevo ritmo de la mitad de la frecuencia —dos veces el período— del original. Las nuevas duplicaciones de período llenan el diagrama espectral con más púas.

Los datos del mundo real confirman la teoría.
Los diagramas espectrales de Libchaber mostraron la pauta precisa de la duplicación de período que la teoría había pronosticado. Las púas de las nuevas frecuencias se destacan con claridad sobre el ruido experimental. La teoría escalar de Feigenbaum predijo no sólo cuándo y dónde surgirían las nuevas frecuencias, sino también su fuerza, o sea su amplitud.
Si hubiera estado enterado del descubrimiento de la universalidad, debido a Feigenbaum, Libchaber habría sabido dónde buscar las bifurcaciones y cómo denominarlas. En 1979, un grupo cada vez más nutrido de matemáticos y físicos aficionados a las ciencias exactas prestaba oído a la teoría de Feigenbaum. Pero la mayoría de los expertos en problemas de los sistemas físicos reales creían tener buenos motivos para mostrarse reservados. Una cosa era la complejidad en los sistemas unidimensionales, los mapas o diagramas de May y Feigenbaum. Y algo bastante diferente en los de dos, tres o cuatro dimensiones que un ingeniero construía. Precisaban verdaderas ecuaciones diferenciales y no sencillas ecuaciones en diferencias. Y otro abismo parecía separar los sistemas de escasas dimensiones de los del flujo fluido, que los físicos concebían como dotados potencialmente de infinitas dimensiones. Incluso una celdilla como la de Libchaber, estructurada con tanto esmero, poseía una virtual infinidad de partículas fluidas, cada una de las cuales era un potencial de movimiento independiente. En algunas circunstancias, cualquiera podía originar una desviación o un torbellino.
—La idea de que el movimiento, material e importante, de semejante sistema se condensa en mapas…, era algo que nadie entendía —dijo Fierre Hohenberg de los AT&T Bell Laboratories de Nueva Jersey, uno de los escasísimos físicos que siguió la teoría y los experimentos nuevos—. Quizá Feigenbaum pensó en ello, pero no lo expresó. Su obra concernía a diagramas o mapas. ¿Y por qué un físico se interesaría en ellos?… Es un juego. Ciertamente, mientras jugaron con ellos, nos pareció que distaban mucho de lo que ansiábamos entender. Pero cuando se vio en experimentos, fue algo emocionante. Lo prodigioso es que, en los sistemas interesantes, se logra comprender en detalle el comportamiento con un modelo que posea escasos grados de libertad.
Hohenberg, al fin, unió al teórico y el experimentador. Dirigía un taller en Aspen en el verano de 1979, y Libchaber estuvo en él. (Cuatro años antes, en el mismo taller estival, Feigenbaum había oído hablar a Steve Smale de un número —uno solo— que saltaba si un matemático contemplaba la transición al caos en cierta ecuación). Hohenberg escuchó interesado cuando Libchaber describió sus experimentos con helio líquido. En el viaje de regreso, Hohenberg se detuvo en Nuevo México y conversó con Feigenbaum. Éste, poco tiempo después, visitó a Libchaber en París. Se encontraron rodeados de las partes diseminadas de aparatos y los instrumentos del laboratorio del francés. Libchaber mostró con orgullo su celdilla y permitió que Feigenbaum expusiera su teoría más reciente. Después anduvieron por las calles parisienses en busca del mejor café posible. Libchaber recordó más tarde cuál fue su asombro al encontrar a un teórico tan joven y, como le definió, tan avispado.
§. De una dimensión a muchísimas
El brinco de los diagramas a la corriente fluida parecía tan enorme, que aun los más bien dispuestos lo definían en ocasiones como un sueño. No se concebía cómo la naturaleza enlazaba tanta complejidad con tanta sencillez.
—Había que considerarlo como un milagro, y no como el nexo habitual entre la teoría y el experimento —dijo Jerry Gollub.
Al cabo de pocos años, el milagro se reiteró en un amplio bestiario de experimentos de laboratorio: celdas más grandes de fluido con agua y mercurio, osciladores electrónicos, lásers y hasta reacciones químicas. Los teóricos adaptaron las técnicas de Feigenbaum y dieron con otras rutas matemáticas que llevaron al caos, parientes de la duplicación de período: pautas tales como la intermitencia y la cuasi periodicidad. Evidenciaron que eran también universales en la teoría y la experimentación.
Los descubrimientos de los experimentadores contribuyeron a promover la era de las pruebas prácticas con ordenadores. Los físicos repararon en que producían las mismas imágenes cualitativas que los experimentos reales y que lo hacían, además, con rapidez millones de veces más grande y con mayor fiabilidad. Para muchos fue más convincente incluso que los resultados de Libchaber el modelo de fluido creado por Valter Franceschini, de la Universidad de Módena (Italia): un sistema de cinco ecuaciones diferenciales, que producía atractores y duplicación de período. Franceschini no sabía una palabra de Feigenbaum, pero su modelo, complejo y pluridimensional, proporcionaba las mismas constantes que el estadounidense había encontrado en los diagramas unidimensionales. Un grupo europeo ofreció, en 1980, una convincente explicación matemática: la de que la disipación depura un sistema complejo de muchos movimientos conflictivos, lo cual reduce el comportamiento de muchas dimensiones a una sola.
Fuera de los ordenadores, seguía siendo un verdadero desafío encontrar un atractor extraño en un experimento con fluidos. Ocupó a experimentadores de la categoría de Harry Swinney hasta bien entrado el decenio de 1980. Y cuando tuvieron, al fin, éxito, los nuevos expertos en ordenadores se refirieron con desprecio a sus resultados como los ecos, toscos y predecibles, de las imágenes magníficamente detalladas que ya producían sus terminales gráficos. En el experimento con ordenador, en el que se generaban millares o millones de puntos de datos, las pautas se hacían más o menos aparentes. En el laboratorio, como en el mundo real, la información útil tenía que discriminarse de lo que no lo era. En un experimento con ordenador los datos manaban como vino de una copa mágica. En uno efectuado en el laboratorio, había que luchar por cada gota.
Pese a ello, las teorías de Feigenbaum y otros no habrían atraído a comunidad tan amplia de científicos sólo con el imán de experimentos con ordenador. Las modificaciones, compromisos y aproximaciones necesarios para digitalizar sistemas de ecuaciones diferenciales no lineales resultaban demasiado sospechosos. La simulación descomponía la realidad en la mayor cantidad posible de pedazos, que siempre eran pocos. Un modelo de ordenador es un conjunto de reglas arbitrarias, elegidas por los programadores. Un fluido verdadero, incluso en una celdilla milimétrica, posee el innegable potencial del movimiento, libre de trabas, el desorden natural. También encierra sorpresas en potencia.
En la edad de la simulación, en que flujos de toda especie, desde las turbinas de un avión de propulsión a chorro a las válvulas cardíacas, son susceptibles de aparecer como modelos en los superordenadores, apenas se recuerda la facilidad con que la naturaleza puede confundir al experimentador. Ningún programa actual consigue simular siquiera un sistema tan sencillo como la celdilla de helio líquido de Libchaber. En cuantas ocasiones examina una simulación, un buen físico debe preguntarse qué parte de la realidad se habrá olvidado, qué posibilidad de sorpresa se dejó de lado. Libchaber se complacía en repetir que no le gustaría volar en un avión simulado, pues le preocuparía la idea de qué se habría omitido. Además, insistía en que las simulaciones de ordenador, si contribuían a construir la intuición o a refinar los cálculos, no generaban descubrimientos genuinos. Tal es, al menos, el credo del experimentador.
Hubo físicos que consideraron el trabajo de Libchaber más como filosofía o como matemáticas que como física, debido a su experimento inmaculado y a lo abstracto de sus metas científicas. Por su parte, él estaba convencido de que las normas que regían su actividad eran reduccionistas, pues daban la primacía a las propiedades atómicas.
—Un físico me preguntará: « ¿Cómo llega este átomo aquí y aquí permanece? ¿Y cuál es la sensibilidad para la superficie? ¿Puede usted desarrollar la hamiltoniana del sistema?». Y si le respondo que eso no me importa, pues estoy interesado en esta forma, en sus matemáticas y evolución, en la bifurcación de la forma en otra, y ésta en otra, etc., me asegurará que eso no es física, sino ciencias exactas. Me lo diría incluso hoy día. ¿Qué contestaré? Sí, desde luego, hago matemáticas. Pero es pertinente a lo que nos rodea. Es también naturaleza.
Las pautas que descubrió eran abstractas. Matemáticas. No expresaron nada sobre las propiedades del helio líquido, o el cobre, o el comportamiento de los átomos en las inmediaciones del cero absoluto. Eran aquellas en que habían soñado los antepasados místicos de Libchaber. Legitimaron un campo de la experimentación que pronto muchos científicos, desde los químicos a los ingenieros eléctricos, exploraron en busca de nuevos elementos del movimiento. Las pautas quedaron expuestas la primera vez que aumentó la temperatura lo bastante para aislar una duplicación de período, y luego la siguiente, y la siguiente. Según la nueva teoría, las bifurcaciones debían producir una geometría de escalas precisas. Eso fue lo que Libchaber vio, las constantes universales de Feigenbaum, que se convertían en aquel momento de ideal matemático en realidad física, mensurable y reproducible. Mucho tiempo después recordó la impresión sentida, la fantástica contemplación de una bifurcación tras otra, y haber comprendido que presenciaba una cascada infinita, rica en estructuras. Fue, como dijo, divertido.

Qué más, cuando el caos absorbe todas las fuerzas
Para formar una sola hoja.
CONRAD AIKEN
§. El plano complejo§. El plano complejo
§. Sorpresa en el método de Newton
§. El conjunto de Mandelbrot: brotes y zarcillos
§. El arte y el comercio se encuentran con la ciencia
§. Límites de cuencas fractales
§. El juego del caos
Michael Barnsley conoció en 1979 a Mitchell Feigenbaum en Córcega, durante una conferencia. Entonces Barnsley, matemático educado en Oxford, tuvo noticia de la universalidad, la duplicación de período y las cascadas infinitas de bifurcaciones. Una buena idea, pensó, de esas que disparan a los científicos a la carrera en busca de parcelas explotables. En lo que le concernía, él creyó ver una en la que nadie había reparado.
¿De dónde procedían los ciclos de 2, 4, 8, 16, las secuencias de Feigenbaum? ¿Aparecerían por arte de ensalmo de algún vacío matemático o eran la obra de algo todavía más recóndito? La intuición susurró a Barnsley que debían de ser parte de un fabuloso objeto fractal, invisible hasta entonces.
Para aquella noción tenía un contexto: el territorio numérico denominado plano complejo. En él, los números desde menos infinito a infinito —esto es, todos los reales— se disponen en una línea que va desde el extremo este, con el cero en el centro. Mas esa línea es sólo el ecuador de un mundo que se extiende también hasta lo infinito por el norte y por el sur. Cada número se compone de dos partes, una real, correspondiente a la longitud este-oeste, y otra imaginaria, la de la latitud norte-sur. Por convención, estos números complejos se expresan así: 2 + 3i, donde i representa la porción imaginaria. Las dos partes proporcionan a cada uno señas únicas en ese plano bidimensional. Por lo tanto, la línea original de los números reales no es más que un caso especial, la serie de números cuya porción imaginaria es igual a cero. En el plano complejo, atender únicamente a los números reales —puntos en el ecuador— equivaldría a limitar la visión a alguna que otra intersección de formas, las cuales podrían revelar otros secretos, si se consideraban en dos dimensiones. Tal fue lo que Barnsley sospechó.
Los epítetos real e imaginario se originaron cuando los números ordinarios parecían más auténticos que aquel nuevo híbrido; pero se reconoció su arbitrariedad, porque eran tan reales y tan imaginarios como los de cualquier otra clase. Históricamente, los imaginarios se inventaron para llenar el vacío conceptual que suscitaba la pregunta: ¿Cuál es la raíz cuadrada de un número negativo? Conforme a regla comúnmente aceptada, el cuadrado de −1 es i, el de −4 es 2i, etc. Faltaba dar un paso corto para comprender que las combinaciones de números reales e imaginarios permitían clases nuevas de cálculo con ecuaciones polinómicas. Los números complejos se suman, multiplican, promedian, utilizan como factores y se integran. Con ellos se efectúan los mismos cálculos que con los reales. Barnsley, cuando trasladó las funciones de Feigenbaum al plano complejo, vio surgir los perfiles de una fantástica familia de formas, en apariencia relacionadas con las ideas dinámicas que intrigaban a los físicos experimentales, y, al mismo tiempo, sorprendentes como construcciones matemáticas.
Comprendió que aquellos ciclos no surgían de la nada. Caían dentro de la línea real del plano complejo, en el que hay, bien observado, una constelación de ciclos de toda especie. Había siempre uno de dos, de tres y de cuatro, flotando invisibles hasta que llegaban a la línea real. Barnsley se precipitó desde Córcega a su despacho del Georgia Institute of Technology y redactó un artículo. Lo remitió para su publicación a las Communications in Mathematical Physics. Su editor era David Ruelle, quien le reservaba malas noticias. Barnsley había redescubierto sin saberlo el trabajo de un matemático francés, el cual ya tenía cincuenta años de edad.
—Ruelle me lo devolvió como si fuese una patata caliente y me dijo: «Michael, no son más que conjuntos de Julia» —explicó Barnsley.
Ruelle agregó un consejo:
—Comuníquese con Mandelbrot.
§. Sorpresa en el método de Newton
John Hubbard, matemático estadounidense aficionado a las camisas llamativas, había enseñado tres años antes cálculo elemental a los estudiantes universitarios del primer curso en Orsay (Francia). Entre las materias corrientes que había expuesto figuró el método de Newton, esquema clásico para resolver ecuaciones por medio de tanteos cada vez más aproximados a la realidad. Sin embargo, aburrido de lo corriente, decidió enseñar el procedimiento newtoniano de manera que obligase a sus alumnos a pensar.
El método citado es antiguo (lo era cuando Newton lo inventó). Los griegos usaron una versión de él para encontrar raíces cuadradas. Se inicia con una conjetura, ésta conduce a otra mejor, y el proceso de iteración se enfoca en una respuesta como un sistema dinámico que busque el estado estable. El procedimiento es rápido. La cantidad de dígitos decimales correctos suele doblarse en cada paso. Hoy día, desde luego, las raíces cuadradas sucumben a métodos más analíticos, lo mismo que todas las ecuaciones polinómicas de segundo grado, o sea en aquellas que las variables se elevan sólo a la segunda potencia. Pero el método de Newton también se utiliza en ecuaciones polinómicas de grado superior, que no pueden resolverse directamente. Se aplica también con éxito en una variedad de algoritmos en informática, porque, como siempre, la iteración es la fuerza de los ordenadores. Una pequeña contrariedad del método newtoniano es que las ecuaciones acostumbran tener más de una solución, particularmente cuando se incluyen las complejas. Cuál de ellas se encuentra depende del supuesto inicial. En la práctica, los estudiantes no lo consideran una dificultad. Por lo general, se tiene una idea clara de dónde se ha de empezar, y si la conjetura parece llevar a una solución errónea, se comienza la operación de otro modo.
Cabía preguntarse qué clase exacta de ruta traza el método de Newton cuando se encamina hacia una raíz de un polinomio de segundo grado en el plano complejo. Podía contestarse, pensando geométricamente, que el procedimiento sólo busca cuál de las dos raíces está más próxima a la conjetura inicial. Así lo dijo Hubbard a sus alumnos de Orsay cierto día en que surgió la cuestión.
—Ahora bien, en lo referente a las ecuaciones, por ejemplo, de tercer grado, la situación se complica. Pensaré sobre ello y se lo explicaré la semana que viene —prometió Hubbard con acento de confianza.
Estaba persuadido de que lo difícil sería enseñar a los estudiantes a calcular la iteración, y de que la conjetura no exigiría grandes esfuerzos. Pero cuanto más reflexionó menos supo qué constituía una conjetura inteligente, o, lo que venía a ser lo mismo, qué efectuaba el método de Newton. La suposición geométrica evidente consistía en dividir el plano en tres cuñas, con una raíz en el interior de cada una; pero Hubbard descubrió que aquello no servía. Sucedían cosas extrañas cerca de los límites. Encima, Hubbard averiguó que no era el primer matemático que daba de cabeza con dificultad tan sorprendente. Lord Arthur Cayley había intentado, en 1879, ir del manejable caso de segundo grado al tercero, pavorosamente ingobernable. Pero Hubbard, un siglo después, tenía a mano un instrumento del que Cayley careció.
Hubbard pertenecía al género de matemático riguroso que desprecia los supuestos, aproximaciones y medias verdades, basados más en la intuición que en las pruebas. De acuerdo con ello, insistía, a los veinte años de que el de Edward Lorenz se hubiese incorporado a la bibliografía, que nadie sabía de veras si aquellas ecuaciones daban origen a un atractor extraño. La conocida espiral doble, aseveró, no era demostración, sino mero indicio, algo que producían los ordenadores.
A despecho de ello, Hubbard empleó uno para efectuar lo que las técnicas ortodoxas no habían hecho. El ordenador no probaría nada. Pero quizá desvelase al menos la verdad, para que un matemático supiera qué debía intentar demostrar. Trató el método de Newton no como un medio de solventar problemas, sino como un problema en sí mismo. Consideró el ejemplo más simple de una ecuación polinómica de tercer grado: x3 − 1 = 0. Es decir, había que hallar el cubo de 1. Con números reales, se tiene, desde luego, la solución vulgar: 1. Sin embargo, el polinomio posee otras dos complejas: −1/2 + i√−3/2 y−1/2 − i√−3/2. Trasladadas al plano complejo, las tres raíces forman un triángulo equilátero, con un punto —pensando en un reloj— en las tres, otro en las siete y otro en las once. Dado un número complejo como lugar de partida, la cuestión era averiguar a cuál de las tres soluciones llevaría el procedimiento newtoniano, como si éste fuese un sistema dinámico y las tres soluciones otros tantos atractores. O como si el plano complejo fuera una superficie lisa que se inclinase a tres valles hondos. Una canica, partiendo de cualquier situación de aquella pendiente, caería en un valle. Pero ¿en cuál?

Límites de complejidad infinita.
Cuando se corta en tres una tarta, las tres partes coinciden en un solo punto, y los límites entre dos de ellas son sencillos. Pero muchos procesos de matemáticas abstractas y de la física del mundo real crean límites de complicación casi inimaginable. El método de Newton, aplicado para hallar la raíz cúbica de −1, divide el plano en tres regiones idénticas, una de las cuales se muestra en blanco. Todos los puntos de este color se sienten «atraídos» por la raíz que se halla en el área blanca más grande; todos los negros son atraídos por una de las otras dos raíces. El límite tiene la curiosa propiedad de que cada uno de sus puntos bordea las tres regiones. Y, como se aprecia en la ilustración, los segmentos ampliados revelan una estructura fractal, que repite la pauta básica a escalas cada vez más reducidas.
Cuando obligaron al ordenador a explorar el espacio cada vez con mayor detalle, Hubbard y sus alumnos se desconcertaron ante la imagen que se insinuaba. Vieron, por ejemplo, manchas verdes ensartadas como joyas, en lugar de una cresta definida entre los valles azul y encarnado, como si la canica, apresada en las atracciones contrapuestas de los dos valles cercanos, hubiese de acabar en el tercero y más distante. Jamás se formó del todo un límite entre un par de colores. Una inspección aún más atenta halló manchas encarnadas en la línea que había entre una verde y el valle azul. Y así sucesivamente. El límite enseñó a Hubbard una característica peculiar, que habría azorado incluso a alguien ducho en los fractales monstruosos de Mandelbrot: ningún punto servía de separación de dos colores solos. Cuando éstos intentaban juntarse, el tercero se entremetía siempre con series de intrusiones nuevas y auto semejantes. Inverosímilmente, cada punto limítrofe bordeaba una región de cada uno de los tres colores.
Hubbard se embarcó en el estudio de aquellas formas complicadas y lo que podía inferirse de ellas para las matemáticas. Su trabajo y el de sus colegas pronto se convirtieron en nueva línea de ataque en el problema de los sistemas dinámicos. Comprendió que la plasmación del diagrama del método de Newton no era sino una de la familia inexplorada de imágenes que reflejaban el comportamiento de las fuerzas en el mundo real. Michael Barnsley buscaba otros parientes. Benoît Mandelbrot, como no tardaron en saber ambos investigadores, estaba descubriendo el abuelito de todas aquellas formas.

Los límites complicados del método de Newton.
La fuerza de atracción de cuatro puntos —en los cuatro agujeros negros— crea «cuencas de atracción», cada una de color distinto, con un complejo límite fractal. La imagen representa el modo como el método de Newton, para resolver ecuaciones, lleva de puntos iniciales diferentes a una de cuatro soluciones posibles (en este caso la ecuación es x4 − 1 = 0).
Sus admiradores se complacen en asegurar que el conjunto de Mandelbrot es el objeto más complicado de las ciencias exactas. La eternidad no bastaría para verlo de manera total: sus discos, erizados de púas espinosas, y sus espirales y filamentos, que se encorvan al exterior y se ensortijan, soportando moléculas bulbosas que cuelgan, infinitamente abigarradas, como racimos del viñedo particular de Dios. Examinado en color, a través de la ventanilla ajustable de la pantalla de un ordenador, el conjunto de Mandelbrot parece más fractal que los fractales, a causa de su rica complicación a lo largo de las escalas. Exigiría una infinidad de información el intento de catalogar las imágenes diferentes que contiene, o el de establecer una descripción numérica de su perfil. Pero he aquí la paradoja: para enviar una descripción total del conjunto por una línea de transmisión, se necesitan sólo pocas docenas de caracteres del código. Un programa conciso de ordenador posee la información suficiente para reproducirlo por completo. Los primeros en entender cómo se mezclaban en él lo complejo y lo simple fueron cogidos desapercibidos, incluido Mandelbrot. El conjunto de éste se transformó en una especie de emblema público del caos, apareció en las satinadas portadas de los folletos de conferencias y de revistas trimestrales de ingeniería, y fue la pieza más importante de una exposición de arte informático que recorrió las naciones en 1985 y 1986. Se captaba con facilidad su belleza en aquellas imágenes; en cambio, costó mucho más captar su significado a los matemáticos, que lo iban comprendiendo paso por paso.
Pueden formarse muchas figuras en el plano complejo con procedimientos iterativos, pero el conjunto de Mandelbrot es único. Surgió vago, espectral, cuando su descubridor se propuso establecer una generalización sobre las formas llamadas conjuntos de Julia. Los inventaron y estudiaron, durante la primera guerra mundial, los matemáticos franceses Gaston Julia y Pierre Fatou, que trabajaron sin las imágenes que ahora proporciona el ordenador. Mandelbrot había visto sus modestos dibujos y su obra —ya caída en la oscuridad— a la edad de veinte años. Los conjuntos de Julia, de aspecto variable, eran los objetos que intrigaban a Barnsley. Algunos parecen círculos, pinchados y deformados en muchos sitios, para proporcionarles estructura fractal. Otros se rompen en regiones y otros son polvos irrelacionados. Los vocablos y conceptos de la geometría euclídea no servían para describirlos. El matemático francés Adrien Douady dijo: «Se obtiene una variedad increíble de conjuntos de Julia. Unos son como nubes gordezuelas, otros como zarza sarmentosa y otros como chispas que flotan en el aire, tras el estallido de un fuego de artificio. Uno ostenta la figura de conejo, y muchos poseen colas de caballo de mar».
Mandelbrot descubrió, en 1979, que podía crear, en el plano complejo, una imagen útil como catálogo de los conjuntos de Julia, como guía de todos y cada uno. Exploró la iteración de procesos complicados, ecuaciones que incluían raíces cuadradas, senos y cosenos. Como había edificado su vida intelectual sobre la hipótesis de que lo sencillo engendra lo complejo, no advirtió inmediatamente cuán extraordinario era el objeto que se cernía fuera del campo visual de la pantalla de su ordenador en la IBM y en Harvard. Apretó sin piedad a los programadores para que precisaran los detalles, y ellos sudaron sangre para reservar en la memoria, ya forzada, espacio para interpolar puntos de un ordenador IBM principal, con un tubo elemental de representación visual en blanco y negro. La situación empeoró porque los programadores debieron estar constantemente alerta para hacer frente a un escollo común en la exploración con ordenador, la producción de «artefactos», apariciones debidas sólo a una rareza de la máquina y que desaparecían cuando el programa se escribía de modo distinto.

Colección de conjuntos de Julia.
Aquello le animó a seguir adelante, refinando las imágenes burdas. Pronto encontró polvo que desordenaba el perfil de los discos y se cernía en el espacio circunstante. Mientras procuraba refinar los detalles, pensó que la buena suerte le había abandonado. Las imágenes se hicieron más confusas en lugar de más claras. Regresó al centro de investigaciones de la IBM, en el condado de Westchester, en busca de una potencia de ordenador con la que Harvard no podía rivalizar. Le asombró comprobar que la confusión era síntoma de algo real. Los brotes y zarcillos salían lánguidamente de la isla principal. Contempló cómo un límite, continuo a todas luces, se transformaba en una cadena de espirales semejantes a colas de caballo de mar. Lo irracional fecundaba lo racional.
El conjunto de Mandelbrot es una colección de puntos. Cada uno, en el plano complejo —o sea cada número complejo—, está en el conjunto o fuera de él. Una manera de definirlo consiste en examinar los puntos uno tras otro, lo que sólo exige una sencilla aritmética iterativa. Para efectuarlo se toma el número complejo; se eleva al cuadrado; se suma el número original; se obtiene el cuadrado del resultado; se suma el número original; se obtiene el cuadrado del resultado, y así en adelante. Si el total tiende al infinito, el punto no está en el conjunto de Mandelbrot. Se halla en él si el total se atiene a lo finito (pudiera estar en una curva cerrada, repetitiva, o vagar caóticamente).

Aparece el conjunto de Mandelbrot.
En las primeras y toscas impresiones de ordenador que obtuvo Mandelbrot, apareció una estructura imperfecta, que se fue detallando así que mejoró la calidad de la computación. ¿Eran islas aisladas las «moléculas» flotantes semejantes a pulgones? ¿O estaban unidas al cuerpo principal con filamentos tan sutiles que no podían observarse? Fue imposible precisarlo.

La repetición indefinida de un proceso y la pregunta de si el resultado es infinito se parece a los procesos de realimentación del mundo cotidiano. Supóngase que se montan un micrófono, amplificador y altavoces en un auditorio, y que preocupa el agudo pitido de la realimentación acústica. Si el micrófono recoge un ruido bastante fuerte, el sonido ampliado de los altavoces volverá al micrófono en un bucle interminable, cada vez más intenso. Si es bastante reducido, el ruido acabará en la nada. Para hacer con números el modelo de este proceso de realimentación, puede adoptarse uno de partida, multiplicarlo por sí mismo, multiplicar el producto por sí mismo, etc. Se comprobará que las cifras grandes conducen inmediatamente al infinito: 10, 100, 10.000… Pero las pequeñas llevan a cero: 1/2, 1/4, 1/16… Para crear una figura geométrica, se define una colección de cuantos puntos, introducidos en esta ecuación, que no se escapan hacia el infinito. Considérense los de una recta desde el cero en adelante, hacia arriba. Si un punto emite un pitido de realimentación, désele color blanco. De lo contrario, el color será negro. No se tardará en tener una figura que consiste en una línea negra de 0 a 1.
Nadie necesitaba recurrir a la experimentación en el caso de un proceso unidimensional. No cuesta comprender que los números mayores que uno llevan al infinito y que el resto no lo hace. Pero, en las dos dimensiones del plano complejo, no suele bastar, conociendo la ecuación, la deducción de una forma definida por un proceso iterativo. El conjunto de Mandelbrot no admite atajos, a diferencia de las figuras geométricas tradicionales, como las circunferencias, elipses y parábolas. El único método de saber qué clase de figura corresponde a una ecuación determinada es proceder por tanteo, y este procedimiento puso a los exploradores de aquel terreno ignorado más cerca espiritualmente de Magallanes que de Euclides.
La unión del mundo de las formas con el de los números, así realizada, representó una ruptura con el pasado. Las nuevas geometrías nacen siempre que alguien cambia una regla básica. Supongamos que el espacio es curvo en lugar de plano, propone un geómetra, y el resultado será una fantástica parodia curva de Euclides que ofrece el marco preciso para la teoría general de la relatividad. Supongamos que el espacio tiene cuatro dimensiones, o cinco, o seis. Supongamos que el número que expresa una dimensión sea una fracción. Supongamos que las figuras pueden retorcerse, estirarse, anudarse. O, ahora, supongamos que las formas se definen iterando una ecuación en un bucle de realimentación, y no resolviéndola una sola vez.
Julia, Fatou, Hubbard, Barnsley y Mandelbrot… Estos matemáticos modificaron las reglas sobre la confección de las figuras geométricas. Los métodos euclídeo y cartesiano para convertir ecuaciones en curvas son conocidos por quien haya estudiado geometría en la segunda enseñanza, o encontrado un sitio en un mapa por medio de dos coordenadas. La geometría clásica, ante una ecuación, busca la serie de números que la satisfagan. Las soluciones de una como x2 + y2 = 1 producen una figura que, en este caso, es una circunferencia. Otras sencillas motivan figuras distintas, las elipses, parábolas e hipérbolas de secciones cónicas, o las más complicadas debidas a ecuaciones diferenciales en el espacio de fases. Pero cuando el geómetra la itera, en vez de resolverla, la ecuación se transforma en un proceso —y no en una descripción—, dinámico en lugar de estático. Si entra un número en ella, otro sale, y aquél permanece, etc. Los puntos saltan de un sitio a otro. Un punto se marca cuando causa cierta clase de comportamiento, pero no cuando satisface la ecuación. Como comportamientos existen el estado estable, la convergencia de una repetición periódica de los estados y la carrera desenfrenada, incontenible, hacia el infinito.
En la era precedente a los ordenadores, hasta Julia y Fatou, que comprendieron las posibilidades de la nueva creación de imágenes, carecieron de los medios para transformarla en ciencia. Los ordenadores posibilitaron la geometría de tanteo. Hubbard analizó el método de Newton, calculando el comportamiento de un punto tras otro, y Mandelbrot encontró su conjunto de la misma guisa, o sea mediante un ordenador que recorriera, uno tras otro, los puntos del plano. No todos, claro está. Los cálculos recurrieron a una rejilla de puntos, pues tanto el tiempo como los ordenadores son finitos. Una rejilla más fina rinde una imagen más precisa, mas a costa de operaciones más largas. Los cálculos sobre el conjunto de Mandelbrot eran sencillos, porque el proceso también lo era: la iteración en el plano complejo de z→ z2 + c. Tómese un número, multiplíquese por él mismo y súmese el número inicial.
Así que se habituó a la actividad de explorar las figuras con ordenador, Hubbard introdujo un estilo matemático innovador, aplicando los métodos del análisis combinatorio, sección de las matemáticas que no se había utilizado aún en los sistemas dinámicos. Pensó que todo se unía. Disciplinas separadas de las ciencias exactas se juntaban en una encrucijada. Sabía que no le bastaría ver el conjunto de Mandelbrot; no se daría por vencido hasta que lo entendiera, y, al fin, aseveró que lo había logrado.
Si el límite era sólo fractal, en el sentido de los monstruos de Mandelbrot, de comienzos de siglo, una imagen se parecería más o menos a la anterior. El principio de la auto semejanza a escalas distintas permitiría predecir lo que el microscopio electrónico vería en el siguiente nivel de ampliación. En cambio, cada incursión más profunda en el conjunto daba sorpresas. Mandelbrot se preocupó porque había dado una definición demasiado reducida de fractal; ansiaba que el vocablo abarcara también aquel objeto. Con la ampliación necesaria, se apreció que el conjunto contenía torpes copias de sí mismo, cosas minúsculas, parecidas a bichitos, que se separaban del cuerpo principal. La ampliación aún mayor mostró que ninguna de aquellas moléculas era igual a las demás. Había siempre clases diversas de caballos de mar, especies distintas de individuos rizosos. En suma, ninguna parte del conjunto era idéntica, fuese cual fuere la ampliación.
El descubrimiento de moléculas flotantes suscitó un problema inmediato. ¿Se componía el conjunto de Mandelbrot de un continente con penínsulas muy alargadas? ¿O era polvo, un cuerpo principal rodeado de islas diminutas? No estaba claro. De nada servía el conocimiento de los conjuntos de Julia, que tenían ambas manifestaciones: figuras enteras y polvos, según los casos. Los últimos, por ser fractales, tienen la característica peculiar de que no hay en ellos dos partes «juntas» —cada porción está separada de las restantes por una región vacía—; pero ningún fragmento está «solo»: uno siempre se halla arbitrariamente cerca de un grupo de ellos. Mandelbrot, al observar las imágenes, comprendió que el experimento con ordenador no despejaba aquella cuestión fundamental. Se concentró sobre todo en las motas que revoloteaban en torno del cuerpo principal. Unas desaparecieron, y otras se trocaron casi en claras réplicas de ellas. Parecían independientes, pero acaso estuviesen enlazadas por líneas tan finas que continuaban burlando la rejilla de puntos computados.
Douady y Hubbard recurrieron a una brillante cadena de matemáticas novísimas para probar que cada molécula flotante pende de una filigrana que la une al resto, delicada red salida de ínfimos abultamientos del conjunto principal, «polímero del demonio», de acuerdo con la expresión de Mandelbrot. Los matemáticos demostraron que cualquier segmento —fueran cuales fueran su situación y su tamaño—, cuando el «microscopio» del ordenador lo ampliase, revelaría más moléculas, todas semejantes, pero no idénticas al conjunto general. Todas estarían rodeadas de espirales y proyecciones propias, semejantes a llamas, las cuales, inevitablemente, mostrarían moléculas más minúsculas, siempre similares y jamás iguales, en cumplimiento de un precepto de infinita variedad, de un milagro de miniaturización, en el que cada detalle estaba seguro de ser en sí un universo, sin par y cabal.

El conjunto de Mandelbrot.
Un viaje a través de escalas cada vez más pequeñas muestra la creciente complejidad del conjunto, con colas de caballo de mar y moléculas como islas, semejantes a la imagen total. En el último recuadro, el índice de ampliación es de un millón en cada dirección.






—Era una concepción de líneas rectas muy geométrica —dijo Heinz-Otto Peitgen, que hablaba de arte moderno—. Por ejemplo, la obra de Josef Albers, que trataba de descubrir la relación cromática, se compuso en esencia de cuadrados de colores distintos sobrepuestos. Fueron muy populares, aunque ahora parezcan trasnochados. No gustan a la gente. En Alemania construyeron enormes bloques de pisos, en el estilo de la Bauhaus, y los inquilinos se van de ellos porque no les agradan como vivienda. Creo que la sociedad actual tiene motivos muy hondos para discrepar de algunos aspectos de nuestra concepción de la naturaleza.
Peitgen había ayudado a un visitante a seleccionar ampliaciones de regiones de los conjuntos de Mandelbrot y Julia, y de otros procesos iterativos complicados, todos de exquisito colorido. En su pequeña oficina californiana ofrecía diapositivas, grandes transparencias e incluso un calendario, del conjunto de Mandelbrot.
—Nuestro entusiasmo se relaciona con ese diferente modo de ver la naturaleza. ¿Cuál es el aspecto auténtico de un objeto natural? En un árbol, ¿qué importa más? ¿La línea recta o el objeto fractal?
En Cornell, mientras tanto, John Hubbard se enfrentaba con demandas comerciales. El departamento de ciencias exactas, que recibía centenares de cartas pidiendo imágenes del conjunto de Mandelbrot, comprendió que habría de proporcionar muestras y listas de precios. Ya habían calculado docenas de imágenes, almacenadas en sus ordenadores, a punto para ser exhibidas con la colaboración de los estudiantes graduados que recordaban los detalles técnicos. Pero las más espectaculares, las de presentación más clara y de colores más vívidos, se debieron a Peitgen, Peter H. Richter y su equipo científico de la universidad alemana de Bremen, que tenía el caluroso patrocinio de un banco local.
El matemático Peitgen y el físico Richter orientaron sus carreras hacia el conjunto de Mandelbrot. Encerraba un mundo de ideas para ellos: una moderna filosofía del arte, una justificación del nuevo papel de la experimentación en las ciencias exactas, y una manera de presentar los sistemas complejos al público general. Publicaron catálogos y libros de papel satinado, y recorrieron el mundo con una exposición de sus imágenes de ordenador. Richter había llegado a los sistemas complejos de la física por la senda de la química y la bioquímica, cuando estudió las oscilaciones biológicas. En artículos sobre fenómenos tales como el sistema inmunológico y la conversión del azúcar en energía por medio de la fermentación, llegó a la conclusión de que las oscilaciones regían a menudo la dinámica de procesos que solían considerarse estáticos, por la razón suficiente de que los sistemas vivos no pueden diseccionarse con facilidad para examinarlos en el tiempo real. Richter tenía sujeto al dintel de su ventana un péndulo doble bien aceitado, su «sistema dinámico favorito», que le habían hecho a petición suya en el taller de mecánica de la universidad. De cuando en cuando, le obligaba a adoptar no ritmos caóticos, que simulaba en un ordenador. La dependencia de las condiciones iniciales era tan sensitiva, que la tracción de la gravedad de una sola gota de lluvia, caída a más de un kilómetro y medio de distancia, hacía confuso el movimiento durante cincuenta o sesenta revoluciones, o sea en el espacio de unos dos minutos. Sus gráficos multicolores del espacio de fases del péndulo doble contenían regiones entremezcladas de periodicidad y caos. Utilizó las mismas técnicas gráficas para mostrar, por ejemplo, los campos idealizados de la magnetización en un metal, y para explorar el conjunto de Mandelbrot.
El estudio de la complejidad proporcionó a su colega Peitgen la ocasión de crear tradiciones en la ciencia, en vez de solventar únicamente problemas.
—En un área de nuevo cuño como ésta, uno puede dedicarse hoy a pensar y, si se es buen científico, a obtener una solución interesante en un par de días, una semana o en un mes —dijo Peitgen.
El asunto no estaba estructurado.
—En uno estructurado, se está al corriente de lo que se sabe, de lo que se ignora y de quién ha trabajado en él sin éxito. En ese caso, se ha de trabajar en un problema reconocido como tal, o si no, uno se extravía. Pero un problema de este género tiene que ser difícil, porque, de lo contrario, ya hubiese sido resuelto.
Peitgen no compartía la resistencia de los matemáticos a utilizar los ordenadores en pruebas experimentales. Concedía que todos los resultados debían adquirir rigor con los métodos corrientes de prueba, o no podría hablarse de matemáticas; pero la misma eficacia de la imagen tenía fuerza suficiente para modificar la evolución de las ciencias exactas. Peitgen estaba convencido de que la exploración con ordenador concedía a los matemáticos la libertad de seguir un camino más natural. Podrían prescindir con ella, temporalmente, del requisito de la prueba rigurosa. Así, como los físicos, iría a donde los experimentos le llevasen. La potencia de cálculo de los ordenadores, y sus estímulos visuales de la intuición, proponían vías prometedoras con las cuales el matemático evitaría los callejones sin salida. Luego, tras hallar nuevos caminos y aislar objetos nuevos, el matemático retornaría a las pruebas tradicionales.
—El rigor es el alma de las matemáticas —dijo Peitgen—. Sus cultivadores jamás renunciarán a un modo de pensar que brinda seguridad absoluta. Mas hay que aceptar situaciones que ahora se entienden parcialmente y que las futuras generaciones quizá entiendan con rigor. Lo admito, sin duda alguna, pero no hasta el punto de renunciar a algo, porque no puedo resolverlo ahora.
En la década de 1980, un ordenador doméstico efectuaba cálculos precisos que permitían obtener imágenes coloreadas del conjunto. Los aficionados no tardaron en comprobar que la exploración de imágenes cada vez más ampliadas proporcionaba una sensación vívida de escala en expansión. Si se pensaba en el conjunto como en un objeto de tamaño planetario, un ordenador personal podía mostrarlo entero, o presentarlo con las dimensiones de una ciudad, edificio, habitación, libro, letra, bacteria o átomo. Quienes contemplaban las imágenes advertían que todas las escalas, a pesar de ser diferentes, tenían pautas semejantes. Y todos aquellos paisajes microscópicos salían de las mismas pocas líneas de código de ordenador.[3]
§. Límites de cuencas fractales
El límite es donde un programa del conjunto de Mandelbrot pasa la mayor parte del tiempo y explota sus compromisos. En él, cuando no se interrumpen cien, mil o diez mil repeticiones, el programa no tendrá la seguridad de que un punto caiga dentro de la fase. ¿Quién sabe qué aportará la millonésima repetición? Por eso los programas que rendían las imágenes más asombrosas y más detalladamente ampliadas del conjunto se ejecutaban en ordenadores principales de gran resistencia, o en los dedicados a procesos paralelos, con millares de cerebros individuales, que efectuaban las mismas operaciones aritméticas en fase de bloque. Los puntos se escapaban más despacio, en el límite, de la fuerza del conjunto, como si vacilaran entre atractores contrarios, uno en cero y otro que llamaba al conjunto desde distancia infinita.
Cuando los científicos fueron del hallazgo de Mandelbrot al problema de representar los fenómenos físicos reales, las cualidades del límite del conjunto ocuparon el primer plano. El que había entre dos o más atractores, en un sistema dinámico, se presentó como una especie de umbral que existe, al parecer, en muchos procesos ordinarios, desde la rotura de materiales hasta la toma de decisiones. En tal sistema, cada atractor posee una cuenca, como las que recogen las aguas de los ríos. Y cada cuenca tiene un límite. Un campo desconocido y prometedor de las matemáticas y la física fue, al principio de los años ochenta, para un grupo influyente, el estudio de los límites de las cuencas fractales.
Esta rama de la dinámica no se interesaba en el comportamiento estable definitivo de un sistema, sino en cómo elegía éste una de las opciones que se le ofrecían. Uno, como el modelo ya clásico de Lorenz, tiene un solo atractor —un comportamiento que prevalece cuando el sistema se estabiliza—, y es caótico. Otros sistemas tal vez acaben en un comportamiento de estado estable no caótico, pero en más de un estado estable posible. El estudio de los límites de las cuencas fractales era el de los sistemas que finalizaban en uno de varios estados finales no caóticos, y proponía la cuestión de averiguar cuál era. James Yorke, que había iniciado aquella investigación a los diez años de dar nombre al caos, propuso un billar romano imaginario. Como casi todos estos juegos, tiene un tirador, provisto de un muelle, que se estira y se suelta para enviar la bola al campo. Éste está inclinado y tiene bordes elásticos y topes eléctricos, que proporcionan a la bola energía adicional. El impulso es importante, pues implica que la energía no se consume regularmente. En pro de la simplificación, el billar carece de aletas en la parte inferior, pero tiene dos rampas de salida. La bola ha de desaparecer por una de ellas.
Es un billar romano determinista, porque no sufre sacudidas. Un parámetro único rige el destino de la bola; es la posición inicial del tirador. Supóngase que la máquina está constituida de forma tal, que un tirón flojo hace siempre que la bola termine su carrera en la rampa de la derecha, y uno fuerte en la de la izquierda. En el período intermedio, el comportamiento es complicado, ya que la bola rebota en los topes con energía, ruido y lapso temporal variables, antes de elegir una salida. Imagínese que se indica con una línea el gráfico del resultado de cada posible posición de partida del tirador. Márquese un punto rojo cuando una posición lleve a una salida en la derecha, y uno verde en el caso de la izquierda. ¿Qué se averiguará sobre esos atractores como función de la posición inicial?
El límite es un conjunto fractal, no auto semejante por necesidad, pero infinitamente detallado. Algunas porciones de la línea aparecerán encarnadas o verdes, sin mezcla, y otras, cuando se amplían, muestran regiones encarnadas tachonadas de verde, o verdes tachonadas de encarnado. En algunas posiciones del tirador, un cambio leve no incluye diferencia alguna; en otras, un pequeño cambio arbitrario señalará una clara diferencia de color.

Límites de cuencas fractales.
Incluso cuando no es caótico el comportamiento a largo plazo de un sistema dinámico, el caos puede surgir en el límite que hay entre una clase de comportamiento estable y otra. A menudo un sistema dinámico tiene más de un estado de equilibrio, como el péndulo que puede detenerse en uno de los dos imanes colocados en su base. Cada equilibrio es un atractor. El límite entre dos atractores puede ser complicado, aunque regular (izquierda). O puede ser complicado e irregular. La mezcolanza enormemente fractal de blanco y negro (derecha) es el diagrama de un espacio de fases de un péndulo. El sistema alcanzará seguramente uno de dos estados estables posibles. Dadas ciertas condiciones iniciales, el resultado se predice bastante bien: negro es negro, y blanco, blanco. Pero, cerca del límite, la predicción es imposible.
Yorke mostró en conferencias imágenes de límites de cuencas fractales. Algunas representaban el comportamiento de péndulos forzados, que podían alcanzar uno de dos estados finales. Como su auditorio sabía, el péndulo forzado es un oscilador básico, que tiene muchos aspectos variables en la existencia cotidiana.
—Nadie podrá acusarme de que he influido fraudulentamente en el sistema al elegir un péndulo —dijo Yorke en tono jovial—. Cosas como él abundan en la naturaleza. Pero su comportamiento discrepa de cuanto figura en la bibliografía. Es fractal de género turbulento.
Las imágenes podían ser fantásticos torbellinos de blanco y negro, como si un cazo hubiese borbotado varias veces durante la fusión incompleta de leche y chocolate. Su ordenador las había hecho recorriendo una rejilla de mil puntos por lado, cada uno de los cuales representaba un punto de partida del péndulo, y había trazado el resultado en blanco y negro. Eran cuencas de atracción, barajadas y dobladas por las conocidas ecuaciones del movimiento newtoniano, y lo obtenido era sobre todo límite. Más de las tres cuartas partes de los puntos trazados estuvieron en el límite. Aquellas imágenes guardaban una lección para los investigadores e ingenieros, una lección y un aviso. Con demasiada frecuencia había que colegir, de una reducida colección de datos, el ámbito potencial del comportamiento de sistemas complejos. Cuando éste actuaba con normalidad, manteniéndose dentro de un espacio reducido de parámetros, los ingenieros llevaban a cabo sus observaciones y esperaban extrapolarlas, más o menos linealmente, a un comportamiento de regularidad inferior. Mas los científicos, con el estudio de los límites de las cuencas fractales, pusieron en evidencia que la frontera entre la calma y la catástrofe podía ser más complicada que lo que cabía imaginar.
—Toda la red eléctrica de la costa oriental es un sistema oscilatorio, casi siempre estable, y nos gustaría saber qué ocurre cuando se lo perturba —dijo Yorke—. Necesitamos conocer cuál es el límite. En realidad, nadie tiene idea de su aspecto. Los límites de las cuencas fractales planteaban graves cuestiones de física teórica. Las transiciones de fases se referían a umbrales y Peitgen y Richter examinaron una de las mejor estudiadas, la magnetización y la no magnetización de materiales. Sus imágenes mostraron la bella complejidad peculiar que empezaba a aceptarse como algo natural, figuras semejantes a coliflores, en las que aparecían protuberancias y surcos cada vez más enmarañados. Variaron los parámetros y aumentaron la ampliación de los detalles. Y se presentó una imagen, constantemente más sometida al azar, hasta que, de pronto, sin aviso, surgió; en el meollo de una región desconcertante, una forma conocida, de pelos deprimidos y tachonada de bultitos: el conjunto de Mandelbrot, sin que le faltase un zarcillo o un átomo. Era otro poste indicador de la universalidad. «Debiéramos creer en la magia», escribieron.
§. El juego del caos
Michael Barnsley siguió una trayectoria diferente. Pensó en las imágenes propias de la naturaleza, en especial en las que generaban los organismos vivos. Hizo experimentos con los conjuntos de Julia y ensayó otros procedimientos, en busca de medios que produjesen variabilidad aún mayor. Por último, recurrió al azar como base de una nueva técnica para simular figuras naturales. Cuando se refirió a ella por escrito, la llamó «construcción global de fractales mediante sistemas de función iterada». En cambio, cuando la mencionaba de palabra, la denominaba «juego del caos».
Para jugar a él con facilidad, se requiere un ordenador con una pantalla para gráficos y un generador de números aleatorios; pero, en principio, una hoja de papel y una moneda sirven. Se escoge un punto de partida en el papel. Cualquiera. Se inventan dos reglas, una para la cara y otra para la cruz. Una indica cómo se va de un punto a otro. «Muévase cinco centímetros al nordeste» o «Muévase un veinticinco por ciento más hacia el centro». Se tira la moneda al aire y se marcan los puntos, aplicando la regla de la cara cuando sale ésta y la de la cruz cuando es ésta la que aparece. Si se prescinde de los primeros cincuenta puntos, como la banca elimina las primeras cartas utilizadas en el juego de la veintiuna, se verá que el juego del caos no produce un campo de puntos dispersos, sino una figura, cuyos pormenores se precisan a medida que avanza la partida.
La percepción intelectual más importante de Barnsley fue que los conjuntos de Julia y otras formas fractales, aunque considerados justamente como el resultado de un proceso determinista, tenían una segunda existencia, asimismo válida, como límite de un proceso azaroso, aleatorio. Propuso, como analogía, un mapa imaginario de Gran Bretaña trazado con tiza en el suelo de una habitación. Costaría a un agrimensor medir con sus instrumentos habituales el área de las formas extravagantes, de costas fractales. Pero supóngase que se arrojan, uno tras otro, granos de arroz al aire, de suerte que caigan sin orden, y que se cuentan aquellos que quedan en el interior del mapa. Poco a poco, el resultado comienza a aproximarse al área de las figuras, como el límite de un proceso fortuito. En términos dinámicos, las figuras de Barnsley eran atractores.
El juego del caos explotaba una cualidad fractal de ciertas imágenes, la de que se componían de copias pequeñas de la principal. El establecimiento de reglas que debían repetirse al azar proporcionaba cierta información global sobre una figura, y la iteración de las reglas regurgitaba la información sin hacer caso de la escala. En este sentido, las reglas adecuadas serían tanto más sencillas cuanto más fractal fuese la figura. Barnsley descubrió en seguida que podía generar todos los fractales, ya clásicos, del libro de Mandelbrot, cuya técnica había sido una sucesión interminable de construcción y refinamiento. En cuanto al copo de nieve de Koch, o el tomador de Sierpiński, se sustituían los segmentos lineales por figuras especificadas. En cambio, con el juego del caos, Barnsley obtuvo formas que nacieron como parodias borrosas y se volvieron progresivamente más claras. No se necesitaba un proceso de refinamiento, sino unas cuantas reglas sencillas que, de alguna manera, incluían la forma definitiva.

El juego del caos.
Cada punto aparece al azar, pero, poco a poco, surge la imagen de un helecho. Toda la información necesaria se encuentra en escasas reglas sencillas.
El primer helecho, producido con un pequeño ordenador de mesa, correspondió exactamente con el que guardaba desde su infancia entre las páginas de un libro.
—Fue una imagen asombrosa, correcta en todos los extremos. Ningún biólogo habría vacilado en identificarlo.
La naturaleza, en cierta manera, aseguró Barnsley, se entretuvo con una versión especial del juego del caos.
—La espora que contiene el código genético de un helecho posee una cantidad precisa de información. Por consiguiente, la complicación con que un helecho se desarrolla tiene un límite. No sorprende, pues, que encontremos la información sucinta equivalente para describir esas plantas. Lo maravilloso sería lo contrario. Pero ¿era necesario el azar? Hubbard pensó en el paralelismo que había entre el conjunto de Mandelbrot y la codificación biológica de la información. Se amoscaba ante la más leve insinuación de que aquellos procesos dependieran de la probabilidad.
—No existe azar en el conjunto de Mandelbrot —afirmó—. No lo hay en las cosas que hago. Tampoco creo que la posibilidad de que haya azar tenga importancia directa para la biología. En ella, el azar es la muerte; en ella, el caos es la muerte. Todo está muy estructurado. Cuando se clonan plantas, las ramas salen en el mismo, idéntico, orden. El conjunto de Mandelbrot se atiene a un esquema extraordinariamente preciso que no da cabida a ninguna expresión del azar. Tengo la vehemente sospecha de que, si un día se averigua cómo está organizado el cerebro, se descubrirá con estupefacción que hay un esquema codificador, de enorme precisión, para formarlo. La idea de lo fortuito en biología es refleja.
El azar posee sólo valor instrumental en la técnica de Barnsley. Los resultados son deterministas y predecibles. Cuando un punto surge en la pantalla del ordenador, nadie adivina dónde aparecerá el siguiente: depende del recorrido de la imaginaria moneda interior de la máquina. Con todo, el flujo de la luz permanece siempre dentro de los límites imprescindibles para producir una figura en el fósforo. Hasta ese extremo el papel del azar es una ilusión.
—La casualidad es un trampantojo —dijo Barnsley—. Tiene importancia para obtener imágenes de cierta medida invariante, que viven en el objeto fractal; pero éste en sí no depende del azar. Con una probabilidad, siempre se obtiene la misma imagen. Sondar los objetos fractales, con un algoritmo fortuito, proporciona información recóndita, de la misma suerte que, cuando entramos en una habitación desconocida, nuestros ojos bailan de un sitio a otro de modo que podría describirse como pendiente del azar, y así tenemos una idea clara de cómo es esa estancia. Pero la habitación es lo que es. El objeto existe hagamos lo que hagamos.
El conjunto de Mandelbrot existe de la misma manera. Existía antes de que Peitgen y Richter se dedicaran a convertirlo en expresión artística; antes de que Hubbard y Douady entendieran su esencia matemática, y antes de que Mandelbrot lo descubriera. Existió en cuanto la ciencia creó un contexto: una noción de números complejos y de funciones iterativas. Entonces esperó que lo desvelasen. O acaso existió mucho antes, desde que la naturaleza se organizó mediante leyes físicas sencillas, repetidas con paciencia inagotable y sin modificarse jamás.
Capítulo 9
El colectivo de los sistemas dinámicos
La comunicación a través de la divisoria
revolucionaria es inevitablemente parcial.
THOMAS S. KUHN
§. Santa Cruz y la década de 1960§. Santa Cruz y la década de 1960
§. El ordenador analógico
§. ¿Qué es esta ciencia?
§. «Una visión de largo alcance»
§. La medida de la impredecibilidad
§. Teoría de la información
§. De la microescala a la macroescala
§. El grifo goteante
§. Ayudas audiovisuales
§. Finaliza una era
Santa Cruz era el campus más nuevo del sistema de la Universidad de California, tallado en un lugar paradisíaco a una hora de viaje, por el mediodía, de San Francisco. La gente comentaba que parecía más un parque nacional que un centro universitario. Los edificios descansaban entre secuoyas y, haciéndose eco del espíritu reinante, los proyectistas se habían desvivido por dejar intactos los árboles. Todos los lugares se enlazaban con estrechos senderos. El campus se hallaba en lo alto de un monte, y por ello se oteaba desde él, hacia el sur, el agua rizada y titilante de la bahía de Monterrey. Santa Cruz, inaugurada en 1966, en pocos años se convirtió en la más selecta y exigente de las universidades californianas. Los estudiantes se codeaban en ella con muchos ídolos de la vanguardia intelectual: Norman O. Brown, Gregory Bateson y Herbert Marcuse como catedráticos, y Tom Lehrer cantó en su recinto. Los departamentos de graduados, salidos de la nada, empezaron a funcionar con aspecto ambivalente, y el de física no fue excepción. La facultad —alrededor de quince físicos— era activa y la juventud preponderaba en ella, lo que convenía a la mescolanza de sobresalientes inconformistas atraídos por Santa Cruz. Influía en ellos la ideología librepensadora de la época; sin embargo, al propio tiempo, los físicos miraban al sur, al Caltech, al California Institute of Technology (Instituto de Tecnología de California), porque comprendían su necesidad de sentar objetivos y probar la seriedad de sus propósitos.
Un estudiante graduado, cuya seriedad nadie ponía en tela de juicio, era Robert Stetson Shaw, bostoniano barbudo procedente de Harvard, el mayor de los seis hijos de un médico y una enfermera. En 1977 estaba a punto de cumplir treinta y un años de edad. Aquello le hacía algo más viejo que la generalidad de sus compañeros, pues su estancia en Harvard había sido interrumpida varias veces por el servicio militar, la estancia en colectividades juveniles y otras experiencias caprichosas situadas entre aquellos dos extremos. Ignoraba por qué había ido a Santa Cruz. Jamás había visto el campus, aunque había examinado un folleto con fotografías de las secuoyas y retórica acerca del ensayo de una nueva filosofía didáctica. Shaw era tranquilo, retraído, de modo llamativo. Estudiaba bien y le faltaban contados meses para terminar su tesis doctoral sobre la superconductividad. A nadie extrañaba que invirtiese mucho tiempo en manejar un ordenador analógico, en la planta inferior del edificio de la facultad.
La educación de un físico estriba en un sistema de mentores y protegidos. Los profesores facultativos hacen que los auxiliares de investigación los ayuden en los laboratorios, o en la ejecución de cálculos aburridos. A cambio de ello, los estudiantes graduados y los posdoctorados consiguen algo de las subvenciones de sus superiores, y migas de sus méritos en las publicaciones. Un buen mentor coopera con el estudiante en la elección de problemas resolubles y fructíferos. Si la relación prospera, la influencia del profesor coadyuva a que su protegido logre un empleo. A menudo, los nombres de ambos quedan unidos para siempre. Pero, cuando una ciencia no existe, pocos son los dispuestos a enseñarla. El caos no tenía mentores en 1977. No había clases sobre él, ni centros de estudios no lineales y de exploración de los sistemas complejos, ni libros de texto acerca del caos, ni revistas especializadas en su tratamiento y difusión.
§. El ordenador analógico
William Burke, cosmólogo y relativista de Santa Cruz, encontró a su amigo el astrofísico Edward A. Spiegel, a la una de la madrugada, en el vestíbulo del hotel de Boston, donde asistían a una conferencia sobre la relatividad general.
— ¡Eh! Acabo de escuchar el atractor de Lorenz —dijo Spiegel.
Había transmutado aquel emblema del caos, con un circuito improvisado conectado a un aparato de alta fidelidad, en una anti melodía recurrente, en un pitido. Convidó a Burke a tomar una copa en el bar y le dio explicaciones.
Spiegel conocía a Lorenz personalmente y estaba enterado de la existencia del caos desde los años sesenta. Sus estudios se habían centrado en la búsqueda de la posibilidad de comportamiento irregular en modelos del movimiento de las estrellas. Se relacionaba con los matemáticos franceses. Por fin, siendo profesor en la Universidad de Columbia, encaminó su investigación astronómica a la turbulencia en el espacio, a las «arritmias cósmicas». Tenía la virtud de seducir a sus colegas con ideas nuevas, y a medida que avanzó la noche, cautivó a Burke, que estaba abierto a cuestiones como aquélla. Había ganado reputación por sus trabajos sobre uno de los regalos más paradójicos que Einstein había hecho a la física: la noción de las ondas de gravedad rizando el cuerpo del espacio-tiempo. Era un problema sumamente no lineal, con irregularidades extravagantes, emparentadas con las turbadoras no linealidades en la dinámica de los fluidos. Abstracto y teórico, Burke sentía, no obstante, afición a la física práctica, tanta que había publicado un artículo sobre las jarras de cerveza: qué grosor se podía dar al vidrio conservando la apariencia de contener una buena medida de líquido. Le complacía referirse a sí mismo como una manifestación del atavismo que consideraba la física como algo real. Había leído en Nature el artículo en que Robert May solicitaba más educación sobre los sistemas no lineales sencillos, y había dedicado unas horas a revisar las ecuaciones de May con una calculadora. Por eso, se le antojó interesante el atractor de Lorenz. No tenía la intención de escucharlo. Quería verlo. De regreso a Santa Cruz, entregó a Rob Shaw un trozo de papel en que había garrapateado tres ecuaciones diferenciales. ¿Podía introducirlas en el ordenador analógico?
En la evolución de la informática, las máquinas analógicas representaban un callejón sin salida. No se admitían en los departamentos de física, y su presencia en Santa Cruz se debía a la casualidad: los proyectos originales habían incluido una facultad de ingeniería; cuando ésta se eliminó, un entusiasta agente de compras ya había adquirido algunos artículos. Los ordenadores digitales, provistos de circuitos que se interrumpían y tornaban a ponerse en marcha, cero o uno, no o sí, daban respuestas concretas a las preguntas de los programadores, y parecían más accesibles a la miniaturización y aceleración de la tecnología que reinaba en la revolución informática. Cuanto se ejecutaba en un ordenador digital podía repetirse con el mismo resultado, y en principio podía remediarlo cualquier otra máquina digital. Por su diseño, los analógicos eran indefinidos, borrosos. Su construcción no incluía interruptores afirmativos-negativos, sino circuitos electrónicos, con resistencias y condensadores, que reconocía quien hubiese jugado con radios en la era anterior al estado sólido, como Shaw había hecho. La máquina de Santa Cruz era un Systron-Donner, pesado y polvoriento, con un tablero delantero semejante a los utilizados en los antiguos cuadros telefónicos de distribución. La programación de un ordenador analógico consistía en seleccionar componentes electrónicos y enchufar cables en el tablero de mando.
Un programador, con distintas combinaciones de circuitos, simula sistemas de ecuaciones diferenciales de modo muy conveniente para los problemas de ingeniería. Si se desea simular una suspensión de automóvil, con muelles, amortiguadores y masa para diseñar una progresión suave y sin saltos, las oscilaciones de los circuitos se hacen coincidir con las del sistema físico. Un condensador ocupa el lugar de un muelle, los inductores representan la masa, etc. Los cálculos carecen de precisión. Se elude la computación numérica. A cambio, se dispone de un modelo compuesto de metal y electrones, bastante rápido y —lo mejor de todo— fácilmente ajustable. Moviendo los mandos, se acomodan las variables para que el muelle sea más fuerte o la fricción más débil. Y se observa cómo cambian los resultados, en tiempo real, gracias a las pautas que aparecen en la pantalla de un osciloscopio.
En las plantas altas, en el laboratorio de superconductividad, Shaw se encaminaba, de modo inconexo, al final de la obra de su tesis. Empezó, sin embargo, a dedicar más horas a entretenerse con el Systron-Donner. Avanzó hasta ver retratos del espacio de fases de algunos sistemas simples, tales como representaciones de órbitas periódicas o ciclos límites. Las ecuaciones de Lorenz, que le habían entregado en un pedazo de papel, no eran más complicadas que los sistemas con que se había solazado. Le llevó escaso tiempo acertar con las clavijas oportunas y ajustar los mandos. Minutos después, Shaw supo que jamás concluiría su tesis sobre la superconductividad.
Pasó varias noches en el sótano, observando el punto verde del osciloscopio que se agitaba en la pantalla. Trazó reiteradamente la característica faz de búho del atractor de Lorenz. El flujo de la figura persistía en la retina, parpadeaba y revoloteaba, y no se parecía a nada de lo que Shaw había encontrado en su investigación. Parecía disfrutar de vida propia. Retenía la mente como una llama, surgiendo en pautas que nunca se reproducían exactamente. La imprecisión y la escasa respetabilidad del ordenador analógico fueron una ventaja para Shaw. En seguida notó la dependencia sensitiva de las condiciones iniciales, la misma que había persuadido a Edward Lorenz de lo fútil de los pronósticos del tiempo atmosférico a largo plazo. Establecía las condiciones iniciales, oprimía la tecla de partida y se presentaba el atractor. Después repetía las mismas condiciones iniciales —dentro de lo físicamente posible—, y la órbita se alejaba sin remordimientos de su curso precedente, no obstante lo cual acababa en idéntico atractor.
Shaw había tenido en su infancia ilusiones sobre la ciencia: se lanzaría románticamente al seno de lo desconocido. Aquélla era, por fin, una exploración de acuerdo con sus ilusiones. La física de la baja temperatura divertía al aficionado al manejo de aparatos, pues empleaba muchas cañerías, grandes imanes, helio líquido y discos graduados. Pero Shaw no veía que le llevase a ninguna parte. Pronto trasladó el ordenador analógico a su lugar de trabajo, que jamás volvió a utilizar en pro de la superconductividad.
§. ¿Qué es esta ciencia?
—Cuanto hay que hacer es posar las manos en esos mandos, y de repente exploras ese otro mundo como uno de los primeros viajeros, y no quieres abandonarlo —dijo Ralph Abraham, profesor de matemáticas que se presentó casi al comienzo para contemplar el atractor de Lorenz en acción.
Había estado con Steve Smale, en Berkeley, en los gloriosísimos días inaugurales, y era, por ende, uno de los pocos miembros de la facultad de Santa Cruz con los antecedentes requeridos para comprender el significado de los juegos de Shaw. Le sorprendió ante todo la velocidad de la manifestación, y Shaw le comentó que usaba condensadores de más para impedir que surgiera más aprisa. Encima, el atractor era robusto. Lo probaba la imprecisión de los circuitos analógicos: la afinación y el retoque de los mandos no la borraban, no la convertían en algo pendiente de la casualidad; antes bien, le daban otra dirección o la doblaban, de forma que adquirió sentido lentamente.
—Rob tuvo la experiencia espontánea de que una leve exploración le revelase todos los secretos —comenzó Abraham—. Todos los conceptos importantes, el exponente de Lyapunov y las dimensiones fractales, entre otros, se le ocurrían a uno con total naturalidad. Se veía y se empezaba a explorar.
¿Era ciencia aquello? Tal trabajo con ordenador, sin formalismos ni pruebas, no merecía llamarse matemáticas, lo que no alteró el apoyo simpatizante de personas como Abraham. La facultad de física no encontró motivos para aceptarlo como parte de su especialidad. Fuese lo que fuere, atrajo visitantes. Shaw solía dejar abierta la puerta de su estudio, y la entrada del departamento de física se hallaba al otro lado del vestíbulo. Hubo notable tráfico de curiosos. Y no transcurrió mucho tiempo antes de que tuviera colaboradores.
El grupo, que se autodenominó «colectivo de los sistemas dinámicos» —otros lo denominaron «camarilla del caos»—, dependía de Shaw como centro imperturbable, pero adolecía de alguna timidez en presentar sus ideas en el mercado académico. Por suerte para él, sus nuevos asociados no eran tan pudibundos. Mientras tanto, escucharon a menudo el criterio firme de Shaw de cómo se cumplía un programa improvisado para explorar una ciencia no admitida como tal.
Doyne Farmer, tejano alto, anguloso y pelirrojo, se transformó en el portavoz más expresivo del grupo. En 1977 tenía veinticuatro años de edad, y era la personificación de la energía y el entusiasmo, una máquina de ideas. Quienes le conocían pensaban al pronto, en ocasiones, que su conducta no pasaba de pura fachenda. Norman Packard, tres años menor que él, era amigo suyo desde la adolescencia. Habían crecido en la misma ciudad de Nuevo México, Silver City. Packard había llegado a Santa Cruz aquel otoño en que Farmer pensaba dedicar, durante un curso, toda su energía a las leyes del movimiento aplicadas al juego de la ruleta. La empresa era tan formal como traída por los cabellos. Durante más de una década, Farmer y un cambiante equipo de colegas físicos, jugadores profesionales y mirones, persiguieron el sueño de la ruleta. Farmer no renunció a él ni siquiera cuando se incorporó a la Sección Teórica de Los Alamos National Laboratory. Calcularon velocidades y trayectorias, escribieron y volvieron a escribir estudios lógicos, escondieron calculadoras en zapatos e hicieron nerviosas apariciones en casinos de juego. Hubo períodos en que todos los miembros del colectivo, excepto Shaw, se concentraron en la ruleta. Debe señalarse que el proyecto les proporcionó adiestramiento inusual en análisis raudo de los sistemas dinámicos, pero apenas tranquilizó al claustro de la facultad de física de Santa Cruz sobre la seriedad de los propósitos científicos de Farmer.
El cuarto miembro del colectivo fue James Crutchfield, el más joven y el único nativo de California. Era bajo y de constitución hercúlea, elegante windsurfista y, lo que valía más aún para el grupo, maestro instintivo en el arte de los ordenadores. Ingresó en Santa Cruz como estudiante ordinario, trabajó como ayudante de laboratorio en los experimentos de la superconductividad de Shaw, antes de que éste descubriera el caos, estuvo durante un año yendo, «por encima del monte», como decían en la universidad, a un centro de investigación de la IBM, donde había logrado un empleo, y no se incorporó al departamento de física como estudiante graduado hasta 1980. Por entonces llevaba dos años en el laboratorio de Shaw, durante los cuales se dio prisa en aprender las matemáticas necesarias para entender los sistemas dinámicos. Como sus compinches, se olvidó por completo de la orientación clásica de la facultad.
Hasta la primavera de 1978, el departamento no se convenció de que Shaw había renunciado a su tesis sobre la superconductividad. Le faltaba tan poco para concluirla… No obstante su aburrimiento, la facultad pensó que podía acelerar las formalidades, doctorarse y entrar en el mundo real. Respecto al caos, había cuestiones de decoro académico. Nadie estaba cualificado en Santa Cruz para supervisar un estudio de aquella materia innominada. Jamás se había doctorado alguien en ella. No había empleos a disposición de graduados en aquella especialidad. No había que olvidar lo monetario. La física de Santa Cruz, como la de todas las universidades estadounidenses, era financiada sobre todo por la National Science Foundation y otros entes del gobierno federal, que concedían fondos de investigación a los miembros de la facultad. La marina, la fuerza aérea, el Ministerio de Energía y la CIA gastaban enormes sumas de dinero en la investigación pura, sin sentir necesariamente preocupación por su aplicación inmediata a la hidrodinámica, aerodinámica, producción energética y espionaje. Un físico facultativo recibía fondos suficientes para pagar el equipo del laboratorio y los salarios de los ayudantes de investigación, estudiantes graduados que salían gracias a ello bien beneficiados. Así costeaban sus fotocopias y sus viajes a los congresos, e incluso disponían de estipendios que les permitían sobrevivir en verano. Si no mediaban tales providencias, el estudiante andaba a la deriva. Tal era el sistema al que renunciaron Shaw, Farmer, Packard y Crutchfield.
Cuando empezaron a desaparecer de noche diversos elementos electrónicos, fue aconsejable buscarlos en el antiguo laboratorio de temperatura baja de Shaw. De tarde en tarde, un miembro del colectivo conseguía mendigando cien dólares de la asociación de estudiantes graduados, o el departamento de física encontraba un procedimiento para consignar una cantidad análoga. Así se acumularon trazadores, convertidores y filtros electrónicos. Un grupo de físicos subatómicos, situado al otro lado del vestíbulo, había condenado a la basura un pequeño ordenador digital, y encontró asilo en el laboratorio de Shaw. Farmer se transformó en especialista sobresaliente en sisar tiempo de ordenador. Le invitaron un verano al National Center for Atmospheric Research (Centro Nacional de Investigación Atmosférica) de Boulder (Colorado), en el que ordenadores gigantes se encargan del estudio de materias tales como la simulación del tiempo global. Su habilidad para ordeñar minutos costosísimos de aquellas máquinas en beneficio propio dejó atónitos a los climatólogos.
También les fue muy útil la destreza manipuladora característica de Santa Cruz. Shaw era un «manitas» desde su infancia. Packard había arreglado televisores en Silver City desde que salió de la niñez. Crutchfield pertenecía a la primera generación de matemáticos para quienes la lógica de los procesadores era como la lengua materna. El edificio de la facultad, entre las umbrosas secuoyas, se parecía a todas las construcciones destinadas al cultivo de la física, ambiente universal de suelos de cemento y paredes que pedían a gritos una capa de pintura; pero la habitación que el colectivo había ocupado desarrolló una atmósfera propia, con rimeros de papeles y fotografías tahitianas en los tabiques, y, más tarde, láminas de atractores extraños. A cualquier hora del día, aunque más por la noche que por la mañana, el visitante encontraba a los miembros del grupo repasando circuitos, arrancando cordones de remiendo, discutiendo sobre la consciencia o la evolución, ajustando la pantalla de un osciloscopio o, sencillamente, prendidos de un reluciente punto verde que trazaba una curva luminosa, y la órbita del cual parpadeaba y se agitaba como algo vivo.
§. «Una visión de largo alcance»
—Nos unió lo mismo: la idea de que había determinismo, pero que no era real —dijo Farmer—. Nos intrigaba la noción de que todos los sistemas deterministas clásicos que habíamos estudiado producían azar. Nos sentimos obligados a comprender la razón de aquel fenómeno.
»Sólo se percibe la fuerza de esa clase de revelación cuando se ha sufrido durante seis o siete años el lavado de cerebro de un programa típico de física. Se nos enseña que hay modelos clásicos en que las condiciones iniciales determinan todo, y que hay también modelos de mecánica cuántica en que las cosas están determinadas, pero, en ellos, debemos enfrentarnos con la cortapisa de cuánta información inicial podemos reunir. No lineal es una expresión que sólo encontrábamos al final del libro de texto. El estudiante de física seguía un curso de matemáticas y la ultimísima lección se refería a ecuaciones no lineales. Por lo general, se pasaban por alto, y, si no se omitían, se contentaban con reducirlas a ecuaciones lineales, de modo tal que se obtenían las soluciones aproximadas. Era un ejercicio de frustración.
»Carecíamos del concepto de la importante diferencia que la no linealidad introduce en un modelo. Emocionaba la idea de que una ecuación brincara de allá para acá de forma aparentemente sujeta al azar. Y nos preguntábamos: “¿De dónde sale este movimiento fortuito? No lo encuentro en las ecuaciones”. Parecía algo gratuito o algo brotado de la nada.
Crutchfield dijo:
—Fue advertir que existe todo un ámbito de la experiencia física que no encaja en el marco corriente. ¿Por qué no formaba parte de lo que nos enseñaban? Teníamos la ocasión de inspeccionar el mundo inmediato, uno tan cósmico que maravillaba y también la de entender algo.
Les encantaba —y desconcertaba a sus profesores— abordar cuestiones sobre el determinismo, la naturaleza de la inteligencia y el sentido de la evolución biológica.
—El lazo que nos unía era una visión de largo alcance —explicó Packard—. Nos asombraba que, avanzando algo más en el parámetro espacial, en los sistemas regulares, que la física clásica ha analizado hasta el agotamiento, se halla algo a lo que no podía aplicarse aquella mole colosal de análisis.
»Hace mucho, muchísimo tiempo, pudo descubrirse el fenómeno del caos. Pero no ocurrió, en parte porque la enorme masa de investigaciones sobre la dinámica del movimiento regular no condujo en esa dirección. Más ahí está, si se mira bien. Debíamos permitir que nos guiase lo físico, las observaciones, para comprobar qué clase de imagen teórica desarrollaríamos. A la larga, interpretamos la investigación de la dinámica complicada como punto de partida que tal vez nos llevase a la comprensión de dinámicas sumamente complejas.
Farmer expuso:
—Desde el punto de vista filosófico, se me antojó que era un medio operativo de definir el libre albedrío, uno que permitía conciliar éste con el determinismo. El sistema es determinista, pero no se puede decir qué hará a continuación. Al propio tiempo, siempre sentí que los problemas trascendentales del mundo tenían que ver con la organización, tanto de la vida como de la inteligencia. Pero ¿cómo se estudiaba eso? Lo que hacían los biólogos parecía muy apropiado y específico; los químicos no lo hacían, desde luego; los matemáticos no soñaban en hacerlo, y era algo que los físicos jamás hacían. He pensado siempre que la aparición espontánea de la autoorganización debía formar parte de la física. Teníamos una moneda con sus dos caras. Aquí había orden, en el que brotaba el azar, y allí, un paso más adelante, había azar, en el que el orden subyacía.
§. La medida de la impredecibilidad
Shaw y sus compañeros convertirían la materia prima de su entusiasmo en programa científico. Tenían que formular preguntas que pudieran contestarse, y que fueran dignas de ello. Buscaron procedimientos para enlazar lo teórico y lo experimental, porque, creían, aquélla era la grieta que debía colmarse. Pero antes de empezar, habían de enterarse de lo que se sabía y de lo que se ignoraba, y sólo eso representaba una tarea formidable.
Estorbó su intento la tendencia de la comunicación científica a transmitirse a fragmentos, sobre todo cuando un tema nuevo surge en las subdisciplinas establecidas. A menudo desconocían si pisaban territorio inexplorado o ya hollado. Antídoto inapreciable de su ignorancia fue Joseph Ford, abogado del caos en el Georgia Institute of Technology. Había decidido que la dinámica no lineal era el futuro de la física —todo el futuro—, y se había auto designado algo así como una cámara informativa de liquidación. Cumplía su cometido con la publicación de artículos. Sus antecedentes se encontraban en el caos no disipativo, el de los sistemas astronómicos o de la física subatómica. Gozaba de un conocimiento nada común del trabajo de la escuela soviética, y se impuso como meta relacionarse con las personas que compartieran, aun remotamente, el espíritu filosófico de la nueva empresa. Tenía amigos en todas partes. Cualquier científico que publicara un artículo sobre la ciencia no lineal podía confiar en que su trabajo quedaría resumido en la creciente lista de extractos de Ford. Los estudiantes de Santa Cruz se enteraron de ella e idearon un modelo estereotipado de postal para solicitar copias de los artículos antes de que se publicasen. Inmediatamente las recibieron en gran cantidad.

Plegamiento del espacio de fases.
La reforma topológica del espacio de fases crea un atractor, como una rosquilla, pero plegada sobre sí misma, que recibe el nombre de «barquillo de Birkhoff».
El físico se propone medir. ¿Qué podía medirse en aquellas figuras, móviles y elusivas? Shaw y sus camaradas intentaron aislar las cualidades especiales que daban tanto encanto a los atractores extraños. Dependencia sensitiva de las condiciones iniciales, la tendencia a apartarse de las trayectorias cercanas. Aquella cualidad convenció a Lorenz de la imposibilidad de pronosticar el tiempo atmosférico a largo plazo. Pero ¿con qué compás de calibres se escantillaba tal cualidad? ¿Podía medirse la impredecibilidad?
Se tenía la respuesta a esta pregunta en una concepción rusa, en el exponente de Lyapunov. Este número proporcionaba una medida precisa de cualidades topológicas correspondientes a conceptos tales como la impredecibilidad. Los exponentes de Lyapunov, en un sistema, pertrechaban de un método para medir los efectos antagónicos de estirar, contraer y plegar en el espacio de fases de un atractor. Suministraban una imagen de todas las propiedades de un sistema, las cuales culminaban en la estabilidad o la inestabilidad. Un exponente mayor que cero equivalía a estirar, es decir, los puntos próximos se separarían. Uno menor que cero, a contraer. En un atractor de punto fijo, todos los exponentes eran negativos, puesto que el esfuerzo se dirigía al interior, al estado estable final. Un atractor en forma de órbita periódica tenía un exponente de cero exacto, y los demás resultaban negativos. Se averiguó que un atractor extraño había de tener, cuando menos, un exponente positivo de Lyapunov.
Los estudiantes de Santa Cruz sufrieron la mortificación de no haber inventado aquella idea, pero la desarrollaron del modo más práctico posible, aprendiendo a medir los exponentes de Lyapunov y a relacionarlos con otras cualidades importantes. Recurrieron al movimiento informático para hacer películas que ilustraran la pulsación del orden y el caos en sistemas dinámicos. Su análisis mostró vívidamente que unos creaban desorden en una dirección, y permanecían correctos y metódicos en otra. Una película presentó lo que fue un cúmulo minúsculo de puntos próximos —representantes de las condiciones iniciales—, de un atractor extraño, mientras el sistema evolucionaba temporalmente. El cúmulo se extendió y se salió de foco. Se transformó en un punto grueso y, luego, en una mancha. Ésta se extendía en cierta clase de atractores, que se destacaban por su eficacia en mezclarse. En otros, la diseminación sucedía sólo en determinadas direcciones. La mancha se trocaba en banda, caótica en el sentido de un eje y ordenada en el de otro. Era como si el sistema poseyera a la vez un impulso ordenado y otro desordenado. Y había duplicaciones. Mientras un impulso producía impredecibilidad fortuita, el otro obedecía al tiempo como un reloj de precisión. Y ambos eran definibles y mensurables.
§. Teoría de la información
La impronta más característica de los estudiosos de Santa Cruz en el caos afectó a una muestra de matemáticas y filosofía denominada teoría de la información. La inventó, a fines de la década de 1940, Claude Shannon, investigador de los Bell Telephone Laboratories. Dio a su obra el título de The Mathematical Theory of Communication (Teoría matemática de la comunicación), que, como concernía a una entidad bastante particular llamada información, se conoció en adelante como teoría de la información. Fue producto de la era electrónica. Las líneas de comunicación y las transmisiones de radio transportaban cierta cosa que los ordenadores pronto almacenarían en fichas perforadas o en cilindros magnéticos, y la cosa no era conocimiento ni significado. Sus unidades básicas no se componían de conceptos, ideas, palabras o números. Sería o no sería una insensatez, pero los ingenieros y matemáticos tenían la posibilidad de medirla, transmitirla y comprobar lo correcto de su transmisión. Información fue un nombre tan bueno como cualquier otro, mas la gente debía recordar que usaba un vocablo libre de significado, sin las connotaciones corrientes de hechos, erudición, sabiduría, comprensión e ilustración.
El equipo físico o hardware determinaba la forma de la teoría. Como la información se almacenaba en interruptores binarios, que recibían la denominación reciente de bits, se convirtieron en la medida fundamental de la información. Desde el punto de vista técnico, la teoría se transformó en un medio de entender cómo los ruidos parásitos, con la apariencia de errores fortuitos, se entremetían en el flujo o secuencia de los bits. Suministró un método para pronosticar la capacidad de transporte de las líneas de comunicación, discos compactos o cualquier técnica que registrase lenguaje, sonidos o imágenes. Ofreció medios teóricos para calcular la efectividad correctora de errores de los distintos esquemas; por ejemplo, emplear bits para verificar otros. Atacaba de lleno la noción básica de «redundancia». Según la teoría de Shannon, el lenguaje ordinario contiene algo más del cincuenta por ciento de elementos redundantes, sonidos o letras innecesarios para transmitir un mensaje. Se trata de una idea bastante generalizada; la comunicación, en un mundo de personas que mascullan las palabras y de errores tipográficos, depende de la redundancia. Lo ilustraba el famoso anuncio de la enseñanza de la taquigrafía —si std pd Ir st mnsj…—, y la teoría de la información permitía medirlo. La redundancia es una desviación pronosticable del azar. Parte de ella, en el habla ordinaria, radica en el significado, y la cantidad de esa parte se expresa con dificultad, puesto que estriba en el conocimiento del lenguaje y del mundo que la gente comparte. Eso permite resolver las palabras cruzadas o completar idealmente una frase inacabada. Había, no obstante, redundancias de otra clase, más accesibles a las medidas numéricas. Estadísticamente, la probabilidad de que, en inglés, una letra sea «e» supera la proporción de uno a veintiséis. Además, las letras no deben contarse como unidades aisladas. Saber que una, en un texto anglosajón, es «t» ayuda a predecir que la siguiente será «h» u «o». Auxilia más aún conocer dos, etc. La tendencia estadística de varias combinaciones de dos y tres letras a aparecer en un lenguaje sirve de gran ayuda para captar alguna esencia característica de éste. El ordenador que se guíe sólo por la relativa probabilidad de las secuencias posibles de tres letras produce, llegado el caso, una corriente fortuita de disparates reconocible como inglesa. Los criptólogos hace mucho tiempo que recurren a tales pautas estadísticas para descifrar códigos secretos sencillos. Los ingenieros de comunicaciones las emplean ahora para ingeniar técnicas de condensación de datos, con el fin de eliminar la redundancia en provecho del ahorro de espacio en una línea de transmisión, o en un disco de almacenamiento. A juicio de Shannon, el modo correcto de considerar aquellas pautas era el siguiente: una corriente de datos, en el lenguaje ordinario, no depende por completo del azar; cada bit está obligado por los anteriores; por ello, cada uno nuevo contiene algo menos del valor de un bit, en cuanto a información real. Esta formulación encerraba un atisbo de paradoja: cuanto más dependiera del azar una corriente de datos tanta más información aportaría cada bit nuevo.
Aparte de su utilidad técnica en el comienzo de la era de los ordenadores, la teoría de Shannon cobró modesta talla filosófica. Una porción del atractivo que ejerció sobre personas ajenas a la informática pudo atribuirse a la elección de un vocablo: entropía. Como Warren Weaver expresó en una exposición clásica de la teoría de la información: «Cuando encuentra el concepto de entropía en la teoría de la comunicación, uno tiene derecho a sentir alguna excitación, tiene derecho a sospechar que ha encontrado algo que acaso sea fundamental e importante». El concepto procede de la termodinámica, en la que aparece como aditamento a la segunda ley: la tendencia inexorable del universo, y de todo sistema aislado que haya en él, a encaminarse a un estado de desorden creciente. Divídase una piscina por la mitad con una barrera; llénese una parte de agua y otra de tinta; espérese a que se aquieten; retírese la barrera; por el movimiento azaroso de las moléculas, el agua y la tinta acabarán por mezclarse. La mezcla jamás se invierte, aunque se espere hasta el fin del cosmos, razón por la cual se dice tan a menudo que la segunda ley es la parte de la física que convierte el tiempo en calle de dirección única. La entropía define la cualidad de los sistemas que aumenta según dicha ley: mescolanza, desorden, azar. El concepto es más fácil de comprender intuitivamente que de medir en cualquier situación de la vida real. ¿Cómo se efectuará una comprobación fidedigna del índice de mezcla de dos sustancias? Quizá contando las moléculas de cada una. ¿Y si se dispusieran en sí-no-sí-no-sí-no-sí-no? A duras penas la entropía se consideraría intensa. Se podrían contar las moléculas pares. ¿Y si la disposición fuese sí-no-no-sí-sí-no-no-sí? El orden se entromete de suerte que disminuye la eficacia de todo algoritmo honrado. Y, en la teoría de la información, las cuestiones de significado y representación incluyen complicaciones adicionales. Una serie como 01 0100 0100 0010 111 010 11 00 000 0010 111 010 11 0100 0 000 000…, parecerá ordenada sólo al observador familiarizado con el alfabeto Morse y Shakespeare. ¿Y qué pensar de las pautas, topológicamente perversas, de un atractor extraño?
Éstos eran máquinas de información para Robert Shaw. En su primera y más ambiciosa concepción, el caos brindaba la oportunidad lógica de devolver a las ciencias físicas, en forma revigorizada, las ideas que la teoría de la información había tomado de la termodinámica. Los atractores extraños, por unir orden y desorden, daban un sesgo desafiante a la cuestión de medir la entropía de un sistema. Algunos eran mezcladores eficientes. Creaban impredecibilidad. Suscitaban entropía. Y, en opinión de Shaw, proporcionaban información donde no existía.
Norman Packard, mientras leía cierto día la revista Scientific American, notó el anuncio de un concurso de ensayos llamado Certamen de Louis Jacot. Parecía bastante disparatado: un premio lucrativo, dotado por un financiero francés, que había criado a sus pechos una teoría sobre la estructura cósmica, galaxias dentro de galaxias. Proponía ensayos sobre el oscuro tema de Jacot. («Sonaba a cosa de chiflados», dijo Farmer). Pero el jurado del certamen era un catálogo de nombres impresionantes de científicos franceses, y el galardón monetario no le iba a la zaga. Packard mostró el anuncio a Shaw.
El día final del plazo de presentación de originales era el de año nuevo de 1978.
En aquellas fechas el colectivo se reunía con regularidad en un enorme caserón de Santa Cruz, a poca distancia de la playa. El edificio acumulaba mobiliario, adquirido en los traperos, y un equipo de ordenador, mucho del cual se consagraba al problema de la ruleta. Shaw disponía de un piano, en el que interpretaba música barroca o improvisaba combinaciones particulares de la clásica y la moderna. Los físicos, en sus encuentros, crearon un estilo propio de trabajo, una rutina de proponer ocurrencias y cribarlas con el tamiz del sentido práctico, de leer la bibliografía y concebir artículos originales. Habían aprendido a colaborar en las revistas con artículos que firmaban por orden rotatorio. El inicial fue de Shaw, uno de los pocos que escribiría, y que siguió escribiendo mentalmente, rasgo suyo muy característico. Y, también característicamente, lo envió demasiado tarde.
En el mes de diciembre de 1977, Shaw se fue de Santa Cruz para asistir a la primera reunión de la New York Academy of Sciences (Academia de Ciencias de Nueva York) dedicada al caos. Financió el viaje su profesor de superconductividad. Shaw, sin haber sido invitado, escuchó en carne y hueso a quienes conocía por sus escritos. David Ruelle. Robert May. James Yorke. Se sintió intimidado no sólo por aquellas personalidades, sino también por el astronómico precio de treinta y cinco dólares que pagó por su habitación del Barbizon Hotel. Mientras atendía a las charlas, se balanceó entre la sensación de que había reinventado, en su ignorancia, cosas que aquellos hombres habían estudiado muy a fondo, y la de que él podía contribuir a ellas con un importante y nuevo punto de vista. Llevaba consigo el borrador inconcluso de su artículo sobre la teoría de la información, papeles garrapateados, metidos en una carpeta, y buscó en vano un mecanógrafo en el hotel y luego en los talleres de reparación de máquinas de escribir. Por último, renunció a su intento. Más tarde, cuando sus amigos quisieron saber detalles de la conferencia, les explicó que el punto culminante había sido el banquete en honor de Edward Lorenz, quien recibía el reconocimiento que se le había negado durante tantos años. Lorenz entró en el comedor, cogido tímidamente de la mano de su esposa, y los científicos se pusieron de pie para dedicarle una ovación. La expresión de espanto del meteorologista chocó a Shaw.
A las pocas semanas, durante un viaje a Maine donde sus padres tenían una casa de recreo, remitió por fin su artículo al Certamen Jacot. Había pasado ya el día de año nuevo, pero el empleado de correos estampó en el sobre una generosa fecha atrasada. El artículo —mezcla de matemáticas esotéricas y filosofía especulativa, ilustrada con dibujos de su hermano Chris, semejantes a los de historietas— obtuvo mención honrosa. Shaw recibió un premio en metálico suficiente para trasladarse a París y recoger el galardón. No fue un éxito importante, pero llegó cuando eran tensas las relaciones del colectivo con la facultad. Necesitaba desesperadamente todos los signos de credibilidad que pudieran encontrar. Farmer renunciaba a la astrofísica, Packard abandonaba la mecánica estadística y Crutchfield no estaba aún preparado para convertirse en estudiante graduado. El claustro pensaba que la situación se había salido de madre.
§. De la microescala a la macroescala
«Strange Attractors, Chaotic Behavior, and Information Flow» (Atractores extraños, comportamiento caótico y flujo de información) circuló aquel año en una edición preliminar, que ascendió, con el tiempo, a mil ejemplares, y fue el trabajoso esfuerzo que trabó, por primera vez, la teoría de la información con el caos.
Shaw extrajo de las sombras supuestos de la mecánica clásica. La energía existe en los sistemas naturales en dos niveles: las macroescalas, en que se cuentan y miden los objetos cotidianos, y las microescalas, en que innúmeros átomos se agitan al azar, movimiento inmensurable, salvo como una entidad promedia, la temperatura. Como Shaw advirtió, la energía total de las microescalas podía superar la de las macroescalas, pero ese movimiento térmico carecía de importancia en los sistemas clásicos: aislado e inutilizable. Las escalas no se comunican entre sí.
—Uno no tiene que conocer la temperatura para resolver un problema mecánico clásico —dijo Shaw.
Sin embargo, en su opinión, los sistemas caóticos y cuasi caóticos tendían un puente sobre la sima que separa las dos clases de escalas. El caos era la creación de la información.
Imagínese agua que salva una obstrucción. Como todos los hidrodinámicos y los piragüistas saben, si corre con bastante rapidez, genera remolinos corriente abajo. A una velocidad dada, los remolinos no cambian de lugar; a otra más elevada, se mueven. El experimentador está en situación de elegir varios métodos para obtener datos de tal sistema, con tanteos de rapidez, por ejemplo. Hay la posibilidad de recurrir a un expediente más sencillo: fijarse en un punto que se halle por debajo del obstáculo y preguntarse, a intervalos regulares, si el remolino está a la derecha o a la izquierda.
En caso de que sea estático, los datos obtenidos vendrán a ser: izquierda-izquierda, izquierda-izquierda-izquierda-izquierda-izquierda. Al cabo de cierto tiempo, el observador presume que los datos nuevos no darán más información sobre el sistema.
O el remolino va adelante y atrás periódicamente: izquierda-derecha-izquierda-derecha-izquierda-derecha-izquierda-derecha-izquierda-derecha. Y una vez más, aunque al pronto parezca algo más interesante, el sistema deja de encerrar sorpresas.
No obstante, cuando se hace caótico, precisamente a consecuencia de su impredecibilidad, el sistema produce un chorro inagotable de información. Cada observación nueva es un nuevo bit. Así se plantea una cuestión difícil al experimentador que desee caracterizar el sistema de modo cabal.
—Jamás podrá abandonar el gabinete de trabajo —dijo Shaw—. El flujo será fuente inagotable de informes.
¿De dónde salen? Del baño cálido de las microescalas, miles de millones de moléculas bailando al azar termodinámico. Así como la turbulencia transmite energía, a través de cadenas de torbellinos, desde las escalas altas a las bajas, así la información se transmite de las microescalas a las macroescalas, o, por lo menos, de tal modo lo describieron Shaw y sus colegas. El canal de transmisión informativa es el atractor extraño, que agranda el azar inicial como el efecto de la mariposa aumenta las pequeñas inseguridades en pautas del tiempo atmosférico a gran escala.
La cuestión era cuánto. Shaw descubrió —después de repetir a regañadientes una parte de su trabajo— que los científicos soviéticos una vez más les habían precedido. A. N. Kolmogorov y Yasha Sinai habían elaborado procedimientos matemáticos esclarecedores sobre la forma como «la entropía por unidad de tiempo» de un sistema se aplica a las representaciones geométricas de superficies, que se estiran y pliegan en el espacio de fases. La esencia de la técnica consistía en dibujar una cajita arbitraria alrededor de una serie de condiciones iniciales, como se dibujaría un cuadradito en el lado de un globo, y, después, el efecto de las distintas expansiones o torsiones de la caja. Por ejemplo, tal vez se alargase en una dirección y permaneciese estrecha en otra. El cambio de área correspondía a introducir incertidumbre sobre el pasado del sistema, una ganancia o una pérdida de información.
Teniendo en cuenta que ésta sólo era sinónimo caprichoso de la impredecibilidad, aquella concepción apenas casaba con las ideas que desarrollaban científicos como Ruelle. Pero el marco de la teoría de la información permitió que el grupo de Santa Cruz adoptase un conjunto de razonamientos matemáticos bien investigados por los teóricos de las comunicaciones. La cuestión de añadir, por ejemplo, ruido parásito extrínseco a un sistema, por lo demás determinista, era nueva en la dinámica, aunque harto conocida en las comunicaciones. Sin embargo, lo que atrajo a aquellos jóvenes fue únicamente y en parte, las matemáticas. Cuando hablaban de sistemas que generaban información, pensaban en la formación espontánea de pautas en el mundo.
—En el pináculo de la dinámica complicada hay procesos de evolución biológica o del pensamiento —puntualizó Packard—. Intuitivamente, parece haber un sentido claro en el que estos sistemas, de esencia complicada, generan información. Miles de millones de años atrás sólo había grumos de protoplasma; ahora, miles de millones de años después, existimos nosotros. La información se ha creado y almacenado en nuestra estructura. En el desarrollo mental de una persona desde la infancia, es evidente que la información no sólo se acumula, sino también se produce. Se crea a partir de enlaces antes inexistentes.
Palabras como aquéllas hubieran dado vértigo a un físico equilibrado.
§. El grifo goteante
A pesar de ello, eran ante todo «manitas», y filósofos en segundo término. ¿Lograrían tender un puente entre los atractores extraños, que tan bien conocían, y los experimentos de la física clásica? Una cosa era decir que derecha-izquierda-derecha-derecha-izquierda-derecha-izquierda-izquierda-izquierda-derecha, era impredecible y que generaba información. Y otra muy diversa considerar una corriente de datos reales y medir su exponente de Lyapunov, su entropía y su dimensión. Ello no impedía que el colectivo de Santa Cruz se sintiera más a sus anchas con aquellas ideas que cualquiera de sus colegas de más edad. Su comunión diaria y nocturna con los atractores les había convencido de que los reconocían en el aleteo, estremecimiento, latido y vaivén de los fenómenos de su vida cotidiana.
Sentados en un café, se entretenían con un juego en el que se preguntaban: ¿A qué distancia se halla el atractor extraño más próximo? ¿Es ese ruidoso parachoques de automóvil? ¿Esa bandera que restalla caprichosamente en la brisa uniforme? ¿Una hoja que se menea?
—Nada se ve hasta que se dispone de la metáfora idónea para percibirlo —comentó Shaw, haciéndose eco de Thomas S. Kuhn.
No pasó mucho tiempo antes de que su amigo relativista Bill Burke estuviera seguro de que el velocímetro de su coche se portaba al estilo no lineal de un atractor extraño. Y Shaw adoptó, y con ello se comprometió en un proyecto experimental que le ocuparía durante años, el sistema dinámico más hogareño que un físico pudiera concebir: un grifo goteante. Casi todas las personas suponen que el grifo goteante canónico es implacablemente periódico. Sometido a investigación, se descubre que no lo es siempre.
—Sirve de ejemplo sencillo de un sistema que va del comportamiento predecible al impredecible —dijo Shaw—. Si se abre un pelo, se presenta un régimen de goteo irregular. Excepto durante un ratito, carece de pauta predecible. Así, pues, hasta algo tan sencillo como un grifo llega a generar una pauta eternamente creativa.
Pero, como productora de organización, la espita que gotea da poco trabajo. De ella caen sólo gotas, y cada una es más o menos igual a la precedente. Pero tenía ciertas ventajas para el investigador principiante del caos. Todo el mundo poseía una imagen mental del artilugio. La corriente de datos era, a pedir de boca, unidimensional: un tamborileo rítmico de puntos únicos medidos en el tiempo. Los sistemas que el grupo de Santa Cruz exploró más tarde no poseyeron esos atributos, como, por ejemplo, el sistema inmunológico del hombre, o el molesto efecto de haz-haz que entorpecía inexplicablemente la conducta de los haces de partículas en colisión en el Stanford Linear Accelerator Center (Centro del Acelerador Lineal de Stanford), emplazado al norte de Santa Cruz. Experimentadores como Libchaber y Swinney obtuvieron una corriente unidimensional de datos, introduciendo una sonda o cala en un punto cualquiera de un sistema algo más complicado. En el grifo goteante, la línea única de datos está ante los ojos. Y no se trata de velocidad o temperatura que varíe continuamente: es sólo una lista de tiempo de goteo.
El físico tradicional tal vez hiciese un modelo material lo más completo posible, si se le pidiese que organizara el estudio de un sistema como aquél. Se comprenden los procesos que rigen la creación y la interrupción de las gotas, pero no son tan sencillos como parece. Variable importante es la velocidad del flujo. (Ha de ser lento en comparación con la mayoría de los sistemas hidrodinámicos. Shaw observó, por lo general, un ritmo de goteo de 1 a 10 por segundo, lo que equivalía a un ritmo de corriente de 106,5 a 1.065,5 litros por quincena). Entre otras variables hay la viscosidad y la tensión superficial. Una gota de agua que cuelga del grifo, en espera de soltarse, adopta una compleja forma tridimensional, cuyo solo cálculo es, como escribió Shaw, «una obra maestra del arte del cómputo con ordenador». Además, la forma dista de ser estática. Puede compararse a un saquito de tensión superficial que oscila adquiriendo masa y dilatando sus paredes hasta sobrepasar un punto crítico, instante en que se suelta. El físico que intente simular a fondo el problema de la gota —anotando series de ecuaciones diferenciales parciales no lineales, emparejadas con apropiadas condiciones de límites, y procurando resolverlas— se encontrará perdido en una maleza muy densa.
Otro modo de enfrentarse con la cuestión sería olvidarse de la física y atenerse sólo a los datos, como si saliesen de una caja negra. ¿Podría manifestar algo útil un perito en dinámica caótica, dada una lista de números que representasen intervalos entre gota y gota? Se comprobó la posibilidad de idear métodos que organizasen tales datos y llevasen a la física métodos que fueron esenciales para que el caos tuviera aplicación en los problemas del mundo real.
Shaw puso manos a la obra, a medio camino entre aquellos extremos, con una especie de caricatura de un modelo físico completo. Ignorando las figuras de las gotas, y asimismo los movimientos complejos en tres dimensiones, hizo un tosco resumen de las propiedades físicas del goteo. Imaginó un peso, pendiente de un muelle, el cual aumentaba sin tregua. El muelle se estiraba y el peso bajaba cada vez más. Llegado a cierto punto, se soltaba una porción de él, que, supuso Shaw teóricamente, dependía sólo de la velocidad de descenso del peso cuando llegaba al punto de desprendimiento.
Después, por descontado, el peso restante saltaba hacia arriba por intervención del muelle, con oscilaciones que los estudiantes graduados aprenden a describir con ecuaciones tradicionales. El rasgo interesante del modelo —el único interesante, y la flexión no lineal que posibilitaba el comportamiento caótico— consistía en que la gota siguiente dependía de cómo obraban entre sí la elasticidad y el aumento constante de peso. Un brinco hacia abajo contribuía a que el peso llegara mucho antes al punto de desprendimiento, o uno hacia arriba retrasaba el proceso. Las gotas no tienen el mismo tamaño en un grifo verdadero. Obedecen a la rapidez del flujo y a la dirección del salto. La que nazca moviéndose ya hacia la parte inferior se separará antes. Si rebota, recibirá un poco más de agua antes de desprenderse. Lo elemental del modelo de Shaw permitió resumirlo en tres ecuaciones, el mínimo necesario para el caos, como Poincaré y Lorenz habían demostrado. Pero ¿generaba tanta complejidad como un auténtico grifo? ¿Y sería la complejidad de la misma clase?
He aquí la razón de que Shaw se hallara, en un laboratorio del edificio de física, con un gran cubo de materia plástica, lleno de agua, sobre su cabeza, del cual partía un tubo con una boca de manguera de latón de inmejorable calidad. La gota interrumpía al caer un haz luminoso, y un microordenador situado en la habitación contigua registraba el tiempo. Mientras tanto, Shaw procesaba sus tres ecuaciones arbitrarias en el ordenador analógico y obtenía un caudal de datos imaginarios. Cierto día celebró una exhibición con explicaciones ante los facultativos, un «seudo coloquio», como dijo Crutchfield, porque los estudiantes graduados no estaban autorizados a pronunciar conferencias formales. Shaw pasó una película en la que un grifo goteaba en un trozo de hojalata. E hizo que su ordenador crepitase con síncopa tersa revelando pautas acústicas. Había resuelto el problema simultáneamente por el principio y el fin. Quienes escucharon percibieron la estructura profunda de aquel sistema, en apariencia desordenado. Pero, para ir más lejos, el colectivo necesitaba obtener datos primarios de cualquier experimento y, partiendo de ellos, retroceder hasta las ecuaciones y los atractores extraños que caracterizaban el caos.
En un sistema más complicado, era posible contrastar una variable con otra, relacionando los cambios de temperatura o velocidad con el paso del tiempo. Mas el grifo goteante sólo suministraba series temporales. Por ello, Shaw ensayó una técnica que acaso sea la contribución más inteligente y más duradera del grupo de Santa Cruz al progreso del caos. Consistió en un método para reconstruir el espacio de fases de un atractor extraño invisible. Era aplicable a cualquier conjunto de datos. En cuanto a los del grifo goteante, Shaw compuso una gráfica bidimensional, en la que el eje x representó el intervalo de tiempo entre dos gotas, y el eje y, el intervalo siguiente. Si transcurrían 150 milisegundos entre la gota uno y la gota dos, y luego otros 150 milisegundos entre la dos y la tres, marcaba un punto en la posición 150-150.
Eso era todo. Si el goteo era regular, como propendía a serlo cuando el agua fluía despacio y el sistema se hallaba en su «régimen de clepsidra», el diagrama resultaba, lógicamente, monótono. Todos los puntos ocupaban el mismo sitio. El gráfico era un solo punto. O casi. De hecho, la primera diferencia entre el grifo goteante del ordenador y el real estribó en que éste se hallaba expuesto a influencias parásitas a causa de su extremada sensibilidad.
—Da la casualidad de que es un sismómetro estupendo —exclamó Shaw irónicamente—, eficacísimo para trasladar lo parásito de las escalas de segunda división a las de la primera.
Acabó por trabajar casi siempre de noche, cuando apenas había peatones en los pasillos. Las influencias extemporáneas transformaban el punto vaticinado por la teoría en una mancha algo difusa.
El sistema pasaba por una bifurcación de duplicación de período cuando se acrecentaba la velocidad de flujo. Las gotas se soltaban a pares. Había un intervalo de 150 milisegundos, y otro, el siguiente, de 80. Entonces el gráfico mostraba dos manchas confusas, una centrada en 150-80 y otra en 80-150. La prueba verdadera se presentó cuando la pauta se hizo caótica. Los puntos habían de diseminarse por todo el diagrama, si el fenómeno pendía del azar. No habría relación alguna entre un intervalo y el próximo a él. Pero, si se ocultaba en los datos, el atractor extraño tal vez se revelase como la fusión de lo borroso en estructuras discernibles.
Para percibir éstas a menudo se requerían tres dimensiones, lo que no planteaba ninguna dificultad. La técnica se generalizaba con facilidad en la confección de un gráfico poli dimensional. En vez de trazarlo con respecto al intervalo n + 1, el n podía representarse relacionado con el n + 1 relacionado con el n + 2. Era una artimaña, un recurso. Ordinariamente, un diagrama tridimensional exigía el conocimiento de tres variables independientes del sistema. La artimaña proporcionaba las tres por el precio de una. Reflejaba la fe de aquellos científicos en que el orden estaba tan arraigado en el desorden aparente, que encontraría la manera de manifestarse incluso a experimentadores ignorantes de las variables físicas que debían medirse, o que eran incapaces de medirlas directamente.
—Cuando se piensa en una variable, su evolución tiene que sufrir el influjo de todas aquellas con las que actúa recíprocamente —dijo Farmer—. Sus valores han de constar como fuere en la historia de esa cosa. Debe existir su marca.
Las imágenes lo ilustraron en el caso del grifo goteante de Shaw. Sobre todo en tres dimensiones, las pautas surgieron como rizados rastros de humo que dejase en el cielo un avión mal pilotado de los que escriben anuncios con él. Shaw comparó los puntos de los datos experimentales con los de los datos que le proporcionaba el modelo de ordenador analógico. La diferencia principal entre unos y otros consistió en que los primeros fueron siempre más imprecisos, alterados por el ruido parásito. A pesar de ello, la estructura era inconfundible. El grupo de Santa Cruz empezó a colaborar con experimentadores tan curtidos como Harry Swinney, que se había mudado a la Universidad de Texas, en Austin, y aprendió a cazar atractores extraños en todo género de sistemas. Había que encajar los datos en un espacio de fases de las dimensiones necesarias. Floris Takens, que había inventado los atractores extraños con David Ruelle, no tardó en dar, independientemente, base matemática a aquella técnica vigorosa de reconstruir el espacio de fases de un atractor con un caudal de datos reales. Como innumerables investigadores pronto descubrieron, la técnica distingue lo meramente parásito del caos, en la nueva acepción: desorden ordenado que los procesos simples crean. Los datos debidos intrínsecamente al azar se extienden en revoltijo indefinido. Pero el caos —determinista y dotado de pautas— los convierte en figuras visibles. La naturaleza favorece sólo unas cuantas sendas de las muchas posibles que llevan al desorden.
§. Ayudas audiovisuales
La transición de rebelde a físico fue lenta. Con relativa frecuencia, en un café u ocupado en el laboratorio, este o aquel estudiante tenía que reprimir la maravilla de que su fantasía científica no hubiera concluido. ¡Dios mío! Aún hacemos esto y aún conserva sentido, como decía Jim Crutchfield. Seguimos aquí. ¿Cuánto durará?
Recibían en la facultad apoyo sobre todo del protegido de Smale, Ralph Abraham, en el departamento de matemáticas, y, en el de física, el de Bill Burke, quien se había encumbrado a «zar del ordenador analógico» con el fin de defender, cuando menos, las aspiraciones del colectivo a utilizar aquella parte del equipo general. El resto de la facultad de física estaba en situación más ambigua. Varios años después, algunos profesores negaron con calor que el grupo hubiera tenido que vencer la indiferencia o la oposición departamental. Y el grupo reaccionó con igual calor a lo que describió como embellecimiento histórico de parte de los conversos tardíos al caos.
—No tuvimos consejero, alguien que nos orientara sobre lo que debíamos hacer —afirmó Shaw—. Representamos durante años un papel antagónico, y así seguimos hasta hoy día. Nunca nos financiaron en Santa Cruz. Trabajamos durante largas temporadas sin cobrar, y hubimos de hacer milagros para salir del paso, sin guía intelectual ni de otra especie.
Con todo, a su manera, la facultad toleró e incluso alentó un amplio período de investigación, que no parecía emparentada con la ciencia conocida. El ponente de la tesis de Shaw sobre la superconductividad le mantuvo en nómina alrededor de doce meses, y lo hizo mucho después de que el joven se hubiera desviado de la física de las bajas temperaturas. Nadie impuso que se interrumpiera el estudio del caos. En sus peores momentos, el claustro adoptó una actitud de benévolo reproche. Cada miembro del colectivo fue convocado, de vez en cuando, para sostener una charla franca. Les advirtieron que, aun cuando sus doctorados llegaran a justificarse por un procedimiento misterioso, nadie podría ayudarlos a encontrar empleo en un campo científico inexistente. Quizá fuese una afición pasajera, decía el claustro, y ¿dónde los dejaría entonces? No obstante, más allá de las secuoyas amparadoras de Santa Cruz, el caos instauraba un estamento investigador propio, y el «colectivo de los sistemas dinámicos» tenía que sumarse a él.
Mitchell Feigenbaum se presentó en una ocasión, durante el recorrido de su circuito de conferencias, para exponer su hallazgo de la universalidad. Como siempre, sus charlas fueron abstrusamente matemáticas; la teoría de renormalización de grupo era muestra esotérica de la física de la materia condensada que aquellos universitarios no habían estudiado. Por otra parte, interesaban más al colectivo los sistemas reales que los delicados mapas o diagramas unidimensionales. Doyne Farmer, en el ínterin, se enteró de que un matemático de Berkeley, Oscar E. Lanford III, exploraba el caos y fue a conversar con él. Lanford escuchó con amabilidad a Farmer y luego, mirándole a la cara, le espetó que no tenían nada en común. Estaba procurando comprender a Feigenbaum.
¡Me mata! ¿No tiene este tío sentido de la oportunidad?, pensó Farmer.
—Contemplaba aquellas pequeñas órbitas. Mientras tanto, nosotros estábamos metidos en plena teoría de la información, con toda su profundidad; demostrábamos el caos, veíamos qué lo movía e intentábamos enlazar la entropía métrica y los exponentes de Lyapunov con medidas más estadísticas.
Lanford, en su conversación con el joven, no hizo hincapié en la universalidad. Sólo después Farmer pensó que no había entendido el verdadero sentido de sus palabras.
—Tuvo la culpa mi ingenuidad. La idea de la universalidad no era un gran resultado aislado y exclusivo. Lo de Mitchell representaba asimismo una técnica para dar trabajo a un ejército de fenómenos críticos desempleados.
»Hasta cierto extremo, parecía que los sistemas no lineales debían tratarse como casos aparte. Luchábamos por encontrar un lenguaje que los cuantificase y los definiese; pero todo se presentaba como si hubiese que enfrentarse con ellos uno tras otro. No atinábamos a agruparlos por clases, ni a ofrecer soluciones válidas para una clase dada, como en los sistemas lineales. La universalidad implicaba hallar propiedades que fuesen exactamente las mismas, de modo cuantificable, para todos los individuos de la clase. Propiedades predecibles. Por eso era tan importante.
»Y había un factor sociológico que inyectaba más combustible. Mitchell expresó sus resultados en el lenguaje de la renormalización. Cogió toda la maquinaria que los especialistas en fenómenos críticos habían usado con tanta destreza. Lo pasaban mal, porque ya no quedaban, por lo visto, problemas que resolver. Buscaban en todas las direcciones algo en que aplicar su arsenal de trucos. Y, de súbito, Feigenbaum surgió con su aplicación, sumamente sugestiva, de ese arsenal. Produjo una subdisciplina.
A pesar de todo, y con independencia total, los estudiantes de Santa Cruz empezaron a causar impresión. Su estrella se remontó tras su inesperada aparición en un congreso sobre física de la materia condensada, celebrado, mediado el invierno de 1978, en Laguna Beach. Lo organizó Bernardo Huberman del Xerox Palo Alto Research Center (Centro de Investigación Xerox de Palo Alto) y de la Universidad de Stanford. El colectivo, que no había sido invitado, se metió en la camioneta convertible de tipo ranchero, un Ford de 1959 propiedad de Shaw, que recibía el nombre de Cream Dream. Por si acaso, llevó algunos útiles, tales como un gran televisor y un vídeo. Cuando un orador anuló su intervención en el último momento, Huberman propuso a Shaw que lo sustituyera. La ocasión era perfecta. El caos se había convertido en materia de comadreo, pero muy pocos físicos asistentes sabían qué era en realidad. Por lo tanto, Shaw explicó para empezar los atractores en espacio de fases: primero puntos fijos (donde todo se detiene); luego los ciclos límites (donde todo oscila); y después los atractores extraños (todo lo demás). Hizo demostraciones con sus gráficos de ordenador en cintas de vídeo. («Las ayudas audiovisuales nos proporcionaban un recurso ventajoso —dijo—. Podíamos hipnotizarlos con luces relampagueantes»). Iluminó el atractor de Lorenz y el grifo goteante. Explicó la geometría: cómo se alargan y doblan las figuras, y qué significa eso en los términos amplios de la teoría de la información. Y para colmar la medida, introdujo al final unas cuantas frases sobre los paradigmas mutables. La charla fue un éxito. Entre el público hubo varios miembros de la facultad de Santa Cruz, los cuales conocieron el caos a través de los ojos de sus colegas.
§. Finaliza una era
En 1979, el grupo completo asistió al segundo congreso sobre el caos de la New York Academy of Sciences, en aquella ocasión como participantes. La especialidad florecía de modo espectacular. El congreso de 1977 había sido el de Lorenz y a él habían acudido docenas de especialistas. El de dos años más tarde fue el de Feigenbaum, y los científicos se presentaron a centenares. Si, en 1977, había buscado tímidamente, y en vano, un mecanógrafo que pusiera en limpio un artículo para introducirlo por debajo de las puertas, el «colectivo de los sistemas dinámicos» se había convertido en algo así como una máquina impresora, que redactaba artículos con celeridad y los firmaba como colaboración de todos sus componentes.
El grupo, sin embargo, como era de esperar, no estaría siempre unido. A medida que se aproximaba más al mundo de la ciencia verdadera, se acercaba asimismo a su separación. Hubo un día en que Bernardo Huberman telefoneó. Buscaba a Rob Shaw y encontró a Crutchfield. Necesitaba un colaborador para escribir un artículo, escueto y sencillo, sobre el caos. Crutchfield, el miembro más joven del colectivo, pensando que se le consideraba un mero «peón», concedía ya que, al menos en un aspecto, la facultad de Santa Cruz no se había equivocado: cada estudiante sería juzgado, con el tiempo, según su valor individual. Además, Huberman poseía en física un refinamiento de que ellos carecían, y en particular sacaba más provecho que ellos de un trabajo determinado. Tenía dudas, pues había visto su laboratorio —«Todo era muy vago, ¿entiende?: sofás y sacos de habichuelas, como si la máquina del tiempo le transportara a uno de vuelta a los hippies y la década de 1960»—; pero necesitaba un ordenador analógico, y, de hecho, Crutchfield se las arregló para tener en marcha, durante horas, su programa de investigación. El colectivo era cuestión difícil, sin embargo.
—Todos quieren entrar en esto —dijo Crutchfield.
Huberman se negó en redondo.
—Y no es por el mérito, sino por si hay fallos. Imaginemos que el artículo sale mal. ¿Echaremos la culpa a un grupo? Yo no formo parte de él —repuso.
Para un buen trabajo, quería un solo asociado.
El resultado fue el que Huberman había esperado: el primer artículo sobre el caos que se publicó en la revista principal de los Estados Unidos, Physical Review Letters, en la que aparecían los últimos avances de la física. En términos de política científica, fue algo muy apreciable.
—No era nada extraordinario para nosotros —explicó Crutchfield—; pero Bernardo supo que provocaría sensación.
También señaló la incorporación del grupo al mundo real. Farmer se encolerizó, porque interpretó la defección de Crutchfield como un atentado al espíritu colectivo.
No obstante, Crutchfield no fue el único en salirse del grupo. Poco después, el propio Farmer y Packard colaboraban con físicos y matemáticos consolidados: Huberman, Swinney y Yorke. Las ideas de Santa Cruz se transformaron en parte firme de la estructura del estudio moderno de los sistemas dinámicos. Cuando un físico disponía de una masa de datos cuya dimensión o entropía quería investigar, las definiciones apropiadas y las técnicas de trabajo bien podían ser las creadas durante los años de remiendos de clavijas de conexión del ordenador analógico Systron-Donner, y los de observación del osciloscopio. Los climatólogos discutían si el caos de la atmósfera terrestre y los océanos tenía dimensiones infinitas, como aceptaban los especialistas en la dinámica tradicional, o si obedecía a un atractor extraño hipo dimensional. Los economistas, que analizaban los datos bursátiles, intentaban hallar atractores de dimensión 3,7 o 5,3. El sistema sería tanto más simple cuanto menor fuese la dimensión. Habían de clasificarse y comprenderse muchas peculiaridades matemáticas. La dimensión fractal, la de Hausdorff, la de Lyapunov, la de la información… Farmer y Yorke fueron quienes mejor explicaron las sutilezas de las medidas de un sistema caótico. La dimensión de un atractor era «el primer nivel de conocimiento necesario para caracterizar sus propiedades», el rasgo distintivo que proporcionaba «la cantidad de información requerida para especificar la situación de un punto en el atractor con precisión determinada». Los métodos de los estudiantes de Santa Cruz y de sus colaboradores de más edad ligaron aquellas ideas a otras medidas importantes de los sistemas: el grado de decadencia de la predectibilidad, la proporción del flujo informativo y la tendencia a crear mezcla. En ocasiones, los científicos que empleaban aquellos métodos se encontraban de pronto trazando diagramas de los datos, dibujando cajitas y contando el número de puntos informativos. Aquellas técnicas, de aspecto tan elemental, situaron por primera vez los sistemas caóticos en el ámbito de la comprensión científica.
Mientras tanto, tras haber aprendido a hallar atractores extraños en banderas flameantes y velocímetros inestables, los científicos tuvieron por norma buscar síntomas de caos determinista en toda la bibliografía física asequible. Error inexplicado, fluctuaciones sorprendentes, regularidad junto a irregularidad, etc., se abultaron en los artículos de experimentadores que habían trabajado con aceleradores de partículas, lásers, conexiones de Josephson y cuanto se quiera imaginar. Los estudiosos del caos se hicieron cargo de aquellos síntomas y aseguraron a los incrédulos que, en efecto, sus problemas eran también los suyos. Un artículo, por ejemplo, se iniciaba con las frases siguientes: «Varios experimentos efectuados con osciladores de conexión de Josephson han revelado un chocante fenómeno de creciente ruido parásito, el cual no se explica según las fluctuaciones térmicas».
Cuando el colectivo se deshizo, parte de la facultad de Santa Cruz se había dirigido ya al caos. Hubo físicos que pensaron, retrospectivamente, que Santa Cruz había desperdiciado la ocasión de convertirse en el centro inicial de trabajo en la dinámica no lineal, los cuales no tardaron en brotar en otras universidades. Al principio del decenio de 1980 los miembros del colectivo se graduaron y dispersaron. Shaw acabó su tesis en 1980, Farmer en 1981 y Packard en 1982. La de Crutchfield apareció en 1983. Era un revoltillo tipográfico que intercalaba folios mecanografiados en no menos de once artículos publicados en revistas de física y matemática. Fue a la Universidad de California, en Berkeley. Farmer se incorporó a la Sección Teórica de Los Álamos. Packard y Shaw se incorporaron al Institute for Advanced Study, en Princeton. Crutchfield estudió los bucles de realimentación de vídeos. Farmer investigó «fractales gordos» y simuló la dinámica compleja del sistema inmunológico del hombre. Packard exploró el caos espacial y la formación de los copos de nieve. Sólo Shaw pareció refractario a unirse a la corriente. Su influyente legado se compuso sólo de dos artículos, uno que le permitió viajar a París, y otro, sobre el grifo goteante, que resumía sus investigaciones en Santa Cruz. Estuvo en un tris, en varias ocasiones, de renunciar por completo a la ciencia. Como dijo un amigo suyo, estaba oscilando.

Las ciencias no tratan de explicar y casi no intentan interpretar: se consagran sobre todo a hacer modelos. Por modelo se entiende una construcción matemática que, con la adición de ciertas aclaraciones verbales, describe los fenómenos observados. La justificación de esa construcción matemática es única y precisamente que sea eficaz.
JOHN VON NEUMANN
§. Una idea errónea de los modelos§. Una idea errónea de los modelos
§. El cuerpo complicado
§. El corazón dinámico
§. Recomposición del reloj biológico
§. Arritmia fatal
§. Embriones de pollo y pulsaciones anormales
§. El caos como salud
Bernardo Huberman miró a su auditorio, en el que había biólogos teóricos y prácticos, matemáticos puros, físicos y psiquiatras, y se dijo que había chocado con una perceptible dificultad de comunicación. Entonces, en 1986, acababa de pronunciar una charla inusual ante un público inusual, el del primer congreso importante sobre el caos en la biología y la medicina, bajo los auspicios de la New York Academy of Sciences, los National Institutes of Mental Health (Institutos Nacionales de Salud Mental) y el Office of Naval Research (Departamento de Investigación Naval). En el cavernoso Auditorio Masur, de los National Institutes of Mental Health, en las afueras de Washington, Huberman distinguió muchos rostros conocidos, veteranos especialistas en el caos, y muchos otros desconocidos. Un orador experimentado podía esperar alguna impaciencia en quienes le escuchaban: era el último día del congreso y la hora del almuerzo se avecinaba peligrosamente.
Huberman, elegante californiano pelinegro, trasplantado de Argentina, no había perdido el interés en el caos desde su colaboración con los miembros de la pandilla de Santa Cruz. Era miembro investigador del Xerox Palo Alto Research Center. Pero, a veces, intervenía en proyectos que no pertenecían a su actividad básica, y allí, en el congreso biológico, terminaba de describir uno de ellos: un modelo del raro movimiento ocular de los esquizofrénicos.
Generaciones de psiquiatras se habían desvivido por definir la esquizofrenia y clasificar a quienes la padecían; pero la enfermedad era casi tan difícil de describir como de curar. La mayor parte de sus síntomas se manifiestan en la mente y la conducta. Se sabía, desde 1908, que uno de sus síntomas físicos parece afectar no sólo a los enfermos, sino también a sus parientes. Cuando procuran contemplar el lento balanceo de un péndulo, los ojos de los pacientes no consiguen seguir el suave movimiento. El órgano visual acostumbra ser un instrumento sumamente eficaz. El de una persona sana se adhiere a los objetos móviles sin el menor pensamiento consciente; las imágenes en movimiento se aquietan en la retina. Pero el de un esquizofrénico salta de forma desorganizada en pequeños incrementos, yendo más allá del blanco o no llegando a él, y creando una constante confusión de movimientos raros. Se ignora el porqué.
Los fisiólogos acumularon durante años ingentes cantidades de datos, e hicieron tablas y gráficas con el fin de mostrar las pautas de la anómala actividad ocular. Por lo regular, creyeron que las fluctuaciones respondían a las de la señal del sistema nervioso central que rige los músculos del ojo. El output defectuoso implicaba input erróneo. Tal vez algunos trastornos que afligían el cerebro de los esquizofrénicos se reflejaban en los ojos. Huberman, que era físico, no estaba de acuerdo e hizo un modelo sencillo.
Pensó del modo más simple posible en el comportamiento del ojo y escribió una ecuación. Había un término para la amplitud del péndulo balanceante y otro para su frecuencia. Otro para la inercia del ojo. Y uno para el amortiguamiento o la fricción. Y hubo términos para la corrección del error, es decir, para conceder al ojo una forma de fijarse en el objeto.
Como Huberman explicó al auditorio, la ecuación resultante describe exactamente un sistema mecánico análogo: una pelota que gira en una gamella curvada que se balancea de un lado a otro. Este movimiento corresponde al del péndulo, y las paredes de la gamella, al aspecto corrector del error, que ha de llevar la pelota hacia el centro. En la manera ya habitual de explorar tales ecuaciones, Huberman había tenido durante horas su modelo en un ordenador, cambiando los parámetros y trazando los gráficos de los comportamientos resultantes. Descubrió orden y caos. En algunos regímenes, el ojo seguía el blanco sin dificultad; luego, así que se aumentaba el grado de no linealidad, el sistema pasaba por una rápida secuencia de duplicación de período y acarreaba un desorden, que no se distinguía del que exponía la bibliografía médica.
En el modelo, el comportamiento irregular no tenía relación con una señal externa. Era consecuencia inevitable del exceso de no linealidad del sistema. El modelo de Huberman, en opinión de algunos médicos presentes, parecía ser uno genético, plausible, de la esquizofrenia. Una no linealidad que podía tanto estabilizar el sistema como perturbarlo, lo cual dependía de si aquélla era débil o fuerte, quizá correspondiese a un solo rasgo genético. Un psiquiatra comparó el concepto a la genética de la gota, en la cual un índice demasiado elevado de ácido úrico crea síntomas patológicos. Otros, más al corriente que Huberman de la bibliografía clínica, replicaron que los esquizofrénicos no eran los únicos en tener movimientos oculares anormales, ya que gran variedad de ellos se observaba en pacientes neurológicos. Oscilaciones periódicas y aperiódicas, toda suerte de comportamiento dinámico encontraría en los datos quien se molestase en aplicarles los instrumentos del caos.
Por cada científico presente que vio abrirse nuevos caminos de investigación, hubo otro que sospechó que Huberman había simplificado demasiado su modelo.
Llegado el momento del debate, su irritación y su desengaño se pusieron de manifiesto.
—Mi pregunta es qué le guía en su modelo —exclamó uno—. ¿Por qué buscar esos elementos específicos de la dinámica no lineal, es decir, esas bifurcaciones y soluciones caóticas?
Huberman reflexionó antes de contestar.
— ¡Ah, ya veo! Comprendo que he fracasado en mi exposición. El modelo es sencillo. Alguien viene y me anuncia: «Observamos esto. ¿Qué cree que sucede?». Entonces le pregunto cuál es, a su juicio, la explicación posible. Y me contesta: «Lo único que se nos ocurre es que algo fluctúa, por breve tiempo, en la cabeza». Respondo: «Bueno, soy, hasta cierto punto, especialista en el caos, y sé que el modelo no lineal de estudio más simple que puede hacerse, el más simple, posee esos rasgos genéricos, prescindiendo de cómo sean esas cosas. Por lo tanto, hago eso y la gente exclama: “¡Qué interesante!” Jamás imaginamos que pudiera haber caos intrínseco en el sistema».
»El modelo no incluye dato neurofisiológico que yo pueda defender. No digo sino que la búsqueda más simple es algo que tiende a cometer un error e ir a cero. De esa forma movemos los ojos y de esa forma una antena localiza un aeroplano. Es un modelo aplicable a cualquier cosa.
Otro biólogo empuñó el micrófono, aún desconcertado por la escueta sencillez del modelo de Huberman. En los ojos verdaderos, señaló, cuatro sistemas musculares de control operan a la vez. Se internó en una complicada descripción técnica de lo que consideraba simulación realista, exponiendo cómo, por ejemplo, se prescinde del término de masa, porque los órganos oculares encierran muchísima humedad y líquido.
—Y hay otra complicación, la de que la cantidad de masa depende de la velocidad de rotación, pues parte de ella se rezaga cuando el ojo acelera con muchísima rapidez. La materia blanda que lo compone se retrasa cuando el revestimiento exterior gira muy rápidamente.
Pausa. Huberman, en su frustración, no supo qué decir. Finalmente, uno de los organizadores del congreso, Arnold Mandell, psiquiatra que llevaba mucho tiempo interesado en el caos, le quitó el micrófono.
—Oigan, deseo presentar una interpretación. Acaban de ver ustedes qué pasa cuando un especialista en dinámica no lineal, que trabaja en sistemas globales de escasa dimensión, habla a un biólogo, que emplea instrumentos matemáticos. Nos extraña la idea de que haya, de hecho, propiedades universales de sistemas en las representaciones más simples. Así, pues, la cuestión es «Cuál es el subtipo de la esquizofrenia», «Hay cuatro sistemas motores oculares» y «Cuál es el modelo desde el punto de vista de la estructura física real», y comienza a descomponerse.
»Lo que acontece en el fondo es que, como médicos o científicos que hemos aprendido las innúmeras partes que componen un todo, nos molesta la posibilidad de que haya elementos universales de movimiento. Y Bernardo se presenta con uno y vean lo que pasa.
Huberman dijo:
—Sucedió en física hace cinco años, pero ahora están convencidos.
§. El cuerpo complicado
La elección es siempre la misma. El modelo puede hacerse más complicado y apegado a la realidad, o más sencillo y manejable. Sólo los científicos más ingenuos creen que el perfecto representa perfectamente lo real. Tendría los mismos inconvenientes que un plano tan grande y pormenorizado como la ciudad que representa, uno en que figurasen todos los parques, calles, edificios, árboles, baches, habitantes e incluso los planos. Si tal representación fuese posible, su especificidad arruinaría su propósito: el de generalizar y abstraer. Quienes ejecutan los planos hacen resaltar los detalles que sus clientes quieren. Sea cual sea su finalidad, los mapas y modelos han de simplificar cuanto puedan el mundo que imitan.
Para Ralph Abraham, matemático de Santa Cruz, un buen modelo es el «mundo de las margaritas» de James E. Lovelock y Lynn Margulis, proponentes de la hipótesis de Gaia, en que las condiciones necesarias para vivir son creadas y mantenidas por la vida misma, en un proceso auto sustentador de realimentación dinámica. El mundo de las margaritas es quizá la versión de Gaia más sencilla imaginable, tan simple que raya en lo estúpido.
—Hay tres cosas —aclaró Abraham—: margaritas blancas, margaritas negras y el desierto desnudo. Y tres colores: blanco, negro y rojo. ¿Cómo nos enseña eso algo sobre nuestra Tierra? Explica cómo emerge la regulación de la temperatura. Explica por qué este planeta tiene temperatura adecuada para la vida. El mundo de las margaritas es un modelo espantoso, no obstante lo cual, revela cómo se creó la homeostasia biológica en el globo terráqueo.
Las margaritas blancas reflejan la luz, refrescando la Tierra. Las negras la absorben, reduciendo el albedo, o capacidad reflectora, gracias a lo cual el planeta es más cálido. Pero las margaritas blancas «ansían» calor, y por ello medran sobre todo cuando la temperatura asciende. Las negras quieren fresco. Estas cualidades se expresan con ecuaciones diferenciales, y el mundo de las margaritas se pone en marcha en un ordenador. Un amplio número de condiciones iniciales guiará a un atractor de equilibrio y, no por necesidad, a un equilibrio estático.
—Es el modelo matemático de uno conceptual, y eso es lo que interesa… No se quieren modelos de alta fidelidad de sistemas biológicos o sociales —dijo Abraham—. Se introducen los albedos, se efectúa la plantación primera y se ven pasar miles de millones de años de evolución. Y se educa a los niños para que sean miembros excelentes de la junta de directores del planeta.
El dechado de sistema dinámico complejo y, por consiguiente, para muchos científicos la piedra de toque de cualquier aproximación a lo complicado, se tiene en el cuerpo humano. Ningún objeto de estudio a disposición de los físicos ofrece igual cacofonía de movimiento contradictorio, a escalas que van de lo macroscópico a lo microscópico: actividad de músculos, fluidos, corrientes, fibras y células. Ningún sistema físico se ha prestado tanto como él a clase tan obsesiva de reduccionismo: cada órgano posee micro estructura y química propias, y los estudiantes de fisiología invierten años sólo en aprender la nomenclatura de sus componentes. Pero ¡qué inapresables llegan a ser éstos! En su expresión más perceptible, una parte corporal puede ser un órgano, en apariencia tan bien definido, como el hígado. O una red, especialmente intrincada, sólida y líquida a la vez, como el sistema vascular. O un conjunto invisible, tan abstracto como el «tráfico» y la «democracia», como el sistema inmunológico, con sus linfocitos y sus mensajeros T4, máquina criptográfica en miniatura para cifrar y descifrar datos sobre los organismos invasores. Sería estéril estudiar tales sistemas sin conocimiento detallado de su anatomía y su química, de suerte que el cardiólogo aprende lo relativo al transporte fónico a través del tejido del músculo ventricular; el neurólogo las sutilezas eléctricas de la actividad de las neuronas; y el oftalmólogo el nombre, lugar y propósito de todos los músculos oculares. En la década de 1980, el caos procreó una fisiología nueva fundada en la idea de que los instrumentos matemáticos contribuirían a que los científicos entendieran los sistemas globales complejos con independencia de los detalles locales. Los investigadores, reconociendo cada vez más que el cuerpo era sede de movimiento y oscilación, desarrollaron métodos para escuchar su abigarrado tamborileo. Dieron con ritmos que no se apreciaban en las preparaciones microscópicas o en las muestras de sangre. Exploraron el caos en las disfunciones respiratorias. Estudiaron los mecanismos de realimentación en el control de los hematíes y leucocitos. Los cancerólogos especularon sobre la periodicidad e irregularidad en el ciclo de la proliferación celular. Los psiquiatras examinaron un planteamiento multidimensional de la administración de fármacos antidepresivos. Pero hubo un órgano en que hallazgos sorprendentes dominaron el auge de la nueva fisiología. Fue el corazón, cuyos ritmos, estables o inestables, normales o patológicos, pautan con tanta precisión la diferencia entre la vida y la muerte.
§. El corazón dinámico
Hasta David Ruelle se había apartado del formalismo para especular sobre el caos en el corazón, «sistema dinámico de interés trascendental para todos nosotros», escribió.
«El régimen cardíaco normal es periódico; pero hay muchas patologías aperiódicas (como la fibrilación ventricular), que llevan al estado estable de la muerte. Todo hace presumir que podrían derivarse grandes beneficios médicos del estudio con ordenador de un modelo matemático realista, el cual reprodujera los distintos regímenes dinámicos cardíacos».
Equipos de investigadores aceptaron el reto en los Estados Unidos y Canadá. Hacía mucho tiempo que se había reparado en irregularidades del latido del corazón, que se habían estudiado, aislado y clasificado. Un oído educado distingue docenas de ritmos anómalos. A la mirada experta, las figuras puntiagudas del electrocardiograma ofrecen indicios para descubrir el origen y la gravedad de una irregularidad rítmica. El profano se da cuenta de la riqueza del problema atendiendo a la abundancia de nombres que reciben las diversas arritmias. Hay latidos ectópicos, alternancias eléctricas y torsiones de puntas. Hay ritmos acusados de bloqueo y de escape. Hay parasistolia (atrial o ventricular, pura o modulada). Hay ritmos de Wenckebach (simples o complicados). Hay taquicardia. La fibrilación es lo que más mina la perspectiva de sobrevivir. Esta nómina de ritmos, como la de las partes orgánicas, tranquiliza a los médicos. Permite especificar en la diagnosis de los corazones maltrechos, y abordar los trastornos con cierta inteligencia. Pero los investigadores que usaban el instrumental del caos descubrieron que la cardiología tradicional efectuaba generalizaciones discutibles, en el caso de los latidos anómalos del corazón, y que, sin advertirlo, recurría a clasificaciones superficiales que oscurecían las causas fundamentales.
Hallaron el corazón dinámico. Casi siempre sus antecedentes se salían de lo ordinario. Leon Glass, de la Universidad de MacGill, en Montreal, era experto en física y química, en el cultivo de las cuales se sintió atraído por las matemáticas y la irregularidad; completó su tesis doctoral sobre el movimiento atómico en los líquidos, antes de encararse con los latidos anormales del corazón. Típicamente, dijo, los especialistas diagnostican muchas arritmias observando cortas bandas de electrocardiogramas.
—Los médicos lo reducen a un problema de reconocimiento de pautas, a identificar las que han visto en el ejercicio de su profesión y en los libros de texto. Desde luego, no analizan con detalle la dinámica de esos ritmos. Son mucho más ricas de lo que se colige de la lectura de las obras de enseñanza.
En la Harvard Medical School (Escuela Médica de Harvard), Ary L. Goldberger, codirector del laboratorio de arritmia del Beth Israel Hospital (Hospital de la Casa de Israel), creía que la investigación cardiológica representaba el umbral de la colaboración de los fisiólogos con los matemáticos y físicos.
—Estamos ante una frontera nueva, y una clase nueva de fenomenología nos espera más allá de ella —dijo—. Las bifurcaciones y los cambios abruptos de comportamiento que vemos, no tienen explicación en los modelos lineales convencionales. Claramente, necesitamos otros modelos, y la física parece proporcionárnoslos.
Goldberger y otros científicos habían de salvar las barreras del léxico técnico y de la clasificación institucional. En su opinión, la incomodidad y la antipatía que muchos fisiólogos sentían por las matemáticas representaban un obstáculo notable. —En 1986, la palabra fractal no se encuentra en los libros de fisiología —dijo—. Sin embargo, estoy convencido de que, en 1996, no habrá uno en que no figure. El médico que escucha el latido cardíaco oye el roce y el choque de fluido contra fluido, fluido contra sólido y sólido contra sólido. La sangre corre de cavidad en cavidad, oprimida por la contracción de los músculos que deja atrás, y dilata los tabiques que tiene delante. Las válvulas fibrosas se cierran, con sonido audible, para impedir el retroceso del torrente sanguíneo. Las contracciones musculares se deben a una complicada onda tridimensional de actividad eléctrica. Simular cualquier aspecto de la conducta del corazón abrumaría a un superordenador; y sería imposible establecer el modelo de todo el ciclo con sus relaciones. Es práctica ajena a los tecnólogos médicos establecer un modelo de ordenador del género tan corriente para un experto en dinámica que diseñe alas para un Boeing, o flujos de motor para la NASA.
Tanteo y error, por ejemplo, han gobernado el diseño de las válvulas cardíacas artificiales, ingenios de metal y material plástico, que ahora prolongan la vida de quienes tienen deficientes las naturales. Hay que reservar un lugar especial, en los anales de la ingeniería, a la válvula del corazón que proporciona la naturaleza, estructura membranosa, flexible y translúcida, con tres minúsculas cavidades en forma de paracaídas. Debe apartarse generosamente, plegándose, para que la sangre entre en las cámaras de bombeo. Para impedir que la corriente sanguínea retroceda, cuando se la impele adelante, ha de llenarse y cerrarse herméticamente a presión, y tiene que hacerlo, sin infiltraciones ni rupturas, dos o tres mil millones de veces. Los ingenieros humanos no han sido tan hábiles. Las válvulas artificiales, de manera general, se han imitado de los fontaneros; diseños típicos, como la «bola enjaulada», se han experimentado, con costo elevado, en animales. Fue bastante difícil salvar los problemas evidentes de escapes y fallos causados por la carga. Muy pocos sospecharon cuán arduo sería eliminar otra dificultad. Como alteraban las pautas de la fluidez en el corazón, las válvulas artificiales engendraron lugares de turbulencia y de estancamiento; cuando se estanca, la sangre forma coágulos, y cuando éstos se quiebran y van al cerebro, provocan ataques. La coagulación interpuso una barrera fatal en la fabricación de corazones artificiales. Sólo a mediados del decenio de 1980, cuando los matemáticos del Courant Institute de la Universidad de Nueva York aplicaron a la cuestión nuevas técnicas de modelo de ordenador, el diseño de las válvulas cardíacas empezó a sacar provecho de la tecnología existente. Su ordenador hizo películas de un corazón activo, fácilmente reconocible, aunque fuese bidimensional. Cientos de puntos, que representaban las partículas sanguíneas, pasaron por la válvula, distendiendo las paredes elásticas del órgano y generando remolinos. Los matemáticos notaron que el corazón agregaba todo un campo de complejidad al problema clásico del flujo de fluidos, porque un modelo realista debía considerar la elasticidad de los tabiques cardíacos. En lugar de fluir sobre una superficie rígida, como el aire en las alas de un avión, la sangre cambiaba dinámicamente y de modo no lineal la superficie del corazón.
Más sutil, y mucho más letal, era la cuestión de las arritmias. La fibrilación ventricular causa al año centenas de millares de defunciones súbitas sólo en los Estados Unidos. En muchas situaciones, la dispara algo específico y bien conocido: la obstrucción de las arterias, que acaba en la muerte del músculo bombeante. El consumo de cocaína, la tensión nerviosa y la hipotermia predisponen a la fibrilación. La irrupción de ésta sigue siendo misteriosa en muchos casos. El médico preferiría ver lesiones, cuando atiende al enfermo que se ha salvado de la fibrilación, porque dispondría de una prueba de la causa. El paciente de corazón aparentemente sano, tras un acceso de fibrilaciones está en realidad más expuesto a sufrir otro ataque.
Hay una metáfora clásica para denotar el corazón fibrilador: una bolsa de gusanos. En vez de contraerse y distenderse, contraerse y distenderse, de forma repetida y periódica, el tejido del músculo cardíaco se retuerce, sin coordinación, impotente para bombear la sangre. En uno que lata como es debido, la señal eléctrica avanza como onda coordinada a través de su estructura tridimensional. Todas las células se contraen al recibir la señal; después se relajan, durante un período crítico de rebeldía, en el que no pueden ponerse en marcha una vez más prematuramente. La onda se interrumpe en el corazón fibrilador, y el órgano nunca está del todo contraído o relajado.
Un rasgo desconcertante de la fibrilación estriba en que muchos de los componentes cardíacos funcionan con normalidad. A menudo, los nódulos marcapasos siguen emitiendo latidos eléctricos uniformes. Las células musculares individuales responden bien. Cada una recibe el estímulo, se contrae, lo transmite y se distiende para esperar el próximo estímulo. El tejido muscular tal vez no revele daño alguno en la autopsia. Ésa es una de las razones por las que los expertos en el caos pensaron que era imprescindible otra exploración global: las partes del corazón fibrilador parecen funcionar, pero el conjunto falla lastimosamente. La fibrilación supone el desorden en un sistema complejo, como los trastornos mentales —tengan o no raíces químicas— lo son en otro.
El corazón no cesará de fibrilar por sí mismo. Es una clase estable de caos. Sólo un choque eléctrico con un aparato desfibrilador —descarga que cualquier especialista en dinámica reconoce como una perturbación masiva— consigue devolver el estado estable al corazón. En conjunto, los desfibriladores son efectivos. Pero su diseño, como el de las válvulas artificiales, ha exigido numerosas conjeturas.
—La tarea de decidir la magnitud y la forma de la descarga eléctrica ha sido estrictamente empírica —dijo Arthur T. Winfree, biólogo teórico—. No había ninguna teoría sobre ello. Ahora parece ser que algunos presupuestos no son correctos. Hay que corregir a fondo el diseño de los desfibriladores, para multiplicar su eficacia y, por lo tanto, multiplicar las posibilidades de éxito.
Se han ensayado, en especial por el método de tanteo y error, terapias con fármacos en otros ritmos cardíacos anormales: «magia negra», como lo definió Winfree. Sin una sólida comprensión teórica de la dinámica del corazón, resulta arriesgado predecir los efectos de un medicamento.
—En los últimos veinte años, se ha efectuado un trabajo maravilloso en la averiguación de los detalles recónditos de la fisiología de la membrana, de todas las funciones precisas, pormenorizadas, de la inmensa complicación de las partes cardíacas. En esencia, la cuestión se halla en estado inmejorable. Pero no se ha considerado la otra cara de la moneda, la de obtener una perspectiva global de cómo actúa el conjunto.
§. Recomposición del reloj biológico
Winfree procede de una familia en la que nadie fue a la universidad. Empezó, asegura, sin tener educación adecuada. Su padre, mientras ascendía desde el fondo de la escala del negocio de los seguros de vida al cargo de vicepresidente, llevó a los suyos, casi todos los años, arriba y abajo de la costa oriental de los Estados Unidos, y Winfree estuvo en más de una docena de escuelas, antes de concluir la enseñanza secundaria. Adquirió, poco a poco, la percepción de que las cosas interesantes del mundo se relacionaban con la biología y las matemáticas, y también la de que ninguna combinación usual de ambas hacía justicia a lo interesante. Por ello, decidió no abordarlas del modo habitual. Estudió física mecánica durante un lustro, en la Universidad de Cornell, y aprendió matemáticas aplicadas y una colección completa de habilidades de laboratorio. Preparado para que le contratase la industria militar, se doctoró en biología y procuró combinar de manera innovadora el experimento con la teoría. Comenzó en Johns Hopkins, que hubo de abandonar a consecuencia de sus conflictos con la facultad, prosiguió en Princeton, que tuvo que dejar asimismo por dificultades de la misma índole, y finalmente se graduó en Princeton, desde lejos, cuando ya enseñaba en la Universidad de Chicago.
Winfree era un ave rara, un pensador insólito, en el mundo biológico, pues aportó decidida noción geométrica a su estudio de los problemas fisiológicos. Su exploración de la dinámica de la biología se inició, al principio de los años setenta, con el estudio de los relojes biológicos o ritmos circadianos. Tradicionalmente, la materia se enfocaba con criterio naturalista: este ritmo corresponde a ese animal. En opinión de Winfree, la cuestión debía hacerse según el pensamiento matemático.
—Tenía la cabeza llena de dinámica no lineal y comprendí que el problema podía —y debía— concebirse en esos términos cualitativos. Nadie sabía ni por asomo cuáles eran los mecanismos de los relojes biológicos. Cabían dos cosas: esperar a que los bioquímicos los imaginasen, e intentar derivar algún comportamiento de los mecanismos conocidos; o estudiar cómo funcionan los relojes conforme a la teoría de los sistemas complejos y la dinámica no lineal y topológica. Me propuse hacer lo último.
Hubo un período en que llenó su laboratorio de mosquitos enjaulados. Como se sabe, estos insectos se animan a diario a la puesta del sol. En un laboratorio en que se mantengan constantes la temperatura y la iluminación, para inhibirlos del día y la noche, los mosquitos tienen un ciclo interno de veintitrés horas y no de veinticuatro. Cada veintitrés horas zumban con especial intensidad. Lo que los alerta al aire libre es la sacudida luminosa que reciben cotidianamente; da cuerda a su reloj.
Winfree proyectó luz artificial sobre los insectos en dosis que calculó cuidadosamente. Aquellos estímulos adelantaron o retrasaron el ciclo siguiente. Hizo la gráfica del efecto obtenido en comparación con la distribución de la sacudida. Después, renunciando a conjeturar qué aspectos bioquímicos mediaban en el fenómeno, consideró el problema de manera topológica, o sea se fijó en la forma cualitativa de los datos, prescindiendo de los pormenores cuantitativos. Llegó a una conclusión sorprendente: había una singularidad en la geometría, un punto diferente de todos los restantes. Estudiando la singularidad, predijo que un estallido de luz especial, de duración dada y lanzado en el momento oportuno, causaría el trastorno total del reloj biológico de un mosquito. O de cualquier ser vivo. La predicción era asombrosa, pero los experimentos de Winfree la respaldaron.
—Se va a un mosquito a medianoche y se le propina cierto número de fotones. Esa descarga, bien calculada, estropea su reloj. En adelante, tiene insomnio. Dormita y zumba un rato, todo al azar, y continuará haciéndolo cuanto tiempo se moleste uno en observarle, o hasta que reciba otra sacudida. Se le ha administrado un chorro de retraso perpetuo.
Al comienzo de la década de 1970, el enfoque matemático de Winfree de los ritmos circadianos despertó poco interés. Por otra parte, era complicado ampliar la técnica de laboratorio a especies que se opondrían a estar en jaulitas durante meses sin fin. La alteración del reloj biológico y el insomnio en el hombre figuraban en la lista de problemas biológicos no solventados. Los dos fomentaban el peor charlatanismo: píldoras inútiles y remedios de curandero. Los investigadores acopiaban datos de los seres humanos, por lo regular estudiantes, jubilados o dramaturgos apremiados por terminar una obra, y deseosos de aceptar unos centenares de dólares semanales a cambio de vivir «aislados del tiempo»: sin luz natural, sin cambios termométricos, sin cronómetros, sin teléfonos. La gente posee un ciclo de sueño y vigilia, y también uno de temperatura corporal. Son osciladores no lineales que se restablecen tras experimentar leves perturbaciones. En el aislamiento, sin estímulos que repongan el ritmo cotidiano, el ciclo de temperatura parece ser de veinticinco horas, con la más baja durante el sueño. Pero investigadores alemanes habían averiguado experimentalmente que, al cabo de unas semanas, el ciclo de sueño y vigilia se desgajaba del de la temperatura, y se volvía caprichoso. La gente permanecía despierta de un tirón durante veinte o treinta horas, y luego dormía durante diez o veinte. Y los sujetos no sólo no se percataban de que su día se había alargado, sino también se negaban a creerlo cuando se lo decían. Sólo mediados los años ochenta se aplicó a los seres humanos el enfoque sistemático de Winfree.
El primer sujeto fue una anciana, que hizo labor de punto durante la primera noche frente a baterías de luces brillantes. Su ciclo cambió por completo. Informó que se sentía en el mejor de los mundos, como si condujera un coche descapotado. Winfree había trasladado ya su atención a los ritmos cardíacos.
Él no hubiese dicho «trasladado». Para Winfree era la misma materia: química distinta, igual dinámica. El corazón le atrajo después de haber observado con impotencia la muerte repentina, cardíaca, de dos personas, un pariente durante las vacaciones estivales, y un desconocido en una piscina en que Winfree nadaba. ¿Por qué se interrumpía de pronto, transformándose en frenesí desesperado y trágicamente inefectivo, un ritmo que se había mantenido durante toda una vida, con dos mil millones de ciclos por lo menos, soportando la relajación y la tensión, la aceleración y la deceleración?
§. Arritmia fatal
Winfree narró lo acontecido a un investigador pretérito, George Mines, quien en 1914 tenía veintiocho años de edad. En su laboratorio de la Universidad de McGill, en Montreal, había construido un pequeño aparato que enviaba impulsos eléctricos, débiles y bien regulados, al corazón.
Caos químico.
Ondas que se propagaban en círculos concéntricos hacia el exterior, y hasta algunas en espiral, revelaron el caos en la reacción de Beluzov-Zhabotinsky, muy bien estudiada en química. Pautas semejantes se han observado en recipientes que contenían millones de amebas. Arthur Winfree teorizó que tales ondas son análogas a las de actividad eléctrica que recorren el músculo cardíaco de una manera ora regular, ora caprichosa.
Es de sospechar que un choque eléctrico, reducido, pero preciso, llegue a hacer fibrilar el corazón, y así debió de pensarlo Mines poco antes de su muerte. Otros pueden adelantar o retrasar el latido siguiente, como en los ritmos circadianos. Hay, no obstante, una diferencia entre los corazones y los relojes biológicos, una imposible de eliminar ni siquiera en un modelo simplificado: el órgano cardíaco tiene una forma en el espacio. Puede asirse con la mano. Puede observarse en él una onda eléctrica a través de tres dimensiones.
Sin embargo, lograrlo pide inventiva. Raymond E. Ideker, del Duke University Medical Center (Centro Médico de la Universidad de Duke) leyó, en 1983, un artículo de Winfree en Scientific American, y notó cuatro predicciones específicas sobre la inducción y la detención de la fibrilación, basadas en la dinámica no lineal y la topología. Ideker no les prestó crédito. Se le antojaron demasiado especulativas y, para un cardiólogo, demasiado abstractas. Al cabo de tres años, las cuatro habían sido ensayadas y confirmadas, e Ideker dirigía un programa avanzado para reunir cuantos datos pudiera y desarrollar con ellos un estudio dinámico del corazón. Era, como describió Winfree, «el equivalente cardíaco del ciclotrón».
El electrocardiograma típico proporciona únicamente una burda visión unidimensional. Durante la operación, el cirujano mueve un electrodo de un sitio a otro del corazón, comprobando de cincuenta a sesenta puntos, durante un período de diez minutos, con lo que obtiene una especie de imagen compuesta. Esta técnica resulta inútil en la fibrilación. El corazón cambia y se estremece con excesiva rapidez. La de Ideker, que se basaba en el proceso de ordenador en tiempo real, consistía en fijar ciento veintiocho electrodos en una red, que colocaba en el corazón como el calcetín en el pie. Los electrodos registraban el campo de voltaje a medida que cada onda recorría el músculo, y el ordenador proporcionaba un mapa cardíaco.
La intención inmediata de Ideker, aparte poner a prueba las ideas teóricas de Winfree, era mejorar los instrumentos eléctricos usados para dominar la fibrilación. Los servicios médicos de urgencia utilizan modelos típicos de desfibriladores, que envían una enérgica descarga eléctrica a través del paciente. A título de experimento, los cardiólogos han desarrollado un pequeño aparato implantable que se fija en el interior de la cavidad torácica de las personas más expuestas al peligro, aunque no se sepa con certeza cómo identificarlas. Ese desfibrilador, algo más grande que un marcapasos, escucha los latidos cardíacos hasta que es necesario propinar la descarga eléctrica. Ideker acumuló los conocimientos imprescindibles para que el diseño de los desfibriladores se transformase de adivinanza, sometida a graves riesgos, en ciencia.
§. Embriones de pollo y pulsaciones anormales
¿Por qué las leyes del caos habían de aplicarse al corazón, de tejido peculiar, con células, que componen fibras ramificadas o relacionadas entre sí, y que transportan iones de calcio, potasio y sodio? La cuestión intrigaba a científicos de la Universidad de McGill y el Massachusetts Institute of Technology.
En McGill, Leon Glass y sus colegas Michael Guevara y Alvin Schrier efectuaron una de las investigaciones más comentadas de la corta historia de la dinámica no lineal. Emplearon diminutos agregados de células cardíacas de embriones de pollo de siete días. Tales bolitas celulares, de algo más de un milímetro de diámetro, colocadas en un plato y sacudidas, latían espontáneamente al promedio de una vez por segundo, sin la intervención de un marcapasos exterior. La pulsación se percibía con claridad con el microscopio. A continuación, se ideó aplicar un ritmo externo. Los científicos de McGill lo llevaron a efecto con un micro electrodo, delgado tubito de cristal acabado en punta sutil que insertaron en una de las células. La corriente eléctrica, a través del tubo, estimuló el conjunto celular con fuerza y ritmo regulables a voluntad.
Resumieron, en 1981, sus hallazgos como sigue en las páginas de Science: «El comportamiento dinámico extraño, visto precedentemente en estudios matemáticos y experimentos de las ciencias físicas, puede en general presentarse cuando se perturban de forma periódica los osciladores biológicos». Observaron duplicación de período, esto es, pautas de latido que se bifurcaban una y otra vez, si se alteraba el estímulo. Hicieron mapas de Poincaré y de ciclos. Estudiaron la intermitencia y el bloqueo.
—Pueden establecerse muchos ritmos distintos entre un estímulo y un trocito de corazón de pollo —dijo Glass—. Con las matemáticas no lineales, entendemos bastante bien los diferentes ritmos y su disposición. Al presente, la enseñanza de los cardiólogos no incluye matemáticas dignas de mención; pero, según concebimos estas cuestiones, ése es el modo en que, en algún momento, las generaciones venideras habrán de considerarlas.
Mientras tanto, durante un programa sobre ciencias médicas y tecnología en que colaboraban Harvard y el MIT, Richard J. Cohen, cardiólogo y físico, encontró un ámbito de series de duplicación de período en experimentos con perros. Con modelos de ordenador, ensayó un esquema plausible, en que las olas de la actividad eléctrica se rompían en islas de tejidos.
—Es ejemplo evidente del fenómeno de Feigenbaum —dijo el investigador—, un fenómeno regular que, en determinadas circunstancias, se vuelve caótico. De ello resulta que la actividad eléctrica del corazón guarda estrecho paralelismo con sistemas en los que se da el comportamiento caótico.
Los científicos de McGill recurrieron también a los antiguos datos acopiados sobre diversos géneros de latidos cardíacos anormales. En un síndrome muy conocido, los anómalos, ectópicos, se mezclaban con los normales, sinuosos. Glass y sus colegas examinaron las pautas y contaron los sinuosos intercalados entre los ectópicos. El número variaba en unas personas, aunque siempre, por causa ignorada, era impar: 3, 5 o 7. En otras personas, el de los normales formaba siempre parte de la secuencia: 2, 5, 8, 11…
—Se han efectuado esas fantásticas observaciones numerológicas, pero los mecanismos no se comprenden con facilidad —comentó Glass—. Hay a menudo alguna regularidad en esos números, y, también con frecuencia, gran irregularidad. Es un lema de este asunto: orden en el caos.
Los conceptos de la fibrilación adoptaron por lo común dos aspectos. Idea clásica era que las señales secundarias de marcapasos procedían de centros anormales, en el interior del propio músculo cardíaco, y que chocaban con la señal principal. Tales centros ectópicos diminutos emitían ondas a intervalos inoportunos, y se pensó que la acción simultánea y la acumulación parcial rompían la onda coordinada de contracción. La exploración de los científicos de McGill proporcionó cierto apoyo a esta tesis, demostrando que una serie de disfunciones dinámicas puede derivarse de la acción recíproca de una pulsación externa y un ritmo inherente al tejido del corazón. Pero aún se explicaba con dificultad por qué habían de surgir, en primer lugar, centros secundarios de marcapasos.
El otro concepto se concentró no en la iniciación de las ondas eléctricas, sino en el modo como son conducidas a través del corazón. Los investigadores de Harvard y el MIT lo siguieron. Averiguaron que había anomalías en la onda, que, girando en círculos apretados, podían causar el «reingreso», en el que algunas áreas iniciaban demasiado pronto un nuevo latido, impidiendo que el corazón hiciera la pausa imprescindible para que el bombeo fuese coordinado.
Insistiendo en los métodos de la dinámica no lineal, los dos grupos de investigadores pudieron usar el conocimiento de que el cambio leve en un parámetro —tal vez en la regulación o en la conductividad eléctrica— acaso llevara un sistema, sano en todos los aspectos, mediante un punto de bifurcación, a un comportamiento cualitativamente nuevo. También empezaron a encontrar un campo común para el estudio global de los trastornos cardíacos, asociando desórdenes que antes se consideraban inconexos. Además, Winfree creyó que, no obstante el diferente enfoque, la escuela del latido ectópico y la del reingreso estaban en lo cierto. Su criterio topológico sugería que las dos ideas podían formar una sola.
—Los objetos dinámicos suelen ser contraintuitivos, y el corazón se halla en ese caso —dijo Winfree.
Los cardiólogos alimentaron la esperanza de que la investigación produciría un método científico para identificar a las personas expuestas a la fibrilación, diseñar aparatos desfibriladores y prescribir fármacos. Winfree esperó que la visión total y matemática de aquellas cuestiones fecundaría una disciplina casi inexistente en los Estados Unidos: la biología teórica.
§. El caos como salud
Hay ahora fisiólogos que hablan de enfermedades dinámicas, consistentes en desórdenes de sistemas y en rupturas de coordinación o de control. Una manera de formularlo es: «Sistemas que por lo general oscilan, dejan de hacerlo o lo hacen de modo nuevo e inesperado, y otros, que no acostumbran oscilar, se ponen a hacerlo». Esos síndromes incluyen trastornos respiratorios, tales como jadeos, respiraciones audibles, respiración de Cheyne-Stokes y apnea infantil, relacionada con el de la muerte súbita en la infancia. Hay desórdenes dinámicos de la sangre, entre ellos un género de leucemia en que los desequilibrios alteran el equilibrio de los leucocitos, glóbulos rojos, plaquetas y linfocitos. Algunos científicos especulan que la esquizofrenia y ciertas depresiones pueden pertenecer a esta categoría.
Hay fisiólogos que se inclinan a concebir el caos como salud. Se reconoce, desde hace bastante tiempo, que la no linealidad en los procesos de realimentación sirve para regular y controlar. Dicho escuetamente: el proceso lineal que reciba un empujoncillo tiende a permanecer una pizca alejado de la trayectoria ordinaria; y otro no lineal, con idéntico empujón, propende a retornar al punto de partida. Christian Huygens, físico holandés del siglo XVII, que contribuyó a inventar el reloj de péndulo y la ciencia de la dinámica clásica, dio por casualidad con uno de los grandes ejemplos de esta forma de regulación, o al menos así se cuenta tradicionalmente. Notó un día que un juego de relojes, adosado a una pared, se movían con la sincronización perfecta de coristas bien adiestradas. Sabía que los cronómetros no podían ser tan precisos. La descripción matemática del péndulo de que entonces se disponía no explicaba aquella misteriosa propagación del orden de un péndulo a otro. Huygens coligió correctamente que los relojes se coordinaban con las vibraciones transmitidas por la madera. Este fenómeno, en que un ciclo regular se acopla a otro, se llama arrastre o simpatía. Explica por qué la Luna siempre mira hacia la Tierra o, de modo más general, los satélites artificiales se inclinan a girar en alguna razón de número entero de su período orbital: 1 a 1, 2 a 1 o 3 a 2. Cuando la razón se aproxima a un número entero, la no linealidad de la atracción de marea del satélite tiende a arrastrarlo. Este fenómeno se presenta en toda la electrónica, y hace posible, por ejemplo, que un receptor de radio capte señales incluso cuando su frecuencia encierra pequeñas fluctuaciones. También explica la capacidad de grupos de osciladores, incluyendo los biológicos, como las células cardíacas y encefálicas, para actuar sincronizadamente. Una muestra espectacular de ello en la naturaleza es una luciérnaga del sudeste de Asia, la cual se congrega a millares en los árboles durante el período de reproducción, parpadeando en fantástica armonía espectral.
Con todos esos fenómenos de control, la robustez adquiere importancia crítica: lo bien que un sistema pueda soportar pequeñas sacudidas. Y, en los biológicos, la flexibilidad: cuán bien funciona un sistema en una gama de frecuencias. El arrastre en un solo modo puede convertirse en esclavitud, impidiendo que un sistema se adapte al cambio. Los organismos han de reaccionar a circunstancias que varían rápidamente y sin concierto; ningún ritmo cardíaco o respiratorio queda incluido en las periodicidades estrictas del modelo físico más sencillo, y lo mismo tiene validez en cuanto a los ritmos más sutiles del resto del cuerpo. Algunos investigadores, como Ary Goldberger de la Harvard Medical School, propusieron que la dinámica sana o robusta estaba marcada por estructuras físicas fractales, como las ramificaciones de los tubos bronquiales en el pulmón, y las fibras rectoras del corazón, que permiten una amplia serie de ritmos. Pensando en los argumentos de Robert Shaw, Goldberger notó: «Los procesos fractales asociados con espectros escalares y de banda amplia son “ricos en información”. Los estados periódicos, en cambio, reflejan espectros de banda estrecha y los definen secuencias monótonas, reiterativas, vacías de contenido informador». Tratar aquellos desórdenes, apuntaron tanto él como otros fisiólogos, tal vez dependiese de ampliar la reserva espectral de un sistema, de su posibilidad de recorrer muchas frecuencias sin caer en un canal cerrado periódico.
Arnold Mandell, el psiquiatra y estudioso de la dinámica de San Diego, que defendió a Bernardo Huberman en el caso del movimiento ocular en la esquizofrenia, fue mucho más allá sobre la intervención del caos en la fisiología.
— ¿Será posible que la patología matemática, esto es, el caos, sea salud? ¿Y la salud matemática, que es la predectibilidad y lo diferenciador en este género de estructura, sea enfermedad?
Mandell había recurrido al caos, en la temprana fecha de 1977, cuando halló «comportamiento peculiar» en ciertos enzimas del cerebro, que sólo podía interpretarse conforme a los métodos nuevos de la matemática no lineal. Había alentado con frases semejantes el estudio de las marañas oscilantes tridimensionales de moléculas proteínicas; en vez de dibujar estructuras estáticas, afirmó, los biólogos debían entender aquellas moléculas como sistemas dinámicos, capaces de transiciones de fase. Era, como expresó, fanático entusiasta, y su interés primordial se centró en el órgano más caótico.

Armonías caóticas.
La acción recíproca de diferentes ritmos, tales como las frecuencias de radio o las órbitas planetarias, produce una versión especial del caos. Imágenes de ordenador de algunos «atractores» que aparecen en ocasiones cuando tres ritmos coinciden.

Flujos caóticos.
Cuando se introduce una vara en un fluido viscoso, se genera una forma ondulada sencilla. Si la introducción se repite varias veces, aparecen formas más complicadas.
En opinión de Mandell, los descubrimientos del caos imponen un cambio en el tratamiento clínico de los trastornos psiquiátricos. Desde el punto de vista objetivo, la acción moderna de la «psicofarmacología» —el empleo de fármacos para tratar todo, desde la ansiedad y el insomnio a la esquizofrenia— tiene que declararse un fracaso. Pocos pacientes —aceptando que lo hagan— se curan. Las manifestaciones más violentas de la enfermedad mental se moderan, pero nadie sabe con qué consecuencias a largo plazo. Mandell ofreció a sus colegas una evaluación escalofriante de las medicinas más utilizadas. Las fenotiazinas, recetadas a los esquizofrénicos, empeoran el trastorno fundamental. Los antidepresivos tricíclicos «aumentan la velocidad del ciclo de los estados de ánimo, y conduce a incrementos a largo plazo del número de recaídas psicopatológicas». Etcétera. Sólo el litio había proporcionado éxitos médicos, indicó Mandell; pero únicamente en el cuidado de determinados trastornos.
En su criterio, el problema era conceptual. Los métodos clásicos para tratar aquella «máquina inestabilísima, dinámica y de infinitas dimensiones» eran lineales y reduccionistas. «El paradigma subyacente es aún: un gen → un péptido → un enzima → un neurotransmisor → un receptor → un comportamiento animal → un síndrome clínico → un fármaco → una escala clínica de clasificación. Señorea en casi toda investigación y tratamiento de la psicofarmacología. Más de cincuenta transmisores, miles de tipos celulares, complicada fenomenología electromagnética e inestabilidad continua, basada en actividad autónoma en todos los niveles, desde las proteínas hasta el electroencefalograma…, y, sin embargo, el cerebro se concibe aún como un cuadro de distribución química». Alguien, expuesto al mundo de la dinámica no lineal, sólo podía dar una contestación: ¡Cuán ingenuos! Mandell instó a sus colegas a que procurasen comprender las móviles geometrías que sustentan sistemas tan complicados como la mente.
Muchos otros científicos emprendieron la aplicación de los formalismos del caos a la investigación de la inteligencia artificial. La dinámica de sistemas que vagaban entre cuencas de atracción, por ejemplo, atrajo a quienes buscaban la forma de establecer modelos de símbolos y recuerdos. El físico que pensara en las ideas como regiones de límites imprecisos, separadas, aunque coincidentes, atrayendo como imanes y, al mismo tiempo, dejando ir, recurriría naturalmente a la imagen de un espacio de fases con «cuencas de atracción». Tales modelos parecían tener los rasgos idóneos: puntos de estabilidad mezclados con inestabilidad, y regiones de límites mutables. Su estructura fractal ofrecía la clase de cualidad de autorreferencia infinita que posee, al parecer, importancia tan esencial en la capacidad de la mente para florecer en ideas, decisiones, emociones y demás elementos de la consciencia. Con el caos o sin él, los científicos cognoscitivos honestos no pueden establecer ya un modelo de la mente como una estructura estática. Reconocen una jerarquía de escalas, desde la neurona en adelante, que brinda la oportunidad al juego recíproco de macroescalas y microescalas, tan peculiar de la turbulencia fluida y de otros procesos dinámicos complejos.
Pauta nacida en lo informe: ésa es la belleza fundamental de la biología y su misterio básico. La vida succiona orden de un océano de desorden. Erwin Schrödinger, pionero de la teoría cuántica y uno de los físicos que efectuaron incursiones de aficionado en la especulación biológica, lo expresó así hace cuarenta años: Un organismo vivo tiene el «asombroso don de concentrar una “corriente de orden” en sí mismo y se libra de esa suerte de decaer en el caos atómico». Parecía evidente a Schrödinger, como físico, que la estructura de la materia viva se diferenciaba de la que estudiaban sus colegas. La piedra angular de la vida —todavía no se llamaba ADN— era un cristal aperiódico. «Hasta ahora hemos tratado en física sólo con cristales periódicos. Para la mente de un físico humilde, son objetos interesantísimos y complicados; representan una de las estructuras materiales más fascinadoras y complicadas con que la naturaleza inanimada confunde su ingenio. No obstante, comparados con el cristal aperiódico, frisan en lo manifiesto e insulso». Se diferenciaban como el papel de pared y el tapiz, como la repetición insistente de un motivo y la variación fastuosa y coherente de la creación de un artista. Los físicos habían aprendido a comprender sólo el papel de pared. Por lo tanto, no maravillaba que hubiesen contribuido tan poco al progreso de la biología.
La opinión de Schrödinger se salía de lo habitual. Que la vida era a la vez ordenada y complicada equivalía a repetir una perogrullada; ver la aperiodicidad como fuente de sus cualidades especiales bordeaba lo místico. En aquella época ni los matemáticos ni los físicos proporcionaron apoyo a la idea. No había instrumentos idóneos para analizar la irregularidad como elemento constitutivo de la vida. Ahora se dispone de ellos.
Aquí se intenta nada menos que la clasificación
de los ingredientes de un caos.
HERMAN MELVILLE,
Moby Dick
§. Nuevas creencias, nuevas definiciones§. Nuevas creencias, nuevas definiciones
§. La segunda ley, el rompecabezas del copo de nieve y el dado cargado
§. Oportunidad y necesidad
Hace veinte años Edward Lorenz reflexionaba sobre la atmósfera, Michel Hénon sobre las estrellas y Robert May sobre el equilibrio de la naturaleza. Benoît Mandelbrot era un matemático desconocido de la IBM, Mitchell Feigenbaum un estudiante no graduado del City College neoyorquino y Doyne Farmer un muchacho que crecía en Nuevo México. La inmensa mayoría de los científicos practicantes compartía un cuerpo de creencias acerca de la complejidad. Y creían en ellas con tanta fe, que no necesitaban expresarlas verbalmente. Sólo más tarde fue posible decir qué eran y someterlas a examen.Los sistemas simples se comportan de manera simple. Un artilugio mecánico como el péndulo, un pequeño circuito eléctrico o una población idealizada de peces en un estanque… Mientras estos sistemas pudieran reducirse a unas pocas leyes, bien entendidas y totalmente deterministas, su conducta a largo plazo sería estable y predecible.
El comportamiento complejo implica causas complejas. Un aparato mecánico, un circuito eléctrico, una población de animales en libertad, una corriente fluida, un haz de partículas, una tormenta, una economía nacional, en fin, cualquier sistema visiblemente inestable, impredecible o anárquico, tenía que obedecer a multitud de componentes independientes o estar sometido a influencias externas esclavas del azar.
Diferentes sistemas se comportan de manera distinta. El neurobiólogo que dedicaba su carrera a estudiar la química de las neuronas humanas, sin saber algo de la memoria o la percepción; el diseñador aeronáutico que utilizaba los túneles de pruebas para solventar problemas aerodinámicos, sin entender la matemática de las turbulencias; el economista que analizaba la psicología de las decisiones de compra, sin adquirir la destreza de pronosticar las tendencias a largo plazo, todos esos científicos y muchos más, convencidos de que los componentes de sus disciplinas eran diferentes, aceptaban como cosa lógica que habían de ser asimismo distintos los sistemas complicados, consistentes en miles de millones de esos componentes.
Ahora bien, eso ha cambiado en la actualidad. En veinte años, físicos, matemáticos, biólogos y astrónomos han establecido ideas variantes, sustitutivas. Los sistemas simples motivan comportamiento complejo. Los sistemas complicados causan comportamiento sencillo. Y, lo que es más importante, las leyes de la complejidad tienen validez universal, y se despreocupan de los detalles de los átomos constitutivos de un sistema.
El cambio no tuvo trascendencia inmediata para la multitud de científicos practicantes, fuesen físicos atómicos, neurólogos o matemáticos. Siguieron trabajando en las cuestiones que les planteaba la investigación en el seno de sus disciplinas. Pero sabían de algo llamado caos, y que algunos difíciles fenómenos habían sido explicados, y que de pronto otros parecían exigir nuevas explicaciones. Quien estudiaba las reacciones químicas en el laboratorio, las poblaciones de insectos en un experimento de campo, en el término de tres años, o las variaciones de las temperaturas oceánicas, no podía justificar del modo tradicional la presencia de fluctuaciones u oscilaciones inesperadas, es decir, ignorándolas. Para algunos aquello representó quebraderos de cabeza. Por otra parte, desde el punto de vista práctico, estaban al corriente de que había dinero del gobierno federal y de las industrias para facilitar la investigación de aquella ciencia de índole vagamente matemática. Creció en ellos la comprensión de que el caos ofrecía una forma reciente de manejar antiguos datos, olvidados en los cajones del escritorio, porque eran demasiado caprichosos e incoherentes. Pensaron cada vez con más convicción que el encajonamiento estanco de la ciencia oponía un obstáculo a su labor. Percibieron con acuidad que, con el decurso del tiempo, se intensificaba la inutilidad de estudiar las partes, haciendo salvedad del todo. Para ellos el caos era la desaparición del programa reduccionista en la ciencia.
Incomprensión; resistencia; enojo; aceptación. Quienes más habían luchado en favor de la causa del caos sufrieron todo aquello. Joseph Ford, del Georgia Institute of Technology, recordó que había dado una conferencia, en la década de 1970, a un grupo de especialistas en termodinámica, durante la cual mencionó que había comportamiento caótico en la ecuación de Duffing, modelo, bien conocido en los libros de texto, de un oscilador sencillo sometido a fricción. La existencia de caos en aquella ecuación era para Ford algo curioso, una de las cosas que sabía que eran ciertas, aunque transcurrieron varios años antes de que se proclamase en Physical Review Letters. Fue como si hubiese afirmado a una cohorte de paleontólogos que los dinosaurios tenían plumas.
— ¿Qué pasó cuando dije aquello? ¡Santo cielo! Los presentes se pusieron a brincar. Todo fue: «Mi papá se divirtió con la ecuación de Duffing, y mi abuelito se divirtió con la ecuación de Duffing, y nadie, ¡nadie!, encontró eso de lo que usted habla». Esperaba que se opusieran a la noción de que la naturaleza es complicada. Lo que no entendí fue tanta hostilidad.
Cómodamente instalado en su oficina de Atlanta, mientras el sol invernal agonizaba en el exterior, Ford bebía gaseosa en una jarra descomunal, en la que se había pintado, con brillantes colores, la palabra «caos». Su colega Ronald Fox, más joven, narró su conversión, poco después de haber comprado para su hijo un ordenador Apple II, en una época en que el físico que se respetase no adquiría tales máquinas para trabajar con ellas. Había oído que Mitchell Feigenbaum había descubierto leyes universales, que guiaban el comportamiento de las funciones de realimentación, y decidió escribir un programa corto para contemplar el comportamiento en la pantalla del Apple. Lo vio plasmado en ella: bifurcaciones en forma de horca y líneas estables que se rompían en dos, luego en cuatro y después en ocho; aparición del mismísimo caos y, dentro de él, asombrosa regularidad geométrica.
—En un par de días, se rehace todo lo de Feigenbaum —aseveró Fox.
Algunos científicos jugaron con aquellos programas durante cierto tiempo y los abandonaron. Otros no resistieron su atractivo. Fox perteneció a los que, teniendo conciencia de los límites de la ciencia lineal clásica, no los olvidaron. Sabía que se había acostumbrado a eliminar los problemas difíciles no lineales. El físico, en la práctica, acaba siempre por decir: He aquí una cuestión que me llevará al manual de las funciones especiales, que es el último lugar al que deseo ir, y estoy tan seguro como que he de morir que no recurriré a una máquina. Soy demasiado refinado para hacerlo.
—La imagen general de la no linealidad llamó la atención a mucha gente, despacio al principio y luego con rapidez progresiva —dijo Fox—. Todos los que la miraban obtenían algún fruto. Ahora volvemos a los problemas encontrados, cualesquiera que sean las ciencias que cultivemos. Hubo un punto en que renunciamos, porque se volvían no lineales. Al presente, sabemos cómo examinarlos, y por eso los rescatamos del olvido.
»Si un área crece de pronto, hay que atribuirlo a que un núcleo de personas siente que les ofrecerá algo, o que, si modifican sus investigaciones, serán muy bien recompensadas. El caos es para mí sueño. Promete que, si se entra en el juego, tal vez se haga saltar la banca.
No obstante, no hubo coincidencia de pareceres en cuanto al nombre y la definición que había que darle.
Philip Holmes, barbicano matemático y poeta de Cornell, procedente de Oxford: Las complicadas, aperiódicas y atractivas órbitas de ciertos sistemas dinámicos (por lo común hipo dimensionales).
Hao Bai-Lin, físico de China, que coleccionó muchos artículos históricos sobre el caos en un volumen de consulta: Una especie de orden sin periodicidad. Y: Campo de investigación que se extiende con rapidez y en el que matemáticos, físicos, hidrodinámicos, ecólogos y muchos otros han efectuado importantes contribuciones. Y: Clase ubicua y recientemente reconocida de fenómenos naturales.
H. Bruce Stewart, experto en matemáticas aplicadas en el Brookhaven National Laboratory (Laboratorio Nacional de Brookhaven) de Long Island: Comportamiento recurrente y, en apariencia, debido al azar en un sistema determinista simple (de regularidad semejante a la de un reloj).
Roderick V. Jensen, de la Universidad de Yale, físico teórico que explora la posibilidad del caos cuántico: El comportamiento irregular, imprevisible, de sistemas dinámicos deterministas no lineales.
James Crutchfield, del colectivo de Santa Cruz: Dinámica con entropía métrica positiva, pero finita. La traducción matemática es: Comportamiento que produce información (amplía pequeñas incertidumbres), pero que no es absolutamente impredecible.
Y Ford, que se proclama apóstol del caos: Dinámica libre al fin de las cadenas de orden y predectibilidad… Sistemas liberados para explorar al azar cada una de sus posibilidades dinámicas… Estimulante variedad, riqueza de elección, plétora de oportunidades.
John Hubbard, al examinar las funciones iterativas y la infinita frondosidad fractal del conjunto de Mandelbrot, consideró que el de caos era nombre de poca monta para describir su trabajo, puesto que implicaba azar. A su juicio, el mensaje imperioso consistía en que los procesos sencillos producían en la naturaleza magníficos edificios de complejidad sin azar. En la no linealidad y la realimentación se tenían los instrumentos necesarios para descifrar y desplegar estructuras tan ricas como el cerebro humano.
Para otros científicos, como Arthur Winfree, que exploraban la topología global de los sistemas biológicos, el de caos era nombre insuficiente por lo angosto. Daba a entender los sistemas muy sencillos, los diagramas unidimensionales de Feigenbaum y los atractores extraños bidimensionales y tridimensionales (y una fracción) de Ruelle. El caos hipo dimensional, presentía Winfree, era un caso particular. Le interesaban las leyes de la complejidad de múltiples dimensiones, y estaba convencido de que existían. Gran parte —demasiada— del universo parecía más allá del ámbito del caos hipo dimensional.
La revista Nature publicó un debate abierto y constante sobre si el clima de la Tierra seguía un atractor extraño. Los economistas procuraron reconocerlos en las tendencias del mercado de valores, pero hasta entonces habían fracasado. Los peritos en dinámica esperaron usar las herramientas del caos para explicar la turbulencia en su plenitud. Albert Libchaber, que ya formaba parte de la Universidad de Chicago, puso su elegante estilo experimental al servicio de la turbulencia, creando una caja de helio líquido miles de veces más grande que la minúscula de 1977. Nadie supo si tales experimentos, que liberaban desorden fluido en el espacio y el tiempo, encontrarían atractores sencillos. Como expresó el físico Bernardo Huberman:
—Si usted metiera una sonda en un río turbulento y dijese: «Miren, aquí hay un atractor extraño hipo dimensional», nos quitaríamos el sombrero con respeto y miraríamos.
El caos simbolizaba el conjunto de ideas que persuadía a aquellos científicos de que eran miembros de una empresa común. Todos, físicos, biólogos, matemáticos, etc., creían que los sistemas simples, deterministas, podían generar complejidad; que los excesivamente enrevesados para las matemáticas tradicionales obedecían a leyes sencillas; y que, en cualquiera de los campos que cultivaban, su tarea esencial consistía en comprender lo complejo.
§. La segunda ley, el rompecabezas del copo de nieve y el dado cargado
«Consideremos de nuevo las leyes de la termodinámica», escribió James E. Lovelock, autor de la hipótesis de Gaia. «Ciertamente, de buenas a primeras, suenan como el aviso puesto sobre la puerta del infierno de Dante…». Sin embargo…
La segunda ley es un dechado de malas noticias técnicas, la cual, partiendo de la ciencia, ha echado raíces hondas en la cultura general. Todo tiende al desorden. Cualquier proceso que cambie una forma de energía en otra pierde algo de calor. La eficacia perfecta es un sueño. El universo puede compararse a una calle de dirección única. La entropía debe crecer siempre en el universo y en cualquier sistema, hipotéticamente aislado, que haya en él. De cualquier manera que se formule, la segunda ley se presenta como regla inapelable. Eso es verdad en la termodinámica. Pero ha conquistado vida propia en reinos intelectuales muy alejados de la ciencia, en los que se la culpa de la desintegración de las sociedades, la decadencia económica, la destrucción de las buenas maneras y muchas otras variaciones del tópico del aumento de la imperfección. Ahora se consideran especialmente descaminadas esas encarnaciones colaterales y metafóricas de la segunda ley. La complejidad florece en nuestro mundo, y quienes recurren a la ciencia para entender de modo general los hábitos de la naturaleza quedarán más satisfechos con las leyes del caos.
Después de todo, en tanto que mengua hacia su equilibrio final, en el informe baño turco de la entropía máxima el universo se las arregla para crear estructuras interesantes. Los físicos reflexivos, a quienes interesa la acción de la termodinámica, se dan cuenta de cuán inquietante es la cuestión, como dijo uno de ellos, «de cómo una corriente de energía, falta de propósito determinado, aporta vida y consciencia al mundo». Forma parte del desconcierto la resbaladiza noción de la entropía, razonablemente bien definida con fines termodinámicos en términos de calor y temperatura, pero inverosímilmente ardua cuando hay que utilizarla como medida del desorden. Los físicos topan con sobradas dificultades en su deseo de medir el grado de orden en el agua, que compone estructuras cristalinas durante su transición al hielo, mientras la energía se disipa de modo incesante. La entropía termodinámica fracasa lamentablemente como medida del grado mutable de forma y de falta de ella en la creación de los aminoácidos, microorganismos, plantas y animales auto reproductores, y sistemas complejos de información, como el cerebro. Desde luego, esos islotes productores de orden han de obedecer a la segunda ley. Las leyes más importantes, las creadoras, se hallan en otra parte.
La naturaleza crea pautas y patrones. Unos están ordenados en el espacio y desordenados en el tiempo, y otros viceversa. Hay pautas fractales, que exhiben a escala estructuras similares a sí mismas. Otras producen estados estables u oscilantes. La formación de pautas y patrones se ha convertido en una rama de la física y la ciencia de los materiales, permitiendo que los científicos modelen la reunión de partículas de agregados, la dispersión fracturada de las descargas eléctricas, el crecimiento de cristales en el hielo y las aleaciones metálicas. Su dinámica parece muy básica —formas que se alteran en el espacio y el tiempo—; sólo ahora se poseen los instrumentos para comprenderlos. Ahora es lícito preguntar a un físico: « ¿Por qué todos los copos de nieve son distintos?».

Ramificación y agrupación.
El estudio de la formación de pautas, que ha estimulado la matemática fractal, unió algunas tan naturales como la trayectoria sesgada de una descarga eléctrica y la agrupación simulada de partículas que se mueven al azar (recuadro).

El desarrollo de tales puntas, dendritas, se acepta ahora como problema de límites inestables y libres, sumamente no lineal, por lo cual ha de entenderse que los modelos necesitan seguir una frontera complicada y culebreante al paso que se transforma. Cuando la solidificación va del exterior al interior, como en una cubeta, el límite suele permanecer estable y uniforme, porque las paredes tienen la facultad de irradiar calor y dominan la velocidad de formación. Pero cuando el cristal se solidifica hacia el exterior, a partir de un núcleo inicial —como el copo de nieve, que captura moléculas de agua mientras cae a través del aire cargado de humedad—, el proceso se hace inestable. Cualquier pizca de límite que se anticipe a sus vecinas tiene ventaja en recoger moléculas ácueas y, por consiguiente, crece más de prisa («efecto de pararrayos»). Se crean otras ramas y, luego, más sub ramas.
Una de las dificultades consistía en cuál de las muchas fuerzas físicas que mediaban era importante y de cuáles podía prescindirse. La principal, como hace mucho tiempo que saben los científicos, es la difusión del calor liberado por el agua al helarse. No obstante, no explica del todo los patrones que los investigadores observan con el microscopio en los copos de nieve o los que hacen en el laboratorio. Recientemente, han encontrado la manera de incorporar otro proceso: la tensión superficial. El corazón del nuevo modelo de copo es la esencia del caos: equilibrio delicado entre las fuerzas de la estabilidad y de la inestabilidad; interacción poderosa de fuerzas a escala atómica y otras a escala normal.

Contrapeso de la estabilidad y la inestabilidad.
Un líquido forma, al cristalizarse, una punta creciente (ésta es una fotografía de exposiciones múltiples), con un límite que se inestabiliza y emite ramas laterales (izquierda). Simulación de ordenador de los delicados procesos termodinámicos que ocurren en los verdaderos copos de nieve (abajo).
Los efectos de la tensión superficial son tan reducidos, que los investigadores se acostumbraron, con fines prácticos, a prescindir de ellos. Fue un error. Las escalas más minúsculas resultaron cruciales; en ellas los efectos superficiales mostraron que eran infinitamente sensibles a la estructura molecular de una sustancia que se solidificaba. En el hielo, una simetría molecular natural proporciona una preferencia intrínseca al crecimiento en seis direcciones. Los científicos se sorprendieron al descubrir que la mezcla de estabilidad e inestabilidad amplía esta preferencia microscópica, que crea la labor de encaje cuasi fractal de los copos de nieve. Las matemáticas oportunas se debieron no a los meteorologistas, sino a los físicos teóricos, y también a los metalurgistas, interesados en la cuestión. La simetría molecular de los metales es diferente y, asimismo, los cristales peculiares que contribuyen a especificar la fuerza de una aleación. Pero las matemáticas son idénticas, porque las leyes de la formación de pautas y patrones tienen validez universal.
La dependencia sensitiva de las condiciones iniciales crea en vez de destruir. Cuando un copo de nieve en formación desciende hacia el suelo, flotando típicamente en el aire durante una hora, o más tiempo, la elección que efectúan las puntas bifurcantes, en un instante dado, depende sensitivamente de cosas tales como la temperatura, la humedad y la existencia de impurezas en la atmósfera. Las seis puntas de un copo, extendiéndose en un espacio milimétrico, están expuestas a la misma temperatura, y, ya que las leyes del crecimiento son deterministas, mantienen una simetría casi perfecta. Pero, debido a la índole del aire turbulento, cualquier par de copos seguirá caminos muy diversos. El definitivo archiva la historia de todas las condiciones cambiantes del tiempo atmosférico que ha experimentado. Y las combinaciones llegan a ser infinitas.
Los copos de nieve, como los físicos se complacen en decir, son fenómenos sin equilibrio. Proceden de la descompensación del flujo de energía de un objeto natural a otro. El flujo transforma un límite en una punta, la punta en una expansión en ramas, y la expansión en una estructura compleja jamás presenciada hasta entonces. Así que han descubierto que esa inestabilidad se somete a las leyes universales del caos, los científicos han aplicado los mismos métodos a multitud de problemas físicos y químicos. E, inevitablemente, sospechan que será posible hacer lo mismo en biología. En el fondo de sus mentes, mientras observan las simulaciones de ordenador de un desarrollo dendrítico, ven algas, tabiques celulares y organismos que germinan y se dividen.
Al presente, parece haber muchos caminos de acceso desde las partículas microscópicas a la complejidad cotidiana. En la física matemática, la teoría de la bifurcación de Feigenbaum y sus colegas prospera en los Estados Unidos y Europa. En el cuerpo abstracto de la física teórica, los científicos abordan cuestiones hasta ahora no estudiadas, como la del caos cuántico, aún no zanjada: ¿Admite la mecánica cuántica los fenómenos caóticos de la clásica? En el estudio de los fluidos móviles, Libchaber construye su enorme caja de helio líquido, y Pierre Hohenberg y Günter Ahlers analizan las ondas de la convección, de figuras tan raras. Los expertos en el caos emplean en astronomía inesperadas inestabilidades gravitacionales para aclarar el origen de los meteoritos, la aparición, al pronto inexplicable, de asteroides desde mucho más allá de Marte. Los científicos utilizan la física de los sistemas dinámicos para estudiar el inmunológico humano, con sus miles de millones de componentes y su capacidad de aprender, recordar y reconocer pautas, y, al mismo tiempo, investigan la evolución con la esperanza de encontrar mecanismos universales de adaptación. Quienes hacen tales modelos ven en seguida estructuras que se copian, compiten y se desarrollan por selección natural.
«La evolución es caos con realimentación», escribió Joseph Ford. El universo se compone de azar y disipación, sí. Pero el azar con dirección llega a producir complejidad asombrosa. Y, como Lorenz descubrió hace tanto tiempo, la disipación es agente de orden.
«Dios juega a los dados con el universo», replica Ford a la célebre pregunta de Einstein. «Pero con dados cargados. Y el principal objetivo de la física actual es averiguar según qué reglas fueron cargados y cómo podremos utilizarlos para nuestros fines».
§. Oportunidad y necesidad
Ideas como las señaladas contribuyen al progreso de la empresa colectiva de la ciencia. Sin embargo, no hay filosofía, prueba o experimento con vigor suficiente para desengañar a los investigadores que creen que la ciencia debe proporcionar ante todo y siempre un método de trabajo. Lo clásico falla en algunos laboratorios. La ciencia normal se extravía, según palabras de Kuhn; un elemento del equipo no responde a lo esperado; «la profesión no puede continuar eludiendo las anomalías». Sin embargo, para los científicos, las ideas del caos no han de prevalecer hasta que el método del caos sea necesario.
Todos los campos proporcionaron ejemplos. Había en ecología Wilson M. Schaffer, el último discípulo de Robert McArthur, decano de la disciplina en los años cincuenta y sesenta. McArthur había edificado una concepción de la naturaleza que prestaba base firme a la noción de equilibrio natural. Sus modelos suponían que habría equilibrios y que las poblaciones de plantas y animales permanecerían contiguas a ellos. Para McArthur, aquello tenía algo que casi podía definirse como cualidad moral: los estados de equilibrio de sus modelos acarreaban el empleo más eficaz de los recursos alimentarios y, por lo tanto, el desperdicio mínimo. La naturaleza, si no se intervenía en ella, sería buena.
Veinte años después, el último estudiante de McArthur se sorprendió pensando que estaba condenada al fracaso la ecología fundada en la idea de equilibrio. La predisposición lineal traiciona los modelos clásicos. La naturaleza es más complicada. En su lugar ve el caos, «a la vez estimulante y un poco amenazador». Quizá llegue a minar los presupuestos ecológicos más resistentes, anuncia a sus colegas. «Lo que pasa por conceptos básicos en ecología se asemeja a la niebla ante la furia de la tempestad, en este caso una tempestad total y no lineal».
Schaffer usa atractores extraños para explorar la epidemiología de enfermedades infantiles, tales como el sarampión y las viruelas locas. Ha acopiado datos en las ciudades de Nueva York y Baltimore, en primer lugar, y después en Aberdeen (Escocia) y en toda Inglaterra y Gales. Ha compuesto un modelo dinámico semejante a un péndulo amortiguado. Las enfermedades sobrevienen anualmente por contagio entre los niños que vuelven a la escuela, y las amortigua su resistencia natural. El modelo de Schaffer predice que tales dolencias tendrán comportamiento llamativo por lo diferente: las viruelas locas han de variar periódicamente, y el sarampión, caóticamente. Y los datos cumplen con exactitud sus predicciones. Las variaciones anuales carecían de explicación para el epidemiólogo tradicional: dependían del azar y eran inestables. Schaffer muestra, con las técnicas de la reconstrucción del espacio de fases, que el sarampión obedece a un atractor extraño, cuya dimensión fractal es alrededor de 2,5.
Había computado exponentes de Lyapunov y trazado mapas de Poincaré.
—Más puntualmente —dijo—: cuando se contempla, la imagen salta a la cara y uno exclama « ¡Dios mío! Es lo mismo».
Aunque el atractor sea caótico, la índole determinista del modelo consiente cierta predectibilidad. A un año de alta incidencia del sarampión, sigue uno de desplome vertical; a uno de infección media, el índice cambia levemente. Y uno de contagio reducido suscita enorme impredecibilidad. El modelo de Schaffer pronosticó también las consecuencias de moderar la dinámica con programas de vacunación multitudinaria, que no podía vaticinar la epidemiología clásica.
Las nociones del caos avanzan en diferentes sentidos, y por distintas razones, en las escalas colectiva y personal. Para Schaffer, como para tantos otros, la transición desde la ciencia tradicional al caos ocurrió de forma inesperada. Era blanco perfecto para la apología «mesiánica» que Robert May publicó en 1975; no obstante, leyó el artículo y lo descartó. Juzgó que las ideas matemáticas no podían ser adecuadas para la clase de sistemas que estudia el ecologista práctico. Sabía demasiada ecología para apreciar lo expuesto por May. Si eran diagramas unidimensionales, se dijo, ¿qué relación tenían con sistemas que cambiaban sin tregua? Un colega le propuso: «Consulte a Lorenz». Anotó la referencia en un papel y jamás se molestó en buscar el texto.
Años más tarde, Schaffer vivió en el desierto próximo a Tucson (Arizona). Los estíos le encontraron en los montes Santa Catalina, al norte, islas de chaparros, en las que sólo hacía calor cuando el suelo desértico abrasaba. En aquellos sotos, durante los meses de junio y julio, tras la floración primaveral y antes de las lluvias veraniegas, Schaffer y sus estudiantes graduados examinaron abejas y flores de especies diferentes. Aquel sistema ecológico se ponderaba con facilidad, a pesar de sus variaciones anuales. Schaffer contó las abejas en todas las corolas, midió el polen con pipetas y analizó los datos matemáticamente. Los abejorros competían con las abejas mielíferas, y éstas con las carpinteras, y Schaffer hizo un modelo convincente para explicar las fluctuaciones de la población.
En 1980 notó que algo no marchaba bien. Su modelo se vino abajo. El actor trascendental era un animal que no había tenido en cuenta: las hormigas. Algunos de sus colegas echaron la culpa al tiempo invernal anómalo; y otros, al estival, no menos anómalo. Schaffer pensó en complicar su modelo con más variables. Pero se sentía frustrado hasta las entretelas del corazón. Corrió la voz entre los graduados de que no era una bicoca pasar el verano con él a 1.500 metros de altitud… Y todo cambió de pronto.
Schaffer encontró por casualidad una separata sobre el caos químico, observado en un enrevesado experimento de laboratorio, y presintió que los autores habían sufrido el mismo problema que él: la imposibilidad de advertir las docenas de reacciones de productos dentro de un recipiente casaba con la de tener en cuenta docenas de especies en los montes de Arizona. Con todo, habían triunfado donde él había fracasado. Leyó, por fin, lo referente a la reconstrucción del espacio de fases. Leyó a Lorenz, Yorke, etc. La Universidad de Arizona patrocinó una serie de conferencias sobre «El orden en el caos». Harry Swinney compareció, y Swinney dominaba el arte de describir los experimentos. Cuando explicó el caos químico, mostró la diapositiva de un atractor extraño y sentenció: «He aquí el dato auténtico», Schaffer sintió un escalofrío.
—Supe de pronto que aquél era mi destino —dijo.
Disponía de un año sabático. Retiró la solicitud de financiación presentada en la National Science Foundation y pidió una beca Guggenheim. En las montañas, las hormigas cambiaban con las estaciones. Las abejas revoloteaban y se disparaban con zumbido dinámico. Las nubes se deslizaban por el firmamento. No volver a trabajar a la antigua.

Notas sobre las fuentes y bibliografía
Este libro se basa en las palabras de unos doscientos científicos, en conferencias públicas, en escritos técnicos y, sobre todo, en entrevistas efectuadas entre abril de 1984 y diciembre de 1986. Algunos consultados son especialistas en el caos; otros no. Varios se prestaron a ceder muchas horas de su tiempo, durante meses enteros, y expusieron visiones de la historia y la práctica de la ciencia que no pueden acreditarse de otro modo. Unos pocos proporcionaron memorias que no han sido publicadas.Existen escasas fuentes de información secundaria sobre el caos, y el lector profano que desee ampliar sus conocimientos topará con dificultades en la satisfacción de sus propósitos. Tal vez la primera introducción general al caos —conserva aún el aroma de la cuestión y presenta parte de las matemáticas fundamentales— sea la sección que Douglas R. Hofstadter firmó, en noviembre de 1981, en Scientific American, y que ha sido reimpresa en Metamagical Themas (Nueva York: Basic Books, 1985). Dos colecciones útiles de los artículos científicos más influyentes son Chaos de Hao Bai-Lin (Singapur: World Scientific, 1984) y Universality in Chaos, de Predrag Cvitanović (Bristol: Adam Hilger, 1984). Estas selecciones apenas presentan coincidencias; y la primera de ellas quizá tenga orientación algo más histórica. Para quienes interese el origen de la geometría fractal, la fuente indispensable, enciclopédica y exasperante, es The Fractal Geometry of Nature, de Benoît Mandelbrot (Nueva York: Freeman, 1977). The Beauty of Fractals, de Heinz-Otto Peitgen y Peter H. Richter (Berlín: Springer-Verlag, 1986), escudriña muchas porciones de las matemáticas del caos al estilo romántico europeo, con valiosos ensayos de Mandelbrot, Andrien Douady y Gert Eilenberger; contiene numerosas representaciones gráficas en color y en blanco y negro, varias de las cuales se reproducen en la presente obra. Un texto bien ilustrado y destinado a los ingenieros y personas que busquen una exposición práctica de las ideas matemáticas es Nonlinear Dynamics and Chaos, de H. Bruce Stewart y J. M. Thompson (Chichester: Wiley, 1986). Ninguno de estos libros será útil a los lectores que carezcan de conocimientos técnicos rudimentarios.
En la presentación de los hechos, motivos y perspectivas de los científicos, he procurado evitar, dentro de lo posible, el lenguaje de la ciencia, dando por sentado que las personas preparadas sabrán de qué se trata cuando se hable de integrabilidad, ley de la distribución de energía o análisis complejo. Los lectores interesados en la presentación matemática o en referencias específicas recurrirán a las notas expuestas por capítulos. En la selección de unas cuantas revistas, entre los millares que pudiera haber citado, me he decidido por aquellas que influyeron más directamente en los hechos aquí narrados, o que sean más útiles, en sentido amplio, a quienes prefieran disponer de explicaciones más precisas sobre las ideas que les interesen.
Las descripciones de lugares se basan por lo regular en mis visitas a ellos. Las siguientes instituciones pusieron a mi servicio sus investigadores, bibliotecas y, en varios casos, equipos de ordenadores: Universidad de Boston, Universidad de Cornell, Courant Institute of Mathematics, European Centre for Medium Range Weather Forecasts, Georgia Institute of Technology, Universidad de Harvard, Thomas J. Watson Research Center de la IBM, Institute for Advanced Study, Lamont-Doherty Geophysical Observatory, Los Alamos National Laboratory, Massachusetts Institute of Technology, National Center of Atmospheric Research, National Institutes of Health, National Meteorological Center, Universidad de Nueva York, Observatoire de Nice, Universidad de Princeton, Universidad de California en Berkeley, Universidad de California en Santa Cruz, Universidad de Chicago, Woods Hole Oceanographic Institute y Xerox Palo Alto Research Center.
Las notas que van a continuación señalan mis principales fuentes sobre citas e ideas particulares. Proporciono cita completa de libros y artículos; cuando se menciona un solo apellido, la referencia implica a uno de los científicos siguientes, cuya colaboración ha sido muy útil para mis investigaciones:

NOTA: Los números de página se refieren a la edición en papel.
Prólogo
9 Los Álamos Feigenbaum, Carruthers, Campbell, Farmer, Visscher, Kerr, Hasslacher, Jen.10 «Sé que es usted» Feigenbaum, Carruthers.
13 Programas gubernamentales Buchal, Shlesinger, Wisniewski.
13 Elementos del movimiento Yorke.
13 Del proceso antes que del estado F. K. Browand, «The Structure of the Turbulent Mixing Layer», Physica 18D (1986), pág. 135.
13 Comportamiento de los automóviles Los científicos japoneses se tomaron muy en serio los problemas del tráfico; por ejemplo, Toshimit su Musha e Hideyo Higuchi, «The Uf Fluctuation of a Traffic Current on an Expressway», Japanese Journal of Applied Physics (1976), páginas 1271-75.
14 El hecho de haberse dado cuenta de ello Mandelbrot, Ramsey; Wisdom, Marcus; Alvin M. Saperstein, «Chaos – A Model for the Outbreak of War», Nature 309 (1984), págs. 303-5.
14 «Hace quince años» Shlesinger.
14 Sólo por tres cosas Shlesinger.
14 La tercera gran revolución Ford.
14 «La relatividad eliminó» Joseph Ford, «What Is Chaos, That We Should Be Mindful of It?», separata, Georgia Institute of Technology, pág. 12.
15 El cosmólogo John Boslough, Stephen Hawking’s Universe (Cambridge: Cambridge University Press, 1980), véase también Robert Shaw, The Dripping Faucet as a Model Chaotic System (Santa Cruz: Aerial, 1984), pág. 1.
El efecto de la mariposa
27 El tiempo atmosférico simulado Lorenz, Marcus, Spiegel, Farmer. Lo esencial de Lorenz es un tríptico de artículos cuyo centro ocupa «Deterministic Nonperiodic Flow», Journal of the Atmospheric Sciences 20 (1963), págs. 130-41; lo flanquean «The Mecanics of Vacillation», Journal of the Atmospheric Sciences 20 (1963), págs. 448-64, y «The Problem of Deducing the Climate from the Governing Equations», Tellus 16 (1964), págs. 1-11. Representan una obra, engañosamente elegante, que aún influye, al cabo de veinte años, en matemáticos y físicos. Algunos recuerdos personales de Lorenz de su primer modelo atmosférico de ordenador aparecen en «On the Prevalence of Aperiodicity in Simple Systems», en Global Analysis, eds. M. Grmela y J. Marsdem (Nueva York: Springer-Verlag, 1979), págs. 53-75.28 Fueron reglas numéricas Una descripción contemporánea de Lorenz, muy legible, del empleo de ecuaciones para establecer un modelo de la atmósfera es «Large-Scale Motions of the Atmosphere: Circulation», en Advances in Earth Science, ed. P. M. Hurley (Cambridge, Mass.: The MIT Press, 1966), págs. 95-109. Análisis inicial e influyente de este problema es Weather Prediction by Numerical Process, de L. F. Richardson (Cambridge: Cambridge University Press, 1922).
29 Pureza de las matemáticas. Lorenz. Asimismo, una exposición de la influencia contradictoria de las matemáticas y la meteorología en su pensamiento es «Irregularity: A Fundamental Property of the Atmosphere», Crafoord Prize Lecture presentada en la Real Academia Sueca de Ciencias, Estocolmo, en 28 de septiembre de 1983, en Tellus 36A (1984), págs. 98-110.
30 «Abarcaría en la misma fórmula» A Philosophical Essay on Probabilities de Pierre-Simon Laplace (Nueva York: Dover, 1951).
31 «La idea básica» Winfree.
32 «Es la clase de regla» Lorenz.
33 Se le ocurrió al pronto «On the Prevalence», pág. 55.
33 Los errores ínfimos fueron catastróficos De todos los físicos y matemáticos clásicos que reflexionaron sobre los sistemas dinámicos, el que mejor comprendió la posibilidad del caos fue Jules-Henri Poincaré. Comentó en Ciencia y método:
«Una pequeñísima causa, que escapa a nuestra percepción, determina un efecto considerable, que hemos de ver forzosamente, y entonces decimos que el efecto se debe al azar. Si conociésemos bien las leyes de la naturaleza, y la situación del universo en el momento inicial, conseguiríamos predecir exactamente la situación del mismo universo en un momento siguiente. Más, incluso en el caso de que las leyes naturales no nos ocultasen sus secretos, continuaríamos sabiendo la situación sólo de manera aproximada. Si eso nos facultase a pronosticar la situación sucesiva con la misma aproximación, no necesitaríamos más, y afirmaríamos que el fenómeno se vaticinó y que las leyes gobiernan todo. Sin embargo, no ocurre siempre así; acaso suceda que pequeñas diferencias en las condiciones iniciales produzcan unas muy grandes en el fenómeno definitivo. Un leve error en las primeras se convertirá en uno colosal en el segundo. Se hace imposible predecir…».
Se olvidó el aviso de Poincaré, pronunciado en el cambio de siglo. En los Estados Unidos, el único matemático que atendió con seriedad a Poincaré en las décadas de 1920 y 1930 fue George D. Birkhoff, quien por curiosa casualidad enseñó durante breve tiempo en el MIT al estudiante Edward Lorenz.
34 «No habíamos tenido éxito» Lorenz.
35 Los años de 1950 y 1960 se caracterizaron Woods, Schneider; amplia revisión de los pareceres expertos de entonces fue «Weather Scientists Optimistic That New Findings Are Near», The New York Times, 9 de septiembre de 1963, pág. 1. 35 Von Neumann imaginó Dyson.
35 Una vasta y costosa burocracia Bonner, Bengtsson, Woods, Leith.
37 Previsiones sobre el crecimiento económico «Expectation and Prediction», de Peter B. Medawar, en Pluto’s Republic (Oxford: Oxford University Press, 1982), págs. 301-4.
37 El efecto de la mariposa Lorenz empleó de momento la imagen de una gaviota; el nombre más duradero parece haber salido de su artículo «Predictability: Does the Flap of a Butterfly’s Wings in Brazil Set of a Tornado in Texas?», discurso pronunciado en la reunión anual de la American Association for the Advancement of Science en Washington (29 de diciembre de 1979).
38 Supóngase que la Tierra Yorke.
38 «Nada de predicción» Lorenz, White.
39 Debía de haber un eslabón «The Mechanics of Vacillation».
40 «Por un clavo» George Herbert; citado en este contexto por Norbert Wiener, «Nonlinear Prediction and Dynamics», en Collected Works with Commentaries, ed. P. Masani (Cambridge, Mass.: The MIT Press, 1981), 3:371. Wiener se anticipó a Lorenz en ver al menos la posibilidad de «auto ampliación de los detalles pequeños del mapa meteorológico». Notó: «Un tornado es un fenómeno muy localizado y aparentes nonadas, de escasa extensión, quizá decidan su trayectoria exacta».
41 «El carácter de la ecuación» John von Neumann, «Recent Theories of Turbulence» (1949), en Collected Works, ed. A. H. Taub (Oxford: Pergamon Press, 1963), 6:437.
42 Taza de café recién hecho «The Predictability of Hydrodynamic Flow», en Transactions of the New York Academy of Sciences II:25:4 (1963), págs. 409-32.
42 «Quizá nos cueste pronosticar» Ibíd., pág. 410.
42 Lorenz despojó hasta los huesos La serie de siete ecuaciones para representar el modelo de la convección fue ideada por Barry Saltzman, de la Universidad de Yale, al cual Lorenz visitó. Por lo común, las ecuaciones de Saltzman se portaban periódicamente, pero una versión «se negó a reposar», como dijo Lorenz, quien advirtió que, durante el comportamiento caótico, cuatro variables se aproximaban a cero, por lo que podían ser descartadas. Barry Saltzman, «Finite Amplitude Convection as an Initial Value Problem», Journal of the Atmospheric Sciences 19 (1962), pág. 329.
44 Geodínamo Malkus; la idea del caos en los campos magnéticos terrestres todavía se debate con calor, y algunos científicos buscan otras explicaciones, de origen externo, como los impactos de grandes meteoritos. Una exposición inicial del concepto de que las inversiones se deben al caos inherente al sistema se debe a K. A. Robbins, «A Moment Equation Description of Magnetic Reversals in the Earth», Proceedings of the National Academy of Science73 (1976), 4297-4301.
44 Rueda de agua o noria Malkus.
47 Tres ecuaciones Este modelo clásico, que suele llamarse sistema de Lorenz, es:
dx/dt = 10(y − x)
dy/dt = xz + 28x − y
dz/dt = xy − (8/3)z.
49 A nadie se le ocurrió La comunidad científica, mediada la década de 1960, citó alrededor de una vez al año «Deterministic Nonperiodic Flow»; dos decenios más tarde, las citas anuales ascienden a más de un centenar.
Revolución
51 El historiador de la ciencia Se ha analizado y debatido sobradamente cómo entendió Kuhn las revoluciones científicas durante los cinco lustros transcurridos desde que manifestó su parecer, más o menos en la época en que Lorenz programaba su modelo de ordenador del tiempo atmosférico. Sobre las opiniones de Kuhn me he basado ante todo en The Structure of Scientific Revolutions, 2 fl ed. ampliada (Chicago: University of Chicago Press, 1970), y de modo secundario en The Essential Tension: Selected Studies in Scientific Tradition and Change (Chicago: University of Chicago, 1977); «What Are Scientific Revolutions?» (Ocassional Paper Nº 18, Center for Cognitive Science, Massachusetts Institute of Technology); y entrevista con Kuhn. Otro análisis útil e importante sobre la cuestión es I. Bernard Cohen, Revolution in Science (Cambridge, Mass.: Belknap Press, 1985).51 «No conseguí entender» Structure, págs. 62-65, citando a J. S. Bruner y Leo Postman, «On the Perception of Incongruity: A Paradigm», Journal of Personality XVIII (1949), pág. 206.
52 Operaciones de limpieza Structure, pág. 24.
52 Los experimentalistas ejecutan Tension, pág. 229.
52 En la época de Benjamin Franklin Structure, págs. 13-15.
53 «En condiciones normales» Tension, pág. 234.
53 Un físico atómico Cvitanović.
54 Tolstoi Ford, entrevista y «Chaos: Solving the Unsolvable, Predicting the Unpredictable», en Chaotic Dynamics and Fractals, eds. M. F. Barnsley y S. G. Demko (Nueva York: Academic Press, 1985).
55 Palabras como éstas sonaron Pero Michael Berry observa que el OED (Oxford English Dictionary) admite «caología» (infrecuente), «la historia o descripción del caos». Berry, «The Unpredictable Bouncing Rotator: A Chaology Tutorial Machine», separata, H. H. Wills Physics Laboratory, Bristol.
55 «Es un masoquismo» Richter.
55 Estos resultados se manifiestan J. Crutchfield, M. Nauenberg y J. Rudnick, «Scaling for External Noise at the Onset of Chaos», Physical Review Letters 46 (1981), pág. 933.
55 El corazón del caos Alan Wolf, «Simplicity and Universality in the Transition to Chaos», Nature 305 (1983), pág. 182.
55-56 El caos presagia Joseph Ford, «What is Chaos, That We Should Be Mindful of It?», separata, Georgia Institute of Technology, Atlanta.
56 Las revoluciones no se declaran «What Are Scientific Revolutions?», pág. 23.
56 «Es algo así como» Structure, pág. 111.
56 La rata de laboratorio Yorke y otros.
57 Aristóteles, al observar el péndulo «What Are Scientific Revolutions?», págs. 2-10.
57 «Si dos amigos se ponen» Galileo, Opere VIII: 277. También VIII: 129130.
59 «La medicina fisiológica y psiquiátrica» David Tritton, «Chaos in the swing of a pendulum», New Scientist, 24 de julio de 1986, pág. 37. Es un ensayo muy legible y de carácter no ético sobre las inferencias filosóficas que se extraen del caos pendular.
59 Es posible En realidad, cualquiera que empuje un columpio produce siempre un movimiento más o menos regular, debido, por lo visto, a que usa un mecanismo inconsciente de realimentación no lineal.
59 Pero, por extraño que parezca Entre los muchos análisis de las posibles complicaciones de un péndulo sencillo, puede utilizarse como buen sumario D. D’Humiéres, M. R. Beasley, B. A. Huberman y A. Libchaber, «Chaotic States and Routes to Chaos in the Forced Pendulum», Psysical Review A 26 (1982), págs. 3483-96.
60 «Bolas espaciales» Michael Berry investigó teórica y experimentalmente los comportamientos físicos de este juguete. En «The Unpredictable Bouncing Rotator» describe una porción de ellos sólo comprensibles desde el punto de vista de la dinámica caótica: «KAM tori, bifurcation of periodic orbits, Hamiltonian chaos, estable fixed points and strange attractors».
62 Un astrónomo francés Hénon.
62 Un ingeniero eléctrico japonés Ueda.
62 Un físico joven Fox.
62 Smale Smale, Yorke, Guckenheimer, Abraham, May, Feigenbaum; una exposición breve, y algo anecdótica, del pensamiento de Smale en este período es «On How I Got Started in Dynamical Systems», en Steve Smale, The Mathematics of Time: Essays on Dynamical Systems, Economic Processes, and Related Topics (Nueva York: Springer-Verlag, 1980), págs. 147-51.
63 Lo ocurrido en Moscú Raymond H. Anderson, «Moscow Silences a Critical American», The New York Times, 27 de agosto de 1966, pág. 1; Smale, «On the Steps of Moscow University», The Mathematical Intelligencer 6:2, págs. 21-27.
63 De vuelta a California Smale.
65 Un colega le informó por carta El colega era N. Levinson. Se reunieron así varias orientaciones matemáticas, que se remontaban a Poincaré. Una era la obra de Birkhoff. En Inglaterra, Mary Lucy Cartwright y J. E. Littlewood examinaron los indicios descubiertos por Balthasar Van der Pol en los osciladores caóticos. Estos matemáticos tenían buen conocimiento de la posibilidad de que hubiera caos en los sistemas sencillos; pero Smale, como la mayor parte de los matemáticos formados tradicionalmente, ignoraba su labor. Fue necesaria la carta de Levinson para enterarle de ella.
66 Sólido y raro Smale; «On How I Got Started».
66 Nos referimos a un tubo de vacío Van der Pol describió su trabajo en Nature 120 (1927), págs. 363-64.
66 «A menudo se percibe en el teléfono» Ibíd.
69 Una versión simple La exposición matemática definitiva de Smale de este trabajo es «Differentiable Dynamical Systems», Bulletin of the American Mathematical Society 1967, págs. 747-817 (también en The Mathematics of Time, págs. 1-82).
69 El proceso remeda Riissler.
69 Pero lo suprimido resultó Yorke.
70 Era una edad de oro Guckenheimer, Abraham.
70 «Es el cambio paradigmático» Abraham.
70 Un modesto enigma cósmico Marcus, Ingersoll, Williams; Philip S. Marcus, «Coherent Vortical Features in a Turbulent Two-Dimensional Flow and the Great Red Spot of Jupiter», comunicación presentada en la 110ª reunión de la Acoustical Society of America, Nashville, Tennessee, 5 de noviembre de 1985.
70 «La Mancha Roja alborotada» John Updike, «The Moons of Jupiter», en Facing Nature (Nueva York: Knopf, 1985), pág. 74.
72 El Voyager duplicó Ingersoll; también, Andrew P. Ingersoll, «Order from Chaos: The Atmospheres of Jupiter and Saturn», Planetary Report4:3, págs. 8-11.
73 «Uno ve a gran escala» Marcus.
74 « ¡Eh! ¿Qué es esta especie?» Marcus.
Altibajos de la vida
75 Pez famélico May Schaffer, Yorke, Guckenheimer. El célebre artículo en que May reseñó las lecciones del caos en la biología de la población se titula «Simple Mathematical Models with Very Complicated Dynamics», Nature 261 (1976), págs. 459-67. También: «Biological Populations with Nonoverlapping Generations: Stable Points, Stable Cycles, and Chaos», Science 186 (1974), págs. 645-47; y May y George F. Oster, «Bifurcations and Dynamic Complexity in Simple Ecological Models», The American Naturalist 110 (1976), págs. 573-99. Una excelente visión del desarrollo de los modelos matemáticos de las poblaciones, antes del caos, es Sharon E. Kingsland, Modeling Nature: Episodes in the History of Population Ecology (Chicago: University of Chicago Press, 1985).75 El mundo ofrece May y Jon Seger, «Ideas in Ecology: Yesterday and Tomorrow», separata, Princeton University, pág. 25.
76 Caricaturas de lo real May y George F. Oster, «Bifurcations and Dynamic Complexity in Simple Ecological Models», The American Naturalist 110 (1976), pág. 573.
80 En la década de 1950 May.
81 Los libros de consulta J. Maynard Smith, Mathematical Ideas in Biology (Cambridge: Cambridge University Press, 1968), pág. 18; Harvey J. Gold, Mathematical Modeling of Biological Systems.
81 Escondida en algún rincón May.
82 Su informe sobre cómo Gonorrhea Transmission Dynamics and Control, Herbert W. Hethcote and James A. Yorke (Berlín: Springer-Verlag, 1984).
82 El método de limitar con cupos. Con simulaciones de ordenador, Yorke averiguó que el método obligaba a los conductores a visitar la gasolinera con mayor frecuencia y a tener siempre lleno el depósito; de tal suerte, se acrecentaba la cantidad de gasolina que permanecía sin consumo en los automóviles del país en cualquier momento.
82 Analizó la sombra que proyectaba Los registros de los aeropuertos probaron más tarde que York había acertado.
82-83 El artículo de Lorenz Yorke.
83 «Los miembros de la facultad» Murray Gell-Mann, «The Concept of the Institute», en Emerging Synthesis in Science, actas de los talleres del Santa Fe Institute (Santa Fe: The Santa Fe Institute, 1985), pág. 11.
84 Entregó una copia Yorke, Smale.
85 «Si se puede escribir» Yorke.
85 Hasta qué extremo la naturaleza no lineal Un ensayo comprensible sobre la linealidad, la no linealidad y el uso histórico de los ordenadores para entender la diferencia, se tiene en David Campbell, James P. Crutchfield, J. Doyne Farmer y Erica Jen, «Experimental Mathematics: The Role of Computation in Nonlinear Science», Communications of the Association for Computing Machinery 28 (1985), págs. 374-84.
85 «La Biblia no dice» Fermi, citado en S. M. Ulam, Adventures of a Mathematician (Nueva York: Scribners, 1976). Ulam describe asimismo el origen de otra importante orientación en la comprensión de la no linealidad: el teorema de Fermi-Pasta-Ulam. Buscando problemas que pudieran calcularse con el nuevo ordenador MANIAC de Los Álamos, los científicos recurrieron a un sistema dinámico que era sólo una cuerda vibrante, modelo sencillo que «tenía, además, un pequeño término no lineal físicamente correcto». Hallaron pautas que se fundían en inesperada periodicidad. Como Ulam lo refiere: «Los resultados fueron por completo distintos cualitativamente de lo que incluso Fermi, con su gran sabiduría en movimientos ondulados, había esperado… Con gran sorpresa nuestra, la cuerda se puso a jugar a una partida de sillas que se eliminan al son de la música…». Fermi no dio importancia al fenómeno, y los resultados no tuvieron mucha publicidad, aunque unos pocos matemáticos y físicos los siguieron, y se convirtieron en parte especial de la leyenda de Los Álamos. Adventures, págs. 226-28.
85 «Animales no elefantes» Pasaje citado en «Experimental Mathematics», pág. 374.
85 «El primer mensaje» Yorke.
86 El artículo sobresalió Escrito en colaboración con el estudiante TienYien Li. «Period Three Implies Chaos», American Mathematical Monthly 82 (1975), págs. 985-92.
86 May había llegado a la biología May.
87 « ¿Qué diablos sucede?» May. Fue esta pregunta, en apariencia sin respuesta, la que le llevó de los métodos analíticos a la experimentación numérica, en busca, por lo menos, de intuición.
91 Bien que fuera detonante Yorke.
91 A. N. Sarkovski «Coexistencia de ciclos de un diagrama continuo de una sola línea en sí mismo», Ukrainian Mathematics Journal 16 (1964), pág. 61.
94 Los matemáticos y físicos soviéticos Sinai, confidencia personal, 8 de diciembre de 1986.
94 Algunos expertos occidentales en el caos Por ejemplo, Feigenbaum, Cvitanović.
95 Para calar en el sistema Hoppensteadt, May.
95 El pasmo de aquel momento Hoppensteadt.
96 Dentro de la ecología May.
97 Epidemias de sarampión en Nueva York William M. Schaffer y Mark Kot, «Nearly One-Dimensional Dynamics in an Epidemic», Journal of Theoretical Biology 112 (1985), págs. 403-27; Schaffer, «Stretching and Foldin in Lynx Fur Returns: Evidence for a Strange Attractor in Nature», The American Naturalist 124 (1984), págs. 798-820.
98 El mundo mejoraría «Simple Mathematical Models», pág. 467.
98 «La intuición matemática» Ibíd.
Una geometría de la naturaleza
99 Una imagen de la realidad Mandelbrot, Gomory, Voss, Barnsley, Richter, Mumford, Hubbard, Shlesinger. El texto básico de Benoît Mandelbrot es The Fractal Geometry of Nature (Nueva York: Freeman, 1977). Una entrevista efectuada por Anthony Barcelos aparece en Mathematical People, eds. Donald J. Albers y G. L. Alexanderson (Boston: Birkhäuser, 1985). Dos ensayos de Mandelbrot menos conocidos y sumamente interesantes son «On Fractal Geometry and a Few of the Mathematical Questions It Has Raised», Proceedings of the International Congres of Mathematicians, 16-24 de agosto de 1983, Varsovia, págs. 1661-75; y «Towards a Second Stage of Indeterminism in Science», separata, IBM Thomas J. Watson Research Center, Yorktown Heights, Nueva York. Las reseñas sobre la aplicación de los fractales se han hecho tan comunes, que sería prolijo citarlas; dos ejemplos útiles son Leonard M. Sander, «Fractal Growth Processes», Nature 322 (1986), págs. 789-93; y Richard Voss, «Random Fractal Forgeries: From Mountains to Music», en Science and Uncertainty, ed. Sara Nash (Londres: IBM United Kingdom, 1985).99 Sucedió en la pizarra de gabinete de trabajo Houthakker, Mandelbrot.
100 Wassily Leontief Citado en Fractal Geometry, pág. 423.
103 En el prólogo de una conferencia Woods Hole Oceanographic Institute, agosto de 1985.
103 Nació en Varsovia Mandelbrot.
105 Bourbaki Mandelbrot, Richter. Poco se ha escrito sobre Bourbaki, incluso a estas alturas. Una introducción juguetona es Paul R. Halmos, «Nicholas Bourbaki», Scientific American 196 (1957), págs. 88-89.
106 Las matemáticas habían de ser algo aparte Smale.
106 Su ciencia está sometida Peitgen.
107 Pionero por necesidad «Second Stage», pág. 5.
109 Esta descripción tan abstracta Mandelbrot; Fractal Geometry, pág. 74; J. M. Berger y Benoît Mandelbrot, «A New Model for the Clustering of Errors on Telephone Circuits», IBM Journal of Research and Development 7 (1963), págs. 224-36.
109 El efecto de José Fractal Geometry, pág. 248.
111 Las nubes no son esferas Ibíd., pág. 1, por ejemplo.
112 Intrigado por las líneas costeras Ibíd., pág. 27.
114 El procedimiento de abstracción Ibíd., pág. 17.
114 «La noción» Ibíd., pág. 18.
115 En una tarde invernal Mandelbrot.
117 La torre Eiffel Fractal Geometry, pág. 131, y «On Fractal Geometry», pág. 1663.
119 Técnicas de matemáticos F. Hausdorff y A. S. Besicovich.
120 «Había un ancho hiato» Mandelbrot.
121 En el nordeste Scholz; C. H. Scholz y C. A. Aviles, «The Fractal Geometry of Faults and Faulting», separata, Lamont-Doherty Geophysical Observatory; C. H. Scholz, «Scaling Laws for Large Earthquakes», Bulletin of the Seismological Society of America 72 (1982), págs. 1-14.
122 «Manifiesto» Fractal Geometry, pág. 24.
122 «No era un libro práctico» Scholz. 124 «Es un modelo único» Scholz.
127 «En la transición gradual» William Bloom y Don W. Fawcett, A Textbook of Histology (Filadelfia: W. B. Saunders, 1975).
127 Varios biólogos teóricos Hay una reseña de estas ideas en Ary L. Goldberger, «Nonlinear Dynamics, Fractals, Cardiac Physiology, and Sudden Death», en Temporal Disorder in Human Oscillatory Systems, eds. L. Resings, U. An der Heiden, M. Mackey (Nueva York: Springer-Verlag, 1987).
127 La red de fibras especiales Goldberger, West.
127-128 Varios cardiólogos que simpatizaban con el caos Ary L. Goldberger, Valmik Bhargava, Bruce J. West y Arnold J. Mandell, «On a Mechanism of Cardiac Electrical Stability: The Fractal Hypothesis», Biophysics journal 48 (1985), pág. 525.
128 E. I. Dupont de Nemours Barnaby J. Feder, «The Army May Have Matched the Goose», The New York Times, 30 de noviembre de 1986, 4: 16.
128 «Me puse a buscar» Mandelbrot.
129 Su nombre apareció I. Bernard Cohen, Revolution in Science (Cambridge, Mass.: Belknap, 1985), pág. 46.
130 «Ciertamente, es algo» Mumford.
130 «Tuvo que vencer tantas dificultades» Richter.
130 No podían evitar De la misma manera que, más tarde, evitó reconocer el mérito concedido rutinariamente a Mitchell Feigenbaum, en referencias a los números y universalidad de tal científico. En vez de hacerlo, Mandelbrot solía mencionar a P. J. Myrberg, matemático que había estudiado, de modo oscuro, en los primeros años sesenta, las iteraciones de los mapas cuadráticos.
131 «Mandelbrot no tuvo los pensamientos» Richter.
131 «La política afectaba» Mandelbrot.
132 Los grandes centros investigadores de la Exxon Klafter.
133 Un matemático contó a sus amigos Relatado por Huberman.
135 « ¿Por qué se declara?» «Freedom, Science, and Aestetics», en Schönheit im Chaos, pág. 35.
136 «Aquel período no simpatizó» John Fowles, A Maggot (Boston: Little, Brown, 1985), pág. 11.
137 «Tenemos que agradecer a los astrónomos» Rober H. G. Helleman, «Self-Generated Behavior in Nonlinear Mechanics», en Fundamental Problems in Statistical Mechanics 5, ed. E. G. D. Cohen (Ámsterdam: North-Holland, 1980), pág. 165.
137 Pero los físicos anhelaron Leo Kadanoff, por ejemplo, preguntó «Where is the physics of fractals?», en Physics Today, febrero de 1986, pág. 6, y contestó la pregunta con un nuevo planteamiento «multifractal» en Physics Today, abril de 1986, pág. 17, que provocó una réplica, enojada, como era de esperar, de Mandelbrot, en Physics Today, septiembre de 1986, pág. 11. La teoría de Kadanoff, escribió, «me llena del orgullo de un padre… ¿Será pronto el de un abuelo?».
Atractores extraños
139 Todos los grandes físicos Ruelle, Hénon, Rössler, Sinai, Feigenbaum, Mandelbrot, Ford, Kraichnan. Existen muchas perspectivas del contexto histórico de los atractores extraños, en cuanto a la turbulencia. Hay una introducción excelente en John Miles, «Strange Attractors in Fluid Dynamics», en Advances in Applied Mechanics 24 (1984), págs. 189-214. El artículo más accesible de Ruelle es «Strange Attractors», Mathematical Intelligencer 2 (1980), págs. 126-37; su proposición catalizadora fue David Ruelle y Floris Takens, «On the nature of Turbulence», Communications in Mathematical Physics 20 (1971), págs. 167-92; entre sus artículos esenciales figuran «Turbulent Dynamical Systems», Proceedings of the International Congress of Mathematicians, 16-24 de agosto de 1983, Varsovia, págs. 271-86; «Five Turbulent Problems», Physica 7D (1983), págs. 40-44; y «The Lorenz Attractor and the Problem of Turbulence», en Lecture Notes in Mathematics No. 565 (Berlín: Springer-Verlag, 1976), págs. 14658.139 Se cuenta sobre Hay muchas versiones de la anécdota. Orszag cita cuatro sustitutos de Heisenberg —Von Neumann, Lamb, Sommerfeld y Von Karman—, y agrega: «Imagino que, si Dios contestase a esas cuatro personas, la respuesta sería distinta en cada caso».
141 Este supuesto Ruelle; también «Turbulent Dynamical Systems», pág. 281.
142 Cuya obra sobre la mecánica de los fluidos L. D. Landau y E. M. Lifshitz, Fluid Mechanics (Oxford: Pergamon, 1959).
142 El oscilatorio, la varicosis sesgada Malkus.
144 «Es verdad» Swinney.
148 Swinney daba clases en 1973Swinney, Gollub.
148 «Tenía la apariencia de improvisación endeble» Dyson.
149 «Lo leímos» Swinney.
149 Comenzaron a comunicar sus resultados Swinney, Gollub.
149 «Allí teníamos la transición» Swinney.
150 El experimento no confirmaba la teoría J. P. Gollub y H. L. Swinney, «Onset of Turbulence in a Rotating Fluid», Physical Review Letters 35 (1975), pág. 927. Los primeros experimentos sólo dieron entrada al reconocimiento de los complejos comportamientos espaciales que podían ocurrir, variando los escasos parámetros del fluido entre los cilindros giratorios. En los años siguientes, se identificaron pautas que iban de «onditas en forma de sacacorchos» a «corrientes onduladas hacia el interior y el exterior» y «espirales interpenetrantes». Se tiene un sumario en C. David Andereck, S. S. Liu y Harry L. Swinney, «Flow Regimes in a Circular Couette System with Independently Rotating Cylinders», Journal of Fluid Mechanics 164 (1986), págs. 155-83.
150 David Ruelle decía Ruelle.
151 «La gente no especializada siempre descubre» Ruelle.
152 Escribió en el instituto un artículo «On the Nature of Turbulence».
152 Las opiniones al respecto variaban Descubrieron en seguida que algunas de sus ideas habían aparecido ya en la bibliografía rusa; «Por otra parte, la interpretación matemática que ofrecemos de la turbulencia es de nuestra propia responsabilidad», escribieron. «Note Concerning Our Paper “On the Nature of Turbulence”», Communications in Mathematical Physics 23 (1971), págs. 343-44.
152 Psicoanalíticamente «sugestiva» Ruelle.
152 « ¿Acaso se pregunta a Dios?» «Strange Attractors», pág. 131.
152 «Takens visitaba» Ruelle.
155 Algunos matemáticos de California Ralph H. Abraham y Christopher D. Shaw, Dynamics: The Geometry of Behavior (Santa Cruz: Aerial, 1984).
157 «Siempre me preocupa» Richard P. Feynman, The Character of Physical Law (Cambridge, Mass.: The MIT Press, 1967), pág. 57.
157 David Ruelle conjeturó Ruelle.
158 «La reacción del estamento científico» «Turbulent Dynamical Systems», pág. 275.
159 Edward Lorenz había adjuntado «Deterministic Nonperiodic Flow», pág. 137.
159 «Se hace muy cuesta arriba conciliar» Ibíd., pág. 140.
160 Le visitó una vez Ruelle.
160 «No se forme un concepto ególatra» Ueda expone sus primeros descubrimientos, desde el punto de vista de los circuitos eléctricos, en «Random Phenomena Resulting from Nonlinearity in the System Described by Duffing’s Equation», en International Journal of Non-Linear Mechanics 20 (1985), págs. 481-91. Proporciona en un epílogo una explicación personal de sus motivos y de la fría acogida de sus colegas. También, Stewart, informe personal.
161 «Una salchicha dentro de una salchicha» Rössler.
162 El más revelador de los atractores extraños Hénon; informó de su invención en «A Two-Dimensional Mapping with a Strange Attractor», en Communications in Mathematical Physics 50 (1976), págs. 69-77, y Michel Hénon e Yves Pomeau, «Two Strange Attractors with a Simple Structure», en Turbulence and the Navier-Stokes Equations, ed. R. Teman (Nueva York: Springer-Verlag, 1977).
165 ¿Es estable el solar? Wisdom.
166 «Para disfrutar de mayor libertad» Michel Hénon y Carl Heiles, «The Applicability of the Third Integral of Motion: Some Numerical Experiments», Astronomical Journal 69 (1964), pág. 73.
167 En el observatorio Hénon.
167 «Yo estaba convencido» Hénon.
167 «Aquí viene la sorpresa» «The Applicability», pág. 76.
169 «Pero el tratamiento matemático» Ibíd., pág. 79.
169 Un físico invitado Yves Pomeau.
169 «En ocasiones los astrónomos temen» Hénon.
172 Otros acopiaron millones de noticias Ramsey.
173 «No he hablado de la fascinación» «Strange Attractors», pág. 137.
Universalidad
175 «Uno se fija en algo» Feigenbaum. Los artículos más importantes de Feigenbaum sobre la universalidad son «Quantitative Universality for a Class of Nonlinear Transformations», Journal of Statistical Physics 19 (1978), págs. 25-52, y «The Universal Metric Properties of Nonlinear Transformations», Journal of Statistical Physics21 (1979), págs. 669-706; una representación algo más accesible, aunque requiera manejo matemático, es «Universal Behavior in Nonlinear Systems», Los Alamos Science 1 (estío de 1981), págs. 4-27. También me he apoyado en sus recuerdos inéditos, «The Discovery of Universality in Period Doubling».175 Cuando llegó al Los Álamos Feigenbaum, Carruthers, Cvitanović, Campbell, Farmer, Visscher, Kerrr, Hasslacher, Jen.
176 «Si se establece un comité» Carruthers.
177 El misterio del universo Feigenbaum.
178 A veces un asesor Carruthers.
179 Tal como Kadanoff consideró Kadanoff.
181 «El movimiento incesante» Gustav Mahler, carta a Max Marschalk.
182 «Cuando la luz se cierne» Zür Farbenlehre, de Goethe, ha tenido varias ediciones. He consultado Goethe’s Color Theory, obra bellamente ilustrada, que editó Herb Aach (Nueva York: Van Nostrand Reinhold, 1970); más fácil de consultar es Theory of Colors (Cambridge, Mass.: The MIT Press, 1970), con excelente introducción de Deane B. Judd.
186 Aquella ecuación de aire inocente En un momento dado, Ulam y Von Neumann usaron sus propiedades caóticas para resolver el problema de generar números al azar con un ordenador digital finito.
186 Metropolis, Stein y Stein Ese artículo —único camino que lleva a Stanislaw Ulam y John von Neumann a James Yorke y Mitchell Feigenbaum— es «On Finit Limit Sets for Transformations on the Unit Interval», Journal of Combinatorial Theory 15 (1973), págs. 25-44.
186 ¿Existe un clima? «The Problem of Deducing the Climate from the Governing Equations», Tellus 16 (1964), págs. 1-11.
188 Clima de la Tierra Blanca Manabe.
189 No sabía nada de Lorenz Feigenbaum.
191 Robert May recordó más tarde May.
191 Las mismas combinaciones de D e I «On Finite Limit Sets», págs. 30-31. Indicación trascendental: «El hecho de que estas pautas… sean propiedad común de cuatro transformaciones, en apariencia independientes…, propone que la secuencia de las pautas es atributo general de una amplia clase de representaciones gráficas o mapas. Por esa razón la hemos llamado secuencia U, en que U quiere decir (con alguna exageración) “universal”». Los matemáticos jamás sospecharon que la universalidad incluiría los números verdaderos; confeccionaron una tabla de 84 valores de parámetro, cada uno con siete decimales, sin observar las relaciones geométricas que disimulaban.
193 «Toda la tradición de la física» Feigenbaum.
199 Sus amigos sospechaban Cvitanović.
199 De repente se «veía» Ford.
199 Premios y honores La beca MacArthur; el Premio Wolf de Física de 1986.
202 La «feigenbaumología» Dyson.
202 «Fue un descubrimiento muy feliz» Gilmore. 202 En el ínterin Cvitanović.
203 Oscar E. Lanford III Incluso entonces la prueba pecaba de heterodoxa, pues dependían de una cantidad ingente de cálculos, de suerte que no podía efectuarse, ni comprobarse, sin el auxilio de un ordenador. Lanford; Oscar E. Lanford, «A Computer-Assisted Proof of the Feigenbaum Conjectures», Bulletin of the American Mathematical Society 6 (1982), pág. 427; también, P. Collet, J. P. Eckmann y O. E. Lanford, «Universal Properties of Maps on an Interval», Communications in Mathematical Physics 81 (1980), pág. 211.
203 «Caballero, ¿nos ofrecerá?» Feigenbaum, «The Discovery of Universality», pág. 17.
203 En el estío de 1977 Ford, Feigenbaum, Lebowitz.
203 «Mitch había visto la universalidad» Ford.
204 «Algo dramático sucedió» Feigenbaum.
El experimentador
207 «Albert está madurando» Libchaber, Kadanoff.207 Sobrevivió Libchaber.
208 «Helio en una cajita» Albert Libchaber, «Experimental Study of Hydrodynamic Instabilities. Rayleigh-Bénard Experiment: Helium in a Small Box», en Nonlinear Phenomena at Phase Transitions and Instabilities, ed. T. Riste (Nueva York: Plenum, 1982), pág. 259.
209 El laboratorio ocupaba Libchaber, Feigenbaum.
211 «La ciencia se edificó» Libchaber.
212 « ¡Claro que se sabe que es así!» Libchaber.
212 «El río manchado» Wallace Stevens, «This Solitude of Cataracts», The Palm at the End of the Mind, ed. Holly Stevens (Nueva York: Vintage, 1972), pág. 321.
213 «Ondulación asólida de lo sólido» «Reality Is an Activity of the Most August Imagination», Ibíd., pág. 396.
214 «Crea riberas» Theodor Schwenk, Sensitive Chaos (Nueva York: Schocken, 1976), pág. 19.
214 «Principio arquetípico» Ibíd.
217 Las desigualdades Ibíd., pág. 39.
217 «Pudiera ser» D’Arcy Wentworth Thompson, On Growth and Form, ed. J. T. Bonner (Cambridge: Cambridge University Press, 1961), pág. 8.
217 «Más allá de toda comparación» Ibíd., pág. viii.
218 «Escasean los que se han preguntado» Stephen Jay Gould, Hen’s Teeth and Horse’s Toes (Nueva York: Norton, 1983), pág. 369.
219 «Arraigados ritmos del crecimiento» On Growth and Form, pág. 267.
219 «La interpretación, en términos de fuerza» Ibíd., pág. 114.
221 Fue algo tan sensible Campbell.
222 «Era física clásica» Libchaber.
223 Sin embargo, una frecuencia distinta Libchaber y Maurer, 1980 y 1981. También proporciona un sumario lúcido la introducción de Cvitanović.
225 «La idea de que el movimiento» Hohenberg.
226 Se encontraron rodeados de las partes diseminadas Feigenbaum, Libchaber.
226 «Había que considerarlo» Gollub.
226 Un amplio bestiario de experimentos La bibliografía es asimismo amplia. Un sumario de la fusión inicial de la teoría con el experimento, en una variedad de sistemas, se tiene en Harry L. Swinney, «Observations of Orden and Chaos in Nonlinear Systems», Physica 7D (1983), págs. 3-15. Swinney proporciona una lista de referencias, divididas en categorías, desde osciladores electrónicos y químicos hasta experimentos de género más esotérico.
227 Para muchos fue más convincente Valter Franceschini y Claudio Tebaldi, «Sequences of Infinite Bifurcations and Turbulence in a FiveMode Truncation on the Navier-Stokes Equations», Journal of Statistical Physics 25 (1981), pág. 1. 228 «Un físico me preguntará» Libchaber.
Imágenes del caos
231 Michael Barnsley conoció Barnsley.232 «Ruelle me lo devolvió» Barnsley.
233 John Hubbard, matemático estadounidense Hubbard; también Adrien Douady, «Julia Sets and the Mandelbrot Set», págs. 161-73. El texto principal de The Beauty of Fractals proporciona asimismo un sumario matemático del método de Newton, lo mismo que de los campos coincidentes de la dinámica compleja tratada en este capítulo.
233 «Ahora bien, en lo referente a las ecuaciones» «Julia Sets and the Mandelbrot Set», pág. 170.
234 Estaba persuadido Hubbard.
236 Jamás se formó del todo un límite Hubbard; The Beauty of Fractals; Peter H. Richter y Heinz-Otto Peitgen, «Morphology of Complex Boundaries», Bunsen-Gesellschaft für Physikalische Chemie 89 (1985), págs. 575-88.
237 El conjunto de Mandelbrot Se tiene una introducción amena, con instrucciones para componer personalmente un programa de microordenador, en A. K. Dewdney, «Computer Recreations», Scientific American (julio de 1985), págs. 16-32. Peitgen y Richter ofrecen, en The Beauty of Fractals, una detallada exposición matemática y algunas de las imágenes más espectaculares que existen.
238 «Se obtiene una variedad increíble» «Julia Sets and the Mandelbrot Set», pág. 161.
238 Mandelbrot descubrió, en 1979 Mandelbrot, Laff, Hubbard. Mandelbrot relata el hecho en primera persona en «Fractals and the Rebirth of Iteration Theory», en The Beauty of Fractals, págs. 151-60.
239 Mientras procuraba refinar Mandelbrot; The Beauty of Fractals.
244 No hay en ellos dos partes «juntas» Hubbard.
245 «Era una concepción de líneas rectas» Peitgen.
246 En Cornell, mientras tanto Hubbard.
246 Richter había llegado a los sistemas Richter.
247 «En un área de nuevo cuño como ésta» Peitgen.
247 «El rigor es el alma» Peitgen.
250 Cada cuenca tiene un límite Yorke; buena introducción, para quien tenga aficiones técnicas, es Steven W. MacDonald, Celso Grebogi, Edward Ott y James A. Yorke, «Fractal Basin Boundaries», Physica 17D (1985), págs. 125-83.
250 Un billar romano imaginario Yorke.
252 «Nadie podrá acusarme» Yorke, comentarios en la Conference on Perspectives in Biological Dynamics and Theoretical Medicine, National Institutes of Health, Bethesda, Maryland, 10 de abril de 1986.
252 Más de las tres cuartas partes Yorke.
252 La frontera entre la calma y la catástrofe De modo semejante, en un texto de presentación del caos a los ingenieros, H. Bruce Stewart y J. M. Thompson avisaron: «Aletargado por una falsa sensación de seguridad, nacida de su familiaridad con la respuesta única de un sistema lineal, el analista o experimentador atareado grita “¡Eureka! He aquí la solución”, una vez que la simulación presenta un equilibrio de ciclo estable, sin molestarse en explorar con paciencia el resultado de diferentes condiciones iniciales. Para evitar errores y desastres, potencialmente dañinos, los diseñadores industriales han de apercibirse a destinar mayor esfuerzo a reconocer todo el ámbito de las respuestas dinámicas de sus sistemas». Nonlinear Dynamics and Chaos (Chiches-ter: Wiley, 1986), pág. xiii.
253 «Debiéramos creer» The Beauty of Fractals, pág. 136.
253 Cuando se refirió a ella por escrito Por ejemplo, «Iterated Function Systems and the Global Construction of Fractals», Proceedings of the Royal Society of London A 399 (1985), págs. 243-75.
255 «Si la imagen es complicada» Barnsley.
256 «No existe azar» Hubbard.
256 «La casualidad es un trampantojo» Barnsley.
El colectivo de los sistemas dinámicos
259 Santa Cruz Farmer, Shaw, Crutchfield, Packard, Burke, Nauenberg, Abrahams, Gucuenheimer. Lo esencial de Robert Shaw, en la aplicación de la teoría de la información al caos, es The Dripping Faucet as a Model Chaotic System (Santa Cruz: Aerial, 1984) en compañía de «Strange Attractors, Chaotic Behavior, and Information Theory», Zeitschrift für Naturforschung 36a (1981), pág. 80. Una narración de las aventuras con la ruleta de algunos de los estudiantes de Santa Cruz, que retrata muy bien el ambiente de aquellos años, es Thomas Bass, The Eudemonic Pie (Boston: Houghton Mifflin, 1985).260 Ignoraba por qué había ido Shaw.
260 William Burke, cosmólogo Burke, Spiegel.
261 «Arritmias cósmicas» Edward A. Spiegel, «Cosmic Arrhythmias», en Chaos in Astrophysics, eds. J. R. Buchler y otros (Nueva York: D. Reidel, 1985), págs. 91-135.
261 Los proyectos originales Farmer, Crutchfield.
262 Con distintas combinaciones de circuitos Shaw, Crutchfield, Burke.
263 Minutos después, Shaw supo Shaw.
263 «Cuanto hay que hacer» Abraham.
264 Doyne Farmer Farmer es el protagonista, y Packard su segundón, en The Eudemonic Pie, historia del proyecto de la ruleta, escrita por un antiguo componente del grupo.
265 La física de Santa Cruz Burker, Farmer, Crutchfield.
266 Era un «manitas» Shaw.
269 Había decidido Ford.
269 Juzgaron que podían hacerse Shaw, Farmer.
272 Teoría de la información El texto clásico, muy legible, es Claude E. Shannon y Warren Weaver, The Mathematical Theory of Communication (Urbana: University of Illinois, 1963), con una útil introducción de Weaver.
274 «Cuando encuentra el concepto» Ibíd., pág. 13.
275 Norman Packard, mientras leía Packard.
276 En el mes de diciembre de 1977 Shaw.
278 A. N. Kolmogorov y Yasha Sinai Sinai, entrevista privada.
279 «En el pináculo» Packard.
280 «Nada se ve» Shaw.
280 «Sirve de ejemplo sencillo» Shaw.
280 Los sistemas que el grupo de Santa Cruz Farmer; un medio de estudiar con uno dinámico el sistema inmunológico, simulando la capacidad del cuerpo humano para «recordar» y reconocer las pautas de manera creativa, se delinea en J. Doyne Farmer, Norman H. Packard y Alan S. Perelson, «The Inmune System, Adaptation, and Machine Learning», separata, Los Alamos National Laboratory, 1986.
281 Variable importante The Dripping Faucet, pág. 4.
281 «Una obra maestra del arte» Ibíd.
282 Un «seudocoloquio» Crutchfield.
283 «Da la casualidad de que» Shaw.
284 «Cuando se piensa en una variable» Farmer.
284 Reconstruir el espacio de fases Estos métodos, que llegaron a ser el principal soporte de la técnica experimental en muchas disciplinas, fueron refinados y ampliados por los investigadores de Santa Cruz y otros experimentadores y teóricos. Una de las propuestas esenciales de Santa Cruz se debió a Norman H. Packard, James P. Crutchfield, J. Doyne Farmer y Robert S. Shaw —la nómina canónica—, «Geometry from a Time Series», Physical Review Letters 47 (1980), pág. 712. El artículo más influyente sobre la materia, obra de Floris Takens, fue «Detecting Strange Attractor in Turbulence», Lecture Notes in Mathematics 898, eds. D. A. Rand y L. S. Young (Berlín: Springer-Verlag, 1981), pág. 336. Una revisión anterior, bastante amplia, de las técnicas de reconstrucción de imágenes del espacio de fases es Harold Froehling, James P. Crutchfield, J. Doyne Farmer, Norman H. Packard y Robert S. Shaw, «On Determining the Dimension of Chaotic Flows», Physica 3D (1981), págs. 605-17.
285 ¡Dios mío! Aún hacemos esto Crutchfield.
285 Algunos profesores negaron Por ejemplo, Nauenberg.
285 «No tuvimos consejero» Shaw.
286 Interesaban más al colectivo los sistemas reales Ello no quiere decir que los estudiantes ignorasen los diagramas y gráficos. Crutchfield, inspirado por la obra de May, invirtió mucho tiempo en 1978 en hacer diagramas, y por ello se le prohibió que se acercase a la mesa trazadora del centro de ordenadores: se habían destruido demasiadas plumillas en la operación de marcar millares de puntos.
286 Lanford escuchó con amabilidad Farmer.
286 «Tuvo la culpa de mi ingenuidad» Farmer.
287 «Las ayudas audiovisuales» Shaw.
288 Hubo un día en que Bernardo Huberman Crutchfield, Huberman.
288 «Todo era muy vago» Huberman.
288 El primer artículo Bernardo A. Huberman y James P. Crutchfield, «Chaotic States of Anharmonic Systems in Periodic Fields», Physical Review Letters 43 (1979), pág. 1743.
289 Farmer se encolerizó Crutchfield.
289 Los climatólogos Todavía se mantiene vivo el debate, por ejemplo, en Nature.
289 Los economistas, que analizaban los datos bursátiles Ramsey.
289 La dimensión fractal, la de Hausdorff J. Doyne Farmer, Edward Ott y James A. Yorke, «The Dimension of Chaotic Attractors», Physica7D (1983), págs. 153-80.
289 «El primer nivel de conocimiento» Ibíd., pág. 154.
Ritmos internos
291 Bernardo Huberman miró Huberman, Mandell (entrevistas y observaciones en la Conference on Perspectives in Biological Dynamics and Theoretical Medicine, Bethesda, Maryland, 11 de abril de 1986). También, Bernardo A. Huberman, «A Model for Disfunctions in Smooth Porsuit Eye Movement», separata, Xerox Palo Alto Research Center, Palo Alto, California.295 «Hay tres cosas» Abraham. La introducción básica a la hipótesis de Gaia —imaginativa visión dinámica de cómo los sistemas complejos de la Tierra se autorregulan, algo dada de lado por su deliberado antropomorfismo— es J. E. Lovelock, Gaia: A New Look at Life on Earth (Oxford: Oxford University Press, 1979).
296 Los investigadores, reconociendo cada vez más He aquí una selección algo arbitraria de referencias sobre temas fisiológicos (todas tienen citas útiles): Ary L. Goldberger, Valmik Bhargava y Bruce J. West, «Nonlinear Dynamics of the Heartbeat», Physica 17D (1985), páginas 207-14. Michael C. Mackay y Leon Glass, «Oscillation and Chaos in Physiological Control Systems», Science197 (1977), pág. 287. Mitchell Lewis y D. C. Rees, «Fractal Surfaces of Proteins», Science (1985), págs. 116365. Ary L. Goldberger y otros, «Nonlinear Dynamics in Heart Failure: Implications of Long Wavelenght Cardiopulmonary Oscillations», American Heart Journal 107 (1984), págs. 612-15. Teresa Ree Chay y John Rinzel, «Bursting, Beating, and Chaos in Excitable Membrane Model», Biophysical Journal 47 (1985), páginas 357-66. Una colección muy amplia y útil de otros artículos análogos es Chaos, ed. Arun V. Holden (Manchester: Manchester University Press, 1986).
297 «Sistema dinámico de interés trascendental» Ruelle, «Strange Attractors», pág. 48.
298 «Los médicos lo reducen a un problema» Glass.
298 «Estamos ante una frontera nueva» Goldberger.
299 Los matemáticos del Courant Institute Peskin; David M. McQueen y Charles S. Peskin, «Computer-Assisted Design of Pivoting Disc Prosthetic Mitral Valves», Journal of Thoracic and Cardiovascular Surgery 86 (1983), págs. 126-35.
300 El paciente de corazón aparentemente sano Cohen.
301 «La tarea de decidir» Winfree.
302 Aportó decidida noción geométrica Winfree expone su visión del tiempo geométrico en los sistemas biológicos en un libro provocativo y bello, When Time Breaks Down: The Three-Dimensional, Dynamics of Electrochemical Waves and Cardiac Arrhythmias (Princeton: Princeton University Press, 1987); artículo en que se reseñan las aplicaciones de los ritmos cardíacos de Arthur T. Winfree, «Sudden Cardiac Death: A Problem in Topology», Scientific American 248 (mayo de 1983), pág. 114.
302 «Tenía la cabeza llena» Winfree.
303 «Se va a un mosquito» Winfree.
304 Informó que se sentía en el mejor de los mundos Strogatz; Charles A. Czeisler y otros, «Bright Light Resets the Human Circadian Pacemaker Independent of the Timing of the Sleep-Wake Cycle», Science 233 (1986), págs. 667-70. Steven Strogatz, «A Comparative Analysis of Models of the Human Sleep-Wake Cycle», separata, Harvard University, Cambridge, Massachusetts.
304 El corazón le atrajo Winfree.
304 «Mines decidió» «Sudden Cardiac Death».
306 Sin embargo, lograrlo pide Ideker.
306 «El equivalente cardíaco» Winfree.
306 La intención inmediata de Ideker Ideker.
307 Emplearon diminutos agregados Glass.
307 «El comportamiento dinámico extraño» Michael R. Guevara, Leon Glass y Alvin Schrier, «Phase Locking, Period-Doubling Bifurcations, and Irregular Dynamics in Periodically Stimulated Cardiac Cells», Science 214 (1981), pág. 1350.
308 «Muchos ritmos distintos» Glass,
308 «Es ejemplo evidente» Cohen.
308 «Se han efectuado esas fantásticas» Glass.
309 «Los objetos dinámicos suelen ser» Winfree.
310 «Sistemas que por lo general oscilan» Leon Glass y Michael C. Mackay, «Pathological Conditions Resulting from Instabilities in Physiological Control Systems», Annals of the New York Academy of Sciences319 (1979), pág. 214.
311 «Los procesos fractales» Ary L. Goldberger, Valmik Bhargava, Bruce J. West y Arnold J. Mandell, «Some Observations on the Question: Is Ventricular Fibrillation “Chaos”», separata.
311 « ¿Será posible?» Mandell.
316 «Se llega al equilibrio con la muerte» Mandell.
316 Mandell ofreció a sus colegas Arnold J. Mandell, «From Molecular Biological Simplification to More Realistic Central Nervous System Dynamics: An Opinion», en Psychiatry: Psychobiological Foundations of Clinical Psychiatry 3:2, eds. J. 0. Cavenar y otros (Nueva York: Lippincott, 1985).
316 «El paradigma subyacente» Ibíd.
317 La dinámica de sistemas Huberman.
317 Tales modelos parecían tener Bernardo A. Huberman y Tad Hogg, «Phase Transitions in Artificial Intelligence Systems», separata, Xerox Palo Alto Research Center, Palo Alto, California, 1986. También, Tad Hogg y Bernardo A. Huberman, «Understanding Biological Computation: Reliable Learning and Recognition», Proceedings of the National Academy of Sciences 81 (1984), págs. 6871-75.
317 «Asombroso don de concentrar», Erwin Schrödinger, What Is Life? (Cambridge: Cambridge University Press, 1967), pág. 82.
317 «Hasta ahora hemos tratado en física» Ibíd., pág. 5.
El caos y allende
321 « ¿Qué pasó cuando dije aquello?» Ford.321 «Se rehace todo lo de Feigenbaum» Fox.
322 En cuanto al nombre y la definición (Holmes) SIAM Review 28 (1986), pág. 107; (Hao) Chaos (Singapur: World Scientific, 1984), pág. i; (Stewart) «The Geometry of Chaos», en The Unity of Science, Brookhaven Lecture Series, n.º 209 (1984), pág. 1; (Jensen) «Classical Chaos», American Scientist(abril de 1987); (Crutchfield) conversación privada; (Ford) «Book Reviews», International Journal of Theoretical Physics 25 (1986), n.º 1.
323 A su juicio, el mensaje imperioso Hubbard.
323 Era nombre insuficiente por lo angosto Winfree.
324 «Si usted metiera una sonda» Huberman.
324 «Consideremos de nuevo» Gaia, pág. 125.
324 Los físicos reflexivos P. W. Atkins, The Second Law (Nueva York: W. H. Freeman, 1984), pág. 179. Este excelente libro, de publicación reciente, es una de las contadas exposiciones de la segunda ley que explora el poder creador de la disipación en los sistemas caóticos. Opinión muy personal y filosófica de las relaciones de la termodinámica con los sistemas dinámicos que brinda Ilya Prigogine, Order Out of Chaos: Man’s New Dialogue With Nature (Nueva York: Bantam, 1984).
327 El desarrollo de tales puntas Langer. Es voluminosa la bibliografía reciente sobre el copo de nieve dinámico. Las obras más útiles son: James S. Langer, «Instabilities and Pattern Formation», Reviews of Modern Physics 52 (1980), págs. 1-28; Johann Nittmann y H. Eugene Stanley, «Tip Splitting without Interfacial Tension and Dendritic Growth Patterns Arising from Molecular Anisotropy», Nature 321 (1986), págs. 663-68; David A. Kessler y Herbert Levine, «Pattern Selection in Fingered Growth Phenomena», que aparecerá en Advances in Physics.
331 En el fondo de sus mentes Gollub, Langer.
331 Las ondas de la convección, de figuras tan raras Un interesante ejemplo de este camino al estudio de la formación de pautas es P. C. Hohenberg y M. C. Cross, «An Introduction to Pattern Formation in Nonequilibrium Systems», separata, AT&T Laboratories, Murray Hill, Nueva Jersey.
331 Los expertos en el caos emplean en astronomía Wisdom; Jack Wisdom, «Meteorites May Follow a Chaotic Route to Earth», Nature 315 (1985), págs. 731-33, y «Chaotic Behavior and the Origin of the 3/1 Kirkwood Gap», Icarus 56 (1983), págs. 51-74.
331 Estructuras que se copian Como lo manifestaron Farmer y Packard: «El comportamiento adaptable es propiedad emergente que nace de manera espontánea gracias a la interacción de componentes simples. Sean esos componentes neuronas, aminoácidos, hormigas o tendones, la adaptación sólo ocurre si el comportamiento colectivo del todo es distinto, cualitativamente, de la suma de las partes individuales. Ésta es en sí la definición de lo no lineal». «Evolution, Games, and Learning: Models for Adaptation in Machines and Nature», introducción a las actas de la conferencia, Center for Nonlinear Studies, Los Alamos National Laboratory, mayo de 1985.
331 «La evolución es caos» «What is Chaos», pág. 14.
331 «Dios juega a los dados» Ford.
332 «La profesión no puede continuar» Structure, pág. 5.
332 «A la vez estimulante y un poco amenazador» William M. Schaffer, «Chaos in Ecological Systems. The Coals That Newcastle Forgot», Trends in Ecological Systems 1 (1986), pág. 63.
332 «Lo que pasa por conceptos básicos» William M. Schaffer y Mark Kot, «Do Strange Attractors Govern Ecological Systems?», BioScience 35 (1985), pág. 349.
332 Schaffer usa Por ejemplo, William M. Schaffer y Mark Kot, «Nearly One-Dimensional Dynamics in an Epidemic», Journal of Theoretical Biology 112 (1985), págs. 403-27.
333 «Más puntualmente» Schaffer.
333 Años más tarde, Schaffer vivió Schaffer; también William M. Schaffer, «A Personal Hejira», obra inédita.Muchos científicos tuvieron la generosidad de guiarme, informarme e instruirme. La contribución de algunos será evidente para el lector; pero muchos otros, no citados en el texto o mencionados sólo de paso, me ayudaron igualmente, poniendo a mi disposición su tiempo y su inteligencia. Abrieron sus archivos, registraron su memoria, debatieron entre sí y apuntaron formas de pensar en una ciencia que me eran indispensables. Varios leyeron el manuscrito original. Mi investigación sobre el tema de este libro necesitó de su paciencia y su honradez.
Deseo expresar mi reconocimiento a mi editor, Daniel Frank, cuya imaginación, sensibilidad e integridad aportaron a estas páginas más de lo que puedo expresar. Dependí de Michael Carlisle, mi agente literario, quien me concedió su apoyo, tan certero como entusiástico. En el New York Times, Peter Millones y Don Erikson me auxiliaron de manera decisiva. Entre las personas que colaboraron con ilustraciones figuran Heinz-Otto Peitgen, Peter Richter, James Yorke, Leo Kadanoff, Philip Marcus, Benoît Mandelbrot, Jerry Gollub, Harry Swinney, Arthur Winfree, Bruce Stewart, la familia Fereydoon, Irving Epstein, Martin Glicksman, Scott Burns, James Crutchfield, John Milnor, Richard Voss, Nancy Sterngold y Adolph Brotman. También estoy agradecido a mis padres, Beth y Donen Gleick, que no sólo me educaron correctamente, sino también corrigieron el libro.
Goethe escribió: «Tenemos el derecho de esperar de quien se propone ofrecernos la historia de una ciencia que nos informe de cómo se conocieron gradualmente los fenómenos de que trata, y de lo que se imaginó, conjeturó, se supuso o pensó sobre ellos». Es «asunto aventurado —continuó— pues, en tal empresa, el escritor anuncia de modo tácito al principio que se propone iluminar unas cosas y dejar otras en la sombra. Sin embargo, el autor ha disfrutado durante el cumplimiento de su quehacer…».Expresamos nuestro agradecimiento por la autorización de reproducir pasajes de las siguientes obras:
- «Ohio» y «The Moons of Jupiter», de Facing Nature, de John Updike. Copyright John Updike, 1985. Con licencia de Alfred A. Knopf, Inc.
- The Character of Physical Law, de Richard Feynman. Copyright The MIT Press. Con licencia del editor, The MIT Press.
- «Thoughts During and Air Raid», de Selected Poems, de Stephen Spender. Copyright Stephen Spender, 1964. Con licencia de Random House, Inc.
- Mathematical Modeling of Biological Systems, de Harvey J. Gold. Copyright John Wiley & Sons, Inc., 1977. Con licencia de John Wiley & Sons.
- «Connoisseur of Chaos», «This Solitude of Cataracts» y «Reality is an Activity of the Most August Imagination», de The Palm at the End of the Mind: Selected Poems and a Play, de Wallace Stevens, editor Holly Stevens. Copyright Holly Stevens, 1967, 1969, 1971. Con licencia de Alfred A. Knopf, Inc.
- Weather Prediction, de L. F. Richardson. Con licencia de Cambridge University Press.
- «The Room» de Collected Poems, de Conrad Aiken. Copyright Conrad Aiken, 1953, 1970; Mary Aiken, 1981. Con licencia de Oxford University Press.
- The Structure of Scientific Revolution, de Thomas Kuhn. Copyright University of Chicago, 1962, 1970. Reservados todos los derechos. Con licencia de The University of Chicago Press.
- «Method in the Physical Sciences», de Collected Works, de John von Neumann, vol. 6. Copyright Pergamon Books Ltd., 1963. Con licencia de pergamon Books Ltd.
Procedencia de las ilustraciones en color, encartadas entre las págs. 128 y 129: pág. 1 del encarte: James P. Crutchfield [atractor de Lorenz] y Benoît Mandelbrot, The Fractal Geometry of Nature(Nueva York: Freeman, 1977) [curva de Koch]; págs. 2-5: Heinz-Otto Peitgen y Peter H. Richter, The Beauty of Fractals (Berlín: Springer-Verlag, 1986) [conjunto de Mandelbrot]; pág. 6: Scott Burns, Harold E. Benzinger y Julian Palmore [método de Newton]; pág. 7: Richard F. Voss [red de filtración]; pág. 8: National Aeronautic and Space Administration (NASA) [Júpiter] y Philip Marcus [simulación de la Mancha Roja].
Procedencia de las ilustraciones en blanco y negro, situadas entre las págs. 256 y 257: John Milnor.
NOTA: Los números de página se refieren a la edición en papel.
Notas:
Elíjase un valor arbitrario para r —por ejemplo, 2,7—, y una población inicial de 0,02. Uno menos 0,02 es 0,98. Multiplíquese por 0,02 y se obtendrá 0,0196. Multiplíquese esta cifra por 2,7 y el producto será 0,0529. La pequeñísima población inicial se ha doblado sobradamente. Repítase el procedimiento, usando como simiente la nueva población, y se conseguirá 0,1353. Con una máquina calculadora programable, de escaso precio, la iteración se reduce a oprimir el mismo botón repetidas veces. La población se eleva a 0,3159, luego a 0,5835, después a 0,6562… El ritmo de aumento se hace más pausado. Más tarde, cuando el hambre afecta a la reproducción, 0,6092. Después, 0,6428, 0,6199, 0,6362 y 0,6249. Los números parecen saltar adelante y atrás, pero se aproximan a uno fijo: 0,6328, 0,6273, 0,6312, 0,6285, 0,6304, 0,6291, 0,6300, 0,6294, 0,6299, 0,6295, 0,6297, 0,6296, 0,6297, 0,6298, 0,6296, 0,6296, 0,6296, 0,6296, 0,6296, 0,6298. ¡Éxito!
En los días en que las operaciones aritméticas se efectuaban con lápiz y papel, y en aquellos en que las máquinas de cálculo se movían con manivelas, la exploración numérica jamás fue mucho más lejos.
0,4000, 0,8400, 0,4704, 0,8719,
0,3908, 0,8332, 0,4862, 0,8743,
0,3846, 0,8284, 0,4976, 0,8750,
0,3829, 0,8270, 0,4976, 0,8750,
0,3829, 0,8270, 0,5008, 0,8500,
0,3828, 0,8269, 0,5009, 0,8500,
0,3828, 0,8269, 0,5009, 0,8500,


El programa tiene que repetir este proceso para cada uno de los millares de puntos de la rejilla, con una escala susceptible de mayor ampliación. Y el programa ha de mostrar el resultado. Los puntos de un conjunto pueden colorearse de blanco unos, y de rojo otros. O, con el fin de que la imagen sea mucho más atractiva, los puntos blancos se sustituyen con matices de color. Si la iteración se interrumpe, por ejemplo, al cabo de diez repeticiones, el programa puede marcar un punto encarnado; si a las veinte, uno anaranjado; si a las cuarenta, uno amarillo, etc. La elección de los colores y las interrupciones que sirven de señal para empezar a utilizar uno de ellos, dependen del gusto del programador. Los colores revelan los contornos del terreno que hay en el exterior del conjunto propiamente dicho.